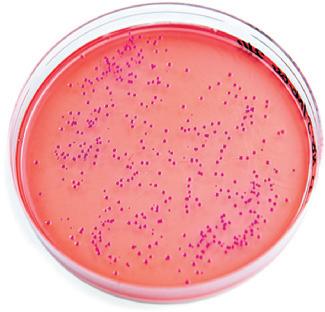
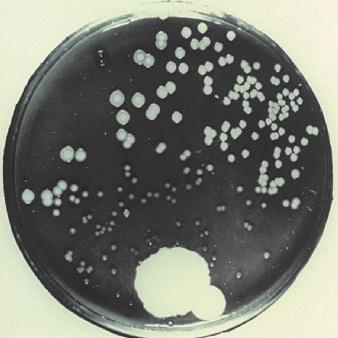

Ciências da Natureza
Anos Iniciais do Ensino Fundamental
Editora responsável: Ana Carolina Navarro dos Santos Ferraro
Organizadora:
EDITORA NOVO RUMO Obra coletiva concebida, desenvolvida e produzida pela Editora Novo Rumo.
Componente curricular: Ciências da Natureza

Ciências da Natureza
Anos Iniciais do Ensino Fundamental
Organizadora: EDITORA NOVO RUMO
Obra coletiva concebida, desenvolvida e produzida pela Editora Novo Rumo.
Editora responsável:
Ana Carolina Navarro dos Santos Ferraro
Mestra em Patologia Experimental pela Universidade Estadual de Londrina (UEL-PR).
Licenciada e bacharela em Ciências Biológicas pela Universidade Estadual de Londrina (UEL-PR).
Licenciada em Pedagogia pela Universidade Pitágoras Unopar Anhanguera. Editora e elaboradora de materiais didáticos.
Componente curricular:
Ciências da Natureza 1ª edição Londrina, 2025
Copyright © Editora Novo Rumo, 2025.
Edição Ana Carolina Navarro dos Santos Ferraro, Angélica Alves de Paula
Assistência editorial Maira Balestri
Preparação e revisão Moisés Manzano da Silva (coord.)
Gerência de produção editorial Camila Rumiko Minaki Hoshi
Supervisão de produção editorial Priscilla de Freitas Cornelsen Rosa
Assistência de produção editorial Lorena França Fernandes Pelisson
Coordenação de produção de arte Tamires Rose Azevedo
Edição de arte Ingridhi Borges
Projeto gráfico e design Dayane Barbieri, Keithy Mostachi, Laís Garbelini
Projeto de capa Marcela Pialarissi
Ilustrações de capa Cajila Barbosa
Coordenação de diagramação Adenilda Alves de França Pucca - Nil
Diagramação AVITS Estúdio Gráfico Ltda., EfeDois Editoração Ltda., Leandro
Júnior Pimenta
Autorização de recursos João Henrique Pedrão Feliciano
Iconografia Alessandra Roberta Arias, Vinícius Costa (trat. imagens)
Objetos digitais
Gerência de produção Erick Lopes de Almeida
Roteiros Renan Alves
Edição de imagens Leticia Nakadomari
Desenvolvimento Ohanna Schmitt Bolfe, Tatiana Tissa Kawakami
Dados Internacionais de Catalogação na Publicação (CIP) (Câmara Brasileira do Livro, SP, Brasil)
Plantar ciências da natureza : 4º ano : anos iniciais do ensino fundamental / organizadora Editora Novo Rumo ; obra coletiva concebida, desenvolvida e produzida pela Editora Novo Rumo ; editora responsável Ana Carolina Navarro dos Santos Ferraro. -- 1. ed. -- Londrina, PR : Editora Novo Rumo, 2025.
Componente curricular: Ciências da natureza.
ISBN 978-65-5158-090-1(livro do estudante)
ISBN 978-65-5158-092-5(livro do professor)
ISBN 978-65-5158-094-9(livro do estudante HTML5)
ISBN 978-65-5158-105-2(livro do professor HTML5)
1. Ciências da natureza (Ensino fundamental) I. Ferraro, Ana Carolina Navarro dos Santos. II. Série.
Índices para catálogo sistemático:
1. Ciências da natureza : Ensino fundamental 372.35
Eliete Marques da Silva - Bibliotecária - CRB-8/9380
Reprodução proibida: Art. 184 do Código Penal e Lei 9.610 de 19 de fevereiro de 1998. Todos os direitos reservados à EDITORA NOVO RUMO.
Avenida Doutor Adhemar Pereira de Barros, 1500, sala 804 - Bela Suíça - Londrina-PR CEP 86047-250 - Tel. (43) 3367-2030 contato@editoranovorumo.com.br
Elaboração de originais
Ana Carolina Navarro dos Santos Ferraro
Mestra em Patologia Experimental pela Universidade Estadual de Londrina (UEL-PR).
Licenciada e bacharela em Ciências Biológicas pela Universidade Estadual de Londrina (UEL-PR).
Licenciada em Pedagogia pela Universidade Pitágoras Unopar Anhanguera. Editora e elaboradora de materiais didáticos.
Angélica Alves de Paula
Doutora e mestra em Ciências Biológicas pela Universidade Estadual de Londrina (UEL-PR).
Licenciada e bacharela em Ciências Biológicas pela Universidade Estadual de Londrina (UEL-PR). Elaboradora e editora de materiais didáticos.
Luciana Maria Garcia
Especialista em Neuropedagogia pelas Faculdades Integradas do Vale do Ivaí (Univale-PR).
Especialista em Educação especial: atendimento às necessidades especiais pelas Faculdades Integradas do Vale do Ivaí (Univale-PR).
Especialista em Psicopedagogia Institucional pela Universidade Norte do Paraná (Unopar-PR).
Licenciada e bacharela em Física pela Universidade Estadual de Londrina (UEL-PR).
Atua como professora em escolas do Ensino Básico. Elaboradora e editora de materiais didáticos.
Marcela Yaemi Ogo
Mestra em Ensino de Ciências e Educação Matemática pela Universidade Estadual de Londrina (UEL-PR).
Especialista em Biologia Aplicada à Saúde pela Universidade Estadual de Londrina (UEL-PR).
Especialista em Análise e Educação Ambiental em Ciências da Terra pela Universidade Estadual de Londrina (UEL-PR).
Especialista em Psicopedagogia Institucional, Clínica e TGD pela Faculdade Futura (SP).
Licenciada em Ciências Biológicas pela Universidade Estadual de Londrina (UEL-PR).
Licenciada em Pedagogia pelo Centro Universitário Facvest (Unifacvest-SC).
Licenciada em Matemática pela Faculdade Educacional da Lapa (FAEL-PR).
Atua como professora em escolas do Ensino Básico. Elaboradora e editora de materiais didáticos.
Em respeito ao meio ambiente, as folhas deste livro foram produzidas com fibras obtidas de árvores de florestas plantadas, com origem certificada.
Impresso no Parque Gráfico da Editora FTD CNPJ 61.186.490/0016-33
Avenida Antonio Bardella, 300 Guarulhos-SP – CEP 07220-020 Tel. (11) 3545-8600 e Fax (11) 2412-5375
APRESENTAÇÃO
Acreditamos que o aprendizado em Ciências da Natureza é essencial para que os estudantes se tornem cidadãos ativos e capazes de pensar de forma autônoma e crítica. Esta coleção foi cuidadosamente pensada para ser uma parceira nessa missão, proporcionando uma abordagem integrada e relevante.
Ao longo de cada unidade, o conteúdo se conecta diretamente com a realidade dos estudantes, valorizando o que eles já sabem e incentivando a construção de novos conhecimentos. Nessa dinâmica, o professor não é apenas um detentor do saber, mas um guia e um mediador, orientando os estudantes a serem os protagonistas de sua aprendizagem.
Para apoiar essa jornada, apresentamos este Livro do Professor. Na primeira parte dele, você encontra informações sobre a estrutura da coleção e a Reprodução do Livro do Estudante com as orientações ao professor nas laterais e nos rodapés das páginas reproduzidas, com comentários práticos para auxiliar no dia a dia em sala de aula, como orientações sobre os conteúdos das unidades, atividades extras, momentos sugeridos de avaliação, entre outros subsídios. Na segunda parte, apresentamos o Manual do Professor, onde você encontra desde a estrutura da Base Nacional Comum Curricular (BNCC) e fundamentos teórico-metodológicos da coleção até recursos práticos, como estratégias de avaliação diversificadas, modelos de planejamento de rotina e de sequência didática, quadro de distribuição dos conteúdos e sugestões de cronogramas que contribuem para o desenvolvimento docente.
É importante ressaltar que as sugestões podem ser adequadas de acordo com a realidade da turma e da escola. Esperamos que seja uma ferramenta útil e enriquecedora no processo de ensino-aprendizagem, possibilitando a formação de cidadãos críticos e participativos na sociedade.
Desejamos a você um ótimo ano letivo!
AS UNIDADES TEMÁTICAS, OS OBJETOS DE CONHECIMENTO E AS HABILIDADES ...................... X OS TEMAS CONTEMPORÂNEOS TRANSVERSAIS .........................................................XI
INTEGRAÇÃO ENTRE OS COMPONENTES CURRICULARES ................................................... XI
A PRÁTICA INTERDISCIPLINAR E O TRABALHO COM PROJETOS INTERDISCIPLINARES................ XII
AVALIAÇÃO ....................................................... XIII O PAPEL DO PROFESSOR E A PRÁTICA DOCENTE ............................................................ XV A PRÁTICA PEDAGÓGICA EM AÇÃO .................... XVI O ENSINO DE CIÊNCIAS DA NATUREZA ....... XXII
FUNDAMENTOS TEÓRICO-METODOLÓGICOS NO ENSINO DE CIÊNCIAS DA NATUREZA ................. XXII
ESTRATÉGIAS QUE AUXILIAM NO DESENVOLVIMENTO DIDÁTICO DOS CONTEÚDOS DE CIÊNCIAS DA NATUREZA ...... XXIV
QUADRO DE DISTRIBUIÇÃO DOS CONTEÚDOS ...........................................XXVI
SUGESTÕES DE CRONOGRAMAS .............. XXVIII
REFERÊNCIAS COMPLEMENTARES PARA A PRÁTICA DOCENTE ..........................XXIX
REFERÊNCIAS BIBLIOGRÁFICAS COMENTADAS – LIVRO DO PROFESSOR ...... XXX
AS COMPETÊNCIAS GERAIS DA EDUCAÇÃO BÁSICA ................................................ VII AS COMPETÊNCIAS ESPECÍFICAS...........................IX
MANUAL DO PROFESSOR
CONHEÇA A COLEÇÃO
Esta coleção é composta de três volumes, sendo 3º , 4º e 5º anos, destinados aos estudantes e professores dos Anos Iniciais do Ensino Fundamental. Cada volume é organizado em 4 unidades que, por sua vez, são subdivididas em temas e seções que desenvolvem as habilidades relacionadas aos objetos de conhecimento e às competências gerais e específicas propostas pela BNCC. Além disso, durante o desenvolvimento dos conteúdos, a coleção aborda os temas contemporâneos transversais, contribuindo para a formação de cidadãos críticos e atuantes na sociedade.
Além dos volumes impressos, a coleção apresenta a versão digital do Livro do Estudante e do Livro do Professor. Esses materiais digitais apresentam recursos acessíveis, favorecendo a utilização por todos os estudantes. Os livros digitais também apresentam alguns recursos, como infográficos clicáveis, que podem ser acessados, na versão digital, por meio do sumário e de ícones indicados nas páginas dos livros.
O LIVRO DO ESTUDANTE
A seguir, apresentamos a estrutura do Livro do Estudante, explicando as características das seções e de outros elementos que compõem a coleção.
VAMOS INICIAR
Essa seção, presente no início de cada volume, tem o objetivo de avaliar os estudantes com relação aos conhecimentos esperados para o ano de ensino, permitindo a você fazer uma avaliação diagnóstica da turma.
PÁGINAS DE ABERTURA
Têm como objetivos marcar o início de cada unidade, despertar a atenção dos estudantes para o que será abordado e relacionar os conteúdos aos conhecimentos prévios e à sua realidade próxima.
DESENVOLVIMENTO DOS CONTEÚDOS
Os conteúdos são desenvolvidos por meio dos textos, das imagens, das atividades e das seções presentes nas unidades. Com o objetivo de tornar as aulas mais dinâmicas e envolventes, as atividades relacionadas aos conteúdos são apresentadas ao longo da teoria, de modo integrado.
VOCABULÁRIO
Apresenta o significado de termos que os estudantes podem desconhecer e que são importantes para a compreensão do texto.
BOXE COMPLEMENTAR
Apresenta textos e imagens com informações complementares aos conteúdos da unidade.
COLETIVAMENTE
Explora os temas contemporâneos transversais, contribuindo para a formação cidadã dos estudantes por meio de reflexões e propostas de resoluções de problemas, de modo que eles sejam atuantes na sociedade em que
vivem. Os temas contemporâneos transversais desenvolvidos são identificados nas orientações ao professor
ENTRE TEXTOS
Promove o trabalho com diferentes gêneros textuais, possibilitando o desenvolvimento de habilidades relacionadas à leitura, à escrita, à oralidade e aos processos gerais de compreensão de leitura: localizar e retirar informação explícita de textos; fazer inferências diretas; interpretar e relacionar ideias e informações; e analisar e avaliar conteúdos e elementos textuais.
VAMOS INVESTIGAR
Seção que sugere atividades práticas investigativas nas quais os estudantes são incentivados a levantar hipóteses, realizar a experimentação, observar e analisar os resultados, além de elaborar conclusões.
VAMOS AVALIAR O APRENDIZADO
Essa seção tem como objetivo sugerir uma avaliação formativa, de modo que você possa avaliar a aprendizagem dos estudantes com relação aos conteúdos abordados na unidade, possibilitando informações para intervenções caso haja defasagens ou dificuldade de aprendizagem.
SAIBA MAIS
Apresenta sugestões de recursos extras, como livros e sites. Cada sugestão é acompanhada por uma breve sinopse.
VAMOS CONCLUIR
Presente no final de cada volume, essa seção contém atividades cujo objetivo é sugerir uma avaliação somativa, de modo que você possa avaliar os estudantes quanto aos conhecimentos adquiridos durante o processo de ensino no ano letivo.
REFERÊNCIAS BIBLIOGRÁFICAS COMENTADAS
Presente ao final do livro, apresenta referências comentadas de livros e sites que foram consultadas na elaboração do Livro do Estudante.
ÍCONE DE RESPOSTA ORAL
Indica que os estudantes devem responder à atividade oralmente.
ÍCONE DE RESPOSTA NO CADERNO
Indica que os estudantes devem registrar as respostas da atividade no caderno.
OBJETO DIGITAL
Indica que há Objeto Educacional Digital relacionado aos temas que estão sendo trabalhados e que pode ser acessado na versão digital do livro.
DESTAQUE DICA
Apresenta dicas que podem auxiliar os estudantes na realização de algumas atividades.
DESTAQUE ATENÇÃO
Apresenta cuidados que devem ser tomados durante a realização de algumas atividades.
O LIVRO DO PROFESSOR
Este Livro do Professor é organizado em duas partes. Esta primeira parte apresenta a estrutura da coleção e a Reprodução do Livro do Estudante, que se refere à reprodução das páginas do Livro do Estudante em tamanho reduzido, com respostas e possíveis comentários para você. Nas laterais e nos rodapés dessas páginas, as orientações ao professor propõem comentários, sugestões de condução para as atividades e respostas de algumas atividades que não foram apresentadas na reprodução da página do Livro do Estudante. Essas orientações colaboram para a prática docente e em seu dia a dia em sala de aula.
A segunda parte, apresentada após a Reprodução do Livro do Estudante, é intitulada Manual do Professor Ela apresenta a estrutura da BNCC, a fundamentação teórico-metodológica da coleção e aborda diversos assuntos que contribuem para o desenvolvimento docente e para o dia a dia em sala de aula. Além disso, apresenta um quadro de distribuição dos conteúdos com as habilidades e as competências da BNCC que estão sendo desenvolvidas em cada unidade e sugestões de cronogramas bimestrais, trimestrais e semestrais. Ao final dessa parte, são apresentadas sugestões de referências complementares para a prática docente e as referências bibliográficas comentadas utilizadas como consulta para a produção das orientações ao professor e do Manual do Professor
Observe a seguir como as orientações ao professor, que constam na primeira parte deste Livro do Professor, estão estruturadas.
Nas orientações ao professor da seção Vamos iniciar, você encontra os objetivos pedagógicos e as sugestões de intervenção, com base nas respostas dos estudantes, considerando os conhecimentos prévios deles.
OBJETIVOS DA UNIDADE
Destaca os objetivos pedagógicos de cada unidade do Livro do Estudante.
SUGESTÃO DE ESTRATÉGIA INICIAL
Fornece dicas para que você possa iniciar as aulas, abordar alguns conteúdos ou realizar uma avaliação diagnóstica de maneira diferente da que foi apresentada no Livro do Estudante.
BNCC
Apresenta habilidades, competências e temas contemporâneos transversais da BNCC que estão sendo desenvolvidos em cada conteúdo, destacando as relações entre esses elementos e o conteúdo.
COMENTÁRIOS DIVERSOS
Os comentários e as explicações de caráter prático referentes às atividades do Livro do Estudante e as considerações pedagógicas a respeito de possíveis
dificuldades dos estudantes na resolução das atividades, bem como alternativas para consolidar conhecimentos, são inseridos em tópicos ao longo da unidade.
Nas orientações ao professor da seção Coletivamente, apresentamos os objetivos pedagógicos e as orientações sobre como desenvolver os conteúdos e as atividades da seção com os estudantes.
Nas orientações ao professor da seção Entre textos, apresentamos os objetivos pedagógicos e as orientações sobre como desenvolver a competência leitora e a competência da escrita por meio do trabalho com essa seção.
Nas orientações ao professor da seção Vamos investigar, apresentamos os objetivos pedagógicos e as orientações sobre como desenvolver a investigação proposta na seção com os estudantes.
Nas orientações ao professor da seção Vamos avaliar o aprendizado, apresentamos os objetivos pedagógicos e as sugestões de intervenção para você, com base nas respostas dos estudantes, considerando possíveis dificuldades na resolução das atividades, bem como alternativas para consolidar aprendizagens.
Nas orientações ao professor da seção Vamos concluir, apresentamos os objetivos pedagógicos e as sugestões de intervenção para você, com base nas respostas dos estudantes, considerando possíveis dificuldades na resolução das atividades, bem como alternativas para consolidar aprendizagens.
RESPOSTAS
Apresenta as sugestões de respostas de algumas atividades e questões indicadas no Livro do Estudante
ATIVIDADE EXTRA
Apresenta sugestões de atividades complementares que contribuem para diversificar as estratégias de aprendizagem.
OBJETIVOS
Lista os objetivos pedagógicos de algumas seções do Livro do Estudante
AVALIANDO
Propõe avaliações formativas para que você possa acompanhar a aprendizagem dos estudantes em diferentes momentos, possibilitando, se for o caso, intervenções no ensino. Para facilitar a avaliação, esse boxe apresenta os objetivos das atividades e as sugestões de intervenção, com foco na recuperação da aprendizagem.
ARTICULANDO CONHECIMENTOS
Destaca momentos em que é possível estabelecer relações entre componentes curriculares de diferentes áreas do conhecimento, além de orientações práticas sobre como realizar as articulações entre os conteúdos.
REFERÊNCIAS COMPLEMENTARES
Fornece sugestões de livros, artigos e sites, contribuindo para a sua formação.
LIVRO DO ESTUDANTE
Reprodução do Livro do Estudante
Ciências da Natureza
Organizadora:
EDITORA NOVO RUMO
Obra coletiva concebida, desenvolvida e produzida pela Editora Novo Rumo.
Editora responsável:
Ana Carolina Navarro dos Santos Ferraro
Anos Iniciais do Ensino Fundamental
Mestra em Patologia Experimental pela Universidade Estadual de Londrina (UEL-PR).
Licenciada e bacharela em Ciências Biológicas pela Universidade Estadual de Londrina (UEL-PR).
Licenciada em Pedagogia pela Universidade Pitágoras Unopar Anhanguera. Editora e elaboradora de materiais didáticos.
Componente curricular: Ciências da Natureza
1ª edição Londrina, 2025
11/09/2025 14:17:00
Esta parte do Livro do Professor contém a Reprodução do Livro do Estudante em tamanho reduzido, com respostas das atividades e possíveis comentários para você. Além disso, nas laterais e rodapés há as orientações ao professor que servem como um guia para a prática pedagógica apresentando sugestões sobre como trabalhar as atividades, além de apresentar as respostas que não foram incluídas na reprodução das páginas. Para deixar mais evidente o sentido de leitura, em algumas páginas utilizamos as indicações e .
Copyright © Editora Novo Rumo, 2025.
Edição Ana Carolina Navarro dos Santos Ferraro, Angélica Alves de Paula
Assistência editorial Maira Balestri
Preparação e revisão Moisés Manzano da Silva (coord.)
Gerência de produção editorial Camila Rumiko Minaki Hoshi
Supervisão de produção editorial Priscilla de Freitas Cornelsen Rosa
Assistência de produção editorial Lorena França Fernandes Pelisson
Coordenação de produção de arte Tamires Rose Azevedo
Edição de arte Ingridhi Borges
Projeto gráfico e design Dayane Barbieri, Keithy Mostachi, Laís Garbelini
Projeto de capa Marcela Pialarissi
Ilustrações de capa Cajila Barbosa
Coordenação de diagramação Adenilda Alves de França Pucca - Nil
Diagramação AVITS Estúdio Gráfico Ltda., EfeDois Editoração Ltda., Leandro
Júnior Pimenta
Autorização de recursos João Henrique Pedrão Feliciano
Iconografia Alessandra Roberta Arias, Vinícius Costa (trat. imagens)
Objetos digitais
Gerência de produção Erick Lopes de Almeida
Roteiros Renan Alves
Edição de imagens Leticia Nakadomari
Desenvolvimento Ohanna Schmitt Bolfe, Tatiana Tissa Kawakami
Dados Internacionais de Catalogação na Publicação (CIP) (Câmara Brasileira do Livro, SP, Brasil)
Plantar ciências da natureza : 4º ano : anos iniciais do ensino fundamental / organizadora Editora Novo Rumo ; obra coletiva concebida, desenvolvida e produzida pela Editora Novo Rumo ; editora responsável Ana Carolina Navarro dos Santos Ferraro. -- 1. ed. -- Londrina, PR : Editora Novo Rumo, 2025. Componente curricular: Ciências da natureza.
ISBN 978-65-5158-090-1(livro do estudante)
ISBN 978-65-5158-092-5(livro do professor)
ISBN 978-65-5158-094-9(livro do estudante HTML5)
ISBN 978-65-5158-105-2(livro do professor HTML5)
1. Ciências da natureza (Ensino fundamental) I. Ferraro, Ana Carolina Navarro dos Santos. II. Série.
CDD-372.35
25-299222.0
Índices para catálogo sistemático:
1. Ciências da natureza : Ensino fundamental 372.35 Eliete Marques da Silva - Bibliotecária - CRB-8/9380
Reprodução proibida: Art. 184 do Código Penal e Lei 9.610 de 19 de fevereiro de 1998. Todos os direitos reservados à EDITORA NOVO RUMO.
Avenida Doutor Adhemar Pereira de Barros, 1500, sala 804 - Bela Suíça - Londrina-PR CEP 86047-250 - Tel. (43) 3367-2030 contato@editoranovorumo.com.br
Elaboração de originais
Ana Carolina Navarro dos Santos Ferraro
Mestra em Patologia Experimental pela Universidade Estadual de Londrina (UEL-PR).
Licenciada e bacharela em Ciências Biológicas pela Universidade Estadual de Londrina (UEL-PR).
Licenciada em Pedagogia pela Universidade Pitágoras Unopar Anhanguera.
Editora e elaboradora de materiais didáticos.
Angélica Alves de Paula
Doutora e mestra em Ciências Biológicas pela Universidade Estadual de Londrina (UEL-PR).
Licenciada e bacharela em Ciências Biológicas pela Universidade Estadual de Londrina (UEL-PR). Elaboradora e editora de materiais didáticos.
Luciana Maria Garcia
Especialista em Neuropedagogia pelas Faculdades Integradas do Vale do Ivaí (Univale-PR).
Especialista em Educação especial: atendimento às necessidades especiais pelas Faculdades Integradas do Vale do Ivaí (Univale-PR).
Especialista em Psicopedagogia Institucional pela Universidade Norte do Paraná (Unopar-PR).
Licenciada e bacharela em Física pela Universidade Estadual de Londrina (UEL-PR).
Atua como professora em escolas do Ensino Básico. Elaboradora e editora de materiais didáticos.
Marcela Yaemi Ogo
Mestra em Ensino de Ciências e Educação Matemática pela Universidade Estadual de Londrina (UEL-PR).
Especialista em Biologia Aplicada à Saúde pela Universidade Estadual de Londrina (UEL-PR).
Especialista em Análise e Educação Ambiental em Ciências da Terra pela Universidade Estadual de Londrina (UEL-PR).
Especialista em Psicopedagogia Institucional, Clínica e TGD pela Faculdade Futura (SP).
Licenciada em Ciências Biológicas pela Universidade Estadual de Londrina (UEL-PR).
Licenciada em Pedagogia pelo Centro Universitário Facvest (Unifacvest-SC).
Licenciada em Matemática pela Faculdade Educacional da Lapa (FAEL-PR).
Atua como professora em escolas do Ensino Básico. Elaboradora e editora de materiais didáticos.
Em respeito ao meio ambiente, as folhas deste livro foram produzidas com fibras obtidas de árvores de florestas plantadas, com origem certificada.
Impresso no Parque Gráfico da Editora FTD CNPJ 61.186.490/0016-33
Avenida Antonio Bardella, 300 Guarulhos-SP – CEP 07220-020 Tel. (11) 3545-8600 e Fax (11) 2412-5375
01/10/2025 10:15:24
APRESENTAÇÃO
Olá, estudante!
Na vida, a gente aprende e ensina o tempo todo. Provavelmente, você já aprendeu muito com sua família, seus professores e amigos.
Neste livro, há momentos tanto para você compartilhar o que já viveu quanto para fazer novas descobertas. Você vai ler e produzir textos, buscar respostas para questões relacionadas ao mundo contemporâneo, com base nos conhecimentos da Ciências da Natureza, além de refletir sobre essas questões e propor soluções para elas. Também vai investigar alguns fenômenos naturais e aprender como eles ocorrem, conhecer como funcionam certos processos sociais e culturais, entre outros assuntos. Esperamos que você interaja com seus colegas e participe das atividades de maneira engajada, desenvolvendo a curiosidade e o gosto por novas descobertas. Lembre-se de que poderá tirar as suas dúvidas com o professor.
Aproveite cada momento para tornar esse aprendizado mais amplo e divertido.
CONHEÇA SEU LIVRO
A seguir, apresentamos a organização do seu livro e indicamos como isso vai ajudar em seus estudos.


VAMOS INICIAR
Essa seção apresenta atividades que servem para você mostrar o que já sabe sobre os conteúdos que serão estudados ao longo do livro.




Bom estudo!




DESENVOLVIMENTO DO CONTEÚDO
Os conteúdos estão organizados em temas e são apresentados por meio de atividades que servem para você mostrar o que já sabe sobre e o que compreendeu a respeito dele.
VAMOS INVESTIGAR

Essa seção apresenta uma proposta de investigação que envolve o conteúdo estudado na unidade.
PÁGINAS DE ABERTURA
Nessas páginas, você vai encontrar uma imagem e um texto sobre o que será estudado na unidade, bem como questões que exploram a imagem e o que você já sabe do conteúdo.
ENTRE TEXTOS
Nessa seção, você vai trabalhar com diferentes gêneros textuais relacionados ao conteúdo estudado na unidade, desenvolvendo práticas de linguagem.





COLETIVAMENTE
Essa seção apresenta temas importantes relacionados a situações do cotidiano e ao conteúdo estudado, contribuindo para a formação de cidadãos críticos e atuantes na sociedade.

BOXE COMPLEMENTAR
Nesse boxe, você encontra algumas informações adicionais que complementam o conteúdo estudado.
VOCABULÁRIO
Esse boxe apresenta o significado de algumas palavras para ajudar na compreensão do conteúdo. Essas palavras estão destacadas nos textos.
VAMOS AVALIAR O APRENDIZADO
Essa seção está localizada ao final de cada unidade e apresenta atividades que servem para você avaliar o que você compreendeu sobre os conteúdos estudados ao longo da unidade.











VAMOS CONCLUIR
Essa seção apresenta atividades que servem para você mostrar seu progresso na aprendizagem.
ÍCONES E DESTAQUES
RESPOSTA ORAL
Indica atividades e questões que você pode responder oralmente.
RESPOSTA CADERNO
Indica atividades e questões que você pode responder no caderno.
OBJETOS DIGITAIS
Indica que há, na versão digital deste livro, um infográfico clicável relacionado ao conteúdo.
REFERÊNCIAS BIBLIOGRÁFICAS COMENTADAS
Essa seção contém as referências de livros, revistas e sites que foram utilizados na elaboração do seu livro.
SAIBA MAIS
Essa seção apresenta sugestões de livros, sites, filmes, entre outros recursos relacionados com os conteúdos estudados ao longo do livro.
Dica
Apresenta dicas que podem facilitar a resolução de algumas atividades.
Atenção
Apresenta cuidados que devem ser tomados ao realizar algumas atividades.
Os sites indicados neste livro podem mostrar imagens e textos diferentes dos que foram pensados para o seu estudo. Isso acontece porque o conteúdo disponível on-line pode ser alterado com o tempo e variar conforme o histórico de pesquisa do usuário. Por isso, não temos como controlar as imagens e textos que aparecem em tais sites
TEMA 13 • DOENÇAS CAUSADAS POR SERES MICROSCÓPICOS E SUA PREVENÇÃO 81
COLETIVAMENTE • Vacinação e desinformação 85
VAMOS INVESTIGAR 90
VAMOS AVALIAR O APRENDIZADO 94
UNIDADE MISTURAS NO DIA A DIA ......................... 98 4
TEMA 14 • SANEAMENTO BÁSICO 100
TEMA 15 • TRATAMENTO DA ÁGUA 102
VAMOS INVESTIGAR 102
TEMA 16 • TRATAMENTO DE ESGOTO 108 ENTRE TEXTOS 112
TEMA 17 • COLETA DE RESÍDUOS SÓLIDOS 114
COLETIVAMENTE • Situação do saneamento básico no Brasil 120
TEMA 18 • MISTURAS 122
TEMA 19 • SEPARAÇÃO DE MISTURAS 126
VAMOS INVESTIGAR 126
VAMOS CONCLUIR 139
SAIBA MAIS 141 REFERÊNCIAS BIBLIOGRÁFICAS COMENTADAS 143
OBJETOS DIGITAIS INFOGRÁFICO CLICÁVEL: A LOCALIZAÇÃO VIA SATÉLITE 14
INFOGRÁFICO CLICÁVEL: COMPOSTAGEM 47
INFOGRÁFICO CLICÁVEL: OS MICRORGANISMOS COMO CAUSADORES DE DOENÇAS 81
INFOGRÁFICO CLICÁVEL: PREVENÇÃO E CONTROLE DA COVID-19 93
INFOGRÁFICO CLICÁVEL: SANITIZAÇÃO DOS ALIMENTOS 111
INFOGRÁFICO CLICÁVEL: DESTILAÇÃO DO PETRÓLEO 131
VAMOS AVALIAR O APRENDIZADO 135 7
01/10/2025 08:51:32
BNCC
• A atividade 1 leva os estudantes a reconhecerem que as mudanças de posição da sombra de um objeto ao longo do dia ocorrem em razão da mudança de posição aparente do Sol no céu, um pré-requisito para o desenvolvimento da habilidade EF04CI09
• A atividade 2 permite verificar o conhecimento dos estudantes sobre os estados físicos dos materiais, um pré-requisito para o desenvolvimento das habilidades EF04CI02 e EF04CI03
• A atividade 3 leva os estudantes a verificarem características observáveis de misturas, iniciando o trabalho com a habilidade EF04CI01
1. Objetivo
• Relacionar a mudança de tamanho e posição das sombras de um objeto, ao longo do período do dia, à mudança de posição aparente do Sol no céu.
Sugestão de intervenção
Para auxiliar os estudantes, faça uma demonstração no pátio da escola. Para isso, providencie uma garrafa e posicione-a em um local com incidência de luz solar. Solicite que observem a sombra e marquem com giz o local onde ela é projetada. Repita o mesmo procedimento após uma hora e novamente depois de duas horas. Por fim, questione sobre o que observaram e quais foram as razões para a sombra mudar de posição.
2. Objetivos
• Reconhecer os estados físicos da água.
• Identificar a mudança de estado físico da água quando exposta à condição de aquecimento.
Sugestão de intervenção
Pergunte aos estudantes se eles já colocaram água líquida no congelador para obter gelo e se ao deixar o gelo em um local em tem-
2. a) Resposta: Gota de água – estado líquido; gelo – estado sólido; vapor de água – estado gasoso.
VAMOS INICIAR
1. Observe a fotografia.
a ) O que acontecerá com a sombra projetada pelo objeto ao longo do período do dia?
b ) Explique por que isso acontece.
Escreva as respostas no caderno.
1. a) Resposta: A sombra projetada pelo objeto mudará de tamanho e de posição.
Ampulheta em uma praia.
2. A água pode estar presente em nosso cotidiano em três estados físicos diferentes: líquido, sólido e gasoso.
a ) No caderno, identifique o estado físico da água em cada uma das condições indicadas na imagem.
b ) Se o copo for mantido onde está, o que acontecerá com o gelo com o passar do tempo?


3. Observe as misturas A e B da fotografia.

Copo com água e gelo.
Imagens sem proporção entre si.
2. b) Resposta: O gelo derreterá (sofrerá fusão), passando do estado sólido para o estado líquido.
água + sal
água + óleo
Misturas de água e sal e de água e óleo.
a ) Em qual delas não é possível observar os dois componentes da mistura? Por quê?
Resposta: Na mistura de sal e água, pois o sal está dissolvido na água.
b ) Qual das técnicas a seguir é mais adequada para separar os componentes da mistura A?
• Evaporação.
Resposta: Evaporação.
• Filtração.
• Peneiração.
1. b) Resposta: A mudança de tamanho e posição da sombra projetada pela ampulheta ao longo do dia é resultado da mudança de posição aparente do Sol no céu, que ocorre em função do movimento de rotação da Terra.
peratura ambiente até o dia seguinte ele sofrerá mudança. Caso eles respondam que o gelo vai derreter, questione o fator responsável por essa mudança.
3. Objetivo
• Identificar misturas homogêneas e heterogêneas e técnicas adequadas à separação dos componentes de uma mistura.
Sugestão de intervenção
Reproduza em sala de aula as misturas A e B mostradas na atividade e execute algumas das técnicas de separação de misturas listadas no item b. Para isso, providencie quatro copos
transparentes, uma colher, uma peneira, filtro de papel, funil, água, sal e óleo. Prepare as misturas A e B e oriente os estudantes a observá-las antes de responder ao item a. Na sequência, posicione a peneira sobre um dos copos vazios e passe a mistura A por ela. Reproduza novamente a mistura A. Posicione o filtro de papel e o funil sobre o outro copo vazio, passando a mistura pelo filtro. Verifique se os estudantes constatam que a filtração e a peneiração não são adequadas para a separação dos componentes da mistura de sal e água.
A. B.
A.
4. a) Resposta: A anta é um animal herbívoro. Ela obtém os nutrientes e a energia que necessita ao se alimentar de frutos e outras partes das plantas.
4. O esquema a seguir representa relações alimentares que ocorrem entre alguns seres vivos. No caderno, utilize as palavras do esquema para completar as frases a e b. Na sequência, responda ao item c
4. b) Resposta: A onça-pintada é um animal carnívoro e, portanto, para nutrir-se, se alimenta de outros animais, como a anta



frutos anta onça-pintada
Representação de relações alimentares entre alguns seres vivos.
Imagem com elementos sem proporção entre si. Cores fantasia.
a ) A ▲ é um animal herbívoro. Ela obtém os nutrientes e a energia que necessita ao se alimentar de ▲ e outras partes das plantas.
b ) A ▲ é um animal carnívoro e, portanto, para nutrir-se, se alimenta de outros animais, como a ▲
c ) Como as plantas obtêm os nutrientes e a energia necessários a sua manutenção, seu crescimento e seu desenvolvimento?
Resposta: Por meio da fotossíntese.
5. A imagem a seguir representa a transformação de uma laranja, ao longo do tempo, causada pela ação de certos organismos.

Laranja em diferentes estágios de decomposição.
a ) Quais organismos são responsáveis por essa transformação?
Resposta: Fungos e bactérias.
b ) Essa transformação pode ser revertida?
Resposta: Não. Trata-se de uma transformação irreversível.
6. Bactérias, vírus, protozoários e alguns fungos são microrganismos. Escreva no caderno apenas as afirmações corretas sobre eles.
a ) Os microrganismos podem ser vistos a olho nu, ou seja, sem o auxílio de equipamentos de ampliação.
b ) A gripe é uma doença causada por vírus.
c ) O acesso a serviços de saneamento básico, como tratamento de água, pode ajudar na prevenção de doenças causadas por microrganismos.
Resposta: Afirmações b e c
BNCC
• A atividade 4 incentiva os estudantes a identificarem como alguns seres vivos obtêm os nutrientes e a energia de que necessitam, pré-requisito para o desenvolvimento da habilidade EF04CI04
• A atividade 5 leva os estudantes a reconhecerem a participação de fungos e bactérias na decomposição da matéria orgânica, colaborando para o desenvolvimento da habilidade EF04CI06
• A atividade 6 permite identificar alguns conhecimentos prévios dos estudantes sobre características dos microrganismos e a prevenção de doenças causadas por eles, iniciando o trabalho com a habilidade EF04CI08
4. Objetivos
• Reconhecer relações alimentares entre seres vivos.
• Identificar como as plantas obtêm os nutrientes e a energia de que necessitam para manutenção, crescimento e desenvolvimento.
Sugestão de intervenção
Escreva na lousa as palavras carnívoro, herbívoro e onívoro e retome o significado delas. Depois, comente que as setas do esquema indicam as relações alimentares entre os seres vivos representados nele, partindo do ser vivo que é consumido em direção àquele que o consome. Ao abordar o item c, relembre-os de que a maioria das plantas é capaz de produzir o próprio alimento e questione-os como elas fazem isso. Se necessário, retome com os estudantes a fotossíntese.
5. Objetivo
• Reconhecer a participação dos microrganismos na decomposição de matéria orgânica.
Sugestão de intervenção
No item a, solicite que os estudantes observem as duas laranjas à direita da fotografia. Questione sobre a presença da mancha verde e branca nelas, verificando se eles as identificam como fungos e se
reconhecem o papel desses microrganismos na decomposição da laranja. Comente que algumas bactérias também são decompositoras. No item b, incentive os estudantes a observarem as laranjas da direita para a esquerda e pergunte a eles se essa é uma transformação possível de ocorrer.
6. Objetivo
• Identificar características dos microrganismos e sua associação com doenças.
Sugestão de intervenção
Para auxiliar os estudantes a julgarem o item a, mostre a eles algumas micro-
01/10/2025 09:14:22
grafias de microrganismos da unidade 3 deste volume, orientando que identifiquem na legenda das fotografias o aumento utilizado para a obtenção delas. No item b, questione-os sobre o que causa a gripe. Caso eles respondam que as baixas temperaturas podem causar a doença, diga que, apesar de ficarmos mais suscetíveis a ter gripe no inverno por diversos motivos, ela é causada por um vírus. No item c, comente que uma das etapas do tratamento de água consiste na eliminação de microrganismos, sendo alguns deles causadores de doenças.
CLOUD-WALKER/ SHUTTERSTOCK.COM
YANYA/SHUTTERSTOCK.COM
OBJETIVOS
DA UNIDADE
• Conhecer diferentes formas de se orientar geograficamente.
• Construir um instrumento para auxiliar na orientação geográfica.
• Compreender que a Terra gira em torno do próprio eixo e que a ocorrência dos dias e das noites está relacionada a esse movimento.
• Investigar o que acontece nas diferentes regiões da Terra conforme ela realiza o movimento de rotação.
• Compreender que o movimento de translação da Terra está associado à ocorrência das estações do ano.
• Investigar a mudança aparente da face iluminada da Lua observada na Terra em cada mês.
• Conhecer o ciclo da Lua.
• Compreender como um calendário é construído e identificar as informações presentes nele.
• Nesta unidade, são trabalhadas as principais formas de orientação geográfica com base nas características da Terra e no movimento dos astros, além dos movimentos que a própria Terra realiza e suas influências na ocorrência dos dias e nas estações do ano. Além disso, são abordados o ciclo lunar e a elaboração de calendários por diferentes povos.
• O tema 1 aborda os diferentes meios que o ser humano pode utilizar para se orientar geograficamente.
• Os temas 2 e 3 abordam os movimentos realizados pela Terra: rotação e translação.
• O tema 4 aborda os momentos do ciclo lunar: lua nova, quarto crescente, lua cheia e quarto minguante. Já o tema 5 trabalha a importância do calendário para o ser humano e os que foram elaborados por diferentes povos.
1 A MOVIMENTAÇÃO DOS ASTROS E A NOSSA
ORIENTAÇÃO NO TEMPO E NO ESPAÇO
Cotidianamente, o Sol surge no horizonte, dando início ao período do dia; ao se pôr, inicia-se o período da noite, em que se podem observar outros astros no céu, como as estrelas e a Lua.
A observação do céu e dos astros celestes, bem como a regularidade de fenômenos naturais, como a sucessão dos dias e da noite e o nascer e o pôr do sol, sempre despertou o interesse da humanidade. Compreender esses e outros fenômenos nos aproxima da forma de pensar o mundo de diferentes povos e épocas, além de entender nosso dia a dia na Terra.

Fotografia da Caatinga na Serra da Capivara, tirada às 10 horas, no município de Coronel José Dias, no Piauí, em 2024.
1.
2.
3.

Respostas
Respostas nas orientações ao professor.
Compare as fotografias das páginas 10 e 11, com base nelas, o que ocorreu com o Sol no período de um dia?
Como você explica o fenômeno observado nas fotografias?
Em sua opinião, o fenômeno observado nas fotografias pode nos ajudar a marcar a passagem do tempo e a nos orientarmos geograficamente?
1. Espera-se que os estudantes respondam que é possível perceber uma mudança aparente na posição do Sol no céu ao longo do período de um dia.
2. Resposta pessoal. Espera-se que os estudantes relacionem o movimento aparente do Sol no céu com o movimento de rotação do planeta Terra.
3. Resposta pessoal. O objetivo desta questão é levar os estudantes a refletirem sobre a importância de compreender a regularidade do movimento aparente do Sol no céu. Por meio da compreensão desse fenômeno, pode-se marcar
Fotografia da Caatinga na Serra da Capivara, tirada às 16 horas, no município de Coronel José Dias, no Piauí, em 2024.
• Inicie a abordagem desta unidade incentivando os estudantes a observarem as fotografias das páginas de abertura. Pergunte qual astro está em evidência nessas imagens. Oriente-os a ler as legendas das imagens para constatarem que se trata de fotografias tiradas no mesmo local em horários diferentes do dia. Em seguida, peça-lhes que notem o que aconteceu com o Sol ao compararem as duas imagens. Verifique se percebem que a posição aparente do Sol mudou ao longo do dia.
• A questão 2 possibilita levantar os conhecimentos prévios dos estudantes em relação ao movimento de rotação da Terra. Incentive a troca de ideias entre eles e acolha as respostas. Se julgar interessante, anote essas respostas para retomá-las ao final da abordagem sobre os movimentos da Terra, fazendo as correções necessárias.
• Na questão 3, incentive os estudantes a trocarem ideias, favorecendo o engajamento e o diálogo respeitoso. Incentive-os a acolher as ideias e os argumentos dos colegas, contribuindo para o desenvolvimento da Competência geral 9 da BNCC.
01/10/2025 09:15:31
a passagem do tempo, orientar-se geograficamente e desenvolver instrumentos de localização e marcação temporal.
FOTOS: FABIO
BNCC
• As atividades desta página favorecem o desenvolvimento da habilidade EF04CI09 , pois fornece subsídios para os estudantes identificarem os pontos cardeais com base no registro das posições aparentes do Sol.
• As atividades desta página incentivam os estudantes a analisarem situações com base em conhecimentos científicos, contribuindo para desenvolver a Competência específica de Ciências da Natureza 3
SUGESTÃO DE ESTRATÉGIA INICIAL
Antes de iniciar a leitura desta página, peça aos estudantes que citem situações em que precisaram de informações para encontrar determinado local e que expliquem como procederam. Eles podem comentar que utilizaram, por exemplo, GPS ou mapas ou que pediram informações a alguém. O objetivo dessa discussão é levá-los a perceber que há diversas maneiras de nos orientarmos geograficamente, mas que em todas precisamos saber as direções a seguir.
• Para auxiliar os estudantes na questão 1 , peça a eles que analisem a situação e identifiquem elementos que possam ajudar os personagens a encontrar a direção que devem seguir na trilha, como o mapa. Talvez não consigam relacionar a análise da posição aparente do Sol no céu à determinação das direções que os personagens devem seguir na trilha. Nesse momento, questione-os se, sabendo que o Sol surge ao amanhecer aproximadamente na direção Leste e se põe aproximadamente na direção Oeste, é possível se orientar geograficamente observando a posição apa-
1. Resposta pessoal. Espera-se que os estudantes respondam que eles podem se localizar usando o mapa e a posição aparente do Sol no céu no período vespertino.
1 ORIENTAÇÃO GEOGRÁFICA
Romano e os filhos decidiram percorrer uma trilha no fim de semana. Observe essa situação na imagem e responda à questão a seguir.
1. Com base na situação, como a família de Romano pode identificar a direção em que devem seguir na trilha?
Imagem com elementos sem proporção entre si. Cores fantasia.
Papai, segundo o mapa, devemos seguir para a direção Norte!
São 15 horas agora.
Podemos determinar as direções Norte, Sul, Leste e Oeste por meio da observação da posição aparente do Sol no céu.
Romano e seus filhos percorrendo uma trilha

2. Observe a situação a seguir, em que Lucas está na escola, e responda quais sentenças são falsas e quais são verdadeiras.

Imagem com elementos sem proporção entre si. Cores fantasia.
rente do Sol no céu e o horário no relógio, como fez o personagem Romano.
• Na questão 2, se julgar interessante, antes de ler as sentenças, peça aos estudantes que identifiquem os elementos que estão nas direções Leste, Oeste, Norte e Sul em relação a Lucas. Anote as respostas na lousa. Em seguida, oriente-os a julgar as sentenças com base nos levantamentos feitos anteriormente.
ATIVIDADE EXTRA
• Depois de realizar a atividade 2, antes das 10 horas da manhã, leve os estudantes para o pátio da escola e peça-lhes que se posicionem
O braço direito de Lucas aponta para a direção em que o Sol surge no horizonte ao amanhecer, que é, aproximadamente, a direção Leste. A direção oposta, apontada pelo braço esquerdo de Lucas, é a Oeste. A direção à frente dele é a Norte e atrás, a Sul.
A. B. C.
A biblioteca está localizada na direção Norte.
O banco está localizado na direção Norte.
As lixeiras estão localizadas na direção Oeste.
Resposta: A: Verdadeira; B: Falsa; C: Verdadeira.
como o personagem Lucas, representado na imagem. Solicite a eles que registrem a posição de alguns locais da escola com base na direção aproximada em que o Sol surge no horizonte ao amanhecer.
• Oriente os estudantes a passarem protetor solar e permanecerem expostos à luz solar somente pelo tempo necessário para a realização da atividade.
09:15:32
Lucas na escola.
Além da observação da posição aparente do Sol no céu, podemos nos orientar geograficamente de diferentes maneiras. Vamos estudar algumas delas a seguir.
3. Ao observar um mapa, como podemos localizar as direções Norte, Sul, Leste e Oeste?
Brasil: Divisão política
Fonte de pesquisa: ATLAS geográfico escolar. 9. ed. Rio de Janeiro: IBGE, 2023. p. 93.
Como pudemos observar no mapa, há uma representação que contém os pontos cardeais: Norte (N), Sul (S), Leste (L) e Oeste (O). Essa representação é chamada de rosa dos ventos. Nela, também podem estar representados os pontos colaterais: Nordeste (NE), Noroeste (NO), Sudeste (SE) e Sudoeste (SO).
3. Resposta: Espera-se que os estudantes respondam que isso é possível por meio da observação da rosa dos ventos.
gráfico em outro instrumento de orientação, além do mapa, levantando os conhecimentos prévios deles a respeito da bússola.
• Caso haja estudantes com deficiência visual na sala de aula, e se julgar conveniente, elabore com a turma um mapa tátil do Brasil, mostrando as diferentes regiões do país. É importante que rosa dos ventos, legenda e escala sejam contempladas nesse mapa. Para auxiliá-los nesta atividade, acesse os materiais disponíveis nas Referências complementares a seguir.
N L
O S NE NO SE SO
REFERÊNCIAS COMPLEMENTARES
CASTANHA, Rafaela da Silva; PANCHER, Andréia M. A importância da cartografia tátil na construção e representação espacial do aluno com deficiência visual no ensino regular de Geografia. In: ENCONTRO REGIONAL DE ENSINO DE GEOGRAFIA, 7., Campinas, 2021. Anais... Campinas: Apegeo/AGB, 2021. p. 148-155. Nesse material, é apresentada a elaboração de rosas dos ventos táteis. PASSO a passo: produção de mapas
BNCC
• A abordagem sobre a rosa dos ventos favorece o desenvolvimento da habilidade EF04CI09, pois fornece subsídios para que os estudantes identifiquem os pontos cardeais.
ARTICULANDO CONHECIMENTOS
Se julgar interessante, faça uma integração com o componente curricular de Geografia. Peça aos estudantes que identifiquem os elementos cartográficos presentes no mapa do Brasil, apresentado nesta página, como título, legenda, mapa de localização, escala e representação gráfica dos pontos de orientação (rosa dos ventos). Aproveite o momento e encontre um mapa do município onde os estudantes vivem e localize com eles as zonas norte, sul, leste e oeste, citando exemplos de locais em cada uma dessas áreas.
• Na questão 3, se os estudantes tiverem dificuldade em identificar os pontos cardeais no mapa, mostre a eles diversos mapas e peça-lhes que localizem o elemento cartográfico que indica as direções em cada um. Verifique se conseguem identificar a rosa dos ventos e reconhecer que as letras indicam as direções, ou seja, os pontos cardeais. Pergunte se já viram esse elemento
09:15:32
táteis para pessoas com deficiência visual. IBGE Educa . Disponível em: https://educa.ibge.gov.br/professores/ educa-recursos/20774-passo-a-passoproducao-de-mapas-tateis-parapessoas-com-deficiencia-visual.html. Acesso em: 9 ago. 2025. Nesse site, é apresentado o passo a passo para elaboração de um mapa tátil do Brasil.
OCEANO ATLÂNTICO
Trópico de Capricórnio
Equador
Rosa dos ventos
BNCC
• A abordagem sobre a bússola contribui para o desenvolvimento da habilidade EF04CI09, pois fornece subsídios para que os estudantes identifiquem os pontos cardeais obtidos por meio dela.
• A abordagem sobre o GPS possibilita o trabalho com o tema contemporâneo transversal Ciência e tecnologia
• Ao iniciar a abordagem desta página, leve para a sala de aula uma ou mais bússolas para os estudantes manusearem. Solicite-lhes que identifiquem os pontos cardeais no mostrador da bússola e que a girem para observar a movimentação da agulha imantada. Verifique se percebem que a direção da agulha imantada permanece enquanto giram a bússola.
• Explique aos estudantes como podemos utilizar a bússola para encontrar as direções Norte, Sul, Leste e Oeste.
• Comente com eles que há aplicativos de celular que simulam o funcionamento de bússolas. Se possível, mostre um em funcionamento e compare-o com uma bússola física.
Outra maneira de determinar os pontos cardeais e colaterais é utilizando instrumentos de orientação, como a bússola. Ela é composta de uma agulha imantada que gira livremente e que apresenta um destaque em uma de suas extremidades. Essa agulha sofre influência do campo magnético da Terra.
Imantada: que tem características magnéticas e se comporta como um ímã.
Os polos magnéticos da Terra são próximos aos polos geográficos. Quando a agulha se alinha ao campo magnético terrestre, ela indica, aproximadamente, a direção norte-sul geográfica.

Na bússola apresentada:
N: Norte
NE: Nordeste
L: Leste
SE: Sudeste
NO: Noroeste
O: Oeste
SO: Sudoeste
S: Sul
agulha imantada
Estima-se que a bússola seja uma invenção chinesa. No entanto, ela foi introduzida na Europa pelos árabes e passou a ser bastante utilizada na navegação. Uma das maneiras de orientação geográfica mais utilizadas atualmente é por meio de aplicativos nos aparelhos celulares com o Sistema de Posicionamento Global, o chamado GPS.
Professor, professora: GPS é a sigla em inglês para Global Positioning System.

INFOGRÁFICO CLICÁVEL: A LOCALIZAÇÃO VIA SATÉLITE
Pessoa usando aplicativo de celular com GPS.
4. Você e seus familiares já usaram o GPS para se orientarem? Conte aos colegas.
Resposta pessoal. O objetivo desta questão é levar os estudantes a compartilharem suas vivências com os colegas.
Bússola.
O GPS foi desenvolvido por cientistas estadunidenses e teve a contribuição da matemática, também estadunidense, Gladys Mae West. Gladys desenvolveu um programa de computador que modelou o formato geoide da Terra, o que contribuiu para a precisão do GPS.
A informação sobre a direção e o posicionamento de um local dado pelo GPS são obtidas por meio de sinais enviados por satélites artificiais.
Geoide: modelo físico da forma da Terra, que se caracteriza por apresentar achatamento nos polos, sendo quase esférica.
Professor, professora: Comente com os estudantes que, além do GPS, atualmente existem outros sistemas de navegação, como o sistema russo Glonass, o europeu Galileo e o chinês BeiDou (BDS).
Gladys Mae West (1930-), 2018.

AS GRANDES NAVEGAÇÕES E O CONHECIMENTO DO CÉU
Na época das Grandes Navegações, entre os séculos 15 e 17, a localização por meio de satélites ainda não era possível. Nesse período, o conhecimento do céu ajudava na orientação e localização dos navios.
O conhecimento das constelações e da periodicidade em que elas podiam ser observadas no céu era um fator que auxiliava na localização das embarcações.
No Hemisfério Norte, por exemplo, a estrela Polar (que faz parte da constelação Ursa Menor) era utilizada para localizar a direção norte geográfica.




BNCC
• A abordagem sobre Gladys Mae West favorece o desenvolvimento da Competência geral 1 e da Competência específica de Ciências da Natureza 1, pois leva os estudantes a compreenderem a Ciência da Natureza como empreendimento humano e valorizarem a contribuição dessa cientista para o conhecimento historicamente construído. Além disso, apresenta a eles uma profissão importante para a sociedade, levando-os a se apropriarem de conhecimentos e experiências que possibilitem entender as relações próprias do mundo do trabalho e fazer escolhas alinhadas ao projeto de vida, o que contribui para o desenvolvimento da Competência geral 6.











































































































































































Já no Hemisfério Sul, com base na constelação do Cruzeiro do Sul, era possível identificar a direção sul geográfica.


















































































































































































































































Para identificar a direção sul geográfica, prolonga-se o braço maior da cruz da constelação Cruzeiro do Sul por 4,5 vezes o seu tamanho (A) e, em seguida, traça-se uma reta vertical até o horizonte (B), localizando, assim, a direção sul (ponto cardeal Sul).
Representação do método utilizado para localizar a direção sul geográfica com base na constelação Cruzeiro do Sul.
Professor, professora: Comente com os estudantes que, para determinar a posição dos astros no céu, os viajantes utilizavam um instrumento chamado astrolábio. Com base na altura da estrela em relação ao horizonte, os navegadores conseguiam determinar sua posição no planeta.
• Enfatize para os estudantes a importância do trabalho desenvolvido pela cientista Gladys Mae West. Converse com eles sobre a biografia dessa personalidade científica e suas contribuições para a sociedade. Consulte o material a seguir para obter mais informações sobre o assunto.
• MULHERES que mudaram a engenharia e a ciência: Gladys West. Instituto de Engenharia, 22 out. 2018. Disponível em: https://www.institutodeengenharia.org.br/ site/2018/10/22/mulheres-que-mudaram -a-engenharia-e-a-ciencia-gladys-west/. Acesso em: 5 ago. 2025.
01/10/2025 09:15:40
• Leve para a sala de aula um aparelho GPS ou um celular com um aplicativo de GPS e mostre aos estudantes seu funcionamento.
• A abordagem sobre as Grandes Navegações e o conhecimento do céu também favorece o desenvolvimento da Competência geral 1 e da Competência específica de Ciências da Natureza 1, pois leva os estudantes a valorizarem e utilizarem os conhecimentos historicamente construídos e compreenderem o conhecimento científico como provisório, cultural e histórico.
constelação Cruzeiro do Sul
B.
Imagem com elementos sem proporção entre si. Cores fantasia.
BNCC
• O experimento proposto nesta página e na próxima contribui para o desenvolvimento da Competência geral 2 e das Competências específicas de Ciências da Natureza 2 e 3, pois, ao registrarem as posições que a sombra de um objeto tem em diferentes horários do dia, os estudantes realizam práticas e procedimentos de investigação científica para analisar fenômenos relativos ao mundo natural.
• Além disso, esse experimento contribui para o desenvolvimento das habilidades EF04CI09 e EF04CI10, pois incentiva os estudantes a identificarem os pontos cardeais com base no registro da sombra de uma vara (gnômon), bem como a compararem essas indicações com as obtidas por meio de uma bússola.
OBJETIVOS
• Identificar os pontos cardeais com base no registro de diferentes posições da sombra de uma vara (gnômon).
• Comparar as indicações dos pontos cardeais obtidas pela observação das sombras de uma vara (gnômon) com as de uma bússola.
• Caso o palito de churrasco seja pontiagudo, quebre essa extremidade.
• Na etapa A, uma possibilidade para encontrar o centro do quadrado de papelão é traçar suas duas diagonais. No ponto de encontro das duas diagonais, está o centro. Em seguida, as diagonais traçadas devem ser apagadas para não atrapalharem a realização de outras etapas da atividade.
• Explique aos estudantes que a ponta-seca é a parte do compasso sem o grafite. Coloque-a no centro do quadrado e auxilie os estudantes a traçarem a circunferência. Permita que ma-
VAMOS INVESTIGAR
a ) Imagine que você esteja em um lugar e precise se orientar pelos pontos cardeais, mas não tem um GPS. Que instrumento você poderia construir para ajudar na orientação?
Resposta nas orientações ao professor
b ) Em sua opinião, a observação das sombras de um objeto pode nos ajudar na orientação?
Resposta nas orientações ao professor
MATERIAIS NECESSÁRIOS
• 1 pedaço quadrado de papelão de 20 cm de lado
• compasso
• lápis
A.
D.
• régua
• espeto de madeira para churrasco sem ponta
• massa de modelar
Encontre o centro do quadrado de papelão com o auxílio da régua e marque um ponto.
B. C. Coloque o aparato em um local que receba incidência direta da luz solar durante todo o período da atividade. Ele deverá ficar nesse local durante toda a atividade.
E.
Peça a um adulto que coloque a ponta-seca do compasso nesse ponto. Faça uma circunferência de 8 cm de raio.
Peça ao adulto que fixe o espeto de madeira sobre o ponto marcado, utilizando a massa de modelar.
Às 10 horas da manhã, com o auxílio da régua, trace no papelão uma linha sobre a sombra do espeto. Indique o ponto 1 no local em que essa linha cruza a circunferência.

Pessoa traçando uma linha sobre a sombra do espeto e marcando o ponto 1 no aparato.
Atenção: Permaneça exposto à luz solar somente pelo tempo necessário para realizar as etapas, usando protetor solar, roupas claras, boné e óculos de sol.
nipulem o compasso somente nesse momento e sob sua supervisão, a fim de evitar acidentes.
• Para a etapa D, é essencial que o local escolhido não atrapalhe a passagem das pessoas.
• Enfatize para os estudantes que devem seguir as dicas de cuidado com a luz solar citadas na página.
• No item a, caso eles tenham dificuldade em responder ou sugiram utilizar diretamente a posição do Sol para determinar os pontos cardeais, enfatize que a questão solicita a construção de um dispositivo para se orientarem. Se julgar interessante, peça aos estudantes que façam uma pesquisa sobre quais outros instru-
mentos, além do GPS, podem auxiliar na orientação geográfica.
• No item b, é possível que os estudantes não citem o gnômon, mas leve-os a levantar hipóteses sobre a possibilidade de se orientarem pela sombra projetada por um objeto.
Respostas
a) Os estudantes podem mencionar um gnômon ou uma bússola, dependendo dos materiais disponíveis.
b) Espera-se que os estudantes respondam que sim, por meio da construção de um gnômon, por exemplo.
F. G. H.
Às 14 horas, repita o procedimento anterior, marcando o ponto 2
Utilizando a régua, trace uma linha passando pelos pontos 1 e 2.
Em seguida, encontre a metade da linha entre os pontos 1 e 2 e marque o ponto 3. Com a régua, faça uma linha que passa pelo centro da circunferência e pelo ponto 3. Essa linha indica, aproximadamente, a direção norte-sul geográfica. A linha que liga os pontos 1 e 2 representa, aproximadamente, a direção leste-oeste geográfica.

Marcação do ponto 3 no aparato.

Agora, responda às questões a seguir no caderno.
Respostas nas orientações ao professor.
1. Qual instrumento você pode utilizar para averiguar se as direções Leste e Oeste coincidem com suas observações? Explique como você pode fazer isso.
2. Agora, compare o aparato que você construiu a esse instrumento. O que você concluiu a partir disso?
3. Quais são as limitações do aparato que você construiu? Ele funcionaria em qualquer situação?
• Na etapa G, diga que o segmento de reta se refere à linha que vai do ponto 1 ao ponto 2. Para encontrar a metade dela, oriente os estudantes a usarem uma régua para medir seu comprimento e, em seguida, dividir o resultado por dois.
• Ao realizar a etapa H, os estudantes devem marcar, na linha traçada na etapa G, o ponto Norte na direção do espeto de madeira e o ponto Sul na parte inferior da linha. O ponto Leste deve ser marcado à direita; e o ponto Oeste, à esquerda, na reta perpendicular à primeira.
• Comente com os estudantes que o aparato montado por eles nesse experimento é chamado de gnômon.
Respostas
1. Uma bússola. Os estudantes podem responder posicionando-a na mesma direção norte-sul indicada pelo aparato e comparar as diferenças de direções.
2. Espera-se que os estudantes respondam que as direções indicadas pelo aparato coincidem, aproximadamente, com as indicadas pela bússola.
3. Espera-se que os estudantes respondam que o aparato não pode ser utilizado durante a noite ou em dias nublados ou chuvosos.
01/10/2025 09:15:41
Marcação do ponto 2 no aparato.
FOTOS:
BNCC
• O conteúdo desta página colabora para o desenvolvimento da habilidade EF04CI11, dado que os estudantes associam o movimento de rotação da Terra a períodos regulares do dia.
• Inicie a abordagem desta página perguntando aos estudantes o que acontece com a sombra da barra metálica do relógio de sol mostrado na fotografia ao longo do dia. Leve-os a compreender que a sombra muda de posição e de tamanho, dependendo da posição aparente do Sol no céu.
• Em seguida, peça-lhes que comparem o funcionamento do relógio de sol ao aparato que montaram na seção Vamos investigar das páginas 16 e 17. Verifique se percebem as semelhanças no funcionamento, relacionando o palito de churrasco à haste metálica e o mostrador do relógio ao quadrado de papelão. No relógio de sol, a sombra da haste é projetada no mostrador; no aparato (gnômon), a sombra do palito de churrasco (vara) é projetada no quadrado de papelão.
• Para auxiliar os estudantes na atividade 1, relembre-os da relação entre o funcionamento do gnômon e do relógio de sol. Leve-os a perceber que em ambos é possível marcar as horas do dia pela mudança de posição da sombra projetada por uma vara (haste). Pergunte a eles o que favorece a formação da sombra de um objeto. Verifique se relacionam isso ao impedimento da passagem da luz por um objeto opaco. Nesse momento, ajude-os a relacionar a mudança de posição da sombra de um objeto com o movimento aparente do Sol no céu. Leve-os a perceber que esse movimento está relacionado ao de rotação.
2 MOVIMENTO DE ROTAÇÃO DA TERRA TEMA
A fotografia mostra um relógio de sol cujo funcionamento é semelhante ao aparato que você montou na atividade prática anterior, o qual é chamado gnômon.
1. Escreva o texto a seguir no caderno substituindo os símbolos pelas palavras adequadas listadas no quadro.

de sol na cidade de Brasília, no Distrito Federal, em 2023.
Sol • movimento aparente • sombra • rotação • posição
O funcionamento do relógio de sol se baseia na mudança de ■ da ■ da vara, que ocorre por causa do ■ do ■ no céu. Isso é causado pelo movimento de ■ da Terra.
Resposta: O funcionamento do relógio de sol se baseia na mudança de posição da sombra da vara, que ocorre por causa do movimento aparente do Sol no céu. Isso é causado pelo movimento de rotação da Terra.
A Terra e os demais planetas do Sistema Solar movem-se ao redor do próprio eixo. Esse movimento é chamado de movimento de rotação da Terra e, associado à luz solar, possibilita a ocorrência dos dias e das noites. Observe o esquema a seguir. Note que a Terra gira ao redor de um eixo de rotação, levemente inclinado de Oeste para Leste.
Parte da Terra recebe luz solar, e nessa região é dia (A). Na outra parte, não há incidência direta dos raios solares e é noite (B).
Movimento de rotação da Terra

Representação do movimento de rotação da Terra com destaque para a incidência de luz solar na região A
Imagens com elementos sem proporção entre si. Cores fantasia.
Conforme a Terra realiza o movimento de rotação, a porção antes não iluminada se volta para o Sol, e ali passa a ser dia (B). Na porção oposta, passa a ser noite (A).
Movimento de rotação da Terra

Representação do movimento de rotação da Terra com destaque para a incidência de luz solar na região B
Relógio
Fonte de pesquisa: COMINS, Neil F.; KAUFMANN III, William J. Descobrindo o Universo Tradução de Eduardo Neto Ferreira. 8. ed. Porto Alegre: Bookman, 2010. p. 39.
eixo de rotação
eixo de rotação
Sol Sol Terra Terra sentido do movimento de rotação sentido do movimento de rotação
A Terra leva cerca de 24 horas para realizar uma volta completa ao redor do próprio eixo, o tempo aproximado de duração de um dia na Terra. O movimento aparente do Sol ocorre porque nos movemos com a Terra, dando a impressão de que é o Sol que se movimenta no céu.
2. Coloque o gnômon que você montou na atividade prática anterior em um local que receba luz solar o dia todo. Com uma régua e um lápis, marque a posição da sombra do palito, de hora em hora, entre às 8 horas e às 16 horas. Anote os horários na frente das marcações.
a ) O que você observou?
Atenção: Permaneça exposto à luz solar somente pelo tempo necessário para realizar as etapas, usando protetor solar, roupas claras, boné e óculos de sol.
Resposta: Espera-se que os estudantes respondam que a sombra projetada muda de posição a cada hora observada.
b ) A mudança nas sombras ocorreu no mesmo sentido do movimento aparente do Sol? Explique suas observações.
Resposta: Espera-se que
os estudantes respondam que ocorreu no sentido oposto. Isso acontece porque o relógio de sol mostra a sombra formada pela luz do Sol.
VAMOS INVESTIGAR
a ) O que você acha que ocorre nas regiões da Terra à medida que o planeta se movimenta ao redor do próprio eixo? Como você poderia investigar isso na prática?
Resposta nas orientações ao professor.
MATERIAIS NECESSÁRIOS
• globo terrestre
• lanterna
A.
B.
• massa de modelar de cores variadas
Fixe pedaços de massa de modelar em diferentes partes do globo. Em uma sala escura, coloque o globo no centro da mesa e acenda a lanterna. Enquanto isso, gire o globo vagarosamente e o observe.
Globo terrestre sendo iluminado por uma lanterna.

Agora, responda às questões a seguir no caderno.
Respostas nas orientações ao professor
1. O que a lanterna acesa representa nessa investigação?
2. A incidência de luz ocorre da mesma maneira em toda a porção iluminada?
toda a superfície terrestre diretamente, ao mesmo tempo, ou se pode haver diferenças nas áreas do planeta iluminadas pelo Sol. Pergunte também se a rotação da Terra influencia as áreas que estão expostas à iluminação.
• Na atividade 2, comente com os estudantes que, em outros dias, ao comparar a posição da sombra da vareta com as indicações das horas que fizeram no papelão, poderão determinar, aproximadamente, que horas são. Esse é o princípio de funcionamento do relógio de sol.
BNCC
• O experimento desta página contribui para o desenvolvimento da habilidade EF04CI11 , pois incentiva os estudantes a associarem o movimento de rotação do planeta Terra aos períodos do dia com base em procedimentos científicos, contribuindo, assim, para desenvolver também a Competência geral 2 e a Competência específica de Ciências da Natureza 2 Além disso, favorece o desenvolvimento da Competência específica de Ciências da Natureza 3, pois incentiva os estudantes a analisarem, compreenderem e explicarem fenômenos relativos ao mundo natural, como o movimento de rotação da Terra.
OBJETIVOS
• Relacionar o movimento da Terra à ocorrência dos dias e das noites.
• Simular o movimento de rotação da Terra.
não receber luz solar diretamente.
01/10/2025 09:15:44
• Posicione a lanterna de maneira que simule adequadamente a incidência de luz solar na Terra. Ela não deve estar posicionada para os polos, e sim na lateral do globo.
Resposta a) Espera-se que os estudantes respondam que ocorrem os dias e as noites. Eles podem sugerir montar uma maquete que apresente algo com formato esférico e que gire livremente para representar a Terra e seu movimento de rotação (um globo terrestre, por exemplo) e algo que represente o Sol (como a lanterna acesa).
• No item a, diga aos estudantes que a Terra tem formato aproximadamente esférico e que o Sol é a única estrela próxima o suficiente para iluminá-la. Portanto, questione se, em razão do formato do planeta, seria possível que o Sol iluminasse
• Procure fixar pedaços de massa de modelar em diferentes partes do globo, principalmente em países dos quais os estudantes já ouviram falar. É importante perceberem que, ao girar o globo simulando o movimento de rotação da Terra, diferentes locais do planeta passam a receber luz solar direta, enquanto outros passam a
Respostas
1. A lanterna acesa representa o Sol. 2. Não, pois um hemisfério recebe mais luz do que o outro. Ao direcionar a lanterna acesa para o globo terrestre e girá-lo vagarosamente, é possível observar que um hemisfério fica mais exposto aos raios solares do que o outro.
BNCC
• A abordagem das teorias sobre qual astro seria o centro do Universo contribui para o desenvolvimento da Competência geral 1 e da Competência específica de Ciências da Natureza 1, pois incentiva os estudantes a perceberem que o conhecimento científico é provisório e que se desenvolve ao longo da história.
• A abordagem sobre o movimento de translação da Terra contribui com o desenvolvimento da habilidade EF04CI11, pois leva os estudantes a associarem esse movimento a períodos regulares, como a contagem do ano.
SUGESTÃO DE ESTRATÉGIA INICIAL
Se julgar interessante, organize a turma em dois grupos. Peça a um dos grupos que leia sobre o geocentrismo e a respeito de não ser uma teoria aceita atualmente. Já o segundo grupo vai fazer o mesmo em relação ao heliocentrismo. Verifique se todos participam da conversa de maneira engajada e acolha as opiniões deles, corrigindo quando necessário.
Com esta atividade, é importante os estudantes compreenderem que atualmente sabemos que nem a Terra nem o Sol são o centro do Universo. Leve-os a perceber que a Ciência é uma construção humana, baseada em observações e experimentação, estando sujeita a mudanças ao longo do tempo conforme novos estudos.
3 MOVIMENTO DE TRANSLAÇÃO DA TERRA
Por muito tempo, houve entre os estudiosos, uma discussão sobre qual astro seria o centro do Universo, e algumas teorias tiveram destaque. Confira a seguir.
No geocentrismo, defendido pelo astrônomo grego Cláudio Ptolomeu (90-168), a Terra seria o centro do Universo, e os demais astros giravam ao seu redor.
No heliocentrismo, proposto pelo astrônomo polonês Nicolau Copérnico (1473-1543), o Sol era o centro do Universo, e os outros astros giravam ao redor da estrela.
Atualmente, nenhuma dessas teorias é aceita, pois estudos e observações realizados pela Astronomia científica permitiram compreender que os planetas do Sistema Solar, incluindo a Terra, se movimentam ao redor do Sol, e que, ainda assim, o Sol não é o centro do Universo.
O movimento que a Terra realiza ao redor do Sol é chamado de translação e leva cerca de 365 dias, o que equivale a cerca de um ano no planeta. Dessa forma, pode ser associado à contagem dos anos e à determinação das estações do ano na Terra.
Movimento de translação da Terra
sentido de translação Sol Terra Imagens com elementos sem proporção entre si. Cores fantasia.
Fonte de pesquisa: COMINS, Neil F.; KAUFMANN III, William J. Descobrindo o Universo. Tradução de Eduardo Neto Ferreira. 8. ed. Porto Alegre: Bookman, 2010. p. 39.
Representação do movimento de translação da Terra

Para entendermos como ocorrem as mudanças de estação ao longo do ano, precisamos conhecer os hemisférios Norte e Sul da Terra. Acompanhe a seguir.
Existe uma linha imaginária que divide o planeta Terra em dois hemisférios: a linha do equador. Acima dela, temos o Hemisfério Norte; e, abaixo, o Hemisfério Sul.
Fonte de pesquisa: ATLAS geográfico escolar. 9. ed. Rio de Janeiro: IBGE, 2023. p. 12.
Representação dos hemisférios Norte e Sul da Terra
Hemisférios terrestres

Hemisfério Norte
Hemisfério Sul
do equador
órbita
linha
1. Em sua opinião, ao longo de um ano, as diferentes regiões do planeta Terra recebem a mesma incidência de luz solar? Converse com os colegas. O movimento de translação da Terra e a inclinação do seu eixo de rotação fazem os hemisférios terrestres receberem diferentes intensidades de luz solar ao longo de um ano.
Essa diferença de intensidade de luz solar interfere nas características desses locais, como a temperatura, caracterizando as diferentes estações do ano. Observe a seguir.
20 ou 21 de março: Início da primavera no Hemisfério Norte e do outono no Hemisfério Sul. A luz solar incide nos dois hemisférios praticamente com a mesma intensidade.

Representação do movimento de translação da Terra no início do outono no Hemisfério Sul.
22 ou 23 de setembro: Início do outono no Hemisfério Norte e da primavera no Hemisfério Sul. A luz solar incide nos dois hemisférios praticamente com a mesma intensidade.

Representação do movimento de translação da Terra no início da primavera no Hemisfério Sul.
pesquisa:
20 ou 21 de junho: Início do verão no Hemisfério Norte e do inverno no Hemisfério Sul. A luz solar incide com menos intensidade no Hemisfério Sul do que no Hemisfério Norte.

Representação do movimento de translação da Terra no início do inverno no Hemisfério Sul.
21 ou 22 de dezembro: Início do inverno no Hemisfério Norte e do verão no Hemisfério Sul. A luz solar incide com mais intensidade no Hemisfério Sul do que no Hemisfério Norte. Imagens com elementos sem proporção entre si. Cores fantasia.

Representação do movimento de translação da Terra no início do verão no Hemisfério Sul.
1. Resposta pessoal. O objetivo desta questão é levantar os conhecimentos prévios dos estudantes sobre como a incidência de luz solar na Terra está relacionada às estações do ano.
Apague as luzes e feche as cortinas para que o ambiente fique escuro. Organize a sala de aula em círculo e posicione o abajur sobre uma carteira escolar no centro. Remova a cúpula do abajur e acenda a lâmpada, utilizando uma extensão elétrica, caso necessário. Esclareça aos estudantes que a lâmpada elétrica do abajur representará o Sol.
Peça a um estudante que segure o globo terrestre e se posicione próximo à carteira escolar com o abajur. Em seguida,
oriente-o a girar o globo terrestre lentamente para representar o movimento de rotação da Terra e andar lentamente ao redor da carteira, seguindo uma trajetória circular, para representar o movimento de translação.
Em seguida, peça à turma que observe a área do globo terrestre sendo iluminada diretamente pela luz da lâmpada elétrica à medida que o estudante se desloca ao redor do abajur.
Solicite ao estudante segurando o glo-
BNCC
• A questão 1 favorece o desenvolvimento da Competência geral 9, pois incentiva o diálogo entre os estudantes, promovendo o respeito sobre ponto de vista do outro e valorizando seus saberes.
AVALIANDO
Objetivo
• Verificar se os estudantes associam os movimentos da Terra à ocorrência dos dias e das noites e das estações do ano e percebem a importância desses movimentos.
Sugestão de intervenção
Ao final da abordagem desta página, pergunte aos estudantes: “O que aconteceria caso a Terra parasse de realizar os movimentos de rotação e translação?”. Espera-se que associem essa situação à interferência nos períodos regulares e comentem que não ocorreriam os dias e as noites nem as estações do ano.
ATIVIDADE EXTRA
Se julgar interessante, aproveite o globo terrestre utilizado na seção Vamos investigar da página 19 para fazer outra investigação, dessa vez para demonstrar a ocorrência das estações do ano. Além do globo terrestre, leve para a sala de aula um abajur.
01/10/2025 09:15:46
bo terrestre que pare em quatro posições diferentes. Você deverá indicar essa posição para ele de acordo com o esquema desta página. Para cada uma das posições, oriente os estudantes a observarem a incidência da luz nos hemisférios Norte e Sul, comentando a respeito da estação do ano em cada um deles. Verifique se percebem que a incidência de luz é diferente nas regiões da Terra acima e abaixo da linha do equador.
A.
C.
B.
D.
Fonte de
ATLAS geográfico escolar. 9. ed. Rio de Janeiro: IBGE, 2023. p. 13.
órbita
ILUSTRAÇÕES: ALEXANDRE DE SOUZA/ ARQUIVO DA EDITORA
BNCC
• A leitura da tirinha na atividade 2 contribui para desenvolver a Competência geral 4 e a Competência específica de Ciências da Natureza 6, uma vez que incentiva os estudantes a utilizarem diferentes linguagens, como a verbal e a visual, para obter informações que levem à compreensão do conteúdo e à produção de conhecimento.
ARTICULANDO
CONHECIMENTOS
Se julgar conveniente, realize um trabalho integrado com o componente curricular de Língua Portuguesa, explicando aos estudantes o que é o gênero textual tirinha. Pergunte se gostam e se têm o hábito de ler textos como esse. Em caso afirmativo, pergunte onde costumam ler tirinhas (em jornais, revistas, livros e/ou internet).
Solicite aos estudantes que leiam em voz alta cada um dos quadrinhos. Ao final da leitura, peça a eles que expliquem o que compreenderam da história.
Se julgar interessante, organize a turma em grupos e peça a cada um que crie uma tirinha com base nos movimentos de rotação ou de translação da Terra.
• Se os estudantes tiverem dificuldade em responder ao item a da atividade 2, pergunte a eles qual estação do ano está ocorrendo no local onde Armandinho vive. Depois que reconhecerem que é o inverno, pergunte se o personagem aparenta gostar do frio. Em seguida, questione se o inverno estaria ocorrendo em todos os lugares do mundo na mesma época. Caso não respondam corretamente, utilize um globo terrestre e uma lanterna para demonstrar que a quantidade de luz solar recebida em cada hemisfério é diferente. Assim,
2. a) Resposta: Porque Armandinho gosta do verão e, enquanto no Hemisfério Sul é inverno, no Hemisfério Norte é verão.
2. Leia em voz alta com os colegas a tirinha a seguir. Depois, responda em seu caderno às atividades propostas.

a ) Sabendo que Armandinho vive no Hemisfério Sul da Terra, por que ele gostaria de passar as férias de inverno no Hemisfério Norte?
b ) Se é primavera no Hemisfério Sul, qual é a estação do ano no Hemisfério Norte da Terra?
Resposta: Espera-se que os estudantes respondam que é o outono.
c ) Qual estação do ano está ocorrendo no Brasil neste momento? Escreva algumas características dessa estação no lugar onde você vive.
Resposta nas orientações ao professor
3. Pedro visitou o mesmo local algumas vezes durante diferentes estações e fez alguns registros fotográficos. Escreva no caderno uma diferença entre as fotografias A e B


A.enquanto é inverno no Hemisfério Sul (onde vive Armandinho) é verão no Hemisfério Norte (para onde Armandinho quer ir).
• Para auxiliar os estudantes na atividade 3, peça-lhes que examinem todos os componentes visíveis nas imagens, principalmente as árvores. Pergunte qual mudança pode ter ocorrido em razão da transição das estações do ano.
Resposta
2. c) A resposta dependerá da estação do ano vigente na data em que os estudantes realizarão a atividade. Eles podem citar características relacionadas à temperatura, à ocorrência de chuvas
Plátano: pode atingir cerca de 35 m de altura.
Plátanos durante o verão no município de Santa Maria, no Rio Grande do Sul, em 2025.
Resposta: Os estudantes podem citar que essas diferenças estão relacionadas às características das árvores do local visitado por Pedro. Durante o verão, os plátanos tinham folhas verdes em grande quantidade. Já no inverno, observam-se folhas secas e em pouca quantidade.
Plátanos durante o inverno no município de Santa Maria, no Rio Grande do Sul, em 2022.
e às mudanças que podem acontecer na vegetação e nos hábitos dos animais.
BECK, Alexandre. Armandinho um. Florianópolis: A. C. Beck, 2014. p. 40.
a) Resposta pessoal. O objetivo desta questão é levar os estudantes a refletirem sobre a relação entre a ocorrência de dias e noites e o movimento de rotação. Também é importante que eles avaliem que o tempo de translação é diferente.
ROTAÇÃO E TRANSLAÇÃO EM OUTROS PLANETAS
DO
SISTEMA SOLAR
a ) Você considera que a duração dos dias e das noites em Vênus é igual à da Terra? E a duração dos anos?
Assim como a Terra, os outros planetas do Sistema Solar realizam os movimentos de rotação e de translação. No entanto, a duração desses movimentos é diferente em cada planeta. Observe a seguir.
Tempos de rotação e translação dos planetas do Sistema Solar Planeta Rotação Translação
Mercúrio 58 dias terrestres 88 dias terrestres
Vênus 243 dias terrestres 224 dias terrestres
Marte 24,6 horas terrestres 687 dias terrestres
Júpiter 9,6 horas terrestres 4 333 dias terrestres
Saturno 10 horas terrestres 29 anos terrestres
Urano 17 horas terrestres 84 anos terrestres
Netuno 16 horas terrestres 164 anos terrestres
Fonte de pesquisa: PLANET compare. Solar System Exploration. Disponível em: https://solarsystem.nasa.gov/planet-compare/. Acesso em: 13 maio 2025.

Fonte de pesquisa: NASA. Jet Propulsion Laboratory. California Institute of Technology. PIA12114: Photojournal Home Page Graphic 2009 (Artist Concept). Disponível em: https://web.archive.org/web/20250612145853/ https://photojournal.jpl.nasa.gov/catalog/PIA12114. Acesso em: 18 jun. 2025.
Dica: Vênus e Urano realizam o movimento de rotação em sentido contrário ao da Terra.
Imagem com elementos sem proporção entre si. Cores fantasia.
Representação do Sistema Solar.
O tempo do movimento de translação pode variar em razão de diferentes fatores, como a massa do planeta, sua composição e a distância em relação ao Sol. Quanto maior é a distância do planeta em relação ao Sol, por exemplo, mais ele demora para completar a volta ao seu redor.
• Comente com os estudantes que, para apresentar o tempo de rotação e de translação dos planetas do Sistema Solar, foram utilizados as horas e o tempo de rotação (aproximadamente 1 dia) e de translação (aproximadamente 1 ano) da Terra como referência.
• Após os estudantes analisarem a tabela Tempos de rotação e translação dos planetas do Sistema Solar, pergunte a eles qual planeta leva mais dias terrestres para realizar o movimento de translação. Em seguida, questione por que esse planeta leva mais tempo para realizar o movimento. Verifique se percebem que, por Netuno ser o planeta mais distante da Terra, o tempo que leva para dar a volta em torno do Sol é maior em relação aos outros planetas do Sistema Solar.
01/10/2025 19:37:48
Sol Mercúrio
Terra
Júpiter
Saturno
Urano
Netuno
Vênus
Marte
Sistema Solar
BNCC
• Esta seção incentiva os estudantes a investigarem como ocorrem os diferentes momentos do ciclo lunar, com base em conhecimentos e procedimentos científicos, contribuindo para desenvolver a Competência geral 2 e a Competência específica de Ciências da Natureza 2. Além disso, favorece o desenvolvimento da Competência específica de Ciências da Natureza 3, pois leva os estudantes a analisarem, compreenderem e explicarem um fenômeno relativo ao mundo natural, fazendo perguntas e buscando respostas com base nos conhecimentos das Ciências da Natureza.
• Essa investigação é um pré-requisito para o desenvolvimento da habilidade EF04CI11, pois leva os estudantes a reconhecerem os movimentos cíclicos da Lua.
OBJETIVOS
• Investigar como ocorre o ciclo lunar.
• Compreender a relação do Sol com os diferentes momentos do ciclo lunar vistos da superfície terrestre.
Resposta
a) Resposta pessoal. O objetivo desta questão é levantar os conhecimentos prévios dos estudantes sobre a ocorrência do ciclo lunar.
• No item a, caso os estudantes tenham dificuldades, comente que a mudança da imagem aparente da parte iluminada da Lua refere-se aos diferentes momentos do ciclo lunar. Pergunte se, ao observam a Lua no céu noturno, ela parece ter o mesmo formato todos os dias. Oriente-os a explicar por que a Lua parece ter diferentes formatos, incentive o engajamento dos estudantes e acolha seus argumentos, corrigindo quando necessário. Caso alguém responda que o for-
LUA 4 TEMA
VAMOS INVESTIGAR
a ) Em sua opinião, a imagem aparente da parte iluminada da Lua que observamos da Terra muda a cada dia? Justifique.
Resposta nas orientações ao professor
MATERIAIS NECESSÁRIOS
• caixa de sapatos com tampa
• tesoura com pontas arredondadas
• lanterna pequena
• pincel
• fita-crepe
• bola de poliestireno expandido
• tinta guache preta
• clipe metálico
Com o pincel, pinte o interior da caixa de sapatos com a tinta guache preta. Espere a tinta secar.
Em uma das laterais mais estreitas da caixa, peça a um adulto que faça um orifício de tamanho suficiente para encaixar uma lanterna pequena. Depois, peça a ele que faça um orifício com cerca de 8 mm de diâmetro no centro de cada uma das laterais da caixa.
bola fixada no clipe furo de 8 mm
D.
Peça a um adulto que dobre o clipe metálico e encaixe a parte levantada na bola de poliestireno expandido. Com a fita-crepe, fixe a outra parte do clipe no centro da tampa da caixa, de modo que a bola fique na altura dos furos.
Feche a caixa, acenda a lanterna e observe a bola em cada um dos orifícios.
lanterna encaixada no orifício

Caixa de sapato com a lanterna, a bola e os furos.
Agora, responda às questões a seguir no caderno.
1. O que você observou em cada orifício?
Respostas nas orientações ao professor
2. Como podemos relacionar esse aparato à observação da Lua?
mato aparente da Lua não muda, pergunte a eles se já perceberam que há dias em que a Lua está cheia, enquanto em outros momentos quase não é possível observá-la no céu noturno.
• Oriente os estudantes a não manusearem a tesoura para fazer os orifícios. Nas etapas A e B, eles devem pedir ajuda a um adulto.
• Caso julgue interessante, encape a parte interna da caixa de sapato com papel-cartão preto, em vez de pintá-la com tinta guache.
• O orifício em que a lanterna será encaixada deve ter exatamente o diâmetro dela, para que fique firmemente fixada. Se possível, coloque massa de modelar ao redor da lanterna.
• Ao fechar a tampa da caixa, ela deve vedar adequadamente a entrada de luz.
01/10/2025 09:19:08
• Na etapa E, oriente os estudantes a desenharem o que observam em cada orifício.
Respostas
1. Espera-se que os estudantes relatem que, pelos orifícios, é possível ver que diferentes partes da bola de poliestireno expandido são iluminadas, assim como nos momentos do ciclo lunar. 2. Espera-se que os estudantes respondam que esta atividade permite simular quatro momentos do ciclo lunar: lua nova, lua quarto crescente, lua cheia e lua quarto minguante.
A.
B. C.
A Lua é o satélite natural da Terra. Os satélites naturais orbitam ao redor dos planetas, então, a Lua realiza o movimento de translação ao redor da Terra.
Ao observarmos a Lua no céu noturno, parece que ela apresenta diferentes formatos a cada dia. No entanto, o que observamos são diferentes porções da face iluminada da Lua enquanto ela realiza o movimento de translação ao redor da Terra.
De acordo com o formato aparente da face iluminada da Lua no céu, ela recebe diferentes nomes em quatro momentos específicos: lua nova, quarto crescente, lua cheia e quarto minguante. Esses momentos compõem o ciclo lunar.
Os momentos do ciclo lunar se repetem em intervalos de tempo regulares de, aproximadamente, 29 dias.




Representação do movimento de translação da Lua ao redor da Terra no quarto minguante.
BNCC
• Ao citar o período regular que as fases da Lua se repetem, o conteúdo desta página contribui para o desenvolvimento da habilidade EF04CI11
• A interpretação do esquema do ciclo lunar permite aos estudantes que compreendam fenômenos naturais com base em conhecimentos científicos, contribuindo para o desenvolvimento da Competência específica de Ciências da Natureza 3
• Ao abordar os momentos do ciclo lunar, é importante que os estudantes compreendam que a Lua não muda de formato, o que observamos são diferentes partes de sua face sendo iluminadas pela luz solar e que são visíveis da superfície terrestre.
• Para auxiliar os estudantes na compreensão das imagens apresentadas na página, peça-lhes que analisem os quadros inferiores de cada imagem, que representam a aparência da Lua vista da Terra em cada momento do ciclo lunar.
ATIVIDADE EXTRA
Imagens com elementos sem proporção entre si. Cores fantasia.
COMINS, Neil F.; KAUFMANN III, William J. Descobrindo o Universo. Tradução de Eduardo Neto Ferreira. 8. ed. Porto Alegre: Bookman, 2010. p. 45.
Dica: A imagem nos quadros inferiores representa a aparência da Lua vista da Terra nos momentos: quarto crescente (B), lua cheia (C) e quarto minguante (D). A lua nova não pode ser observada no céu noturno (A).
01/10/2025 09:19:11
Se julgar conveniente, sugira aos estudantes que realizem uma atividade de observação da Lua durante seu ciclo. Para isso, oriente-os a fazer, no caderno, um quadro com sete colunas e quatro linhas, semelhante a um calendário. Com a ajuda dos pais ou responsáveis, eles deverão observar a Lua diariamente, preferencialmente no período da noite, por 29 dias, e desenhar seu formato aparente em cada quadro, anotando o dia da observação. Relembre-os de que a lua nova não é visível no céu.
Fonte de pesquisa:
Representação do movimento de translação da Lua ao redor da Terra na lua nova.
Representação do movimento de translação da Lua ao redor da Terra no quarto crescente.
Terra Sol lua nova
A.
quarto crescente
Terra Sol B.
Representação do movimento de translação da Lua ao redor da Terra na lua cheia.
lua cheia
Terra Sol C.
quarto minguante
Terra Sol D.
Lua nova
Lua cheia
Quarto crescente
Quarto minguante ILUSTRAÇÕES:
BNCC
• A abordagem desta seção contribui com o desenvolvimento da Competência geral 1 e da Competência específica de Ciências da Natureza 1, pois leva os estudantes a compreenderem as Ciências da Natureza como um empreendimento humano e a valorizarem os conhecimentos historicamente construídos.
• Esta seção também possibilita desenvolver com os estudantes os temas contemporâneos transversais Ciência e tecnologia e Trabalho
OBJETIVOS
• Conhecer o gênero textual biografia.
• Conhecer o evento histórico da ida do ser humano à Lua.
• Reconhecer e valorizar a contribuição do trabalho de várias cientistas mulheres na ida do ser humano à Lua.
• Elaborar a biografia de um cientista da área da Astronomia.
Resposta a) Resposta pessoal. O objetivo desta questão é incentivar os estudantes a compartilharem suas experiências pessoais e seus conhecimentos sobre o gênero textual biografia.
ARTICULANDO CONHECIMENTOS
Esta seção possibilita uma integração com o componente curricular de Língua Portuguesa, proporcionando aos estudantes a compreensão do gênero textual biografia por meio da leitura e da produção desse gênero.
Peça a três estudantes que, voluntariamente, leiam as biografias desta página. Oriente cada um a ler uma diferente. Em seguida, peça-lhes que citem elementos em comum entre elas.
ENTRE TEXTOS
Uma das maiores conquistas da Ciência na história foi a chegada do ser humano à Lua. Esse evento ocorreu em 20 de julho de 1969 e contou com o trabalho de diversos profissionais. Além dos três astronautas que participaram da missão: Neil Armstrong, Michael Collins e Buzz Aldrin, destaca-se o trabalho de três cientistas que tiveram papel fundamental para que a chegada do ser humano à Lua fosse possível.
Vamos conhecer brevemente a história de vida dessas três cientistas por meio de suas biografias.
Biografia trata-se de um gênero textual que narra a história de uma pessoa ou de um personagem, seguindo geralmente uma ordem cronológica, e que destaca os principais fatos que fizeram parte de sua vida.
a ) Você já leu uma biografia? Se sim, conte para os colegas o que motivou sua leitura.
Resposta nas orientações ao professor
Leia as biografias a seguir.
Margaret Hamilton, matemática, cientista da computação e engenheira de software, nasceu em 17 de agosto de 1936, na cidade de Paoli, estado da Indiana, Estados Unidos. Entre outros feitos, tornou-se diretora de Software do programa Apollo, desenvolvendo o programa de voo usado na missão Apollo 11, a qual levou o ser humano a pousar na Lua. O programa desenvolvido por ela foi essencial para o sucesso da missão.
Katherine Johnson nasceu em 26 de agosto de 1918, na cidade de White Sulphur Springs, no estado da Virgínia Ocidental, Estados Unidos. Foi matemática e cientista espacial, e suas habilidades em matemática tiveram importante contribuição para os cálculos de voos das primeiras missões espaciais, tendo papel fundamental nos cálculos que ajudaram a sincronizar o módulo lunar da Apollo 11 com o módulo de serviço. Ela faleceu em 24 de fevereiro de 2020, aos 101 anos.
Verifique se percebem que esses textos contam um pouco da vida pessoal e profissional de várias cientistas. Depois, leia com os estudantes a definição desse gênero textual.
Após responder às questões a, b e c desta seção, oriente os estudantes na elaboração de uma biografia, conforme sugerido no item d. Peça-lhes que produzam a biografia de um cientista, não repetindo com a do colega.
Se julgar conveniente, solicite-lhes que elaborem a biografia do cientista escolhido em uma folha de papel sulfite. Oriente-os a colar a imagem do cientista e a escrever em letra cursiva as informações pesquisadas. Junte todas as produ-


ções, formando um portifólio.
Organize a turma para que todos tenham a oportunidade de levar para a casa o portifólio para ler com os pais ou responsáveis.
Margaret Hamilton (1936-), 1969.
Katherine Johnson (1918-2020), 1966.
Judy Sullivan, bióloga e engenheira biomédica estadunidense. Trabalhou para a Nasa, entre outras missões, e na missão Apollo 11 como engenheira-chefe do sistema biomédico, monitorando o equipamento que fornecia informações sobre a saúde dos astronautas durante a viagem ao espaço.
EXPLORANDO O TEXTO

Judy Sullivan (1943-).
b ) Por que a participação das três cientistas mulheres foi fundamental para que os seres humanos chegassem à Lua?
Resposta nas orientações ao professor
c ) Em sua opinião, qual é a importância das biografias, como as retratadas anteriormente? Converse com os colegas.
Resposta nas orientações ao professor
ALÉM DO TEXTO
d ) Junte-se a um colega e pesquisem em um computador com internet ou nos arquivos da biblioteca da escola a biografia de um importante cientista da área de Astronomia. Escreva no caderno, com letra cursiva, a história dele, destacando sua importância para a Ciência. Em seguida, compartilhe sua pesquisa com os colegas, lendo as informações que você anotou sobre a biografia do cientista que escolheu.
Resposta nas orientações ao professor
e ) Em sua opinião, qual foi a importância da chegada do ser humano à Lua para a humanidade? Converse com os colegas.
Resposta nas orientações ao professor.

Respostas
Imagem com elementos sem proporção entre si. Cores fantasia.
Família assistindo à chegada do ser humano à Lua em uma televisão.
• Após a leitura das biografias das cientistas, oriente os estudantes a conversarem sobre a importância dos trabalhos desenvolvidos por essas mulheres e a falta de reconhecimento na época em razão do gênero. Verifique se eles percebem que as contribuições das cientistas mulheres são tão importantes quanto as dos cientistas homens e que seus trabalhos e estudos deveriam ser igualmente reconhecidos.
EXPLORANDO O TEXTO
Respostas
b) Espera-se que os estudantes respondam que os cientistas, cada um dentro de suas especialidades, tornaram possível o plano de voo da missão Apollo 11, corrigindo eventuais erros e monitorando a saúde dos astronautas durante a viagem para o espaço. c) Resposta pessoal. O objetivo desta questão é levar os estudantes a refletirem sobre a importância desse gênero textual, que retrata a história de pessoas e personagens, possibilitando que sejam reconhecidos pelos seus feitos.
ALÉM DO TEXTO
• No item d, leve os estudantes até um computador com acesso à internet na escola ou oriente-os a fazer a pesquisa na internet em casa, com os pais ou responsáveis. Incentive-os a buscar informações em fontes confiáveis e verifique se fazem a pegada de três pontos no lápis ao realizarem a escrita cursiva.
• Para auxiliá-los no item d, apresente nomes de outras cientistas mulheres que atuaram ou atuam na área da astronomia. Confira alguns exemplos nesse site:
• MULHERES na astronomia. Espaço Ciência, 7 mar. 2018. Disponível em: http://ec.pe.gov. br/?p=12238. Acesso em: 7 ago. 2025.
01/10/2025 09:19:15
d) Resposta pessoal. A resposta depende do cientista escolhido pelos estudantes. Espera-se que sejam citados, por exemplo, ano e local de nascimento, o curso e a instituição onde se formou, além dos principais trabalhos de sua carreira.
e) Resposta pessoal. O objetivo desta questão é levar os estudantes a perceberem que a chegada do ser humano à Lua faz parte de uma conquista da humanidade, pois permitiu constatar a importância da tecnologia no desenvolvimento do conhecimento sobre os astros e o Universo.
BNCC
• A abordagem desta página possibilita o desenvolvimento da habilidade EF04CI11, pois fornece subsídios para os estudantes associarem os movimentos cíclicos da Lua a períodos de tempo regulares e ao uso desse conhecimento na construção de calendários em diferentes culturas, como o construído pelo povo indígena Kalapalo.
• Abordar o calendário dos Kalapalo também favorece o desenvolvimento da Competência geral 6, pois incentiva os estudantes a valorizarem a diversidade de saberes e vivências culturais. Além disso, possibilita o trabalho com os temas contemporâneos transversais Diversidade cultural e Educação para valorização do multiculturalismo nas matrizes históricas e culturais brasileiras.
• Para auxiliar os estudantes na questão 1, pergunte se lembram de alguma situação em que precisaram consultar um calendário.
Questione-os se anotam as datas das principais atividades da escola, dos aniversários dos familiares e amigos e dos feriados, por exemplo. Verifique se citam o calendário ou mesmo uma agenda, que é elaborada com base no calendário. Se nunca tiveram contato com esses objetos, pergunte se já viram algum familiar ou responsável fazendo anotações neles. Explique a importância dos calendários e das agendas para organizar tarefas e compromissos do dia a dia, bem como para ter um registro pessoal de atividades realizadas no passado.
CALENDÁRIO 5
1. Resposta pessoal. O objetivo desta questão é levar os estudantes a refletirem sobre a organização e a funcionalidade dos calendários, pois esse instrumento permite organizar o tempo e programar atividades futuras, dividindo o tempo em anos, meses, semanas e dias.
1. Você costuma usar calendários? Em quais situações podemos utilizar esse instrumento?
A observação dos astros permitiu ao ser humano realizar várias tarefas, como a organização da passagem do tempo. Para isso, diferentes calendários foram elaborados por diversas civilizações, incluindo os povos indígenas.
No Parque Indígena do Xingu, na aldeia Kalapalo, as atividades cotidianas são realizadas de acordo com as estações do ano. Essas atividades estão organizadas na forma de um calendário.
Representação do calendário do povo Kalapalo.
Fonte de pesquisa: KAYABI, Aturi et al Geografia indígena: Parque Indígena do Xingu. São Paulo: Instituto Socioambiental, 1996. p. 54.

Janeiro: Mês de muita chuva e reclusão dos jovens que vão passar para idade adulta.
Fevereiro: Mês em que a roça é cercada, evitando a destruição por porcos do mato.
Março: Mês de construção das casas.
Abril: Mês de cobrir as casas com sapê
Maio: Mês em que os jovens reclusos saem da reclusão.
Junho: Mês da entrega do polvilho para a festa Kuarup.
Julho: Mês da desova do tracajá.
Agosto: Mês da festa Kuarup.
Setembro: Mês de início das chuvas.
Outubro: Mês que as frutas do pequizeiro começam a cair.
Novembro: Mês em que os rios enchem.
Dezembro: Mês de festas.
Imagem com elementos sem proporção entre si. Cores fantasia.
Sapê: caules secos de determinadas plantas que são usados para cobrir casas.
REFERÊNCIAS COMPLEMENTARES
LIMA, Mônica dos Santos; GONÇALVES JÚNIOR, Luiz; FRANCO NETO, João Veridiano. A construção do corpo indígena kalapalo (Alto Xingu – Brasil): processos educativos envolvidos. Políticas Educativas, Campinas, v. 1, n. 2, p. 146155, jul. 2008.
• Comente com os estudantes que os conhecimentos astronômicos dos povos indígenas, como a observação dos movimentos aparentes do Sol e da Lua no céu e os estudos das constelações indígenas ao longo do tempo, associados à biodiversidade do local onde viviam, possibilitaram e possibilitam a organização de suas atividades e a vida em sociedade.
Disponível em: https://seer.ufrgs.br/index.php/ Poled/article/view/18311/10785. Acesso em: 8 ago. 2025.
Nesse artigo, é abordado o rito de reclusão dos jovens da etnia Kalapalo. KALAPALO. Povos Indígenas no Brasil. Disponível em: https://pib.socioambiental.org/pt/ Povo:Kalapalo. Acesso em: 8 ago. 2025.
Esse site apresenta informações sobre a língua, a população, a organização social, as músicas, os rituais e as atividades econômicas dos Kalapalo.
BNCC
O calendário é um instrumento utilizado na contagem do tempo em dias, meses e anos. Durante a história da humanidade, muitos povos elaboraram o próprio calendário. Em geral, sua construção está relacionada à observação dos astros, como o Sol e a Lua, e aos seus movimentos de rotação e de translação.
Estima-se que o primeiro calendário tenha sido elaborado em cerca de 2700 a.C., na Mesopotâmia. Ele era dividido em 12 meses, no qual cada mês seguia o ciclo lunar, tendo, aproximadamente, 29 ou 30 dias, o que totalizaria 354 ou 355 dias.
Os romanos também elaboraram seu primeiro calendário, cerca de 4 mil anos atrás, que se baseava no ciclo lunar. Eles dividiam o ano em 10 meses, totalizando 304 dias a cada ano.
O líder militar romano Júlio César (100 a.C-44 a.C.), em 46 a.C., fez algumas alterações no calendário romano e implementou o calendário juliano, baseado no movimento de translação da Terra.
Nesse período, acreditava-se que um ano teria 365 dias e 6 horas, o que resultou em uma discrepância em relação às estações do ano.
O papa italiano Gregório 13 (1502-1585), no século 16, corrigiu a diferença acumulada em anos e determinou que um ano tinha 365 dias, 5 horas e 48 minutos, criando o calendário similar ao que utilizamos atualmente.
Confira na tabela a quantidade de dias para cada mês dos calendários juliano e gregoriano.
Meses e dias dos calendários juliano e gregoriano
Mês
(Januarius)
(Februarius)
Quantidade de dias no calendário juliano
Quantidade de dias no calendário gregoriano
Fonte de pesquisa: MARQUES, Manuel Nunes. Origem e evolução do nosso calendário. Disponível em: https://www.mat.uc.pt/%7Ehelios/Mestre/H01orige.htm. Acesso em: 23 maio 2025.
para que esse momento do ciclo lunar se repita. Pergunte como os calendários foram elaborados pelas diferentes culturas e verifique se associam a construção dos calendários aos movimentos cíclico e regular dos astros, principalmente os da Terra.
• Após apresentar os calendários juliano e gregoriano, relembre os estudantes de que a cada quatro anos o mês de fevereiro tem um dia a mais, resultando em 366 dias no ano. Esse ano é chamado de bissexto.
• Comente com os estudantes que os termos entre parênteses no quadro Meses e dias dos calendários juliano e gregoriano referem-se aos nomes dos meses do ano em latim.
ATIVIDADE EXTRA
Depois de terminar o trabalho com o tema 5, organize os estudantes em grupos e sugira uma atividade de pesquisa, na biblioteca ou em um computador com acesso à internet, para que encontrem imagens e curiosidades sobre outros tipos de calendários. Proponha que pes-
• Ao mencionar os calendários desenvolvidos por diferentes povos, como o mesopotâmico e o romano, elaborados com base na observação dos astros e no movimento da Terra, esta página contribui para o desenvolvimento da habilidade EF04CI11
• Além disso, a abordagem desta página contribui para o desenvolvimento da Competência geral 1 e da Competência específica de Ciências da Natureza 1, visto que as mudanças pelas quais os calendários passaram permitem aos estudantes compreenderem que o conhecimento científico é um empreendimento humano, cultural e histórico, valorizando essa construção.
AVALIANDO
Objetivo
• Verificar se os estudantes identificam os elementos de um calendário e reconhecem a periodicidade do ciclo lunar por meio da análise de um calendário lunar.
Sugestão de intervenção
Disponibilize aos estudantes um calendário lunar e peça a eles que identifiquem o dia da semana e o mês do aniversário deles, bem como o momento do ciclo lunar nesse dia. Em seguida, oriente-os a identificar quando esse momento se repetirá. Verifique se percebem que levará 29 dias
quisem o calendário chinês e calendários indígenas, como o do povo Guarani e dos povos indígenas do Rio Tiquié. Eles podem utilizar editores de apresentações e montar slides digitais para apresentar aos colegas, contribuindo com o desenvolvimento da Competência geral 5 da BNCC e da Competência específica de Ciências da Natureza 6 da BNCC, ao utilizarem tecnologias digitais para acessar e disseminar informações. Outra opção é montar cartazes com imagens e textos sobre esses calendários.
1. Objetivos
• Identificar o momento do ciclo lunar representado em uma imagem.
• Explicar a razão pela qual observamos o formato aparente da Lua mudar a cada dia.
• Reconhecer um momento do ciclo lunar por meio da observação da posição em que a Lua se encontra em relação à Terra e ao Sol.
Sugestão de intervenção
Para auxiliar os estudantes no item a , peça-lhes que, primeiro, descrevam as características do quarto minguante, da lua nova, do quarto crescente e da lua cheia. Em seguida, oriente-os a comparar essas descrições com a imagem apresentada na atividade.
Caso tenham dificuldades para responder ao item b, pergunte que astro ilumina a Lua e questione se ela fica parada no espaço ou realiza algum movimento. Verifique se percebem que, conforme a Lua se movimenta ao redor da Terra, a parte visível dela, nesse planeta, é iluminada pelo Sol, originando os diferentes formatos aparentes no céu noturno.
Para auxiliar os estudantes no item c, solicite-lhes que imaginem o que um observador na superfície da Terra estaria observando em cada posição da Lua. Pergunte quais partes da Lua são visíveis da Terra em cada situação.
2. Objetivo
• Analisar a projeção das sombras de um objeto de acordo com a posição da fonte de luz.
Sugestão de intervenção
Se os estudantes tiverem dificuldade em identificar a imagem com a projeção incorreta, peça a eles que se lembrem da atividade realizada na seção Vamos investigar das páginas 16 e 17, em que construíram um gnômon e marcaram a pro-
Escreva as respostas no caderno.
VAMOS AVALIAR O APRENDIZADO
1. Marcos vive no Hemisfério Sul e fotografou a Lua. Observe a imagem a seguir.
1. b) Resposta: Espera-se que os estudantes respondam que, durante seu ciclo, diferentes porções da parte visível da Terra são iluminadas pelo Sol.

a ) Como é chamada a fase da Lua registrada por Marcos?
b ) Por que vemos o aspecto aparente da Lua mudar durante o ciclo lunar?
1. a) Resposta: Espera-se que os estudantes respondam que é a lua cheia.
Imagem da Lua registrada por Marcos.
c ) Escreva no caderno a posição em que a Lua se encontrava quando Marcos registrou a imagem.

1
Imagens com elementos sem proporção entre si. Cores fantasia.

Posição 2
1. c) Resposta: Espera-se que os estudantes identifiquem que o momento do registro corresponde à posição 1
Fonte de pesquisa: COMINS, Neil F.; KAUFMANN III, William J. Descobrindo o Universo Tradução de Eduardo Neto Ferreira. 8. ed. Porto Alegre: Bookman, 2010. p. 45.
2. Observe as imagens a seguir e reproduza, no caderno, aquela que apresenta a sombra na posição incorreta, corrigindo-a.
Resposta nas orientações ao professor

jeção das sombras em dois horários. Questione se as sombras registradas ficavam do mesmo lado do Sol ou do lado oposto. Aproveite o momento e peça aos estudantes que expliquem por que a posição aparente do Sol no céu e a sombra projetada por um objeto iluminado por ele mudam ao longo do dia. Verifique se relacionam essas mudanças ao movimento de rotação da Terra.
Imagens com elementos sem proporção entre si. Cores fantasia.

Representação da
Resposta
uma madeira.
2. Espera-se que os estudantes percebam que a situação A está correta e a B, incorreta. Dessa maneira, precisam desenhar corretamente a sombra projetada pela madeira na situação B, que deve estar do lado oposto ao Sol.
BNCC
• A atividade 1 contribui para o desenvolvimento da habilidade EF04CI09, pois leva os estudantes a associarem os movimentos cíclicos da Lua a períodos regulares.
Representação da sombra de uma madeira.
Posição
sombra de
Terra
Terra Sol Sol
A.
B.
3. Rúbia anotou no caderno algumas frases incompletas. Observe.
3. Resposta: a) Um ano regular tem 365 dias. b) Um ano bissexto tem 366 dias e ocorre a cada 4 anos. c) Um ano tem 12 meses, dos quais 7 têm 31 dias. d) Uma semana tem 7 dias, equivalente a 168 horas. e) Um ano regular tem 8 760 horas.
a ) Um ano regular tem ■ dias.
b ) Um ano bissexto tem ■ dias e ocorre a cada ■ anos.
c ) Um ano tem ■ meses, dos quais ■ têm 31 dias.
d ) Uma semana tem ■ dias, equivalente a ■ horas.
e ) Um ano regular tem ■ horas.
No caderno, reproduza as frases que Rúbia escreveu e as complete substituindo os símbolos pelos números corretos.
4. Júlio e o pai foram acampar. Escreva no caderno quais dos objetos a seguir eles podem usar para se orientarem geograficamente.


Resposta: Espera-se que os estudantes respondam que os equipamentos são GPS, mapa e bússola.






Imagens sem proporção entre si.
a ) Explique com suas palavras como funcionam esses objetos.
Resposta pessoal. O objetivo desta atividade é levar os estudantes a escreverem o que compreenderam sobre o funcionamento de cada um dos itens: GPS, mapa e bússola.
01/10/2025 09:19:27
3. Objetivo
• Calcular a quantidade de meses, dias e horas que há em um ano.
Sugestão de intervenção
Caso os estudantes tenham dificuldade em responder a esta atividade, relembre-os de que o ano chamado regular é o não bissexto e que este último é o que tem o dia 29 de fevereiro. Se necessário, oriente-os a consultar a tabela da página 29, questionando previamente se o calendário que utilizamos é o juliano ou o gregoriano. Para a realização desta atividade, os estudantes também podem consultar um calendário.
4. Objetivos
• Reconhecer alguns instrumentos de orientação geográfica.
• Explicar o funcionamento de alguns instrumentos de orientação geográfica.
Sugestão de intervenção
Se os estudantes tiverem dificuldade em reconhecer os instrumentos de orientação, pergunte a eles qual é a utilidade de cada objeto apresentado na atividade. Caso não se lembrem do funcionamento de algum equipamento, informe que um deles apresenta informações sobre a posição dos pontos cardeais por meio do campo magnético da Terra, outro permite a localização com base em pontos de referência e o terceiro fornece a posição atual deles por meio de satélites artificiais. Assim, peça-lhes que associem os modos de funcionamento aos instrumentos.
Se possível, leve um exemplar dos objetos de orientação geográfica, como a bússola, o mapa e o GPS, além de outros objetos que não estão relacionados a essa função, como apito, lanterna e garrafa. Peça aos estudantes que manuseiem esses objetos, reconhecendo elementos que favorecem a orientação geográfica.
Mapa.
Corda.
Saco de dormir.
GPS.
Bússola.
Garrafa.
Apito.
Lanterna.
OBJETIVOS DA UNIDADE
• Identificar as características dos materiais em cada estado físico.
• Investigar as transformações que ocorrem com a água.
• Identificar situações do cotidiano que envolvem transformações físicas.
• Identificar situações do cotidiano que envolvem transformações químicas.
• Diferenciar transformações reversíveis de transformações irreversíveis.
• Refletir sobre a transformação do plástico no ambiente.
• Investigar a transformação da matéria orgânica.
• Conhecer a posição ocupada pelos seres vivos de uma cadeia alimentar.
• Compreender a formação das teias alimentares.
• Compreender o fluxo de energia e nutrientes que ocorre nas cadeias alimentares.
• Refletir sobre as causas e consequências dos desequilíbrios nas cadeias alimentares.
• Nesta unidade, os estudantes aprenderão as transformações físicas e químicas que ocorrem em seu dia a dia. Além disso, estudarão as relações alimentares entre os seres vivos.
• O tema 6 aborda as transformações físicas que ocorrem em situações do dia a dia, bem como os estados físicos dos materiais. Já o tema 7 apresenta as transformações químicas que ocorrem em situações do dia a dia e com os seres vivos, como a fotossíntese e respiração.
• No tema 8, são abordadas as transformações reversíveis e irreversíveis das transformações químicas e físicas dos materiais. No tema 9 , são tratadas as transformações da matéria orgânica.
UNIDADE2

TRANSFORMAÇÕES NO
AMBIENTE E NO DIA A DIA
Urso-polar se locomovendo de um bloco de gelo ao outro no arquipélago de Svalbard, no Círculo Polar Ártico, em 2024.
• Nos temas 10 e 11, são abordadas as relações alimentares que ocorrem entre os seres vivos e as consequências dos desequilíbrios dessas relações, respectivamente.
Urso-polar: pode atingir cerca de 2,5 m de comprimento.
Nas últimas décadas, a temperatura média da Terra tem aumentado, o que tem sido relacionado ao aumento da ocorrência de eventos climáticos extremos, como chuvas intensas e secas prolongadas, além de outras consequências, como o derretimento das geleiras e o aumento do nível dos oceanos.
Essas mudanças podem impactar a vida dos seres vivos que habitam o planeta.
O derretimento do gelo marinho, por exemplo, pode prejudicar a sobrevivência dos ursos-polares. Esses predadores vivem nas áreas frias ao longo do Círculo Polar Ártico, onde percorrem o gelo em busca de outros animais, como as focas, para se alimentarem. Com o derretimento, esse gelo passa a formar blocos, separados uns dos outros, dificultando a caça e podendo prejudicar a alimentação dos ursos-polares.
O derretimento do gelo marinho e a nutrição dos animais são situações que envolvem a transformação dos materiais.

BNCC
ARTICULANDO CONHECIMENTOS
Qual condição é responsável pela transformação do gelo em água líquida?
O urso-polar é um animal carnívoro, herbívoro ou onívoro?
Justifique sua resposta.
Como a falta de alimento pode impactar a sobrevivência dos animais? Qual é a importância da alimentação para a sobrevivência deles? 1.
Respostas nas orientações ao professor.
• A questão 3 sugere aos estudantes argumentarem com base em informações científicas sobre questões que envolvem a consciência ambiental e seus impactos na sobrevivência dos animais por causa do derretimento das geleiras, contribuindo para desenvolver a Competência específica de Ciências da Natureza 5. Esse assunto também está relacionado ao tema contemporâneo transversal Educação ambiental
• Na questão 2, comente que, ocasionalmente, os ursos-polares também podem se alimentar de vegetais, como raízes e musgos. No entanto, eles se alimentam principalmente de outros animais, sendo a foca sua principal presa.
Respostas
1. Espera-se que os estudantes respondam que a condição responsável por essa transformação é o aumento da temperatura ou o aquecimento.
2. Carnívoro, pois ele se alimenta de outros animais, por exemplo, da foca.
Se julgar interessante, apresente um mapa-múndi aos estudantes e peça que identifiquem onde fica o Círculo Polar Ártico. Se eles se confundirem e apontarem para a Antártida, explique que esse continente fica no Polo Sul do planeta Terra. Essa abordagem favorece a integração com o componente curricular de Geografia. Diga a eles que não existem povos originários da Antártida e que em 1959 foi criado o Tratado da Antártida, estabelecendo que o continente é uma Reserva Natural Internacional. Nesse local, as ocupações são feitas apenas com o objetivo de fazer pesquisas científicas. Apesar disso, explique que uma de suas regiões — a península Antártida — foi a que mais se aqueceu nos últimos anos, sendo cinco vezes maior do que a média global. Para possibilitar a inclusão dos estudantes com deficiência visual, utilize um mapa tátil, com elementos em alto-relevo e diferentes texturas. É possível delimitar o continente também, usando cola quente ou barbante, e compor a extensão de sua área com materiais de diferentes texturas, como areia ou serragem. Faça o mesmo procedimento para delimitar a extensão da área do Ártico, para que eles percebam a diferença entre suas localizações no mapa e extensão.
01/10/2025 09:22:31
3. Espera-se que eles comentem que os animais obtêm os nutrientes e a energia de que precisam para crescer e se desenvolver adequadamente alimentando-se de outros seres vivos. É na alimentação que os nutrientes são transformados para que a energia armazenada neles seja disponibilizada.
BNCC
• A abordagem desta página contribui para o desenvolvimento da habilidade EF04CI03, já que mostra, brevemente, mudanças causadas por aquecimento de materiais, como a água no estado sólido.
• As transformações das geleiras, quando expostas a diferentes condições (aquecimento e resfriamento), colaboram para desenvolver a habilidade EF04CI02
• Inicie as atividades desta página solicitando aos estudantes que identifiquem em que estado físico da matéria a escultura apresentada encontra-se e de qual material ela é feita. Explore a imagem com eles e, se julgar interessante, leve outras imagens de esculturas feitas de diferentes materiais, como areia, materiais recicláveis, entre outros, e peça-lhes que identifiquem o material de que são feitas, bem como o estado físico deles.
• Depois, explore com eles a imagem da lagoa da geleira de Jökulsárlón, na Islândia, e explique brevemente os três estados físicos da água. Aproveite as imagens das geleiras para comentar sobre o derretimento pelo qual estão passando, indo do estado sólido para o líquido por causa da intensificação do efeito estufa no planeta. Discuta também, ainda que brevemente, os efeitos nocivos das mudanças climáticas sobre o nível do mar e como isso pode impactar o planeta Terra e os seres vivos.
ATIVIDADE EXTRA
Providencie cubos de gelo e três recipientes transparentes de diferentes formatos. Coloque os cubos de gelo nos recipientes, alcançando a capacidade máxima. Peça aos estudantes que observem o que acontece com o gelo com o passar do tempo. Pergunte-
6 TRANSFORMAÇÕES FÍSICAS E ESTADOS FÍSICOS DOS MATERIAIS
1. Resposta: Espera-se que os estudantes respondam água ou gelo.
Observe a fotografia e responda oralmente às questões a seguir.

1. De que material é feita a escultura mostrada na fotografia?
2. Em qual estado físico esse material está? Sólido, líquido ou gasoso?
Resposta: Sólido.
3. O que aconteceria se a escultura fosse aquecida? Ela manteria o formato original? Explique.
Resposta nas orientações ao professor
Escultura de gelo exposta em um festival na cidade de Harbin, na China, em 2023.
De modo geral, os materiais podem ser encontrados nos estados físicos sólido, líquido e gasoso. Dependendo do estado físico, esses materiais podem apresentar diferentes características. Acompanhe a seguir.
No estado físico gasoso, os materiais não têm formato definido, e a água é conhecida como vapor de água quando está nesse estado. O ar atmosférico apresenta vapor de água. Em nosso cotidiano, um exemplo de liberação de vapor de água pode ser observado quando colocamos água para aquecer em uma panela ou chaleira.
No estado físico sólido, os materiais têm formato e volume definidos. Em geleiras ou icebergs, a água se encontra no estado sólido. Nas residências, os cubos de gelo utilizados em bebidas, por exemplo, representam a água no estado sólido.
No estado físico líquido, os materiais não têm formato definido, que variam de acordo com o local onde eles estão. Podemos encontrar a água nesse estado físico em rios, lagos, mares e oceanos, por exemplo. Nas residências, a água das torneiras está no estado físico líquido.

estado físico gasoso estado físico líquido estado físico sólido
Lagoa da geleira de Jökulsárlón, na Islândia, em 2023.
4. Escreva no caderno o nome de um objeto ou material na sua escola que se encontra em cada estado físico: sólido, líquido e gasoso.
Resposta pessoal. Os estudantes podem citar lápis, caneta, carteira, lousa ou borracha para o estado sólido; água ou suco para o estado líquido; e ar para o estado gasoso.
-lhes se os cubos de gelo ocupam o mesmo espaço que a água no estado líquido e se mantêm o formato ou não. Retome com eles as características da água nos estados sólido e líquido em relação ao formato.
Esta atividade leva os estudantes a observarem, na prática, algumas características dos materiais nos estados sólido, líquido e gasoso, contribuindo para desenvolver a Competência específica de Ciências da Natureza 3 da BNCC.
Resposta
3. Espera-se que os estudantes respondam que, ao ser aquecida, a escultura derreteria, ou seja, sofreria fusão, passando do estado sólido para o líquido, e que, consequentemente, seu formato original se perderia, pois a água no estado sólido apresenta formato e volume definidos, enquanto no estado líquido, seu volume e formato variam de acordo com o local onde se encontra.
TRANSFORMAÇÕES FÍSICAS DOS MATERIAIS
VAMOS INVESTIGAR
a ) Quais transformações podem ocorrer com a água se sua temperatura for alterada?
Resposta nas orientações ao professor
MATERIAIS NECESSÁRIOS
• 2 copos plásticos transparentes
• caneta marcador permanente
• água
A. B.
Utilizando a caneta marcador, identifique os copos com as letras A e B
Em seguida, coloque a mesma quantidade de água nos dois copos.

C. D. E.
Atenção: Permaneça exposto ao sol apenas o tempo necessário para realizar a atividade e utilize chapéu ou boné e protetor solar.
Copos A e B com água em seu interior.
Indique com a caneta marcador o nível da água no copo A
Na sequência, coloque o copo A em um local no qual ele receba luz solar diretamente e o copo B no congelador de um refrigerador. Após três horas, verifique o que ocorreu com a água nos dois copos.
Agora, responda às questões a seguir no caderno.
Respostas nas orientações ao professor
1. O que aconteceu com a água em cada um dos copos?
2. Quais fatores foram responsáveis pelas transformações observadas nos copos A e B?
3. A transformação que ocorreu no copo B pode ser revertida? Como?
BNCC
• O experimento desta página leva os estudantes a utilizarem práticas e procedimentos da investigação científica, a testarem e relatarem transformações de um material do dia a dia quando expostos a diferentes condições (aquecimento e resfriamento), além de levá-los a concluir que essas mudanças são reversíveis, o que contribui para o desenvolvimento da Competência geral 2, da Competência específica de Ciências da Natureza 2 e das habilidades EF04CI02 e EF04CI03
OBJETIVOS
• Investigar o que ocorre com a água quando exposta a diferentes condições.
• Identificar um exemplo de transformação reversível.
Resposta a) Espera-se que os estudantes citem que, aumentando a temperatura, conseguimos ferver a água; e diminuindo a temperatura, conseguimos congelá-la.
• Se os estudantes tiverem dificuldade para responder ao item a, pergunte se já observaram alguém cozinhando macarrão com água fervente e o que ocorre com ela quando é colocada no congelador de um refrigerador. Alguns deles podem mencionar também que, ao deixarmos a água exposta à luz solar, aceleramos o processo de evaporação.
• Ao realizarem a etapa D, oriente-os a permanecer expostos à luz solar somente o tempo necessário para colocar o copo no local e a passar o protetor solar na pele.
• Se os resultados esperados não se concretizarem, oriente os estudantes a utilizarem copos mais largos para aumentar a superfície de contato com o ar e acelerar o processo ou deixarem os copos mais tempo nas condições propostas.
• Caso tenham dificuldade para responder à atividade 1, verifique se eles obser-
vam que a quantidade de água no copo A diminui e pergunte a eles para onde essa água deve ter ido.
• Caso os estudantes tenham dificuldade para responder à atividade 2, peça que submetam o copo B com a água solidificada às condições em que o copo A permaneceu, ou seja, em um local que receba luz solar diretamente. Oriente-os a deixar o copo nesse local por algumas horas e observar o que ocorre.
Respostas
1. Espera-se que os estudantes respondam que parte da água do copo A, que
01/10/2025 09:22:34
ficou exposto à luz solar, evaporou e que a água do copo B congelou (se solidificou).
2. O calor recebido pela água do copo A fez parte dela evaporar e que a temperatura do congelador provocou o congelamento da água do copo B.
3. Sim. A transformação pode ser revertida deixando o copo em temperatura ambiente por determinado tempo ou colocando o gelo formado em uma panela sobre a chama de um fogão até que a água retorne ao estado líquido.
BNCC
• As situações ilustradas nesta página contribuem para desenvolver as habilidades EF04CI02 e EF04CI03 , pois os estudantes observam situações do cotidiano nas quais a água sofre transformações ao ser exposta a diferentes condições e a reversibilidade delas.
• Incentive os estudantes a lerem em voz alta os textos referentes às situações apresentadas nesta página. A cada situação, pergunte a eles se a água está recebendo ou cedendo calor para o ambiente.
• Na situação relacionada à vaporização, comente com os estudantes que o vapor de água é transparente, não podendo ser observado no ambiente. O vapor que observamos saindo da chaleira, por exemplo, são gotículas de água provenientes da condensação do vapor de água em contato com ar atmosférico.
AVALIANDO
Objetivo
• Verificar se os estudantes compreenderam as transformações que ocorrem com a água quando submetida a diferentes condições.
Sugestão de intervenção
Peça aos estudantes que façam no caderno um esquema com os três estados físicos da água, dando o nome das transformações, e que informem se houve aquecimento ou resfriamento para que dada transformação ocorresse. Oriente-os a fazer um esquema similar ao modelo a seguir.
Como você estudou, a água pode sofrer transformações e, assim, mudar de um estado físico para outro. Isso ocorre, por exemplo, quando ela é aquecida ou resfriada. Observe as situações a seguir.
Imagens com elementos sem proporção entre si. Cores fantasia.

Representação de uma cozinha, destacando situações que envolvem mudanças de estados físicos da água.
Na situação A, a água líquida colocada nas formas sofreu uma transformação ao ceder calor para o refrigerador, passando para o estado físico sólido. A mudança do estado líquido para o sólido é chamada de solidificação
B.
Na situação B, a água líquida no interior da chaleira sobre a chama do fogão sofreu uma transformação em razão do aquecimento, passando para o estado físico gasoso. A mudança do estado líquido para o gasoso é chamada de vaporização
Ao deixar um copo com água e gelo sobre a mesa da cozinha, situação C, a água sólida (cubos de gelo) sofreu uma transformação (derreteu) em razão do aquecimento, passando para o estado físico líquido. A mudança do estado sólido para o líquido é chamada de fusão. Também na situação C, a água no estado gasoso presente no ar atmosférico (vapor de água) entrou em contato com a superfície do copo com água e gelo. Como a temperatura do copo é menor do que a do ambiente, quando o vapor de água do ar entra em contato com o copo, ele passa para o estado líquido. A mudança do estado gasoso para o líquido é chamada de condensação
fusão (aquecimento)
sólido líquido
solidificação (resfriamento)
vaporização (aquecimento)
gota de água na superfície do copo

Representação de um copo de água com gelo
gasoso
condensação (resfriamento)
A.
B. C.
A.
C.
5. Resposta: Espera-se que os estudantes respondam que não e comentem que, apesar de ter seu formato alterado, a composição química da água é a mesma.
As mudanças de estado físico da água que você estudou representam transformações físicas.
5. Em sua opinião, ao sofrer as transformações abordadas nas situações anteriores, a composição da água foi alterada?
As transformações físicas são aquelas nas quais os materiais mantêm sua composição após serem transformados.
Além da água, outros materiais também podem sofrer transformações físicas em determinadas condições. Acompanhe o exemplo a seguir.
A. B.
Ao acender uma vela, parte da parafina que a constitui é aquecida com o calor da chama e sofre fusão, passando do estado sólido para o líquido.
Quando a parafina no estado líquido perde calor e se resfria, ela passa desse estado para o estado sólido novamente.

A. B.
Imagens sem proporção entre si.

6. As velas podem ser cilíndricas, piramidais, cúbicas. Como você acha que um artesão poderia obter velas com diferentes formatos a partir da parafina sólida?
As transformações físicas também podem ser observadas em processos industriais. Para fazer um brinco de ouro, por exemplo, um ourives precisa derreter o ouro, moldá-lo e deixá-lo solidificar novamente.
Ourives: pessoa que fabrica ou conserta objetos feitos de metais preciosos. Resposta nas orientações ao professor.
Ourives derretendo ouro

Professor, professora. Confira os comentários sobre as transformações da parafina da vela nas orientações ao professor
Resposta
6. Resposta pessoal. O objetivo desta questão é levar os estudantes a refletirem sobre as características dos materiais nos estados físico, sólido e líquido, bem como sobre as condições necessárias para as mudanças de fases da parafina. Espera-se que eles comentem que, para moldar a parafina em diferentes formatos, são necessários recipientes de diferentes formatos. Além disso, a parafina deve ser aquecida para que passe ao estado líquido, pois nesse estado os materiais adquirem o formato do recipiente que ocupam. Após colocar a parafina nos recipientes e o pavio, seria necessário aguardar o material
01/10/2025 09:22:38
ceder calor para o ambiente, passando para o estado sólido. Nesse estado, a parafina tem formato e volume definido e, desse modo, ficaria com o formato do recipiente em que foi acondicionada, sendo possível obter velas com diferentes formatos.
• Pergunte aos estudantes qual fator afeta o estado físico da água. Averigue se eles relacionam as mudanças de estado físico ao calor. Trata-se de uma oportunidade para explicar que os materiais podem ser encontrados nos três estados físicos e que se mantêm num determinado estado ou passam de um estado a outro de acordo com a variação da temperatura.
• Explique a eles que parte da parafina é consumida na combustão, transformando-se com o gás oxigênio em gás carbônico, monóxido de carbono e água. Já a parte da parafina que não foi consumida se solidifica após a queima.
• A parafina que reagiu com o oxigênio não caracteriza mudança de estado físico, pois, nesse processo, a queima da parafina produz diferentes componentes. Ademais, essa transformação química não é reversível. Já a transformação física que ocorre com a parafina do estado sólido para o líquido pode ser revertida.
Vela acesa. Vela derretendo.
BNCC
• Os exemplos de transformações químicas apresentadas nesta página fornecem subsídios para os estudantes relatarem transformações dos materiais que ocorrem no dia a dia, quando expostos ao aquecimento, o que favorece o desenvolvimento da habilidade EF04CI02
SUGESTÃO DE ESTRATÉGIA INICIAL
Se julgar conveniente, inicie a abordagem desta página realizando o preparo de um bolo simples com os estudantes. Providencie a receita e os ingredientes e leve todos à cozinha da escola. Faça cada etapa do preparo do bolo, questionando-os se está ocorrendo alguma transformação física. Leve-os a refletir se, ao serem levados ao forno, os ingredientes adicionados na massa do bolo vão manter sua composição e se é possível retornarem às características iniciais.
Oriente-os a ajudar nas etapas do preparo do bolo, mas ficando você responsável por manipular o fogão e outros objetos que possam ser perigosos.
Peça a alguns voluntários que anotem as respostas dadas pela turma aos questionamentos feitos por você durante o preparo do bolo. Essas anotações podem ser retomadas ao final da abordagem sobre transformações químicas para que sejam feitas as correções necessárias.
• Para auxiliar os estudantes na questão 1, pergunte a eles o que acontece na quebra dos ovos. Verifique se eles percebem que a casca, a gema e a clara apenas mudaram de formato, mas não de composição, caracterizando uma transformação física.
7 TRANSFORMAÇÕES QUÍMICAS DOS MATERIAIS
Para preparar um bolo, um confeiteiro realiza diversas etapas. Leia, a seguir, o modo de preparo de uma receita de bolo.
Modo de preparo
• Quebre os ovos.
• Misture os ovos com o açúcar.
• Adicione o leite e o óleo e misture-os com os outros ingredientes.
• Adicione a farinha e misture bem.
• Adicione o fermento químico e mexa a mistura delicadamente.
• Leve a mistura ao forno pré-aquecido a 180 °C para assar.
• Após 45 minutos, verifique se o bolo está assado e retire-o do forno.
Imagem com elementos sem proporção entre si. Cores fantasia.

Representação de um confeiteiro preparando um bolo.
1. Cite uma transformação física que ocorre no preparo do bolo.
Resposta: A quebra dos ovos.
Nas etapas do preparo de um bolo, nem todas as transformações que ocorrem são físicas, algumas são químicas.
As transformações químicas também são chamadas de reações químicas. São transformações em que ocorre a formação de novos materiais, que apresentam propriedades diferentes do material original.
Ao queimar um pedaço de papel (A), por exemplo, ele é transformado em cinzas e ocorre a liberação de calor (B).
A.

• Se julgar interessante, explique aos estudantes que o fermento químico, usado para fazer a massa do bolo crescer, é uma mistura de compostos químicos. Comente que, além desse tipo de fermento, existe o fermento biológico, o qual é, em geral, composto por seres vivos microscópicos chamados leveduras (fungos). O fermento biológico é mais comumente usado no preparo de pães e pizzas. A ação desse tipo de fermento será estudada na unidade 3 deste volume.
B.

Produto formado ao final da queima da folha de papel.
Aparência de uma folha de papel começando a queimar.
Durante o preparo do bolo, quando o fermento químico é adicionado à massa, os compostos químicos presentes nele começam a reagir, liberando gás carbônico. Essa reação química é acelerada com o aquecimento da massa do bolo. O gás carbônico liberado pela reação química se acumula na massa, criando pequenas bolsas de ar que a fazem crescer em volume.
De maneira geral, podemos identificar que ocorreu uma transformação química quando há formação de gases, mudança de cor e liberação de luz ou calor, entre outras evidências.
Observe a seguir outros exemplos de transformações químicas no cotidiano.
Se os objetos de ferro não tiverem proteção, como pintura, eles podem enferrujar.
A ferrugem é a reação do ferro com o gás oxigênio e o vapor de água presentes no ar. A coloração da ferrugem indica que uma nova substância foi formada.
A efervescência observada quando alguns comprimidos são colocados na água também é uma transformação química. Nesse caso, uma das novas substâncias formadas pela reação química é um gás, geralmente, o gás carbônico.
Uma importante transformação química que ocorre naturalmente nos ambientes por ação da luz solar é a fotossíntese
As plantas utilizam a energia da luz solar em uma reação química que transforma a água e o gás carbônico em gás oxigênio e nutrientes para elas.
2. Cite mais dois exemplos de transformações químicas que ocorrem no cotidiano.
Resposta pessoal. Os estudantes podem citar exemplos como o cozimento de alimentos, a respiração, o amadurecimento de frutas e a queima de substâncias ou combustíveis.

Objeto de ferro enferrujado.
sem proporção entre si.
Comprimido efervescente na água.


BNCC
• As reações que ocorrem na formação de ferrugem, na efervescência de comprimidos e na fotossíntese, apresentadas nesta página, contribuem para o desenvolvimento da habilidade EF04CI02, pois incentivam os estudantes a observarem as transformações que ocorrem com materiais do dia a dia.
• A identificação de transformações químicas em situações do cotidiano, com base no conhecimento científico, contribui para desenvolver a Competência específica de Ciências da Natureza 3
• Para auxiliá-los na questão 2, relembre-os das observações que evidenciam as transformações químicas – formação de gases, mudança de cor, liberação de luz ou calor – e peça que tentem se recordar dessas ocorrências em situações do cotidiano.
01/10/2025 09:22:43
Imagens
Planta recebendo luz solar.
AVALIANDO
Objetivo
• A atividade 3 permite avaliar se os estudantes compreenderam o que caracteriza as transformações físicas e as transformações químicas.
Sugestão de intervenção
Para auxiliar os estudantes que apresentarem dificuldades em fazer essa atividade, peça-lhes que, primeiro, definam as características de uma transformação física e de uma transformação química. Verifique se eles compreenderam que, nas transformações físicas, os materiais mantêm sua composição após serem transformados. Já nas transformações químicas, ocorre a formação de novos materiais, que apresentam propriedades diferentes dos materiais originais. Anote as respostas deles na lousa para retomá-las durante a análise dos exemplos 1 e 2
Peça também que citem características que nos permitem deduzir que ocorreu uma transformação química, como a formação de gases, mudanças de cor, liberação de luz ou calor etc. E que observem as imagens do exemplo 1 e descrevam o que aconteceu com o tomate. Verifique se citam que o tomate mudou de cor, caracterizando uma transformação química. Assim, questione que tipo de alteração ocorreu no tomate e na banana. Em seguida, peça que façam a mesma coisa com o exemplo 2. Verifique se eles percebem que a banana sofreu apenas transformação no formato, caracterizando uma transformação física.
TRANSFORMAÇÕES NA NUTRIÇÃO E NA RESPIRAÇÃO
Para manter o organismo em funcionamento adequado, precisamos de alimentos e nutrientes.
Quando comemos, os alimentos passam por transformações físicas na mastigação, sendo cortados, triturados e amassados. Na sequência, passam por diversas transformações químicas no sistema digestório, no qual são quebrados em partículas menores, chamadas nutrientes. Alguns desses nutrientes podem ser utilizados para fornecer energia para nosso organismo. Para que a energia contida nesses nutrientes seja utilizada pelo corpo, eles sofrem diversas transformações, como na respiração. Nesse processo, utilizamos o gás oxigênio que absorvemos do ar e os nutrientes dos alimentos e eliminamos o gás carbônico.


3. No caderno, indique se as transformações que ocorrem de A para B em cada um dos exemplos a seguir são físicas ou químicas.
Resposta: Exemplo 1: transformação química. Exemplo 2: transformação física.
Exemplo 1

Exemplo 2



Imagens sem proporção entre si.
BNCC
• A atividade 3 favorece o desenvolvimento da habilidade EF04CI02, pois leva os estudantes a identificarem e relatarem transformações dos materiais que ocorrem no dia a dia, como a transformação física no preparo da banana amassada e a transformação química no processo de amadurecimento do tomate.
Tomate verde.
Tomate maduro. Banana. Banana amassada.
Crianças alimentando-se.
Criança inspirando o ar.
A.
A.
B.
B.
TRANSFORMAÇÕES REVERSÍVEIS E
IRREVERSÍVEIS
Como você estudou, as transformações podem ser físicas ou químicas, modificando as características físicas do material ou formando outras substâncias, respectivamente.
Agora, observe as situações a seguir.
Situação 1
1. Resposta pessoal. Espera-se que os estudantes respondam que a transformação na situação 1 é física e na situação 2 é química.

Situação 2
Panela aberta com água fervente sobre a chama de um fogão.


Panela tampada com água fervente sobre a chama de um fogão.

1. Classifique as transformações que ocorreram de A para B, em cada uma das situações, em físicas ou químicas, de acordo com suas características.
2. Qual das transformações mostradas pode ser revertida ao que era antes? Justifique sua resposta.
Em determinadas transformações, físicas ou químicas, alguns materiais podem voltar ao que eram antes, como as mudanças de estado físico da água, ou seja, são transformações reversíveis. No entanto, alguns materiais que passam por determinada transformação não retornam ao que eram antes, pois sofreram transformações irreversíveis, como o ovo frito.
2. Resposta pessoal. Espera-se que os estudantes respondam que a transformação que ocorreu com a água, pois a água mudou do estado gasoso para o líquido, e, aquecendo novamente essa água no estado líquido, ela pode voltar a ser gasosa.
• Para auxiliar os estudantes que apresentarem dificuldade na questão 2, leve-os a perceber que a água em estado físico líquido, dentro da panela sobre a chama de um fogão, é aquecida passando para o estado físico gasoso e, quando entra em contato com a tampa da panela, que é mais fria, a água condensa, retornando ao estado físico líquido. Ou seja, quando a água sofre resfriamento, ela retorna ao estado físico de antes do aquecimento, não mudando suas características. Já em relação à transformação que ocorre com o ovo, pergunte se, após retirar a fonte de calor que promove o cozimento do ovo, seria possível que ele retornasse às características de
BNCC
• A análise das situações 1 e 2, apresentadas nesta página, favorece o desenvolvimento das habilidades EF04CI02 e EF04CI03 , pois leva os estudantes a relatarem transformações nos materiais que ocorrem no dia a dia e a concluírem que algumas dessas mudanças, causadas por aquecimento, são reversíveis enquanto outras são irreversíveis.
• Na atividade 1, auxilie os estudantes a identificarem na segunda imagem da situação 1 a presença de gotas de água na tampa da panela. Pergunte-lhes qual mudança ocorreu com o vapor de água quando a panela foi tampada e qual é o nome dessa mudança. Verifique se eles percebem que houve uma mudança de estado físico, em que a água passou do estado físico gasoso para o estado físico líquido, ou seja, o vapor de água condensou ao entrar em contato com a superfície da tampa. Questione-os sobre que tipo de transformação caracteriza a mudança de estado físico da água. Em relação à situação 2, questione-os sobre o que aconteceu com o ovo após ser aquecido. Leve-os a perceber que ocorreu uma mudança de cor, sabor e textura do ovo, caracterizando uma transformação química.
01/10/2025 09:22:54
quando estava cru, levando-os a identificar que essa transformação, diferentemente da mudanças de estado físico, é irreversível.
Ovos crus em uma frigideira sobre a chama de um fogão.
Ovos fritos.
A.
A.
B.
B.
BNCC
• Os dois exemplos mostrados nesta página, da mudança de cor da sílica-gel e do preparo da pipoca, leva os estudantes a concluírem que algumas transformações que ocorrem em nosso dia a dia podem ser reversíveis ou irreversíveis, contribuindo com o desenvolvimento da habilidade EF04CI03
• Ao tratar da sílica-gel, diga aos estudantes que este é um material que pode ser colocado em armários, gavetas, potes de remédios, instrumentos musicais e outros objetos para remover a umidade deles, evitando a ocorrência de ferrugem e a proliferação de mofo.
• Na atividade 3, diga aos estudantes que, embora não seja visível na fotografia, a sílica-gel também aumenta de tamanho nessa transformação, pois ela está absorvendo umidade do ambiente. Depois que eles constatarem que a principal mudança é sua coloração, pergunte se a transformação ocorrida é física ou química.
• Para facilitar a percepção dos estudantes e promover a inclusão, se julgar interessante, leve para a sala de aula grãos de milhos e pipoca. Peça que manipulem os materiais e pergunte quais mudanças ocorreram após os grãos de milho serem aquecidos e transformados em pipoca. Pergunte que tipo de transformação é essa – física ou química – e se é possível revertê-la.
AVALIANDO
Objetivo
• Verificar se os estudantes reconhecem a reversibilidade de uma reação de combustão.
Sugestão de intervenção
Transformações reversíveis são aquelas em que os materiais podem retornar ao estado original após serem transformados.
Transformações irreversíveis são aquelas em que os materiais não podem retornar ao estado original após serem transformados.
Alguns materiais, como a sílica-gel, absorvem a umidade do ambiente, sofrendo uma transformação. Observe as imagens a seguir.


Sílica-gel após absorver umidade.
3. O que aconteceu com a sílica-gel após absorver a umidade do ar?
A transformação que ocorre com a sílica-gel é reversível, pois, se for retirada a umidade dela, voltará a ficar azul.
Já no preparo da pipoca, ocorre uma transformação irreversível. Depois do aquecimento dos grãos de milho, não é possível que eles retornem ao estado inicial.
A transformação do grão de milho de pipoca em pipoca ocorre a uma temperatura aproximada de 180 °C. Nessa temperatura, materiais no interior do grão liberam vapor, aumentando a pressão dentro dele e forçando o seu rompimento.

Imagens sem proporção entre si.

Pipoca pronta para o consumo.
3. Resposta pessoal. Espera-se que os estudantes respondam que a sílica-gel mudou de cor, de azul para rosa.
Peça aos estudantes que retornem à página 38 desta unidade e observem as imagens que apresentam a queima do pedaço de papel. Em seguida, pergunte a eles se a transformação pela qual o papel passou é reversível ou irreversível. Recorde-os de que uma transformação química não precisa ser, necessariamente, irreversível, pois a sílica-gel apresentada nesta página passa por esse tipo de transformação e é reversível.
Sílica-gel antes de absorver umidade.
Grãos de milho de pipoca.
1
COLETIVAMENTE
A transformação do plástico no ambiente
Conhecendo o problema
Respostas nas orientações ao professor
a ) No seu caderno, anote quantos objetos de plástico você costuma utilizar ao longo de um dia. Leia sua lista para um colega.
b ) Dos objetos listados por você e seu colega, quantos são descartados após o primeiro uso?
No nosso dia a dia, utilizamos plástico em diversas atividades que realizamos. O plástico é um material de baixo custo, leve, versátil e produzido a partir de materiais fósseis, como o petróleo. É utilizado, por exemplo, em embalagens de alimento e de produto de limpeza, em brinquedos, em utensílios médicos, de cozinha e de higiene pessoal e mais uma diversidade de itens. Por suas características e seus múltiplos usos, o plástico tem sido produzido e comercializado em grande quantidade.
Produção mundial de plástico (1950-2020)
c ) Observando o gráfico, o que você pode concluir sobre a produção do plástico ao longo das décadas?
Professor, professora: O dado referente ao ano de 2020 representa uma projeção.
BNCC
• O tema abordado na seção incentiva os estudantes a identificarem as principais consequências do descarte inadequado de materiais plásticos no ambiente e a refletirem sobre o consumo excessivo desses materiais, favorecendo o trabalho com os temas contemporâneos transversais Educação ambiental e Educação para o consumo
• Ainda contempla o tema contemporâneo transversal Ciência e tecnologia, pois aborda o desenvolvimento do bioplástico.
• O gráfico apresentado nessa página favorece o desenvolvimento da Competência geral 4, pois leva os estudantes a utilizarem uma linguagem matemática para obter conhecimento.
OBJETIVOS
• Identificar o uso de objetos plásticos em atividades do dia a dia e como seu descarte é realizado.
Fonte de pesquisa: GLOBAL plastic production with projections, 1950 to 2060. Our World In Data. Disponível em: https://ourworldindata.org/grapher/global -plastic-production-projections. Acesso em: 29 maio 2025.
Apesar de sua produção e seu consumo em larga escala, pouco do plástico que é produzido mundialmente é reciclado. Segundo dados da Organização para a Cooperação e Desenvolvimento Econômico (OCDE), cerca de 9% dos resíduos plásticos produzidos no mundo foram reciclados em 2020.
A maior parte dos resíduos plásticos é destinada a aterros sanitários ou é mal gerida, sendo descartada em locais inadequados, causando poluição ambiental.
• Conhecer a transformação do plástico quando descartado de forma inadequada no ambiente.
• Reconhecer a importância do descarte adequado de materiais plásticos.
• Refletir sobre a importância da reciclagem de materiais plásticos.
• Reconhecer atitudes que reduzem o consumo de plástico.
• Adotar atitudes que contribuem para a redução da poluição do ambiente por materiais plásticos.
1. CONHECENDO O PROBLEMA
• Ao trabalhar as questões a e b com os estudantes, peça que avaliem se são consumidores conscientes ou se fazem consumo excessivo de plástico. Questione também se, com os familiares ou responsáveis, fazem a separação e o descarte adequado dos objetos plásticos. Incentive-os a trocar experiências com os colegas, promovendo o engajamento deles.
• Auxilie os estudantes na interpretação dos dados registrados no gráfico e verifique se eles percebem que nele é mostrada a comparação da produção de plásticos nas últimas décadas.
• Comente que o descarte correto do plástico permite destiná-lo às usinas de reciclagem, isso pode contribuir para minimizar a poluição do ambiente, e a coleta seletiva deve tornar-se obrigatória em todos os locais e sujeita a multas caso seja descumprida.
01/10/2025 09:25:17
Respostas
a) Resposta pessoal. O objetivo desta questão é levar os estudantes a identificarem o consumo de plástico no dia a dia.
b) Resposta pessoal. O objetivo desta questão é levar os estudantes a refletirem sobre o consumo de plástico de uso único, como embalagens, canudos, talheres e copos que são utilizados uma única vez e descartados.
c) A produção do plástico aumentou. Espera-se que os estudantes percebam que de 1950 até 2020 essa produção aumentou cerca de 225 vezes.
• Se julgar adequado, explique aos estudantes que as micropartículas e as nanopartículas de plástico são tão pequenas que é impossível vê-las a olho nu, mas, de acordo com uma pesquisa bem recente publicada pela revista Fapesp, essas partículas existem e estão presentes em todos os lugares, de feiras a mercados, presentes em produtos naturais e industrializados.
ARTICULANDO
CONHECIMENTO
Você pode trabalhar o tema contemporâneo transversal Educação ambiental com o professor do componente curricular de Matemática. Para isso, leiam com os estudantes o trecho da reportagem Microplásticos: preocupação mundial e proponham uma atividade em que é possível envolver frações que proporcionem uma melhor compreensão das escalas de milímetro e micrômetro, e explique a eles que 1 mm é a décima parte de 1 cm; 1 micrômetro é a milésima parte de um milímetro.
• Os microplásticos são resultado da degradação de plásticos maiores, mas também podem ser originados de produtos como esfoliantes, roupas sintéticas e pneus.
2. ORGANIZANDO
AS IDEIAS
• Na atividade c, se possível, leve os estudantes a um local da escola com acesso à internet e oriente-os a fazer essa pesquisa em sites de divulgação científica vinculados a instituições de ensino como universidades. Caso não seja possível o acesso à internet, leve para a sala de aula textos de divulgação científica sobre o tema.
O plástico pode demorar mais de 400 anos para ser decomposto no ambiente. Ao longo do tempo, esse material pode ser transformado por diversos fatores. Ação da luz, variações de temperatura, umidade e abrasão podem contribuir para a fragmentação dos plásticos, resultando na formação dos microplásticos. Sobre esse assunto, leia o texto a seguir.
Microplásticos: preocupação mundial
[...]
Microplásticos são pequenas partículas de plástico, com tamanhos variando entre 1 micrômetro (milésima parte de um milímetro) e 5 milímetros. Essas partículas podem ser originadas no meio ambiente pela quebra de plásticos maiores em pedaços menores (denominados ‘microplásticos secundários’) ou partículas de plástico já fabricadas e comercializadas nessa faixa de tamanho (chamadas ‘microplásticos primários’).
Atualmente, os microplásticos já foram encontrados no ar, no solo, em rios, represas, mares, oceanos, plantas, animais e até em órgãos e fluidos humanos, como pulmão, placenta, sangue e leite materno.
NEVES, Raquel A. F. Microplásticos: preocupação mundial. Ciência Hoje, Rio de Janeiro, n. 411, jul. 2024. p. 18.
Placenta: estrutura presente no corpo da fêmea de algumas espécies de mamíferos durante a gestação, por meio da qual ocorre a troca de substâncias entre a mãe e o feto em desenvolvimento.
Organizando as ideias 2
Respostas nas orientações ao professor.
a ) Os plásticos e microplásticos são encontrados hoje em diversos ambientes e nos seres vivos. Em sua opinião, o que contribui para esse fato?
Imagem com elementos sem proporção entre si. Cores fantasia.

Respostas
a) Resposta pessoal. O objetivo desta questão é levar os estudantes a refletirem sobre as causas da poluição por plásticos e microplásticos. Espera-se que eles citem a produção e o consumo excessivo do material, o descarte inadequado dos resíduos plásticos e a baixa taxa de reciclagem do material.
b) Os plásticos de uso único são itens geralmente utilizados uma única vez antes de serem descartados. Os estudantes podem citar como exemplos: copos descartáveis, mexedor de café, canudos plásticos e hastes flexíveis com pontas de algodão.
c) Resposta pessoal. O objetivo desta questão é levar os estudantes a conhecerem os prejuízos à saúde dos seres vivos causados pelo microplástico. Eles podem citar, por exemplo, que os microplásticos podem causar a obstrução do trato digestório e a falsa sensação de saciedade ao serem ingeridos por alguns animais, e que isso pode ocasionar a morte do organismo por falta de alimento. Outros possíveis prejuízos são problemas relacionados à reprodução de seres vivos aquáticos, à capacidade de os microplásticos adsorverem componentes tóxicos do ambiente e de terem em sua constituição compostos que podem ser tóxicos aos organismos.
Representação de produtos embalados em plástico em uma prateleira de supermercado e pessoas diante dela.
b ) Defina o que são plásticos de uso único e cite exemplos desses itens. Se necessário, faça uma pesquisa.
c ) Você acha que os microplásticos podem causar prejuízos aos seres vivos? Junte-se a três colegas e façam uma pesquisa sobre o tema.
Buscando soluções
Respostas nas orientações ao professor
Segundo a Organização das Nações Unidas (ONU), para que a poluição por plásticos possa ser reduzida nos próximos anos, diversas atitudes devem ser adotadas. Confira a seguir algumas delas.
• Reutilizar: buscar soluções, como garrafas reabastecíveis ou sacolas reutilizáveis.
• Reciclar: incentivar financeiramente a reciclagem, reduzir os subsídios para as empresas de matérias-primas fósseis, aumentar o uso de produtos feitos com embalagens já recicladas, entre outros meios.
• Reorientar e diversificar: substituir embalagens plásticas por produtos feitos de materiais que sejam decompostos no ambiente em menor tempo.

Imagem com elementos sem proporção entre si. Cores fantasia. Representação de pessoa com sacola reutilizável em um mercado.
a ) Cite três atitudes que contribuam para a redução da poluição por plástico que você realiza ou que podem ser incluídas na sua rotina. Agora, leia a manchete a seguir, que aborda uma alternativa ao plástico.
Pesquisadores da UFRJ desenvolvem bioplásticos feitos a partir de alimentos
Além de serem uma alternativa para plásticos convencionais, as embalagens podem se decompor em seis meses
NADER, Maria Rita. Pesquisadores da UFRJ desenvolvem bioplásticos feitos a partir de alimentos. Conexão UFRJ, 13 fev. 2025. Disponível em: https://conexao.ufrj.br/2025/02/pesquisadores-da -ufrj-desenvolvem-bioplasticos-feitos-a-partir-de-alimentos/. Acesso em: 29 maio 2025.
b ) Por que o bioplástico citado pode ser considerado uma alternativa menos prejudicial ao ambiente do que os plásticos convencionais?
c ) Junte-se a três colegas e produzam um mural com ações e soluções tecnológicas que possam ajudar a reduzir a poluição por plástico.
imprimir essas reportagens e colar trechos delas no mural.
Respostas
01/10/2025 09:25:18
• O problema do plástico de uso único e dos microplásticos é complexo e exige uma abordagem integrada que envolva sociedade, governos, indústrias e indivíduos. Ao adotar soluções sustentáveis e promover uma mudança cultural em relação ao consumo de plástico, podemos trabalhar juntos para proteger nosso planeta e garantir um futuro mais sustentável para as próximas gerações.
• Trabalhe com os estudantes as atitudes que devem ser adotadas para que a poluição por plástico possa ser reduzida nos próximos anos e destaque outras, como Educação e Conscientização, Inovação em Materiais, Legislação e Políticas Públicas.
• Ao trabalhar o item a, pergunte aos estudantes se eles têm o hábito de refletir sobre o plástico que consomem. Pergunte a eles se costumam analisar as embalagens que manipulam no dia a dia, para verificar se são recicláveis ou recicladas. Pergunte também se eles têm o hábito de não utilizar canudos e copos plásticos, optando pelo uso de itens reutilizáveis. Conduza-os a refletir se todo o plástico que consomem é de fato necessário ou pode ser substituído.
• No item b, questione os estudantes sobre a importância do apoio financeiro a pesquisas que busquem alternativas para o uso e a poluição do plástico, levando-os a refletir sobre a importância do investimento em ciência e tecnologia no enfrentamento de problemas globais. Espera-se que eles comentem que essas pesquisas são fundamentais para a descoberta e aplicabilidade de novos materiais.
• No item c, incentive os estudantes a, com os pais ou responsáveis, pesquisarem em sites confiáveis notícias sobre materiais que sejam menos prejudiciais ao ambiente e que sirvam de alternativa para o plástico. Eles podem, por exemplo,
a) Resposta pessoal. Os estudantes podem citar a reutilização de embalagens plásticas, a separação e destinação adequada das embalagens para a reciclagem e o uso de materiais reutilizáveis, como sacolas de tecidos e canudos de metal, em substituição a itens plásticos de uso único.
b) Espera-se que os estudantes comentem que o bioplástico citado no trecho da
reportagem se decompõe muito mais rapidamente do que o plástico convencional no ambiente e que, portanto, seria uma alternativa menos poluente.
c) O objetivo desta questão é levar os estudantes a compartilharem soluções para reduzir a poluição por plástico no ambiente escolar. Eles podem incluir no mural atitudes que costumam ter e que possam reduzir a poluição por plástico e tecnológicas, com base em informações obtidas em sites confiáveis.
BNCC
• Essa investigação favorece o desenvolvimento da Competência geral 2 e das Competências específicas de Ciências da Natureza 2 e 3, pois incentiva os estudantes a dominarem processos, práticas e procedimentos da investigação científica, além de analisarem e explicarem fenômenos relacionados ao mundo natural, como a decomposição da matéria orgânica, com base nos conhecimentos das Ciências da Natureza.
OBJETIVOS
• Observar e registrar os diferentes estágios de decomposição de folhas de plantas ao longo de várias semanas.
• Perceber a transformação da matéria orgânica por meio da decomposição.
• Antes de iniciar a atividade investigativa, verifique possíveis adaptações em espaços físicos e/ou materiais para que a atividade seja realizada por todos os estudantes.
• Inicie a prática cerca de um mês antes de abordar o tema 9. Os restos de folhas verdes de diferentes plantas podem ser colhidos próximo às plantas caídas no chão, em um jardim, pomar ou horta.
• A atividade pode ser realizada usando garrafas PET de 2 litros. Basta cortá-las e deixá-las com a mesma altura, formando potes.
Resposta a) Resposta pessoal. O objetivo desta questão é levar os estudantes a levantarem hipóteses sobre o que acontece com as folhas de árvore alguns dias após caírem no chão. Espera-se que eles digam que as folhas vão ser degradadas ou decompostas no ambiente.
• A decomposição da matéria orgânica também fa-
9 A TRANSFORMAÇÃO DA MATÉRIA ORGÂNICA: DECOMPOSIÇÃO
VAMOS INVESTIGAR
a ) Em sua opinião, o que acontece com as folhas das árvores alguns dias após caírem no chão?
Resposta nas orientações ao professor
MATERIAIS NECESSÁRIOS
• terra vegetal
• 5 potes plásticos transparentes
A. B. C. D.
E. F. G. H.
• caneta permanente
• folhas verdes de plantas diversas
Adicione terra vegetal a cada um dos potes plásticos até atingir cerca de 3 4 da altura.
Com a caneta permanente, enumere os potes de 1 a 5.
Adicione as folhas no pote 1, até enchê-lo, e anote a data.
Coloque todos os potes em um local coberto e arejado. Umedeça os solos diariamente, sem encharcá-los.
• água

Terra vegetal sendo adicionada a um dos potes plásticos.
Após sete dias, coloque folhas no pote 2 até preenchê-lo e anote a data.
Após 14 dias, coloque folhas no pote 3 até preenchê-lo e anote a data.
Após 21 dias, coloque folhas no pote 4 até preenchê-lo e anote a data.
Após 28 dias, coloque folhas no pote 5
Agora, responda às questões a seguir no caderno.
Respostas nas orientações ao professor
1. Após 28 dias, o que aconteceu com as folhas em cada um dos potes?
2. Caso você tenha observado transformações nas folhas, o que acha que foi responsável por essa transformação?
vorece a fertilidade do solo, pois contribui para a formação de húmus, uma substância rica em nutrientes que aumenta a capacidade de retenção de água e aeração do solo.
• Na atividade 1, oriente os estudantes a observarem primeiro o pote 5, com as folhas recém-adicionadas e que ainda não sofreram decomposição, e peça que comparem os resultados dos potes 4, 3, 2 e 1, respectivamente, com esse pote.
Respostas
1. Espera-se que os estudantes respondam que as folhas foram degradadas, ou seja, sofreram decomposição, e que em cada pote as folhas
encontram-se em diferentes estágios de decomposição. Espera-se que eles descrevam que o material no pote 1 é o mais avançado no estágio de decomposição; e o 4, o de menor avanço. Já as folhas do pote 5, como foram recém-adicionadas, ainda não terão sofrido decomposição. Verifique se eles notam mudanças nas folhas como a perda de coloração.
2. Resposta pessoal. O objetivo desta atividade é levantar os conhecimentos prévios dos estudantes sobre a decomposição, que promove a reciclagem de nutrientes do solo.
1. Resposta nas orientações ao professor
1. Considere o solo de uma floresta, como o mostrado na fotografia, coberto de folhas e galhos que caíram das árvores. O que aconteceria com os restos vegetais se eles não fossem decompostos?
Como você estudou anteriormente, quando um material demora um longo tempo para se decompor no ambiente, como o plástico, ele pode se acumular e causar problemas ambientais, como a poluição.
A matéria orgânica, como restos de vegetais e animais mortos, não se acumula graças a um processo que ocorre no ambiente chamado decomposição

A decomposição é realizada por alguns organismos, como fungos e bactérias, chamados decompositores. Esses organismos podem estar presentes, por exemplo, no solo e na água, onde atuam na decomposição da matéria orgânica.

Fungos Resinicium bicolor em restos de madeira. Imagem ampliada cerca de 1 200 vezes e colorida em computador.
Os decompositores obtêm a energia e os nutrientes necessários à sua sobrevivência da matéria orgânica que decompõem. Ao realizarem esse processo, liberam no ambiente nutrientes, como alguns nutrientes minerais e gás carbônico, que poderão ser absorvidos e utilizados por outros seres vivos, como as plantas.
As plantas, por sua vez, utilizam os nutrientes do ambiente para produzir o próprio alimento, e, quando consumidas, elas poderão nutrir outros animais por meio das relações alimentares. É esse assunto que vamos estudar a seguir.
BNCC
• A abordagem desta página contribui para desenvolver a habilidade EF04CI06, ao relacionar a participação de fungos e bactérias no processo de decomposição da matéria orgânica em substâncias que serão devolvidas ao ambiente e poderão ser utilizadas pelas plantas, por exemplo.
• Ao trabalhar a questão 1, aproveite o momento para comparar o tempo de decomposição da matéria orgânica, trabalhado na seção Vamos investigar, da página 46, com o tempo de decomposição dos resíduos plásticos abordados anteriormente na seção Coletivamente. Verifique se os estudantes percebem que, se a matéria orgânica não sofresse decomposição ou demorasse muito tempo para se decompor, assim como o plástico, ela poderia acumular-se no ambiente e também se tornar um problema ambiental.
• Comente com eles que a velocidade com que a decomposição ocorre pode variar em razão de fatores como temperatura, umidade e presença ou ausência de oxigênio. Aproveite o momento e pergunte aos estudantes por que acham que o solo não poderia ser encharcado ao fazer o experimento da seção Vamos investigar, da página 46 Verifique se comentam que encharcar o solo com água poderia comprometer a disponibilidade de oxigênio contida no solo.
• Leia a legenda da imagem do fungo Resinicium bicolor em restos de madeira com os estudantes e explique que “colorida em computador” quer dizer que as cores da imagem não são reais, ou seja, elas foram aplicadas quando analisadas em computador, para facilitar sua compreensão.
• Se julgar pertinente, comente que quando a decomposição ocorre na ausência de oxigênio pode haver a formação e liberação de metano e gás carbônico, que, em determinadas situações, podem ser aproveitados como biocombustíveis (biogás). Esse assunto será abordado na Unidade 4 deste volume.
Resposta
01/10/2025 09:25:23
1. O objetivo desta questão é levar os estudantes a refletirem sobre a importância da decomposição. Eles podem comentar que os restos de vegetais se acumulariam ao longo dos anos, bem como toda a matéria orgânica no planeta.
Folhas de árvores no chão de uma floresta.
fungo
madeira
INFOGRÁFICO CLICÁVEL: COMPOSTAGEM
BNCC
• O conteúdo desta página contribui para o desenvolvimento da habilidade EF04CI04, uma vez que os estudantes podem identificar o papel do Sol como fonte primária de energia para os seres vivos. As atividades 2 e 3 contribuem para o desenvolvimento da habilidade EF04CI05, pois permitem que constatem algumas diferenças entre o ciclo da matéria e o fluxo de energia.
• Se os estudantes apresentarem dificuldade para responder à atividade 1, retome o conteúdo sobre os componentes do ambiente pedindo que identifiquem qual é o ser vivo e o componente não vivo da fotografia. Em seguida, pergunte-lhes se as plantas precisam de luz solar para sobreviver ou se ela é dispensável.
• Na atividade 2, caso os estudantes tenham dificuldade para responder, auxilie-os a relembrar que o processo de fotossíntese é uma transformação química. Pergunte a eles quais são os componentes não vivos do ambiente que estão envolvidos na fotossíntese. Após relembrarem que a planta utiliza gás carbônico, água e luz solar para formar gás oxigênio e nutrientes, questione se esse processo é uma transformação física ou química. Posteriormente, pergunte qual é a importância dos nutrientes para a planta e se um animal herbívoro também pode se beneficiar deles.
• Ao comentar o processo de fotossíntese, se julgar pertinente, apresente um esquema que ilustre todos os componentes envolvidos nesse processo.
• Depois que os estudantes responderem à atividade 3, pergunte o que acontecerá com os nutrientes produzidos pela planta e ingeridos pelo animal. Nesse momento, espera-se que eles per-
10TEMA
2. Resposta: Espera-se que os estudantes respondam que ocorre uma transformação química. Essa reação é importante para a produção de nutrientes para as plantas, que, muitas vezes, servem de alimento para outros seres vivos.
CADEIAS ALIMENTARES
1. Resposta: Espera-se que os estudantes digam que as plantas utilizam a luz solar no processo de fotossíntese, no qual elas produzem seu alimento.
1. Qual é a relação entre o ser vivo e o componente não vivo mostrado na fotografia? Converse com os colegas sobre o assunto.
2. Qual é o tipo de transformação que ocorre naturalmente por ação da luz solar nas plantas? Qual é a importância dessa transformação para os seres vivos?

As plantas interagem com o ambiente para produzir o próprio alimento, captando a energia luminosa da luz solar, a água e o gás carbônico, que são transformados em gás oxigênio e nutrientes. Assim, a luz solar é uma fonte primária de energia para os seres vivos no planeta Terra. Observe a imagem a seguir.
Veado-campeiro (adulto): pode atingir cerca de 1,4 m de comprimento.

3. Como o veado-campeiro está interagindo com a planta? Os seres vivos podem interagir com o ambiente e com outros seres vivos. Essas interações ocorrem de diferentes maneiras, como por meio da alimentação.
3. Resposta: Espera-se que os estudantes respondam que o veado-campeiro está usando a planta como alimento.
cebam que esses nutrientes serão aproveitados pelo organismo do animal para obter energia.
• Ao ler o primeiro parágrafo com os estudantes, pergunte o que eles entendem por fonte primária de energia para os seres vivos na Terra. Verifique se eles percebem que esse trecho se refere à capacidade que as plantas têm de produzir seu próprio alimento e que isso está relacionado à conversão de energia luminosa em um tipo de energia que pode ser utilizado pelos seres vivos para se desenvolverem.
Folhas de vegetação expostas à luz solar.
Filhote de veado-campeiro.
BNCC
Diferentemente das plantas, os animais não são capazes de produzir o próprio alimento. Eles precisam se alimentar de outros seres vivos, como partes de plantas ou de outros animais.
4. Associe as imagens dos animais mostrados na primeira coluna (A, B e C) ao tipo de alimento que cada um ingere, na segunda coluna (1, 2 e 3).
Peixe-boi-marinho: pode atingir cerca de 4,5 m de comprimento.

O peixe-boi é um animal herbívoro.
Ariranha: pode atingir cerca de 1,8 m de comprimento.

A ariranha é um animal carnívoro.
Lobo-guará: pode atingir cerca de 1,5 m de comprimento.

O lobo-guará é um animal onívoro.
Resposta: A – 2; B – 3; C – 1.
Alimenta-se de pequenas aves, pequenos mamíferos, como roedores, além de insetos, frutos e sementes.
Alimenta-se somente de vegetais.
Alimenta-se principalmente de peixes.
01/10/2025 09:25:29
• A atividade 4, ao apresentar fotografias de relações alimentares entre seres vivos, colabora para o desenvolvimento da habilidade EF04CI04 , pois fornece subsídios para os estudantes analisarem a posição ocupada por determinados animais em uma cadeia alimentar.
• Se julgar pertinente, antes de iniciar a atividade desta página com os estudantes, primeiro, levante os conhecimentos prévios deles a respeito dos termos carnívoros, herbívoro e onívoros. Anote as respostas deles na lousa. Você pode solicitar que procurem esses termos no dicionário. Depois de definir com os estudantes esses termos, peça que façam a atividade 4. Leve-os a identificarem o tipo de alimento que os animais mostrados nas imagens consomem. Provavelmente, classificarão o lobo-guará e a ariranha como carnívoros. Nesse momento, peça que eles leiam as sentenças referentes aos tipos de alimentação que os diferentes animais podem fazer. Leve-os a identificar em qual sentença o alimento observado em cada imagem está descrito.
• Complemente a atividade 4 solicitando aos estudantes que citem exemplos de outros animais carnívoros, herbívoros e onívoros. Faça um quadro na lousa com três colunas, uma para cada categoria, e escreva o nome dos animais citados por eles, acolhendo suas respostas e fazendo as correções necessárias.
A.
B.
C.
BNCC
• A abordagem desta página contribui para o desenvolvimento das habilidades EF04CI04, EF04CI05 e EF04CI06, pois incentiva os estudantes a analisarem uma cadeia alimentar simples, identificando a posição ocupada nela pelos seres vivos; além disso, leva-os a compreender que o Sol é uma fonte primária de energia. Essa abordagem também fornece subsídios para que eles analisem as semelhanças entre o ciclo da matéria e o fluxo de energia e relacionarem a participação de fungos e bactérias no processo de decomposição.
• Inicie a abordagem desta página solicitando aos estudantes que observem o esquema da cadeia alimentar. Peça a eles que, voluntariamente, expliquem o que esse esquema representa. Verifique se respondem que se trata de uma cadeia alimentar e se refletem sobre a relação alimentar que ela representa. Acolha as respostas deles, fazendo as correções necessárias.
• Explique aos estudantes que as setas representadas no esquema podem ser lidas como “serve de alimento para”. Faça essa leitura na seta que aponta do capim para o preá e peça-lhes que façam o mesmo com o restante das setas do esquema. Nesse momento, peça a eles que respondam à questão 6 desta página.
• Se os estudantes tiverem dificuldade para responder à atividade 6, peça-lhes que observem do que os animais estão se alimentando na imagem, ou o que eles pretendem caçar para poder se alimentarem. Explique que os organismos decompositores não precisam ser classificados.
• Diga a eles que o Sol é a fonte primária de energia e que ajuda as plantas a rea-
Há uma sequência de relações alimentares entre os seres vivos, por meio da qual um transfere energia e nutrientes para o outro. Essa sequência de relações alimentares é chamada de cadeia alimentar
Cada ser vivo ocupa determinada posição em uma cadeia alimentar, podendo ser classificado em produtor, consumidor ou decompositor
5. Qual é a importância da alimentação para os seres vivos?
6. Classifique os animais da cadeia alimentar a seguir em herbívoros ou carnívoros.
Imagem com elementos sem proporção entre si. Cores fantasia.
Dica: As setas indicam a passagem de nutrientes ou o fluxo de energia de um ser para o outro nas cadeias alimentares.
5. Resposta: Espera-se que os estudantes comentem que a alimentação é importante para os seres vivos porque é por meio dela que eles obtêm a energia e os nutrientes de que necessitam para se desenvolverem.

6. Resposta: O preá é um animal herbívoro, e a suçuarana é um animal carnívoro.
lizarem a fotossíntese e a armazenarem nutrientes. Quando um animal herbívoro, como o preá, come a planta, parte dos nutrientes dela passam para o preá. Quando um animal carnívoro, como a suçuarana, come o preá, parte dos nutrientes dele passam para a suçuarana.
• Caso os estudantes tenham dificuldade com a atividade 5, pergunte se os seres vivos conseguiriam se desenvolver sem adquirir energia e nutrientes. Em seguida, comente que a energia e os nutrientes são obtidos pelos animais por meio da alimentação, já que eles não produzem seu próprio alimento.
Representação de uma cadeia alimentar em um ambiente terrestre. Nesta imagem, os organismos decompositores estão ampliados.
BNCC

O capim produz o próprio alimento por meio da fotossíntese. Por isso, é classificado como produtor

Representação do capim. Representação do preá.

Representação da suçuarana.
O preá não produz o próprio alimento e consome outro ser vivo, principalmente o capim, para obter energia e nutrientes. Por isso, ele é considerado um consumidor
A suçuarana também ocupa a posição de consumidor na cadeia alimentar, pois não produz o próprio alimento e consome outro ser vivo: o preá.
Professor, professora: Caso ocorram em uma cadeia

Representação das bactérias e fungos decompositores
Seres vivos decompositores, como fungos e bactérias, realizam a decomposição da matéria orgânica no ambiente. Eles consomem restos de plantas e de animais, como a suçuarana e o preá.
Imagens com elementos sem proporção entre si. Cores fantasia.
consumidores em níveis posteriores ao secundário, eles serão chamados de consumidores terciários, quaternários, e assim sucessivamente.
O preá e a suçuarana são consumidores, mas ocupam posições diferentes na cadeia alimentar. Dependendo da posição que o consumidor ocupa, ele pode ser classificado em primário, secundário ou terciário, e assim sucessivamente.
Por exemplo, o ser vivo que se alimenta do produtor em uma cadeia alimentar é chamado de consumidor primário. Já o ser vivo que se alimenta do consumidor primário em uma cadeia alimentar é o consumidor secundário.
7. Qual animal é o consumidor primário e qual é o consumidor secundário nessa cadeia alimentar?
Resposta: O preá é o consumidor primário, e a suçuarana é o consumidor secundário.
identifiquem quantos consumidores existem em uma cadeia em que o preá se alimenta do produtor, o lobo-guará se alimenta do preá e a suçuarana se alimenta do lobo-guará. Espera-se que eles identifiquem o preá como consumidor primário, o lobo-guará como consumidor secundário e a suçuarana como consumidor terciário.
ATIVIDADE EXTRA
Se julgar pertinente, faça com os estudantes uma atividade que explore a cons-
trução de outra cadeia alimentar. Para isso, prepare antecipadamente 16 fichas feitas de cartolina. Em quatro fichas, cole a imagem de capim; em outras quatro fichas, cole a imagem de um bisão; em outras quatro, cole a imagem de um lobo-cinzento e, nas últimas quatro fichas, cole a imagem de fungos e bactérias decompositoras.
Organize a turma em quatro grupos e distribua quatro fichas (capim, bisão, lobo-cinzento e bactéria e fungos decompositores) para cada um. Cada grupo
• A atividade 7 desta página complementa o trabalho com a habilidade EF04CI04, pois incentiva os estudantes a identificarem e atribuírem a posição ocupada pelos seres vivos da cadeia alimentar apresentada.
• Após trabalhar a classificação dos consumidores de acordo com a posição na cadeia alimentar, explique aos estudantes que a categorização em consumidor primário, secundário e terciário e assim sucessivamente, é realizada somente para os consumidores; os produtores e decompositores não recebem esse tipo de denominação.
• Na atividade 7, caso os estudantes apresentem dificuldade, peça-lhes que observem novamente o esquema da página 50 e identifiquem o ser vivo produtor e o animal que se alimenta dele, levando-os a identificar o consumidor primário. Depois, peça a eles que identifiquem o animal que se alimenta do consumidor primário. Ao fazer a atividade dessa forma, os estudantes serão capazes de observar com maior facilidade a diferença na posição dos consumidores.
• Ao realizar a atividade 7 com os estudantes, aproveite o momento e diga a eles que, além da suçuarana, o lobo-guará se alimenta do preá. Peça que
01/10/2025 09:25:33
deverá montar a cadeia alimentar utilizando as fichas. Oriente-os a colar as fichas sobre uma folha de papel sulfite, posicionando cada ser vivo na cadeia alimentar. Oriente-os a desenhar as setas indicando a passagem de nutrientes e o fluxo de energia.
Para finalizar, promova um tempo para que os grupos compartilhem o resultado da atividade com os colegas. Em seguida, faça as correções necessárias e exponha as cadeias em um mural na sala de aula.
BNCC
• A atividade 8 desta página contribui para o desenvolvimento das habilidades EF04CI04 e EF04CI06 , pois incentiva os estudantes a analisarem uma cadeia alimentar, identificarem a posição ocupada pelos seres vivos e reconhecerem a participação de fungos e bactérias como agentes decompositores.
• Na atividade 9, caso os estudantes respondam que os seres vivos só podem ter uma posição na cadeia alimentar, questione se os animais se alimentam exclusivamente de um único ser vivo. Como exemplo, peça-lhes que retornem ao esquema da cadeia alimentar representada na página 50 e pergunte se a suçuarana se alimenta apenas de preás na natureza, ou se ela pode se alimentar de outros animais, inclusive animais que se alimentam de preás.
• Na questão 10, caso os estudantes tenham dificuldade para perceber que o ser humano pode ocupar diferentes posições como consumidor, peça-lhes que escrevam no caderno as duas cadeias alimentares a seguir: alface galinha ser humano; alface ser humano. Em seguida, solicite-lhes que classifiquem o ser humano nas duas cadeias e verifique se eles o classificam como consumidor secundário na primeira e como consumidor primário na segunda.
Respostas
9. Resposta pessoal. O objetivo desta questão é conduzir os estudantes a pensarem no conceito de teia alimentar.
10. Resposta pessoal. O objetivo desta questão é levar os estudantes a perceberem, por meio dos hábitos alimentares do ser humano, que outros animais também podem ocupar mais de um lugar na cadeia alimentar.
8. As cadeias alimentares também ocorrem no ambiente aquático, onde o fitoplâncton realiza a fotossíntese. Observe a cadeia alimentar a seguir.
Imagem com elementos sem proporção entre si. Cores fantasia.

Representação artística de uma cadeia alimentar em um ambiente aquático. Nesta imagem, os fungos, as bactérias e o fitoplâncton estão ampliados.
Fitoplâncton: conjunto de seres vivos microscópicos que vivem em ambiente aquático.
a ) Identifique o produtor, os decompositores e os consumidores primário, secundário e terciário da cadeia alimentar.
b ) Qual é a importância dos fungos e bactérias nessa cadeia alimentar?
Resposta: Os fungos e as bactérias decompõem os restos do fitoplâncton e dos animais.
9. Em sua opinião, um mesmo ser vivo pode ocupar mais de uma posição na cadeia alimentar?
Resposta nas orientações ao professor
10. Agora, pense no ser humano, que pode se alimentar de plantas e de animais. Responda novamente à questão anterior.
Resposta nas orientações ao professor.
Os animais onívoros podem ocupar mais de uma posição em uma cadeia alimentar, atuando como diferentes tipos de consumidor. Eles podem variar a alimentação, ora se alimentando de plantas, ora consumindo outros animais.
O ser humano, o cachorro, o lobo-guará, a ema e a galinha são exemplos de animais onívoros.
A alimentação dos seres humanos pode incluir alimentos de origem animal e de origem vegetal.

Prato com arroz, feijão, carne de frango e salada.
8. a) Resposta: Produtor: fitoplâncton. Consumidor primário: lambari. Consumidor secundário: dourado. Consumidor terciário: lontra. Decompositores: fungos e bactérias.
AVALIANDO
Objetivo
• A atividade 8 permite avaliar se os estudantes conseguem identificar a posição ocupada pelos seres vivos em uma cadeia alimentar e reconhecer a importância dos seres decompositores para o ambiente.
Sugestão de intervenção
Caso os estudantes apresentem dificuldade para responder ao item a, explique a eles que o fitoplâncton refere-se ao conjunto de seres vivos microscópicos capazes de realizar fotossíntese. Com base nessa explicação, peça que identifiquem os produtores, os consumidores e decompositores da cadeia alimentar aquática representada na atividade. Verifique se eles identificam os fungos e as bactérias como decompositores, contribuindo para a respostas deles ao item b
lontra
dourado lambari
fitoplâncton
alguns fungos e bactérias
Além de o ser vivo ocupar diferentes posições em uma cadeia alimentar, pode fazer parte de mais de uma dessas cadeias. Dessa forma, elas podem ser interligadas, formando teias alimentares.
Observe a teia alimentar a seguir.
Imagem com elementos sem proporção entre si. Cores fantasia.

veado-campeiro
seres vivos decompositores suçuarana
BNCC
• O conteúdo dessa página contribui para o desenvolvimento das habilidades EF04CI04 e EF04CI06 , pois, com base na teia alimentar apresentada, os estudantes devem construir cadeias alimentares simples, com a inclusão da participação de seres vivos decompositores.
capim
gafanhoto preá
Representação de uma teia alimentar em um ambiente terrestre. Nesta imagem, os organismos decompositores estão ampliados.
11. Identifique e escreva no caderno três cadeias alimentares presentes nessa teia alimentar.
Resposta nas orientações ao professor
seguida, peça que encontrem os consumidores secundários e terciários. Algumas cadeias apresentam apenas consumidores primários, outras apenas consumidores primários e secundários. E por fim, algumas apresentam do consumidor primário ao quaternário.
Resposta
11. Os estudantes podem identificar cadeias alimentares como: capim preá suçuarana; capim gafanhoto teiú suçuarana; capim gafanhoto sapo-ferreiro teiú; capim gafanhoto; capim veado-campeiro suçuarana; capim gafanhoto
• Durante a leitura sobre as teias alimentares, diga aos estudantes que a teia alimentar é um conjunto de duas ou mais cadeias alimentares, ou seja, ela conecta diferentes cadeias alimentares. Isso permite que um mesmo ser vivo possa ocupar diferentes posições nessas cadeias. Para que isso fique evidente, peça-lhes que digam que tipo de consumidor o preá é no esquema dessa página e auxilie-os a identificar que o preá pode ser um consumidor primário (quando se alimenta do capim) ou secundário (quando se alimenta do gafanhoto).
• Se os estudantes apresentarem dificuldade para isolar as cadeias alimentares no esquema da atividade 11, ajude-os perguntando qual ser vivo representa o produtor e, baseando-se nele, organizar as cadeias. Se eles ainda não forem capazes de identificá-las, pergunte quais animais se alimentam desse produtor, definindo os consumidores primários de cada cadeia. Em
01/10/2025 09:25:35
sapo-ferreiro teiú suçuarana. Para todas as cadeias identificadas, eles devem representar setas partindo de todos os seres vivos que as compõem em direção aos decompositores.
BNCC
• O esquema sobre o fluxo de energia apresentado nessa página colabora para o desenvolvimento da habilidade EF04CI05 , uma vez que fornece subsídios para que os estudantes consigam descrever semelhanças e diferenças entre o ciclo da matéria e o fluxo de energia entre os componentes vivos e não vivos de um ecossistema.
SUGESTÃO DE ESTRATÉGIA INICIAL
Se julgar interessante, antes de iniciar o trabalho desta página com os estudantes, reproduza o esquema de transferência de energia ao longo de uma cadeia alimentar na lousa. Escreva o nome dos componentes da cadeia e faça as setas com tamanhos reduzidos ao longo da cadeia alimentar. Solicite que observem as setas dessa cadeia alimentar e pergunte se eles sabem por que o tamanho das setas está se reduzindo ao longo da cadeia alimentar. Pergunte se eles acham que a quantidade de energia proveniente do Sol, obtida na produção de alimento pela planta, é a mesma disponível para o consumidor primário que se alimenta dessa planta.
Aproveite e pergunte se acham que a quantidade de nutrientes disponível para o consumidor primário é a mesma disponível para o consumidor secundário, ou parte dela é perdida.
Após realizar essa estratégia, leia com os estudantes os textos dessa página, enfatizando que, a cada nível da cadeia alimentar, a energia transferida é menor em razão da dissipação para o ambiente e ao uso da energia pelo ser vivo do nível anterior.
• Explique que as setas vermelhas que partem do capim, do preá e da suçuarana
TRANSFERÊNCIA
DE NUTRIENTES E DE ENERGIA NAS CADEIAS ALIMENTARES
Como você estudou, a cadeia alimentar envolve a transferência de energia e de nutrientes. Alguns seres vivos, como as plantas, são capazes de produzir o próprio alimento. Do alimento que produzem, elas obtêm a energia de que necessitam para crescer e se desenvolver, por exemplo.
Já outros seres vivos, como os animais, obtêm os nutrientes e a energia de que precisam ao se alimentarem de outros seres vivos.
Acompanhe o esquema a seguir.
Transferência de energia em uma cadeia alimentar
Fonte de pesquisa: SADAVA, David. et al Vida: a ciência da Biologia. Tradução de Ardala
Imagem com elementos sem proporção entre si. Cores fantasia.
Dica: Neste esquema, a espessura das setas (amarelas) diminui ao longo da cadeia, indicando redução da quantidade de energia.

O Sol é a fonte primária de energia em uma cadeia alimentar.
Cada ser vivo utiliza parte da energia para o funcionamento do organismo e parte dela é perdida (seta vermelha) sob a forma de calor, por exemplo.
O capim utiliza a energia da luz solar para produzir seu alimento. Parte dessa energia fica armazenada nele.
Ao se alimentar do capim, o preá obtém parte da energia presente nessa planta.
Ao se alimentar do preá, a suçuarana obtém parte da energia presente nele.
12. Na cadeia que você acabou de estudar, toda a energia luminosa fixada pelo capim estará disponível para o preá?
Resposta nas orientações ao professor.
13. À medida que se distancia do produtor, o que ocorre com a energia disponibilizada ao consumidor ao longo de uma cadeia?
Resposta nas orientações ao professor
O fluxo de energia ao longo de uma cadeia alimentar é unidirecional, ou seja, ocorre do produtor em direção aos consumidores. Já o fluxo da matéria, como você estudou, ocorre de maneira cíclica.
representam a energia dissipada para o ambiente, principalmente, na forma de calor. A transferência de energia ocorre em apenas uma direção, partindo do organismo que produz seu próprio alimento, como as plantas, para os demais seres vivos envolvidos na relação alimentar.
• Na questão 13, oriente os estudantes a observarem as espessuras das setas amarelas no esquema, que representam a quantidade de energia que é disponibilizada de um nível trófico ao outro da cadeia. Verifique se eles observam que as espessuras das setas diminuem ao longo da cadeia alimentar.
Respostas
12. Não. Parte da energia obtida pelo capim por meio da fotossíntese é utilizada por ele para sua manutenção, crescimento e desenvolvimento. Apenas a energia não utilizada por esse organismo ficará disponível para o consumidor primário, nesse caso, o preá.
13. Espera-se que os estudantes comentem que, à medida que se distancia do produtor, a energia disponibilizada ao consumidor diminui.
Katzfuss et al. 11. ed. Porto Alegre: Artmed, 2020. v. 2. p. 802.
Representação do fluxo de energia em uma cadeia alimentar.
Sol 1.
capim 2.
preá 3. suçuarana 4.
Os nutrientes são transferidos entre os seres vivos, da fonte de alimento para aquele que a consome.
Transferência de matéria em uma cadeia alimentar
preá 2.
capim 1.
Imagem com elementos sem proporção entre si. Cores fantasia.

suçuarana 3.
decompositores 4.
Representação da transferência de matéria em uma cadeia alimentar.
Fonte de pesquisa: SADAVA, David.; HILLIS, David. et al Vida: a ciência da Biologia. Tradução de Ardala Katzfuss et al. 11. ed. Porto Alegre: Artmed, 2020. v. 2. p. 802.
A matéria orgânica proveniente do capim (1), do preá (2) e da suçuarana (3) é transformada por seres vivos decompositores (4). A decomposição transforma a matéria orgânica em materiais mais simples (nutrientes), que são liberados no ambiente e podem ser absorvidos por outros seres vivos, como as plantas. Assim, a matéria retorna às cadeias alimentares.
14. Explique com suas palavras a frase a seguir.
Resposta nas orientações ao professor
“Diferentemente do que ocorre com a matéria, a quantidade de energia diminui a cada nível da cadeia alimentar.”
CADEIAS ALIMENTARES EM QUE A FONTE PRIMÁRIA DE ENERGIA NÃO É A LUZ SOLAR
Nas profundezas dos oceanos, nas chamadas zonas abissais, certas bactérias que vivem nesse ambiente utilizam materiais presentes nas fontes de água quente, originadas de fendas vulcânicas, para produzir energia. Esse processo é chamado de quimiossíntese e não utiliza a luz solar como fonte primária de energia.
Essas bactérias são a base da cadeia alimentar nessas zonas.
Fonte de água quente nas profundezas do Oceano Pacífico, em 2024.
Resposta
14. Resposta pessoal. Espera-se que os estudantes percebam que os nutrientes são transferidos entre os seres vivos, daquele que é fonte de alimento para aquele que o consome, e podem retornar ao ambiente em razão da ação dos seres vivos decompositores. Já na transferência de energia, cada ser vivo utiliza parte da energia para o funcionamento do organismo e outra parte é perdida sob a forma de calor, assim, a quantidade de energia diminui a cada nível trófico.

BNCC
• A análise da cadeia alimentar apresentada nessa página contribui para desenvolver a habilidade EF04CI04
• A atividade 14 favorece o desenvolvimento da habilidade EF04CI05 , pois incentiva os estudantes a descreverem semelhanças e diferenças entre o ciclo da matéria e o fluxo de energia entre os componentes vivos e não vivos de um ecossistema.
• Se os estudantes apresentarem dificuldade para explicar a frase da atividade 14, questione-os por que a energia diminui ao longo da cadeia alimentar. Se necessário, retome com eles o esquema da página 51. Verifique se eles respondem que os seres vivos da cadeia utilizam parte da energia para o funcionamento do organismo e outra parte é perdida sob a forma de calor. Leve-os a refletir que isso não acontece com a matéria orgânica, pois os nutrientes liberados no ambiente pela decomposição são reaproveitados pelos seres vivos, como as plantas (produtores), retornando para as cadeias alimentares.
01/10/2025 09:33:18
• Leia com os estudantes o texto do boxe Cadeias alimentares em que a fonte primária de energia não é a luz solar. Depois, pergunte a eles por que o Sol não contribui para a fotossíntese nessa região. Explique-lhes que a luz solar não é capaz de alcançar grandes profundidades nos oceanos e, por isso, existem locais que podem ser completamente escuros, impossibilitando a ocorrência da fotossíntese.
• O trecho de reportagem desta página e os questionamentos sobre o assunto abordado nela favorecem o desenvolvimento da Competência geral 7 e da Competência específica de Ciências da Natureza 5, pois fornece subsídios para os estudantes construírem argumentos com base em dados e evidências sobre um problema ambiental resultante de ações humanas, o que ajuda a promover a consciência socioambiental. Além disso, o assunto abordado no trecho de reportagem possibilita o trabalho com o tema contemporâneo transversal Educação ambiental
• Leia com os estudantes, em voz alta, o trecho da reportagem apresentada nesta página. Questione-os sobre o assunto tratado no texto. Leve-os a refletir sobre como as ações humanas podem causar impactos diretos na Mata Atlântica. Por exemplo, essas ações podem resultar na redução da disponibilidade de alimentos para os animais que vivem nesse bioma, comprometendo o conteúdo nutricional, e no aumento da predação de alguns animais, em razão da redução da vegetação que os deixa mais expostos aos predadores.
• Na questão 3, caso os estudantes apresentem dificuldade, peça a eles que representem no caderno a cadeia alimentar: planta queixada onça-pintada. Pergunte a eles o que aconteceria com essa cadeia se a onça-pintada fosse extinta do ambiente. Verifique se eles respondem que os queixadas seriam menos predados e com isso a população desses animais poderia aumentar. Em seguida, pergunte o que poderia acontecer com a quantidade de plantas das quais os queixadas se alimentam.
2. Resposta: A caça das presas diminui a disponibilidade de recursos alimentares
11 DESEQUILÍBRIO NAS CADEIAS ALIMENTARES
para onça-pintada, o que pode prejudicar a sobrevivência dessa espécie na Mata Atlântica, uma vez que os animais obtêm dos alimentos que consomem a energia e os nutrientes necessários à sua sobrevivência.
Leia o trecho de reportagem a seguir. Espécie está praticamente extinta na região
[…]
Pesquisadores encontraram 11 onças-pintadas na Serra do Mar
A onça-pintada é considerada em perigo de extinção na região, pois a área da Mata Atlântica na Serra do Mar foi reduzida em 85%. As onças dependem de áreas extensas para sobreviver. A fragmentação da Mata Atlântica e a ação humana as deixa expostas e vulneráveis, conforme explicou o coordenador técnico do projeto, Roberto Fusco.
“Fora isso, você tem a pressão de caça, que vem junto com esse desmatamento também. Então, a pressão de caça sobre a onça-pintada, diretamente, e também sobre as presas dela. [...]”.
LIN, Nelson. Pesquisadores encontraram 11 onças-pintadas na Serra do Mar. Agência Brasil, 16 jun. 2024. Disponível em: https://agenciabrasil.ebc.com.br/radioagencia-nacional/meio-ambiente/audio/2024-06/ pesquisadores-encontraram-11-oncas-pintadas-na-serra-do-mar. Acesso em: 29 maio 2025.
Vulneráveis: em situação de risco ou com mais dificuldade para se proteger ou cuidar de si.
Agora, responda oralmente às questões a seguir.
1. Segundo o texto, quais ações humanas colocam as onças-pintadas em risco de extinção?
Resposta: A redução do hábitat, o desmatamento e a pressão
2. Explique por que a caça das presas é um fator que contribui para que as onças-pintadas estejam em perigo de extinção na Mata Atlântica.
3. A onça-pintada é considerado um predador topo de cadeia alimentar, isto é, não tem predadores naturais em seu hábitat. Converse com um colega sobre as possíveis consequências da redução das espécies consideradas topo de cadeia alimentar para as demais espécies de um ambiente.
Onça-pintada: pode atingir cerca de 1,8 m de comprimento.
3. Resposta nas orientações ao professor da caça diretamente sobre a onça-pintada e indiretamente sobre suas presas.
Leve-os a perceber que, com o aumento da população de queixadas, a vegetação seria consumida mais rapidamente, reduzindo a quantidade de alimento disponível para esses animais, o que poderia afetar a sobrevivência deles.
Resposta
3. O objetivo desta atividade é levar os estudantes a refletirem sobre como a extinção de uma espécie pode levar a um desequilíbrio das relações alimentares em um ambiente. Espera-se que eles comentem que um predador no topo da cadeia alimentar é responsável por regular a quantidade de suas presas em um ecossistema.

Onça-pintada.
A.
4. A cutia se alimenta da semente da castanheira-do-brasil. Esse animal enterra algumas sementes, o que auxilia na reprodução dessa árvore. Por outro lado, ela serve de alimento para alguns animais, como a onça-pintada.
a ) Associe corretamente as informações às imagens a seguir.
Resposta: A – 3; B – 2; C – 1.
Consumidor secundário.

Cutia: pode atingir cerca de 66 cm de comprimento.
C. Produtor. B.
Consumidor primário.


Onça-pintada: pode atingir cerca de 1,8 m de comprimento.
b ) Imagine que, por diversos motivos, como a caça ilegal, a cutia tenha sido eliminada do ambiente. O que poderia acontecer com as castanheiras-do-brasil e com as onças-pintadas?
Resposta nas orientações ao professor
Como você estudou, o desmatamento e a caça de animais silvestres podem causar desequilíbrios nas cadeias alimentares.
Além dessas atividades, outros fatores, como a poluição ambiental e as queimadas, podem levar à destruição de hábitat, morte de seres vivos e prejuízos na disponibilidade de abrigo e de alimento.
A introdução de espécies exóticas no ambiente e a retirada de espécies também podem provocar desequilíbrio das cadeias alimentares e extinção de espécies.
Espécies exóticas: espécies que se encontram fora do seu local de distribuição natural.

BNCC
• A atividade 4 possibilita o desenvolvimento da habilidade EF04CI04, pois leva os estudantes a analisarem uma cadeia alimentar, identificando nela a posição dos seres vivos e avaliando as consequências de alterações nessa cadeia.
• Você pode aproveitar a temática desequilíbrio nas cadeias alimentares e o conhecimento sobre o gênero textual oral seminário, que será apresentado na seção Entre textos, nas páginas 58 e 59, para promover com os estudantes um projeto. Para isso, organize a turma em três grupos: 1 - pesquisa sobre o tráfico de animais; 2 - pesquisa sobre a caça ilegal e predatória; e 3 - pesquisa sobre a introdução de espécies invasoras (proposta na seção Entre textos). Após realizadas as pesquisas, oriente os grupos a conversarem sobre os impactos dessas ações para as cadeias alimentares e a propor soluções para esses problemas ambientais. Ao final, peça que elaborem uma apresentação oral e visual sobre o problema ambiental estudado e as propostas das soluções para esse problema, utilizando programas de edição com o uso de computador ou cartazes. O objetivo desse projeto é desenvolver habilidades relacionadas à busca de informações confiáveis, ao debate sobre questões socioambientais e à produção de apresentação sobre o tema, promovendo o protagonismo dos estudantes. Os seminários podem ser apresentados para os pais ou responsáveis e para a comunidade escolar.
• Diga aos estudantes que as espécies exóticas podem competir com as nativas por recursos do ambiente, como alimento, prejudicando-as. Muitas vezes, ao serem introduzidas em um ambiente, as espécies exóticas não apresentam um predador no local para regular o tamanho populacional, e quando essas espécies encontram alimento com facilidade, sua população pode aumentar. As espécies exóticas também podem
introduzir agentes causadores de doenças no ambiente, que poderão afetar a saúde e a sobrevivência das espécies nativas.
Resposta
4. b) Espera-se que os estudantes respondam que a eliminação da cutia do ambiente pode interferir na dispersão das sementes da castanheira-do-brasil e, consequentemente, na reprodução dessa planta, reduzindo a quantidade de novos indivíduos. Já a onça-pintada pode sofrer com a falta de alimento, o que pode interferir na sobrevivência da espécie no ambiente.
Castanheira-do-brasil: pode atingir cerca de 60 m de altura.
Cutia.
Castanheira-do-brasil. Onça-pintada.
Queimada em área florestal no município de Poconé, no Mato Grosso, em 2023.
BNCC
• A abordagem das espécies exóticas invasoras possibilita o trabalho com o tema contemporâneo transversal Educação ambiental. Além disso, favorece o desenvolvimento da Competência geral 7 e da Competência específica de Ciências da Natureza 5 , pois fornece subsídios para os estudantes construírem argumentos e defenderem pontos de vista sobre um problema ambiental, com base em conhecimentos científicos, promovendo a consciência socioambiental.
OBJETIVOS
• Conhecer o gênero textual oral seminário.
• Conhecer alguns problemas relacionados às espécies exóticas invasoras.
• Produzir e apresentar um seminário.
• Inicie a abordagem desta seção lendo em voz alta com os estudantes a explicação sobre o que é o gênero textual oral seminário. Em seguida, comente com eles que esse gênero é muito utilizado para apresentar um conteúdo a determinado público e faz o uso, quando possível, de recursos audiovisuais. Esse gênero pode ser utilizado, por exemplo, para a exposição de resultados de trabalhos desenvolvidos nas escolas, nas faculdades, nas universidades e no meio profissional.
• A aplicação desse gênero textual em sala de aula é muito importante para a formação dos estudantes, pois ele proporciona o desenvolvimento da capacidade de pesquisa, raciocínio e reflexão em torno de determinado conteúdo, além de desenvolver habilidades relacionadas à comunicação científica.
ENTRE TEXTOS
O seminário é um gênero textual oral, no qual primeiro é realizado um estudo sobre determinado tema e, posteriormente, é feita a apresentação de forma oral. Sobre esse assunto, leia o trecho da reportagem a seguir.
Seminário Regional de Espécies Exóticas Invasoras
Para promover a troca de experiências e destacar a importância da segunda maior causa de perda de biodiversidade mundial, o Programa Estadual de Controle de Espécies Exóticas Invasoras – Sema/RS organizou, com o auxílio do Instituto de Meio Ambiente do Estado de Santa Catarina – IMA e do Instituto Ambiental do Paraná – IAP, o 1º Seminário Regional de Espécies Exóticas Invasoras. […]
SEMINÁRIO Regional de Espécies Exóticas Invasoras. Secretaria do Meio Ambiente e Infraestrutura do Rio Grande do Sul. Disponível em: https://www.sema.rs.gov.br/s. Acesso em: 29 maio 2025.
Invasoras: espécies exóticas que, ao serem introduzidas em um ambiente, se reproduzem e se proliferam rapidamente nele, causando prejuízos à biodiversidade local.
EXPLORANDO O TEXTO
Respostas nas orientações ao professor
a ) Você já participou como apresentador ou ouvinte de um seminário? Conte para os colegas o tema desse seminário e como foi.
b ) Em sua opinião, qual é a importância da temática abordada pelo seminário mencionado na reportagem?

EXPLORANDO O TEXTO
• Antes de os estudantes responderem aos itens a e b, peça-lhes que observem a imagem desta página e indiquem elementos que nos permitem identificar que está sendo representada uma situação de seminário nela. Eles podem indicar a presença de estudantes apresentando um recurso visual para outros estudantes que representam o público que assiste ao seminário.
Respostas
a) Resposta pessoal. O objetivo desta atividade é incentivar o compartilhamento de vivências e o
Imagem com elementos sem proporção entre si. Cores fantasia.
Representação de estudantes apresentando um seminário sobre animais exóticos invasores.
conhecimento dos estudantes sobre o que é um seminário.
01/10/2025 09:33:25
b) Resposta pessoal. O objetivo desta atividade é levantar os conhecimentos prévios dos estudantes sobre as espécies exóticas invasoras e provocar uma reflexão sobre as consequências da presença dessas espécies em determinado ambiente. Eles podem responder, por exemplo, que as espécies exóticas invasoras são uma causa importante de perda de biodiversidade e que elas podem causar desequilíbrios ambientais.
ALÉM DO TEXTO
Respostas nas orientações ao professor
O texto a seguir é um trecho de um relatório que aborda o impacto de espécies invasoras sobre a biodiversidade brasileira. Leia-o em voz alta.
[...] Foram registradas 476 espécies exóticas invasoras no território brasileiro, sendo 268 animais e 208 plantas e algas [...]. A estimativa de prejuízos varia de 77 a 105 bilhões de dólares, entre os anos de 1984 e 2019, devido aos impactos negativos causados por apenas 16 espécies exóticas invasoras [...].
Invasões biológicas por mosquitos como os do gênero Aedes, muitas vezes associados aos chamados arbovírus, tem gerado graves consequências à saúde pública, em virtude de doenças como dengue, zika, chikungunya e febre amarela urbana. O mexilhão-dourado, por sua vez, tem impactado empreendimentos hidrelétricos, estações de tratamento de água e tanques-rede de fazendas aquícolas, acarretando sérios prejuízos econômicos. [...]
Imagens com elementos sem proporção entre si. Cores fantasia.

Representação de mexilhão-dourado.
BNCC
• A preparação de um seminário sobre as espécies exóticas invasoras pelos estudantes colabora para o desenvolvimento das Competências específicas de Ciências da Natureza 5 e 6, pois os incentiva a construir e apresentar argumentos com base em dados, evidências e informações acessadas por meio de diferentes linguagens e tecnologias. Além disso, o tema do seminário está relacionado ao tema contemporâneo transversal Educação ambiental.
ALÉM DO TEXTO
Representação de mosquito do gênero Aedes
SUMÁRIO para tomadores de decisão do relatório brasileiro sobre espécies exóticas invasoras, biodiversidade e serviços ecossistêmicos. São Carlos: Cubo, 2024. Disponível em: https://www. bpbes.net.br/wp-content/uploads/2024/02/STD_digital_Especies-Exoticas-Invasoras.pdf. Acesso em: 29 maio 2025.
c ) Escreva no caderno, com letra cursiva, o nome das espécies invasoras citadas no texto e os prejuízos relacionados a elas, ainda segundo o texto.
d ) Junte-se a três colegas e formem um grupo. Façam um seminário sobre uma espécie exótica invasora encontrada no Brasil. Para isso:
• pesquisem a origem dessa espécie, onde é encontrada no Brasil e quais são os impactos que ela causa ao ambiente e a outros seres vivos;
• montem uma apresentação e apresentem o seminário aos colegas.
Arbovírus: seres microscópicos que podem causar doenças.
Tanques-rede: tanques flutuantes instalados em cursos de água para criação de peixes.
• Ao final da leitura do trecho do relatório apresentado nesta página, peça aos estudantes que citem os termos que não conhecem o significado, além dos que têm vocabulário na página, e procurem as palavras em um dicionário.
• Na resposta ao item c , verifique se os estudantes fazem a pegada de três pontos no lápis, facilitando a escrita cursiva.
• Para a realização do seminário proposto no item d, organize os grupos mesclando estudantes de diferentes perfis, para que possam compartilhar conhecimentos e habilidades.
• Oriente os estudantes a fazerem uma seleção das informações coletadas durante a pesquisa, para que utilizem apenas aquelas que julgarem pertinentes e confiáveis. Para fazer isso, sugira a eles que estabeleçam uma ordem de relevância para os dados recolhidos.
• Para que os estudantes apresentem o seminário de forma organizada, sugira que sigam as etapas de apresentação a seguir.
1º – Abertura com o nome dos participantes e o título do seminário.
2º – Informações sobre a espécie estudada, sua origem e onde ela é encontrada no Brasil.
3º – Relato de quais são os prejuízos que
ela causa ao ambiente e a outros seres vivos.
4º – Possível causa que deu início ao problema e sugestão de como revertê-lo.
5º – Encerramento com agradecimentos e espaço para os demais estudantes fazerem perguntas.
• Os estudantes podem montar a apresentação por meio de cartazes ou utilizando um programa de edição de apresentações.
Respostas
c) Espera-se que os estudantes citem
01/10/2025 09:33:25
prejuízos econômicos relacionados ao abastecimento de água, ao fornecimento de energia e à criação de peixes, associados ao mexilhão-dourado, e para a saúde pública, associados aos mosquitos do gênero Aedes
d) Resposta pessoal. O objetivo desta atividade é levar os estudantes a conhecerem espécies exóticas invasoras encontradas no Brasil e os impactos ambientais associados à sua introdução, bem como levá-los a produzir e apresentar um seminário.
1. Objetivo
• Avaliar se os estudantes conhecem algumas atitudes básicas de segurança no trânsito e a transformação física envolvida na formação da neblina.
Sugestão de intervenção
No item a desta atividade, preste atenção na troca de ideias estabelecida entre os estudantes e verifique se eles têm noções básicas dos cuidados que os motoristas devem ter no trânsito. Pergunte se eles acham que seria seguro um motorista dirigir na velocidade máxima da via com visibilidade comprometida. Se necessário, diga que a distância de frenagem aumenta de acordo com a velocidade. Pergunte a eles também se a utilização de recursos que aumentam a visibilidade dos veículos seria recomendada nessa condição.
Se os estudantes tiverem dificuldade para identificar a transformação envolvida na formação da neblina, no item b, pergunte qual é o estado físico da água no ar atmosférico antes da formação da neblina e a condição do ambiente para que ela se forme. Identificados o vapor de água no ambiente e a condição de baixa temperatura, peça a eles que identifiquem também que tipo de transformação ocorre.
2. Objetivo
• Verificar se os estudantes compreendem que o processo de fusão de um material é uma transformação física que necessita de calor para acontecer e não altera a composição do material.
Sugestão de intervenção
Se os estudantes apresentarem dificuldade para responder ao item, sugira que associem a fusão a uma posterior solidificação da água, destacando que sua composição química se mantém e que isso também ocorre com o ferro. Além disso, eles podem perceber
Escreva as respostas no caderno.
VAMOS AVALIAR O APRENDIZADO
1. Em dias de baixas temperaturas e chuvosos, é comum ocorrer formação de neblina no ambiente. Essa névoa dificulta a visibilidade e torna perigoso o tráfego de veículos em ruas e estradas.
Veículo trafegando em meio à neblina.
1. a) Resposta pessoal. Espera-se que os estudantes citem o uso dos faróis baixos e a diminuição da velocidade de condução.

a ) Converse com os colegas e indiquem os cuidados que o motorista deve ter ao dirigir em meio à neblina.
b ) Por qual mudança de estado físico a água passa quando o vapor está em ambiente com baixas temperaturas e forma a neblina?
Resposta: Ocorre a condensação, isto é, a passagem da fase gasosa para a líquida.
2. As fotografias a seguir mostram, de forma simplificada, como uma peça de ferro para carros é feita. Observe-as.

de ferro armazenadas em uma indústria.


derretido
a ) A etapa A, em que o ferro se torna líquido, e a etapa B, em que ele volta a ficar sólido, não alteram a composição do ferro. Que tipo de transformação ocorre?
b ) O que é feito para o ferro se tornar líquido?
Resposta: O ferro é aquecido.
2. a) Resposta: Trata-se de uma transformação física, pois não há alteração da composição do ferro, ocorrendo apenas uma mudança de fase.
durante o processo de fabricação que com as barras de ferro são produzidas peças com o mesmo material, porém com formato diferente. No item b, caso os estudantes não saibam como o ferro é derretido, peça que observem a fotografia do centro e pergunte se o ferro líquido aparenta estar quente. Eles também podem associar a fusão do gelo, que recebe calor do ambiente para se tornar água no estado líquido, à pressão constante.
BNCC
• As atividades desta página relatam transformações físicas que ocorrem com partículas de água do ambiente e com o ferro utilizado em uma indústria, apresentando também imagens da reversibilidade deste último, o que contribui para o desenvolvimento das habilidades EF04CI02 e EF04CI03. Além disso, a atividade 1, ao abordar a segurança no trânsito em situações de neblina, permite trabalhar o tema contemporâneo transversal Educação para o trânsito
Barras
Ferro
sendo despejado no molde de uma peça.
Peça automotiva feita de ferro.
A.
B. C.
3. Alguns óculos têm lentes que escurecem quando expostas à luz solar, formando um material escuro, que reduz a entrada de luz nos olhos. Se retiradas da luz solar, as lentes voltam a ficar transparentes, pois o material escuro retorna ao estado anterior.

Óculos com lentes que escurecem na luz solar.
a ) Explique se a transformação que ocorre nas lentes desses óculos é física ou química e se ela é reversível ou irreversível. Se preciso, faça uma pesquisa sobre o funcionamento dessas lentes.
Resposta nas orientações ao professor
4. A queima do palito de fósforo, representada na imagem, é um processo reversível ou irreversível? Justifique sua resposta. Estágios de um palito de fósforo queimando.
Resposta: Irreversível, pois o material que compõe o palito não pode voltar ao seu estado original após ser queimado.
Imagens sem proporção entre si.

5. No preparo caseiro do iogurte natural, acrescenta-se uma pequena quantidade de fermento lácteo ao leite morno para que ele se transforme em iogurte.
5. a) Resposta: É uma transformação química, pois ocorre a formação de novas substâncias.
a ) A transformação do leite em iogurte é física ou química?
b ) Como é possível perceber que ocorreu essa transformação?

Iogurte natural.
Resposta: Os estudantes podem responder que o iogurte apresenta outras características, como espessura, cheiro e sabor diferentes.
6. Na fotografia a seguir, estão ocorrendo transformações com a madeira e a água.
Escreva no caderno qual material está passando por uma transformação física e qual está passando por uma transformação química.
Resposta nas orientações ao professor
Água sendo aquecida em fogo de lenha.
to de fósforo foi degradada pelo fogo, de maneira que não pode retornar às características que apresentava antes.
5. Objetivo
• Reconhecer algumas mudanças associadas à transformação química.
Sugestão de intervenção
Para auxiliar os estudantes nesta atividade, comente que no fermento lácteo há uma mistura de microrganismos que transformam os açúcares naturais presentes no leite em outra substância, caracterizando uma transformação química.

6. Objetivo
• Identificar uma situação em que ocorrem duas transformações, uma física e outra química.
Sugestão de intervenção
Para auxiliar os estudantes nesta atividade, leve-os a identificarem quais materiais retratados na imagem estão passando por transformações. Depois, verifique se percebem que a água está sendo aquecida, mudando de estado físico, enquanto a madeira está queimando, formando cinzas ou carvão. Questione-os sobre qual
BNCC
• As atividades desta página, que tratam de transformações físicas e químicas e da reversibilidade de algumas transformações, permitem trabalhar as habilidades EF04CI02 e EF04CI03.
3. Objetivo
• Identificar o tipo de transformação que ocorre nas lentes fotossensíveis e sua reversibilidade.
Sugestão de intervenção
Para auxiliar os estudantes nesta atividade, pergunte a eles se há formação de novos materiais nas lentes dos óculos quando expostos à luz solar. Verifique se respondem que ocorreu a formação de um material de cor escura. Depois, pergunte em qual tipo de transformação ocorre a formação de novos materiais: química ou física.
Pergunte o que acontece com essas lentes ao serem retiradas da luz solar. Espera-se que eles identifiquem, no texto, que as lentes voltam a ficar transparentes, caracterizando uma transformação reversível.
4. Objetivo
• Compreender que o processo de queima é uma transformação química irreversível.
Sugestão de intervenção
Para auxiliar os estudantes, leve-os a perceber que a madeira que forma o pali-
01/10/2025 09:33:37
dessas transformações mantém a composição do material e qual forma novos materiais.
Respostas
3. a) A transformação é química, pois há a formação de novas substâncias que deixam a lente escura, e reversível, porque o material escuro pode retornar a ser um material transparente.
6. Espera-se que os estudantes respondam que a madeira está passando por uma transformação química e que a água está passando por uma transformação física.
BNCC
• A atividade 7 colabora para o desenvolvimento das habilidades EF04CI02 e EF04CI03, pois leva os estudantes a relatarem transformações nos materiais em uma situação do cotidiano e a concluírem sobre a reversibilidade delas.
• A atividade 8 leva os estudantes a reconhecerem a importância ambiental da decomposição, favorecendo o desenvolvimento da habilidade EF04CI06
7. Objetivo
• Reconhecer as características de uma transformação química reversível.
Sugestão de intervenção
Para auxiliar os estudantes nesta atividade, leve-os a perceber que ocorre uma transformação em um composto químico presente na pintura do galo do tempo. Em contato com a água, esse composto químico muda da cor azul para a rosa, tornando-se azul novamente quando o ar está mais seco, o que caracteriza uma transformação química reversível. Comente com eles que, além da umidade, a temperatura é importante na mudança de cor do galo do tempo.
8. Objetivo
• Reconhecer a importância da decomposição para as cadeias alimentares.
Sugestão de intervenção
Para auxiliar os estudantes nesta atividade, peça que descrevam as características dos frutos retratados na imagem. Depois, pergunte o que acontece com a matéria orgânica que compõe esses frutos após serem decompostos no ambiente. Verifique se concluem que a matéria orgânica é aproveitada por outros seres vivos, por exemplo, pelos produtores de uma cadeia alimentar.
7. Algumas décadas atrás, um objeto decorativo muito comum era o galo do tempo. Nesse objeto, há um material capaz de mudar de cor de acordo com as condições do tempo. Quando a umidade do ar está mais baixa, ou seja, o ar está mais seco, o material adquire a coloração azul; quando a umidade do ar está mais alta, adquire coloração rosa.
Galo do tempo em condições de umidade elevada (A) e baixa umidade do ar (B).

a ) Essa mudança é uma transformação física ou química? Justifique sua resposta.
Resposta nas orientações ao professor
b ) Trata-se de uma transformação reversível ou irreversível? Justifique sua resposta.
Resposta nas orientações ao professor
8. Observe a fotografia.
a ) Qual processo é observado na imagem?
Resposta: A decomposição.
b ) Qual é a importância desse processo para as cadeias alimentares?
Resposta nas orientações ao professor

Frutos degradados sobre o solo.
9. O animal mostrado na imagem a seguir é a ave dodô, um animal dócil que viveu nas Ilhas Maurício até ser extinto. Com a chegada do ser humano à ilha, essa ave sofreu predação. Seus ovos passaram a ser devorados
por espécies de roedores que chegaram com as embarcações. Após a chegada do ser humano à ilha, o dodô foi extinto em menos de 100 anos. O último animal foi visto em 1668.
Representação da ave dodô, extinta há mais de três séculos.

a ) Quais foram as causas que levaram à extinção da ave dodô?
Resposta nas orientações ao professor
9. Objetivo
• Reconhecer as consequências da inserção de novas espécies em uma cadeia alimentar.
Sugestão de intervenção
Peça aos estudantes que leiam novamente o enunciado da atividade e identifiquem o que aconteceu ao dodô com a chegada do ser humano à ilha, como a predação.
Respostas
7. a) Transformação química, pois é possível observar a alteração da cor do material quando em contato com a água.
7. b) Transformação reversível, pois, se o fator responsável pela transformação for retirado, no caso, a umidade do ar mais elevada, o galo do tempo volta a apresentar a coloração que tinha antes: azul.
8. b) Por meio da decomposição, a matéria orgânica é transformada em materiais mais simples, que podem ser absorvidos pelas plantas, retornando para as cadeias alimentares.
9. A predação exagerada dessa ave pelo ser humano e a introdução de novas espécies de roedores, que se alimentaram dos ovos delas.
Professor, professora: A legenda da imagem não foi inserida para não comprometer a realização da atividade.
10. Observe a imagem.
a ) Em sua opinião, qual é o problema ambiental retratado? Ele pode levar ao desequilíbrio de uma cadeia alimentar?
Resposta nas orientações ao professor.
b ) Qual é a importância do fitoplâncton nessa cadeia alimentar?
Resposta: O fitoplâncton atua como produtor na cadeia alimentar.
11. Analise a teia alimentar no ambiente a seguir.

Representação de uma teia alimentar. Nesta imagem, os organismos decompositores estão ampliados.
a ) Com base na teia alimentar representada, organize, no caderno, os animais listados a seguir de modo a representar duas cadeias alimentares.
Cadeia alimentar 1
• gafanhoto
• planta
• suçuarana
• tatu-bola
• seres vivos decompositores
Imagens com elementos sem proporção entre si. Cores fantasia.
Cadeia alimentar 2
• mocó
• planta
• suçuarana
• seres vivos decompositores
Resposta pessoal. Comentários nas orientações ao professor.
b ) Qual é o componente do ambiente que atua como fonte primária de energia em ambas as cadeias?
Resposta: O Sol.
c ) Ao longo das cadeias representadas, a energia aumenta ou diminui de um nível da cadeia ao próximo nível? Explique.
Resposta nas orientações ao professor.
BNCC
• A atividade 11 contribui com o desenvolvimento da habilidade EF04CI04, pois incentiva os estudantes a analisarem uma teia alimentar e, com base nela, construírem cadeias alimentares, reconhecendo a posição dos seres vivos nelas e o papel do Sol como fonte primária de energia.
10. Objetivo
• Reconhecer a importância dos produtores em uma cadeia alimentar.
Sugestão de intervenção
Para auxiliar os estudantes nesta atividade, pergunte se eles identificam algum objeto na imagem que não pertença naturalmente ao ambiente aquático, como a botina e o capacete de mergulhador. Questione-os como acham que esses objetos foram parar nesse ambiente, levando-os a perceber o descarte inadequado de resíduos sólidos nesse local. Depois, pergunte o que pode acontecer com o peixe ao ingerir um objeto que não faz parte de sua dieta e qual é a consequência para seu predador.
Para auxiliá-los no item b, peça que, primeiro, definam o termo fitoplâncton e, em seguida, questione-os sobre a importância deles para o ambiente aquático.
11. Objetivo
• Reconhecer a posição de alguns seres vivos e a importância do Sol em uma teia alimentar.
Sugestão de intervenção
Para auxiliar os estudantes a construírem as cadeias alimentares no item a, peça que identifiquem os seres vivos citados na lista na imagem da teia alimentar, classificando-os de acordo com a posição que ocupam nessa teia. No item b, pergunte de onde vem a energia que se distribui por toda a cadeia alimentar. Em seguida, questione-os sobre o que acontece com essa energia ao longo de uma cadeia alimentar, se ela retorna ao ambiente pela
ação dos seres decompositores ou diminui conforme os seres vivos vão utilizando-a em seu funcionamento e é perdida para o ambiente.
Respostas
10. a) Descarte irregular de resíduos sólidos nos rios e mares. Essa ação prejudica os seres vivos que podem ingerir esses resíduos e morrerem, provocando um desequilíbrio na cadeia alimentar da qual fazem parte.
11. a) Espera-se que os estudantes representem a cadeia alimentar 1 como: planta
01/10/2025 09:33:39
gafanhoto tatu-bola suçuarana; e que representem a cadeia alimentar 2 como: planta mocó suçuarana. Os estudantes devem ainda representar, em ambas as cadeias, setas partindo de todos os seres vivos em direção aos seres vivos decompositores.
11. c) A energia diminui, pois, parte dela é utilizada pelos seres vivos da cadeia e outra parte é perdida para o ambiente na forma de calor. Portanto, a energia não estará totalmente disponível para o próximo ser vivo da cadeia alimentar.
suçuarana
mocó
tatu-bola
planta
gafanhoto
seres vivos decompositores
OBJETIVOS DA UNIDADE
• Conhecer algumas características de bactérias, fungos, protozoários e vírus.
• Conhecer alguns papéis desempenhados pelos microrganismos nos seres vivos e no ambiente.
• Conhecer os benefícios que o ser humano pode obter de alguns microrganismos.
• Compreender que alguns microrganismos são causadores de doenças e identificar suas maneiras de transmissão.
• Conhecer medidas para prevenção de doenças causadas por microrganismos.
• Nesta unidade, os estudantes conhecerão os microrganismos e suas influências nos seres vivos e no ambiente. O tema 12 inicia essa abordagem enfatizando o tamanho desses seres e a necessidade do uso de microscópios para observá-los. São apresentadas algumas características das bactérias e suas relações com outros seres vivos e o ambiente, tal como sua participação nos processos de decomposição da matéria orgânica, os benefícios para o ser humano e outros seres vivos e sua utilização na produção de alimento e na busca de novas aplicações. O efeito negativo das bactérias patogênicas também é abordado neste tema ao citar uma doença causada no ser humano e sua maneira de transmissão.
• Ao tratar dos fungos, a apresentação de um alimento embolorado e o enriquecimento do solo no processo de compostagem evidenciam o papel desses seres vivos como decompositores. A participação dos fungos na produção de combustíveis e alimentos, bem como a capacidade de algumas espécies de causar doenças em seres humanos, também é abordada.
UNIDADE3

MICRORGANISMOS
Seres vivos microscópicos coletados de um telefone celular. Imagem ampliada cerca de 3 000 vezes e colorida em computador.
• Com relação aos protozoários, são apresentadas suas características, com ênfase nas maneiras de locomoção e alguns papéis essenciais desempenhados em outros seres vivos, como é o caso de sua presença no sistema digestório de alguns animais. A existência desses microrganismos em corpos de água e as doenças causadas por eles também serão trabalhadas neste tema.
• No tema 12, também são abordadas algumas características dos vírus, como a necessidade desses organismos de invadirem células de outros seres vivos para se reproduzirem e a capacidade de causar doenças, além de aspectos
positivos, como o uso na produção de vacinas ou para controle biológico.
• Já no tema 13, serão abordadas doenças de transmissão direta e indireta causadas pelos microrganismos estudados e as medidas de prevenção adequadas a cada uma delas. Além disso, é tratada a importância das vacinas na prevenção de doenças e das altas taxas de vacinação na população para controlá-las ou erradicá-las, bem como evitar que casos de doenças já controladas voltem a ocorrer.
Você não pode enxergá-los a olho nu, mas eles estão aqui, ali, por toda parte, inclusive no seu corpo. Apesar de muito pequenos, eles são essenciais tanto para o ambiente como para o funcionamento adequado do organismo. De quem estamos falando? Dos seres microscópicos, também conhecidos como microrganismos.

1. 2. 3.
Respostas nas orientações ao professor
As estruturas coloridas mostradas na imagem são seres vivos que não podem ser observados a olho nu. Em sua opinião, por que eles não são visíveis a olho nu?
Em sua opinião, como podemos enxergar esses seres vivos?
Cite um local onde podemos encontrar seres vivos semelhantes aos da imagem.
microscópio são células de seres vivos microscópicos conhecidos como leveduras.
• Antes de ler o texto introdutório desta página com os estudantes, escreva na lousa a seguinte pergunta: “Vocês acham que existem microrganismos no corpo humano?”. Caso respondam que sim, pergunte se a presença deles é benéfica ou prejudicial. Se julgar pertinente, anote as respostas dos estudantes na lousa e retome-as após o estudo da unidade.
Respostas
1. Resposta pessoal. O objetivo desta questão é levantar os conhecimentos
prévios dos estudantes sobre os microrganismos.
2. Resposta pessoal. O objetivo desta questão é levantar os conhecimentos prévios dos estudantes sobre o uso de microscópios.
3. Possíveis respostas: No ar, no solo, na água, sobre outros seres vivos ou no interior deles.
• Nas atividades 1 e 2, verifique se eles respondem que alguns seres vivos são tão pequenos que não podem ser observados a olho nu. Dessa maneira, é preciso observá-los por meio do uso de
Se julgar conveniente, inicie a unidade com a atividade prática a seguir.
Materiais
• copo plástico transparente (de 200 mL)
• colher (de sopa)
• conta-gotas
• lâminas para microscopia
• lamínulas para microscopia
• água
• fermento biológico
• açúcar
• microscópio óptico
Passo a passo
a) No copo plástico transparente, adicione um pouco de água e um pacote de fermento biológico. Misture bem até dissolver completamente o fermento na água.
b) Adicione uma colher de açúcar e complete com mais água, mexendo bem.
c) Oriente os estudantes a observarem a mistura e a desenharem no caderno o que viram.
d) Utilizando o conta-gotas, coloque uma gota da mistura sobre a lâmina, cobrindo-a com a lamínula.
e) Oriente-os a observar a amostra no microscópio e a desenhar no caderno o que viram.
Ao final da atividade, peça aos estudantes que comentem as diferenças entre o que observaram a olho nu e o que observaram com o auxílio do microscópio óptico. Explique a eles que as estruturas observadas no
01/10/2025 09:37:20
instrumentos de ampliação, como um microscópio.
• Se os estudantes tiverem dificuldade em responder à atividade 3, explique a eles que os microrganismos podem ser encontrados em vários locais, inclusive em objetos como o celular. Enfatize que devemos cuidar da higiene pessoal, principalmente da higienização das mãos, uma vez que durante o dia tocamos várias superfícies e objetos que podem conter esses seres microscópicos. Explique a eles que, ao levarmos as mãos ao rosto, os microrganismos que podem estar em nossas mãos entram no corpo pela região dos olhos, nariz e boca.
BNCC
• A abordagem deste tema permite o desenvolvimento da habilidade EF04CI07 ao possibilitar aos estudantes que verifiquem a participação dos microrganismos na produção de alimentos, combustíveis e medicamentos. Além disso, ao proporcionar que reconheçam as bactérias e os fungos como organismos decompositores e a importância da decomposição para a ciclagem de nutrientes no ambiente, o tema colabora com o desenvolvimento da habilidade EF04CI06
• Explique aos estudantes que os microscópios mostrados nesta página apresentam diferentes formas de funcionamento. Nos microscópios ópticos, as lentes focalizam os feixes de luz visíveis, possibilitando a visualização da amostra em aumentos, geralmente, de 40, 100, 400 e 1 000 vezes. Já nos microscópios eletrônicos, um feixe de elétrons passa pelo material e é processado por um computador, possibilitando aumentos de mais de 150 000 vezes.
BNCC
• A abordagem da história do desenvolvimento dos microscópios ao longo do tempo favorece o desenvolvimento da Competência geral 1 e da Competência específica de Ciências da Natureza 1, pois leva os estudantes a valorizarem os conhecimentos historicamente construídos e compreenderem as Ciências da Natureza como empreendimento humano.
• Pergunte aos estudantes se eles acham importante a utilização de microscópios para estudar os microrganismos. Depois de ouvir as respostas, acesse o site indicado a seguir e apresente-lhes algumas imagens do SARS-CoV-2 obtidas por microscopia eletrônica.
12 SERES MICROSCÓPICOS
Os seres vivos são encontrados em diferentes locais do ambiente. Muitos deles são seres vivos muito pequenos que não podem ser observados a olho nu, ou seja, sem equipamentos auxiliares de ampliação. Eles são chamados seres vivos microscópicos e podem ser encontrados no ar, na água, no solo e até mesmo nas plantas e nos animais.
As bactérias, os protozoários e alguns fungos são exemplos de seres vivos microscópicos. Além deles, existem ainda seres microscópicos que não são vivos: os vírus. É sobre todos esses organismos que vamos estudar a seguir.
MICROSCOPIA
Professor, professora: as características dos vírus e sua classificação como seres não vivos por alguns cientistas será comentada na página 80 desta unidade.
Os seres microscópicos podem ser observados com o auxílio de um equipamento chamado microscópio, que amplia várias vezes a imagem que enxergamos, permitindo ver em detalhes o que não conseguimos perceber a olho nu.
Os primeiros microscópios foram desenvolvidos pelos fabricantes de lentes holandeses Hans Janssen (1534-1592) e Zacharias Janssen (1580-1638). Eles perceberam que a associação de duas lentes ampliava o tamanho das imagens.

O microscópio óptico é formado pela associação de uma (ou um par) de lente chamada ocular a um conjunto de lentes, chamadas objetivas.
Microscópio eletrônico. Imagens sem proporção entre si.
Microscópio óptico.
Ao longo dos anos, os microscópios foram aperfeiçoados. Em 1931, o físico alemão Ernst Ruska (1906-1988) desenvolveu o microscópio eletrônico, que permite obter imagens com maior ampliação do que os microscópios ópticos.
• MENEZES, Maíra. Imagens de microscopia revelam processo de infecção celular pelo SARSCoV-2. Fiocruz, 18 maio 2022. Disponível em: https://fiocruz.br/noticia/2022/05/imagens -de-microscopia-revelam-processo-de -infeccao-celular-pelo-sars-cov-2. Acesso em: 22 jul. 2025. Diga que as imagens são do vírus causador da COVID-19. Dê destaque às imagens que mostram o vírus aderindo à membrana da célula e a invadindo. Comente com os estudantes que esse tipo de estudo ajuda os cientistas a compreenderem como os vírus atuam nos organismos que infectam e são importantes para o desenvolvimento de medicamentos e vacinas.

BACTÉRIAS
1. Resposta pessoal. O objetivo desta questão é verificar os conhecimentos prévios dos estudantes sobre as bactérias.
1. O que você sabe sobre as bactérias? Conte para os colegas.
As bactérias são seres vivos formados por apenas uma célula. Quando isoladas, geralmente não são observadas a olho nu. No entanto, a maioria delas pode formar colônias, conjuntos constituídos de várias células e que podem ser observados a olho nu.

Bactéria Escherichia coli. Imagem ampliada cerca de 25 000 vezes e colorida em computador.
Placa com meio de cultura contendo colônias da bactéria Escherichia coli
A imagem A mostra uma bactéria isolada. Na imagem B, cada um dos pontos na placa representa uma colônia de bactérias.
O corpo humano, por exemplo, tem grande quantidade de bactérias. Muitas delas são essenciais para o funcionamento de órgãos do corpo.
As bactérias Bifidobacterium sp., mostradas na imagem a seguir, podem ser encontradas no intestino do ser humano saudável. Elas auxiliam na produção de vitaminas e na digestão e na absorção de nutrientes, além de estimular as defesas do organismo.

as que se associam a outros organismos para se alimentar, sem lhes causar danos.
• Ao abordar as bactérias benéficas que existem no intestino humano, se julgar pertinente, faça aos estudantes a seguinte pergunta: “Vocês acham que os alimentos que ingerimos podem favorecer ou prejudicar a manutenção das bactérias do intestino?”. Oriente-os a discutir o assunto com os colegas e verifique se associam uma alimentação saudável com a manutenção dos microrganismos benéficos desse órgão. Após a conversa, explique aos estudantes que uma
Meio de cultura: mistura que contém todas as substâncias necessárias ao desenvolvimento e à multiplicação de seres vivos, como as bactérias.
Bactérias Bifidobacterium adolescentis. Imagem ampliada cerca de 24 000 vezes e colorida em computador.
alimentação equilibrada, com consumo de frutas, legumes, verduras e cereais, é fundamental para manter os microrganismos que fazem bem ao intestino. Por outro lado, uma dieta desiquilibrada pode favorecer o crescimento de bactérias prejudiciais à saúde.
• Caso julgue interessante, explique que quando as bactérias benéficas do intestino são prejudicadas, podemos apresentar sintomas como inchaço e dor abdominal, gases em excesso e irritabilidade. Nesses casos, é necessário procurar a ajuda de profissionais da saúde, como médicos
• Na atividade 1, verifique se os estudantes mencionam em suas respostas, por exemplo, que as bactérias podem causar doenças. Pergunte a eles se já leram ou ouviram alguma notícia sobre doenças causadas por esses organismos. Incentive-os a relatar suas experiências livremente e acolha as respostas, permitindo o engajamento ativo dos estudantes na construção do conhecimento sobre o tema.
• Comente com os estudantes a respeito das bactérias visíveis a olho nu. Diga-lhes que algumas bactérias, como a Thiomargarita magnifica e T. namibiensis, podem ser vistas sem o auxílio de microscópios. A bactéria T. namibiensis pode medir cerca de 750 μm de diâmetro (0,75 mm). Já a T. magnifica pode alcançar quase 1 centímetro de comprimento (9 000 μm)
• Incentive os estudantes a lerem a definição de meio de cultura e explique a eles que as bactérias podem se alimentar de diversas formas. Há as que produzem o próprio alimento por meio da fotossíntese, como as cianobactérias. Há também bactérias produtoras que não utilizam a luz do Sol como fonte primária de energia, realizando a quimiossíntese. Ainda existem bactérias que não produzem seu alimento, entre elas as parasitas, as decompositoras de matéria orgânica e
01/10/2025 09:37:25
e nutricionistas, que poderão indicar o ajuste da alimentação e o uso de probióticos. Os probióticos são suplementos alimentares compostos de microrganismos vivos que podem ser ingeridos em cápsula ou solução ou podem ser encontrados em alguns alimentos, como iogurtes e leites fermentados.
A. B.
BNCC
• A abordagem desta página contribui para o desenvolvimento das habilidades EF04CI06 e EF04CI07 , pois incentiva os estudantes a analisarem situações em que ocorre a participação de bactérias na decomposição da matéria orgânica, enfatizando sua importância no retorno da matéria ao ambiente, bem como a participação de bactérias na produção de alimentos, como o iogurte.
• Se os estudantes tiverem dificuldade em responder ao item a da atividade 2, pergunte a eles se as bactérias podem prejudicar a saúde do ser humano, se podem ter alguma relação com a matéria orgânica e se auxiliam na fabricação de alguns produtos. Para explicar essas relações, no item b, ajude-os a identificar como as bactérias podem participar de cada situação. Explique a situação 1, comentando que, em geral, a febre é uma resposta do corpo humano a uma infecção causada por microrganismos, como as bactérias, ou seja, algumas delas causam doenças nos seres humanos, bem como em outros seres vivos. No entanto, nem todas as bactérias são prejudiciais aos seres vivos; algumas são utilizadas na produção de alimentos, como na situação 2, e outras são essenciais para a decomposição da matéria orgânica, como mostrado na situação 3
• Muitas vezes, as pessoas associam as bactérias somente a doenças. É importante enfatizar os benefícios de algumas ao ambiente e aos seres vivos. Se julgar conveniente, leve para a sala de aula embalagens de produtos que citem a utilização de bactérias em sua fabrica ção, para complementar o exemplo do iogurte da atividade 2 Além deles, caso julgue interessante, leve rótulos de alimentos probióticos e comente que nesses ali-
2. Confira as situações a seguir.


Produção de iogurte.
2. a) Resposta: Espera-se que os estudantes respondam que todas essas situações têm uma relação direta com bactérias.

Alimento
a ) Quais dessas situações você acha que têm alguma relação direta com bactérias?
b ) Agora, explique no caderno essa relação.
Imagens sem proporção entre si.
Além de estarem no corpo humano e desempenharem papéis importantes nele, as bactérias são essenciais ao ambiente e a outros seres vivos.
Algumas bactérias participam da decomposição da matéria orgânica. Como você estudou, nesse processo, restos de plantas e animais são transformados em nutrientes, que retornam ao ambiente. Esses nutrientes podem ser absorvidos por seres vivos, como as plantas.
A.

B.

Fungos e bactérias atuam juntos no processo de decomposição.
em outros animais. 2: Algumas bactérias são usadas para produzir alimentos, como o iogurte. 3: Algumas bactérias realizam a decomposição da matéria orgânica. 2. b) Resposta: 1: Algumas bactérias podem causar doenças nos seres humanos e
mentos são adicionados microrganismos vivos benéficos ao intestino.
• Ao trabalhar o processo de decomposição da laranja, mostrado na fotografia, se julgar pertinente, retome com os estudantes a decomposição da matéria orgânica. Pergunte a eles quais seres vivos são responsáveis por essa decomposição. Verifique se respondem que são os fungos e as bactérias e enfatize que esses organismos atuam juntos no processo de decomposição. Diga que a parte verde da laranja em decomposição é composta principalmente por fungos e que as bactérias, apesar de não serem visíveis na fotografia, também estão presentes.
Laranja.
Laranja em decomposição.
3.
Criança com febre.
em decomposição.
3. Leia o trecho de reportagem a seguir que aborda a ação de uma bactéria sobre o polietileno tereftalato, um tipo de plástico conhecido como PET.
[...] um grupo de pesquisadores japoneses, tendo à frente Shosuke Yoshida, identificou uma nova espécie de bactéria, Ideonella sakaiensis, capaz de usar o polietileno tereftalato como fonte de carbono e energia – em outras palavras, capaz de se alimentar de PET.
[...]
3. a) Resposta: Espera-se que os estudantes respondam que essa aplicação
pode ser usada para reduzir os prejuízos ao ambiente causado pelo descarte de objetos feitos de plástico.
ARANTES, José Tadeu. Pesquisa melhora enzima que degrada plástico. Agência Fapesp, 25 abr. 2018. Disponível em: https://agencia.fapesp.br/pesquisa-melhora-enzima-que-degrada-plastico/27651. Acesso em: 4 abr. 2025.
a ) Qual é a importância desse tipo de aplicação estudado pelos cientistas?
b ) Ao se alimentar do PET, a bactéria degrada esse material. Esse tipo de aplicação se assemelha a que função das bactérias na cadeia alimentar?
Resposta: Espera-se que os estudantes mencionem a função de decompositor.
Existem bactérias que se associam a plantas e a animais estabelecendo uma relação benéfica com eles.
Alguns mamíferos que se alimentam de plantas, como as vacas, têm um sistema digestório especializado capaz de digerir a celulose, um tipo de açúcar encontrado nas plantas.
A digestão da celulose nesses animais se deve, em parte, à presença de seres vivos microscópicos no sistema digestório.
Vaca alimentando-se de grama.

4. Na relação descrita, qual é a importância dos microrganismos para o crescimento e desenvolvimento do animal?
Resposta nas orientações ao professor
5. Utilize a legenda para decifrar o código a seguir e descobrir como são chamados esses animais. Registre a resposta no caderno.
Legenda
MITESRUNAN
no ambiente nutrientes como gás carbônico e água. Verifique se eles compreenderam que as bactérias citadas no texto desempenham papel semelhante ao das bactérias decompositoras que atuam nas cadeias alimentares, porém utilizando o plástico em vez da matéria orgânica.
Resposta
4. Espera-se que os estudantes comentem que as bactérias estabelecem uma importante relação com os animais ruminantes. Sem elas, esses animais não seriam capazes de digerir o alimento que consomem, como a grama. Na falta de digestão, os nutrientes dos alimentos não são
Resposta: Ruminantes.
Código
01/10/2025 09:37:33
absorvidos pelo organismo, prejudicando a saúde e o desenvolvimento do animal.
• Caso os estudantes tenham dificuldade em formar a palavra na atividade 5, reproduza os quadros com o código e a legenda na lousa e forme a palavra com eles. Explique-lhes que, quando esses animais estão se alimentando, dizemos que estão ruminando o alimento. Para complementar a atividade, peça a eles que procurem a definição de ruminante no dicionário e escrevam a descrição no caderno.
• O trabalho com o trecho de reportagem e a comparação da degradação do plástico PET com o processo de decomposição desenvolvido pelos microrganismos, na atividade 3, favorecem o desenvolvimento da Competência específica de Ciências da Natureza 6 e da habilidade EF04CI06
• No item a da atividade 3, caso julgue necessário, comente com os estudantes que o PET é utilizado na fabricação de garrafas de água e refrigerante. Aproveite para retomar os problemas ambientais causados pelo uso excessivo de plástico e o descarte irregular desse material no ambiente, abordados anteriormente neste volume. Relembre-os de que o plástico pode levar cerca de 450 anos para se decompor no ambiente e leve-os a refletir sobre como as bactérias Ideonella sakaiensis podem contribuir para minimizar os problemas ambientais causados pelo plástico.
• Caso os estudantes tenham dificuldade em responder ao item b da atividade 3, enfatize que a bactéria Ideonella sakaiensis é capaz de obter do PET nutrientes e energia ao decompor esse material. Caso julgue necessário, comente que ao degradar o PET para obter energia, a bactéria libera
Vaca: tamanhos variados de acordo com a raça.
BNCC
• Ao abordar os trabalhos das cientistas e agrônomas Johanna Döbereiner (1924-2000) e Mariangela Hungria da Cunha (1958-), são desenvolvidas a Competência geral 1 e as Competências específicas de Ciências da Natureza 1 e 4, pois os estudantes são levados a valorizar o conhecimento historicamente construído, compreendendo as Ciências da Natureza como empreendimento humano, além de avaliar implicações socioambientais da Ciência. Essa abordagem também colabora com o desenvolvimento do tema contemporâneo transversal Ciência e tecnologia.
• Leve os estudantes a perceberem a importância dos nutrientes para os seres vivos. Assim, verifique se eles entendem que, na relação estabelecida entre a planta e as bactérias rizóbios, tanto a planta quanto as bactérias são beneficiadas, pois ambas estão recebendo nutrientes.
• Se julgar interessante, diga que a planta precisa de nitrogênio para se desenvolver, mas essa substância se encontra no ar e a planta não tem um mecanismo para absorvê-la. Assim, a planta fornece condições anaeróbias e nutrientes para o crescimento da bactéria, que tem capacidade de absorver o nitrogênio e transformá-lo de maneira que possa ser incorporado pelas plantas.
REFERÊNCIAS
COMPLEMENTARES
JOHANNA Döbereiner. Memória Embrapa. Disponível em: https://www.embrapa. br/en/memoria-embrapa/ personagens/johanna -dobereiner. Acesso em: 7 ago. 2025.
Nesse site, acesse informações sobre a vida e a carreira da agrônoma Johanna Döbereiner.
As bactérias conhecidas como rizóbios, por exemplo, vivem no solo e podem se alojar nas raízes de certos tipos de plantas, formando pequenos nódulos nelas.
Essas bactérias são capazes de captar da atmosfera o nitrogênio, um nutriente necessário ao crescimento adequado das plantas, mas que não está diretamente disponível para os vegetais.
Ao se associarem às plantas, as bactérias fornecem nitrogênio para elas. As plantas, por sua vez, fornecem às bactérias nutrientes produzidos na fotossíntese e utilizados como fonte de energia por esses microrganismos.

BACTÉRIAS, PLANTAS E DUAS IMPORTANTES
CIENTISTAS BRASILEIRAS
As cientistas e agrônomas Johanna Döbereiner (1924-2000) e Mariangela Hungria da Cunha (1958-) dedicaram-se a estudar as relações entre bactérias e plantas, e suas pesquisas transformaram a agricultura brasileira. Com base nelas, bactérias capazes de fornecer nutrientes aos vegetais passaram a ser utilizadas no cultivo de algumas plantas, substituindo os fertilizantes minerais.
Além de ser menos prejudicial ao ambiente, o uso desses microrganismos na agricultura permitiu a redução do custo de cultivo de plantas como a soja. Com isso, o grão da soja tornou-se um dos principais produtos agrícolas exportados pelo país.

Döbereiner observando amostra de bactérias.

Mariangela Hungria da Cunha no laboratório que atua como pesquisadora, em Londrina, no Paraná.
MARIANGELA Hungria: a microbiologista que semeia futuro e colhe reconhecimento. Ministério da Ciência, Tecnologia e Inovação, 21 mar. 2025. Disponível em: https://www.gov.br/mcti/ pt-br/acompanhe-o-mcti/noticias/2025/03/ mariangela-hungria-a-microbiologista-que -semeia-futuro-e-colhe-reconhecimento. Acesso em: 7 ago. 2025.
Nesse site, conheça mais sobre a agrônoma Mariangela Hungria da Cunha.
ATIVIDADE EXTRA
Oriente os estudantes a fazerem uma pesquisa sobre outros papéis que as bactérias
desempenham que tragam benefícios ao ambiente ou a outros seres vivos, ou a utilização das bactérias na confecção de produtos usados pelos seres humanos. Solicite-lhes que anotem no caderno o nome científico dessa bactéria e escrevam um breve texto explicativo de como ela atua. Depois de realizarem a atividade, peça a cada um que leia em voz alta o texto produzido, incentivando todos a participarem. Caso algum deles não se sinta à vontade para fazer a leitura, pergunte se um voluntário pode ler o texto. O importante é todos terem acesso às informações pesquisadas.
nódulos
Raiz de uma planta com nódulos formados por bactérias.
Johanna
As bactérias são capazes de realizar o processo de respiração e necessitam de gás oxigênio. No entanto, existem bactérias capazes de viver em ambientes sem gás oxigênio, pois realizam um processo chamado fermentação
Algumas bactérias que realizam fermentação são utilizadas na indústria alimentícia para produzir alimentos, como iogurtes, queijos, vinagre e leite fermentado.


Fermentação: processo de obtenção de energia sem a utilização do gás oxigênio.
Bactérias Lactobacillus bulgaricus (A) e Streptococcus thermophilus (B) em iogurte. Imagem ampliada cerca de 4 375 vezes e colorida em computador.
Apesar da importância das bactérias para o ambiente e para os seres vivos, algumas delas podem prejudicar a saúde do ser humano e causar doenças como tétano, meningite, tuberculose, botulismo e cólera.
A cólera é uma doença causada pela bactéria Vibrio cholerae. A infecção ocorre quando o ser humano ingere água ou alimentos contaminados por essa bactéria.
A pessoa com cólera pode ter dores abdominais, diarreia e vômito, o que pode levar à desidratação e à morte.
Bactéria Vibrio cholerae Imagem ampliada cerca de 6 000 vezes e colorida em computador.

BNCC
• Ao abordar como assunto a bactéria Vibrio cholerae, causadora da cólera, e sua maneira de transmissão, desenvolve-se a habilidade EF04CI08, pois os estudantes são incentivados a refletirem sobre medidas adequadas à prevenção dessa doença.
• Caso os estudantes tenham dificuldade em realizar a atividade 6, pergunte a eles de que maneira uma pessoa pode se contaminar com a bactéria Vibrio cholerae Questione também se a contaminação ocorre por meio de respiração, ingestão, contato com pessoas infectadas etc. Estabelecida a forma de contaminação, peça-lhes que citem o que podemos fazer para garantir a remoção dessas bactérias dos alimentos, uma vez que não conseguimos enxergá-las a olho nu.
REFERÊNCIAS COMPLEMENTARES
CÓLERA. Ministério da Saúde. Disponível em: https:// www.gov.br/saude/pt-br/ assuntos/saude-de-a-a -z/c/colera. Acesso em: 22 jul. 2025.
6. Faça uma pesquisa e responda de que modo podemos prevenir a cólera. Registre a resposta no caderno.
Resposta: A prevenção inclui cuidados com a higiene pessoal, como lavar as mãos
antes das refeições e após usar o banheiro. Além disso, deve-se ingerir apenas água filtrada ou fervida e lavar bem os alimentos antes de consumi-los.
AVALIANDO
Objetivo
• Verificar se os estudantes compreenderam que as bactérias não causam apenas prejuízos aos seres humanos.
Sugestão de intervenção
O assunto sobre as bactérias termina nesta página com um exemplo de uma consequência negativa causada por esses organismos aos seres humanos. Para avaliar se os estudantes
01/10/2025 09:37:36
não ficaram com a percepção de que bactérias só causam prejuízos, peça-lhes que façam uma breve conclusão sobre a temática. Ouça os comentários deles, escreva os principais tópicos na lousa e verifique se todos compreenderam que esses microrganismos desempenham papéis importantes na natureza, como a decomposição da matéria orgânica, e também podem ser utilizados na indústria alimentícia, por exemplo. Enfatize que uma minoria das bactérias causa doenças, mas é necessário estarem atentos às maneiras de prevenção.
Acesse a página do Ministério da Saúde para ler mais informações sobre causas, sintomas, transmissão, tratamento e diagnóstico da cólera.
Iogurte.
A.
B.
BNCC
• A atividade 7 desta página contribui para o desenvolvimento da habilidade EF04CI06, pois relaciona a participação de fungos ao processo de decomposição.
• No item a da questão 7, caso os estudantes tenham dificuldade em lembrar se já se alimentaram de cogumelos, cite os mais comuns utilizados na culinária, como o champignon, o funghi e o shiitake
• No item b da atividade 7, caso os estudantes tenham alguma dificuldade, explique-lhes que, apesar de o bolor e o cogumelo serem muito diferentes, ambos são formados por fungos. Diga que bolor e mofo são termos populares utilizados para se referir aos fungos que surgem sobre os alimentos.
• No item c da questão 7, verifique se os estudantes comentam em suas respostas que o bolor precisa dos nutrientes presentes no pão para obter energia.
• Se possível, mostre aos estudantes fungos comestíveis, como o champignon (Agaricus bisporus) e o shiitake (Lentinula edodes). Se julgar pertinente, leve para sala de aula fotografias de pratos que têm os cogumelos comestíveis em seu preparo, como molhos, omeletes, saladas e risotos. Comente que não devemos ingerir cogumelos que não conhecemos, pois algumas espécies são venenosas.
• Pergunte-lhes se pães ou outros alimentos com bolor estão adequados para o consumo. Verifique se reconhecem que alimentos com bolor não devem ser consumidos, pois podem prejudicar a saúde. Pergunte também o que podem fazer quando encontram um alimento embolorado em um mercado. Verifique se respondem que, além de não comprar, devem avisar um funcionário do mercado para que retire o produto da gôndola.
FUNGOS
7. a) Resposta pessoal. O objetivo desta atividade é incentivar a participação dos estudantes e o compartilhamento de vivências sobre o assunto.
7. Confira as imagens a seguir.


a ) Você já consumiu um alimento preparado com cogumelos comestíveis? Em caso afirmativo, converse com os colegas sobre isso.
b ) O que o cogumelo mostrado na imagem A tem em comum com o bolor presente no pão retratado na imagem B?
c ) Em sua opinião, por que o bolor se desenvolve no pão?
A maioria dos fungos vive livremente na natureza, em locais úmidos e com alimento disponível. Alguns deles são formados por várias células e podem ser observados a olho nu, como os cogumelos e as orelhas-de-pau.
Orelha-de-pau: pode atingir cerca de 13 cm de diâmetro.
7. b) Resposta: Tanto o cogumelo como o bolor do pão são fungos.
Orelhas-de-pau.
Alguns fungos, como as leveduras, são formados por apenas uma célula e só podem ser observados com o auxílio de um microscópio.
7. c) Resposta pessoal. O objetivo desta questão é levantar os conhecimentos prévios dos estudantes a respeito das características dos fungos.
Leveduras Saccharomyces cerevisiae. Imagem ampliada cerca de 3 000 vezes e colorida em computador.
• Depois de realizar a atividade, pergunte se os estudantes já viram cogumelos em algum ambiente e peça-lhes que citem as principais características desse local. Verifique se percebem que os cogumelos geralmente se desenvolvem em ambientes úmidos e ricos em matéria orgânica e prossiga com a leitura da página.


Cogumelos comestíveis.
Pão com bolor.
bolor
Os fungos podem ser utilizados na fabricação de alimentos, na produção de combustíveis e medicamentos.
Na produção de queijos azuis, como os do tipo gorgonzola e roquefort, é utilizado o fungo Penicillium roqueforti, responsável pela coloração azul-esverdeada e pelo sabor característico desse tipo de queijo.

Outro exemplo de alimento que leva fungos no preparo é o pão. O fermento biológico utilizado nele contém a levedura
Saccharomyces cerevisiae
8. Qual é a importância do fermento para o preparo do pão?
Na preparação do pão, as leveduras do fermento realizam fermentação ao se alimentarem de alguns dos ingredientes adicionados à massa, como o açúcar e o amido contido na farinha, liberando gás carbônico e álcool.
O gás carbônico fica retido na massa, formando pequenas câmaras com gás, que fazem o pão crescer e ficar macio. Já o álcool formado evapora enquanto o pão assa.

fungos

A Saccharomyces cerevisiae também é utilizada na fabricação do etanol, combustível produzido pela fermentação da cana-de-açúcar. Nesse processo, a levedura consome o açúcar da cana-de-açúcar, liberando álcool e gás carbônico. 8. Resposta: O fermento é importante para o crescimento da massa.
a leitura da receita e, no modo de preparo, pergunte aos estudantes por que acham que após o preparo da massa é necessário aguardar um tempo antes de levá-la ao forno. Permita que verbalizem o raciocínio, engajando-os na construção do conhecimento sobre o tema. Verifique se associam o tempo de espera ao crescimento da massa de pão e identificam as leveduras do fermento biológico como item fundamental para que esse crescimento ocorra.
BNCC
• A abordagem desta página contribui para o desenvolvimento da habilidade EF04CI07 , pois permite aos estudantes que identifiquem a participação dos fungos na produção de alimentos, como o queijo e o pão, e na produção de combustíveis, como o etanol.
• Antes de fazer a leitura com os estudantes sobre a participação das leveduras no preparo do pão, faça a seguinte pergunta: “Quem já observou um pão sendo preparado por um adulto?”. Caso algum estudante responda que sim, questione: “Quais ingredientes são utilizados no preparo do pão?”. Permita que verbalizem seus conhecimentos e acolha as respostas, anotando os ingredientes citados na lousa. Se julgar pertinente, realize a atividade extra sugerida a seguir.
ATIVIDADE EXTRA
Leve para a sala de aula uma receita de preparo de pão que leve fermento biológico e apresente-a para os estudantes.
Destaque o uso de fermento biológico no preparo do pão e questione o significado da palavra biológico Verifique se eles associam essa palavra à presença de seres vivos no ingrediente e explique que o fermento biológico contém as leveduras Saccharomyces cerevisiae. Continue com
01/10/2025 09:37:40
• Na questão 8, verifique se os estudantes compreendem que o fermento biológico é composto pela levedura Saccharomyces cerevisiae e que esse microrganismo é fundamental para o crescimento da massa do pão. Se tiverem dificuldade em responder, questione-os se a massa do pão cresceria caso o fermento não fosse adicionado.
Penicillium roqueforti. Imagem ampliada cerca de 205 vezes e colorida em computador.
Queijo azul.
Massa de pão.
BNCC
• Ao exercitar a curiosidade e a investigação sobre atuação dos microrganismos na produção de alimentos como o pão, esta seção contribui com o desenvolvimento da Competência geral 2, da Competência específica de Ciências da Natureza 2 e da habilidade EF04CI07
Objetivos
• Verificar a ação de microrga nismos com base na observação dos produtos gerados no processo de fermentação realizado por eles.
• Identificar a participação de microrganismos na produção de alimentos.
• Avaliar se ingredientes utilizados no preparo do pão, como o açúcar e a farinha, influenciam a atividade das leveduras do fermento biológico.
Resposta
a) Resposta pessoal. O objetivo desta questão é levar os estudantes a refletirem sobre as condições necessárias para a ação das leveduras do fermento biológico.
• Na questão a, permita que se expressem livremente. Anote na lousa todas as respostas, antes do início da investigação, para que possam ser confrontadas posteriormente com os resultados obtidos na atividade experimental.
• Alguns materiais indicados para a realização desta atividade experimental podem ser substituídos: o cronômetro, por um relógio, tomando-se nota do horário inicial da prática para marcar a passagem do tempo; e a fita adesiva, por elástico, para prender os balões nas aberturas das garrafas.
• Caso a coleta de resíduos sólidos recicláveis e a separação dos resíduos sólidos ocorram no ambiente escolar ou na comunidade
VAMOS INVESTIGAR
a ) Além do fermento biológico, você acha que outros ingredientes, como a farinha e o açúcar, podem interferir no crescimento da massa de um pão?
Resposta nas orientações ao professor
MATERIAIS NECESSÁRIOS
• fermento biológico seco instantâneo
• açúcar
• farinha de trigo
• água morna
• 5 garrafas plásticas transparentes de 500 mL cada, com tampa
• caneta hidrográfica permanente
• 5 balões de festa
• funil
• xícara de chá
• fita adesiva
• cronômetro
Identifique as garrafas plásticas com A, B, C, D e E utilizando a caneta hidrográfica permanente.
Com o auxílio do funil, preencha as garrafas com meia xícara de cada ingrediente conforme o indicado a seguir.
Garrafa A: açúcar
Garrafa B: farinha de trigo
Garrafa C: fermento biológico
Garrafa D: açúcar + fermento biológico
Garrafa E: farinha de trigo + fermento biológico
Peça a um adulto que adicione uma xícara de água morna em todas as garrafas.

do estudante, ao final da atividade prática, oriente a turma a dispensar o conteúdo das garrafas e higienizá-las para destiná-las à reciclagem. Caso não ocorram nesses ambientes, incentive a reutilização das garrafas.
• Antes do início da prática, instrua os estudantes a encherem os balões de festa para verificar se não estão furados. Oriente-os a encher o balão até que atinja o tamanho aproximado de uma laranja. Diga a eles que não devem encher demasiadamente os balões para não os afrouxar. Em seguida, instrua os estudantes a segurarem a abertura do balão por aproximadamente 30 segundos, impedindo que o ar saia por ela. Caso
Adulto adicionando água morna nas garrafas A, B, C, D e E
algum balão murche, deverá ser substituído. Separe alguns balões extras para a substituição, se necessário.
• Instrua os estudantes a pedirem a um adulto que aqueça a água na etapa C e oriente-os a não manipular a água aquecida.
C.
A. C. B. D. E.
D.
Tampe as garrafas e vire-as para baixo e para cima para misturar os materiais.
E.
F.
Pessoa misturando o conteúdo de uma das garrafas.
Destampe as garrafas e encaixe os balões de festa rapidamente na abertura de cada uma delas.
Utilizando a fita adesiva, prenda bem os balões nas aberturas das garrafas.
Balão de festa sendo preso na abertura de uma das garrafas.


G. Agora, responda às questões a seguir no caderno.
Utilize o cronômetro para marcar 20 minutos. Após esse tempo, analise cada uma das montagens e registre no caderno o que você observou.
Resposta nas orientações ao professor
1. O que aconteceu com os balões de festa em cada uma das garrafas na etapa G?
2. Com base em seus conhecimentos, explique os resultados observados.
3. Após a realização dessa atividade prática, como você responderia à pergunta do início desta seção?
4. Por que, na prática realizada, a água adicionada nas garrafas precisa estar morna? Se necessário, faça uma pesquisa para responder a esta questão.
5. Você acha que os resultados dessa prática seriam parecidos se, em vez de água morna, fosse adicionada água quente às garrafas? Justifique sua resposta.
6. Você obteve os mesmos resultados que seus colegas? Caso os resultados tenham sido diferentes, como vocês poderiam explicar essas diferenças?
3. Resposta pessoal. O objetivo desta questão é levar os estudantes a retomarem suas respostas iniciais, corrigindo-as, se necessário, com informações adquiridas ao longo da atividade prática. Espera-se que comentem que o fermento biológico é fundamental para o crescimento da massa do pão, além de perceberem que usar algum açúcar na massa é importante para que a levedura realize o processo de fermentação e a massa do pão cresça e se torne macia. Caso algum estudante tenha respondido inicialmente que apenas o fermento é necessário
ao crescimento da massa, peça a ele que compare os resultados obtidos da garrafa C, que continha apenas fermento, e das garrafas D e E, com açúcar e farinha, respectivamente. Verifique se percebem que a atividade das leveduras foi maior nas garrafas D e E
4. Espera-se que os estudantes infiram que a temperatura da água pode afetar a sobrevivência e a atividade das leveduras.
5. Resposta pessoal. Espera-se que os estudantes mencionem que os resultados seriam diferentes. Verifique se eles comentam que provavelmente nenhum
• Na etapa D, diga aos estudantes que eles devem fechar bem as garrafas antes de virá-las.
• Na etapa E, diga aos estudantes que eles devem encaixar rapidamente os balões nas aberturas das garrafas, pois o fermento biológico pode reagir pouco tempo depois de entrar em contato com alguns ingredientes. Se necessário, auxilie-os nessa etapa.
Respostas
1. Espera-se que os estudantes comentem que os balões das garrafas C, D e E inflaram com o passar do tempo, enquanto os balões das garrafas A e B permaneceram murchos ao longo dos 20 minutos.
2. Resposta pessoal. O objetivo desta questão é levar os estudantes a relacionarem o conteúdo abordado na unidade à atividade prática realizada. Espera-se que comentem que os balões das garrafas D e E inflaram, pois, ao consumirem o açúcar e o amido da farinha presentes no conteúdo das garrafas D e E, respectivamente, as leveduras realizaram o processo de fermentação, liberando etanol e gás carbônico. O gás carbônico liberado fez que os balões inflassem. Caso tenham observado o enchimento do balão também na garrafa C, comente que isso pode ocorrer em razão da presença de açúcares na composição do fermento biológico seco.
01/10/2025 09:37:43
dos balões inflaria ou inflaria muito pouco, pois a temperatura elevada da água poderia prejudicar a sobrevivência das leveduras, diminuindo a atividade delas.
6. Resposta pessoal. O objetivo desta questão é levar os estudantes a compararem os resultados obtidos na prática e formularem hipóteses a fim de explicarem as diferenças, caso haja alguma.
BNCC
• Ao relacionar a participação de fungos e bactérias no processo de decomposição de alimentos e na liberação de nutrientes no solo, a atividade 9 contribui para o desenvolvimento da habilidade EF04CI06 , pois incentiva os estudantes a reconhecerem a importância ambiental desses microrganismos.
• Na atividade 9, caso os estudantes não associem o papel dos fungos e das bactérias à decomposição da matéria orgânica, retome com eles a interação dos microrganismos com outros seres vivos em uma cadeia alimentar. Leve-os a resgatar o conhecimento de que esses microrganismos desempenham um importante papel na ciclagem dos nutrientes.
• Explique aos estudantes que a compostagem é um processo simples que traz diversos benefícios para o ambiente, por exemplo, o aumento de infiltração e retenção de água, a diminuição do risco de erosão, o aumento do fornecimento de micro e macronutrientes que favorecem o crescimento das plantas e a diminuição do volume de rejeito orgânico e da liberação de gases do efeito estufa.
BNCC
• A abordagem sobre micoses e a atividade 10 levam os estudantes a refletirem sobre os cuidados que ajudam a evitar a onicomicose, o que contribui para o desenvolvimento da habilidade EF04CI08. Além disso, incentivam a terem atitudes que promovem o cuidado de si e do próprio corpo e seu bem-estar, recorrendo aos conhecimentos das Ciências da Natureza, favorecendo o desenvolvimento da Competência geral 8 e da Competência específica de Ciências da Natureza 7
• Explique aos estudantes
9. Na imagem, uma pessoa está misturando restos de alimentos ao solo, que, após certo tempo, ficará rico em nutrientes, podendo ser utilizado para plantação.
Por que o solo, que possui fungos e bactérias, fica rico em nutrientes após esse processo?
Pessoa preparando solo para compostagem.

Apesar da importância na indústria e da importância ambiental, alguns fungos podem prejudicar a saúde do ser humano e de outros seres vivos, causando infecções conhecidas como micoses. Confira o exemplo a seguir.
A onicomicose é uma infecção fúngica que acomete as unhas. Elas acabam ficando manchadas, endurecem e descolam dos dedos.
Em geral, a onicomicose ocorre nos pés, pois os calçados proporcionam um ambiente quente e úmido, ideal para o desenvolvimento do fungo.
Unha de pé humano com onicomicose.

10. Escreva no caderno como o cuidado mostrado na fotografia pode ajudar a evitar infecções por fungos.

Resposta: Espera-se que os estudantes comentem que secar os pés após o banho ajuda a evitar infecções fúngicas, uma vez que os fungos necessitam de um ambiente úmido para se desenvolverem.
9. Resposta: Espera-se que os estudantes respondam que esses seres vivos microscópicos presentes no solo realizam o processo de decomposição dos restos de alimentos, tornando os nutrientes disponíveis para as plantas.
secando os pés após o banho.
que a onicomicose pode ser adquirida pelo uso de alicates de unha e pelo contato com solo, animais e pessoas contaminados com o fungo.
• Se julgar interessante, explique aos estudantes que esse tipo de infecção ocorre porque o fungo causador se alimenta da queratina, uma proteína que forma a maior parte das unhas.
• Na atividade 10, comente com os estudantes que, além de lavar os pés diariamente e secar bem entre os dedos, é importante usar calçados arejados, trocar as meias com frequência e dar preferência a meias de tecido de algodão, para não acumular suor na pele, pois a umidade nos pés cria um ambiente favorável à ocorrência de micoses.
REFERÊNCIAS COMPLEMENTARES
MICOSE. Sociedade Brasileira de Dermatologia. Disponível em: https://www.sbd.org.br/ doencas/micose-2/. Acesso em: 22 jul. 2025. ONICOMICOSE. Sociedade Brasileira de Dermatologia. Disponível em: https://www.sbd.org. br/cuidados/onicomicose/. Acesso em: 22 jul. 2025.
Essas indicações apresentam alguns aspectos gerais, sintomas, tratamentos e prevenção das infecções causadas por fungos.
Pessoa
BNCC
A DESCOBERTA DA PENICILINA
Os fungos também são utilizados na produção de medicamentos, como a penicilina.
O bacteriologista britânico Alexander Fleming (1881-1955) estudava maneiras de combater bactérias que causavam infecções e, por acaso, fez uma das maiores descobertas do século 20.
Fleming esqueceu algumas de suas placas de cultura de bactérias sem tampa. Em contato com o ar atmosférico, essas placas foram contaminadas por fungos do gênero Penicillium

Após alguns dias, o bacteriologista percebeu que, na região próxima ao fungo, as bactérias não conseguiam se desenvolver.
Placa de cultura de Alexander Fleming contendo colônias de bactérias e fungos do gênero Penicillium
bactérias fungos Fleming descobriu que o fungo produzia uma substância que matava vários tipos de bactérias: a penicilina, primeiro antibiótico da história. O bacteriologista divulgou sua descoberta em 1929, mas a penicilina só foi produzida em laboratório em 1938.
A penicilina foi muito utilizada na Segunda Guerra Mundial (1939-1945), salvando milhares de soldados feridos. Graças ao antibiótico descoberto por Alexander Fleming, algumas doenças como pneumonia, sífilis e tuberculose deixaram de ser fatais.
Com o avanço da Ciência e da Medicina, foram desenvolvidos muitos antibióticos, o que possibilitou o tratamento de infecções bacterianas que acometem os seres humanos e outros animais.
Bacteriologista: pessoa especializada em estudar bactérias.
Antibiótico: medicamento utilizado no tratamento de doenças causadas por bactérias.
medicamentos sem indicação médica. Caso não saibam essas informações, comente alguma situação sua em que foi necessário tratar com antibióticos.
• Explique aos estudantes que os antibióticos são medicamentos essenciais no tratamento de doenças bacterianas, pois inibem a reprodução das bactérias ou causam a morte delas. Diga-lhes que todo antibiótico tem um tempo diferente de duração no organismo e cada infecção bacteriana exige um tempo específico de tratamento. Por isso, é importante seguir corretamente todas as orientações
médicas, como o horário de ingestão e a duração do tratamento. Comente que o uso excessivo e de modo incorreto de antibióticos pode causar a seleção de bactérias resistentes a esses medicamentos, dificultando o tratamento das doenças. Quando a prescrição médica não é seguida corretamente, as bactérias mais resistentes podem não ser mortas pelo medicamento e se reproduzirem, aumentando sua quantidade no organismo. O antibiótico utilizado pode não ser eficiente contra essas bactérias, resultando em graves problemas de saúde.
• A abordagem desta página possibilita desenvolver a Competência geral 1, a Competência específica de Ciências da Natureza 1 e a habilidade EF04CI07, pois leva os estudantes a conhecerem a história de um evento acidental ocorrido no século XX, em que se descobriu que um microrganismo era capaz de produzir uma substância com atividade antibacteriana e passou-se a utilizá-lo para produzir o primeiro medicamento antibiótico da história. Aproveite esta seção para discutir com a turma a importância e as implicações das pesquisas científicas na sociedade.
• Incentive os estudantes a analisarem o crescimento de fungos e bactérias na placa de cultura de Alexander Fleming (1881-1955). Verifique se eles notam que as bactérias não se desenvolveram nas proximidades do fungo e se atribuem esse fato à produção da penicilina.
• Pergunte a eles se já tomaram antibióticos e em quais situações. Incentive os estudantes a falarem da doença que trataram com o antibiótico, se consultaram um profissional da saúde para obter a indicação da medicação e se seguiram todas as indicações do médico, quanto tempo durou o tratamento, entre outras questões. Enfatize a importância de não consumir
01/10/2025 09:42:15
REFERÊNCIAS
COMPLEMENTARES
ZORZETTO, Ricardo. O avanço das superbactérias. Pesquisa Fapesp, n. 335, p. 12-17, jan. 2024. Disponível em: https:// revistapesquisa.fapesp.br/wp-content/ uploads/2024/01/012-017_capa-infeccoes_335-Parte-1.pdf. Acesso em: 22 jul. 2025.
Essa reportagem aborda os problemas e os desafios que microrganismos resistentes a medicamentos impõem à saúde no Brasil e no mundo.
Retrato de Alexander Fleming.
• Os protozoários fazem parte dos protistas, um grupo não monofilético, ou seja, que não compartilha um ancestral em comum. O termo protista é utilizado para fazer referência a seres vivos eucariotos que não são classificados como plantas, animais ou fungos. Assim, os protistas incluem uma série de seres vivos eucarióticos, de maioria microscópica e unicelular, fotoautotróficos e heterotróficos e com diferentes parentescos. Nessa unidade, que apresenta os microrganismos, bem como as doenças causados por esses seres microscópicos e sua prevenção, optamos por abordar os protozoários, em razão da a importância médica desse grupo de protistas.
• Leia o trecho de reportagem a seguir para os estudantes.
Toxoplasmose: doença é transmitida por água e alimentos contaminados; casos graves podem causar perda de visão e danos cerebrais [...]
A toxoplasmose é uma infecção causada pelo protozoário Toxoplasma gondii, transmitido principalmente pelo consumo de água ou alimentos contaminados. [...]
Manter boas práticas de higiene pessoal e dos alimentos, além de fazer acompanhamento pré-natal, no caso das gestantes, são as medidas mais eficazes para evitar a toxoplasmose.
Ao contrário da crença popular, o Ministério da Saúde ressalta que o contato com gatos e felinos não causa a doença. A transmissão ocorre no contato com fezes contaminadas de felinos, no consumo de água contaminada ou alimentos mal lavados ou mal cozidos.
TAVARES, Aline. Toxoplasmose: doença é transmitida por água e alimentos contaminados; casos graves podem causar perda de visão e danos cerebrais. Portal do Butantan, 16 maio 2024. Disponível em: https://butantan.gov.br/ noticias/toxoplasmose-doenca-e -transmitida-por-agua-e-alimentos -contaminados--casos-graves -podem-causar-perda-de-visao -e-danos-cerebrais. Acesso em: 22 jul. 2025.
Professor, professora: O termo “protozoários” faz referência a microrganismos
PROTOZOÁRIOS
unicelulares e heterotróficos que fazem parte do grupo dos protistas. Confira mais informações sobre os protistas nas orientações ao professor
Em uma aula de Ciências, o professor de Laura coletou uma amostra de água de um rio em um parque. Acompanhe a seguir.
No parque
Vejam só, a água do rio parece limpa. Vamos analisá-la no laboratório.

Imagens com elementos sem proporção entre si. Cores fantasia.
No laboratório
Professor, tem algo se mexendo!

Laura analisando no microscópio a água coletada.
Aparentemente, a água coletada no rio estava limpa, mas ao microscópio Laura e os colegas observaram microrganismos chamados protozoários.
Os protozoários são seres vivos compostos de apenas uma célula. A maioria deles é microscópica, mas existem os que podem ser vistos a olho nu. Eles podem ser encontrados em diferentes locais do ambiente, como nos corpos de água, no solo, nos seres vivos e na matéria orgânica em decomposição.
Existem protozoários que não têm estruturas para se locomover. Outros se locomovem na água com o auxílio de estruturas, como cílios, flagelos e pseudópodes. Confira a seguir algumas estruturas de locomoção dos protozoários.
• Oriente os estudantes a fazerem uma pesquisa sobre o protozoário Toxoplasma gondii, causador da toxoplasmose, e as consequências da contaminação desse microrganismo para o ser humano. Incentive-os a conversar sobre a necessidade de manter boas práticas de higiene pessoal, consumir água potável e lavar e cozinhar bem os alimentos antes do consumo para prevenir a doença. Verifique se eles relacionam essas atitudes ao modo de transmissão.

Representação de protozoário visualizado por Laura ao microscópio.
• O conteúdo dessa página e a abordagem da reportagem sobre a toxoplasmose colaboram para o desenvolvimento da habilidade EF04CI08 da BNCC, pois leva os estudantes a reconhecerem a presença dos protozoários em meio aquático, bem como constatarem que alguns protozoários causadores de doenças podem ser transmitidos pela água, possibilitando que discutam e reconheçam medidas de prevenção dessas doenças.
01/10/2025 09:42:16
Laura e os colegas com o professor no parque.
O Paramecium se locomove por meio de cílios.

A Leishmania se locomove por meio de flagelos.
cílios flagelo

Paramecium sp. Imagem ampliada cerca de 140 vezes e colorida em computador.
Leishmania braziliensis Imagem ampliada cerca de 2 200 vezes e colorida em computador.
Além de servir de alimento para muitos seres vivos, alguns protozoários habitam parte do sistema digestório de animais, como vacas e cupins. Ali, ajudam a digerir a celulose, um tipo de açúcar encontrado nas plantas.
Protozoário Trichonympha agilis, que vive no trato digestório de cupins. Imagem ampliada cerca de 600 vezes.
A Amoeba proteus se locomove por meio de pseudópodes.

pseudópodes
Amoeba proteus. Imagem ampliada cerca de 300 vezes e colorida em computador.

Alguns protozoários também podem causar doenças nos seres humanos, como malária, amebíase, giardíase e doença de Chagas.
A doença de Chagas é transmitida ao ser humano por meio das fezes do inseto barbeiro contaminado com o protozoário Trypanosoma cruzi. Enquanto o barbeiro suga o sangue, deposita suas fezes sobre a pele da pessoa, que, ao coçar o local da picada, favorece a entrada do protozoário no organismo.
Trypanosoma cruzi

Protozoários Trypanosoma cruzi em meio a células sanguíneas. Imagem ampliada cerca de 400 vezes e colorida artificialmente.
AVALIANDO
Objetivo
• Verificar se os estudantes conhecem as principais diferenças entre bactérias, fungos e protozoários.
Sugestão de intervenção
Ao final desse tema, os estudantes devem ter percebido que alguns fungos, bactérias e protozoários têm características que os diferem uns dos outros. Oriente-os a escrever na lousa a importância de cada um desses microrganis-
Inseto barbeiro: pode atingir cerca de 4 cm de comprimento.

Inseto barbeiro.
mos para o ambiente e os seres humanos, bem como algumas doenças que alguns podem causar.
01/10/2025 09:42:23
REFERÊNCIAS COMPLEMENTARES
TAVARES, Dérica Fonçalves et al. Modelos didáticos como instrumento de inclusão em aulas práticas de microbiologia. Revista Docência do Ensino Superior, Belo Horizonte, v. 12, p. 1-21, 2022. Disponível em: https://periodicos.ufmg.br/index. php/rdes/article/view/39531/32092. Acesso em: 8 ago. 2025.
• Para promover a inclusão de estudantes com deficiência visual, desenvolva com a turma a confecção de modelos didáticos para trabalhar as estruturas de locomoção dos protozoários. Confira nas Referências complementares, desta página um artigo que aborda a confecção desse tipo de modelo para trabalhar conteúdos de Microbiologia.
• Depois de ler sobre a doença de Chagas, diga aos estudantes que ela foi descrita pelo médico brasileiro Carlos Chagas (1879-1934) no ano de 1909. Em seguida, peça a eles que pensem quais medidas de prevenção podem ser eficazes contra essa doença. Auxilie-os comentando algumas maneiras de prevenção, como o uso de inseticidas, a construção de habitações que não favoreçam a proliferação do inseto barbeiro e o uso de telas nas janelas. Para mais informações, acesse o site a seguir.
• DOENÇA de Chagas. Agência Fiocruz de Notícias . Disponível em: https://agencia.fiocruz.br/ doenca-de-chagas. Acesso em: 22 jul. 2025.
BNCC
• O conteúdo desta página possibilita o desenvolvimen to da habilidade EF04CI08, pois os estudantes aprendem como uma doença causada por um protozoário é transmitida por meio de um inseto vetor.
Esse artigo aborda a confecção e a utilização de modelos didáticos para promover a inclusão de estudantes com deficiência visual em aulas de Microbiologia.
• Ao ler a página com os estudantes, incentive-os a responder oralmente à pergunta: “Afinal, você sabe o que são vírus?”. Deixe que se expressem livremente, possibilitando o engajamento dos estudantes no aprendizado. Eles podem mencionar, por exemplo, que os vírus podem causar algumas doenças. Se julgar conveniente, acolha as respostas e anote-as na lousa. Após a leitura do tema, retome essas respostas, complementando-as, se necessário.
• Sobre os vírus, leia o texto a seguir.
[...]
A questão de os vírus serem organismos vivos ou não tem uma resposta ambígua. A vida pode ser definida como um conjunto complexo de processos resultantes da ação de proteínas codificadas por ácidos nucleicos. Os ácidos nucleicos das células vivas estão em atividade o tempo todo. Sob o aspecto de que são inertes fora das células vivas de seu hospedeiro, os vírus não são considerados organismos vivos. No entanto, quando um vírus penetra uma célula hospedeira, o ácido nucleico viral torna-se ativo, ocorrendo a multiplicação viral. Sob esse prisma, os vírus estão vivos quando se multiplicam dentro da célula hospedeira. [...]
TORTORA, Gerard J.; FUNKE, Berdell R.; CASE, Christine L. Microbiologia. 12. ed. Porto Alegre: Artmed, 2017. p. 359. • Comente com os estudantes que, por causa de suas características únicas, os vírus são considerados por alguns cientistas um organismo não vivo e por outros, um organismo vivo. Portanto, essa é ainda uma questão amplamente debatida pela Ciência. Essa abordagem colabora para o desenvolvimento da Competência específica de Ciências da Natureza 1 da BNCC ao permitir que o conhecimento científico seja reconhecido como provisório.
VÍRUS
Leia a manchete a seguir publicada em 11 de março de 2020.
Organização Mundial da Saúde declara pandemia de coronavírus
ORGANIZAÇÃO Mundial da Saúde declara pandemia de coronavírus. Agência Brasil, 11 mar. 2020. Disponível em: https://agenciabrasil.ebc.com.br/geral/noticia/2020-03/organizacao -mundial-da-saude-declara-pandemia-de-coronavirus. Acesso em: 15 abr. 2025.
Em 2020, esse comunicado tornava oficial que o mundo estava passando por uma pandemia de COVID-19, uma doença transmissível causada por um vírus.
Mas afinal, você sabe o que são vírus?
Os vírus são seres microscópicos que podem ser vistos apenas ao microscópio eletrônico.
Esses organismos não são formados por células e necessitam parasitar outros seres vivos para se reproduzir. Por essas e outras características, os vírus não são considerados organismos vivos por muitos cientistas.
Ao invadirem as células de outros seres vivos, os vírus podem causar doenças. Algumas delas afetam os seres humanos, como a COVID-19, a dengue, a gripe, o sarampo, a zika e a febre amarela.
Vírus SARS-CoV-2, causador da COVID-19, infectando células humanas. Imagem ampliada cerca de 175 000 vezes e colorida em computador.

Apesar de causarem doenças nos seres humanos, os vírus podem trazer benefícios a humanidade.
Alguns deles, por exemplo, podem ser utilizados como inseticida, atuando no controle de insetos que prejudicam a agricultura. Além disso, os vírus podem ser empregados na produção de vacinas. Algumas delas, por exemplo, podem ser fabricadas com parte do vírus ou com vírus inteiros que foram inativados, ou seja, modificados para não serem capazes de causar doenças.
Pandemia: ocasião em que uma doença transmissível afeta muitas pessoas no mundo. Coronavírus: grupo de vírus que podem causar doenças em animais. Inseticida: substância capaz de causar a morte de insetos.
• Ao expor que os vírus podem ser utilizados na produção de vacinas, se julgar pertinente, acesse com os estudantes o material Vacina 100 dúvidas, que aborda como a vacina da gripe é produzida e por que é preciso tomá-la todos os anos. INSTITUTO Butantan. Disponível em: https:// publicacoeseducativas.butantan.gov.br/. Acesso em: 22 jul. 2025.
vírus SARS-CoV-2
2. Resposta pessoal. O objetivo desta questão é levar os estudantes a analisarem a caderneta de vacinação e verificarem se estão com as vacinas em dia.
DOENÇAS CAUSADAS POR SERES MICROSCÓPICOS E SUA PREVENÇÃO

INFOGRÁFICO CLICÁVEL: OS MICRORGANISMOS COMO CAUSADORES DE DOENÇAS
Criança sendo vacinada contra a dengue em Manaus, no Amazonas, em 2024.
1. Qual é a importância da ação mostrada na fotografia?
que os estudantes mencionem a importância da vacinação como medida de
2. Você está com a vacinação em dia?
Resposta pessoal. Espera-se prevenção de doenças.
Quando estamos doentes, nossa saúde fica prejudicada e precisamos de alguns cuidados, como repouso, medicamentos e ingestão de líquidos. Embora muitas doenças tenham cura, a prevenção, quando disponível, é a melhor opção.
Uma das principais maneiras de prevenir e combater doenças no mundo é a vacinação. As vacinas estimulam o organismo a produzir defesas contra os agentes causadores das doenças, como vírus e bactérias. Assim, quando entramos em contato com esses agentes após a vacinação, nosso organismo impede que a doença se desenvolva.
A primeira vacina foi desenvolvida pelo médico britânico Edward Jenner (1749-1823). No final do século 18, muitas pessoas estavam morrendo na Inglaterra, vítimas de varíola, uma doença causada por vírus.
Desde então, com o avanço da ciência, novas vacinas vêm sendo desenvolvidas e aprimoradas, contribuindo para a prevenção de várias doenças transmissíveis.

os agentes causadores da doença nas vacas, retirados das pessoas resistentes à varíola. Para mais informações sobre o desenvolvimento da primeira vacina, leia o artigo a seguir.
• EDWARD Jenner e a inoculação vacinal. Filosofia e história da Biologia, v. 19, n. 1, p. 31-44, 2024. Disponível em: https://revistas.usp.br/ fhb/article/view/fhb-v19-n1-02/fhb-v19-n1-02. Acesso em: 22 jul. 2025.
REFERÊNCIAS COMPLEMENTARES
BIO-MANGUINHOS: Enfrentando emergências sanitárias para salvar vidas. Era Virtual. https:// www.eravirtual.org/bio-manguinhos/. Acesso em: 8 ago. 2025.
BNCC
• A abordagem desse tema contribui para o desenvolvimento da habilidade EF04CI08, da Competência geral 8 e das Competências específicas de Ciências da Natureza 7 e 8, pois permite aos estudantes que conheçam medidas adequadas para a prevenção de algumas doenças, cuidando do próprio corpo e do bem-estar e contribuindo com a saúde individual e coletiva.
• Na atividade 2, se julgar pertinente, oriente os estudantes a responderem à questão com os pais ou responsáveis, para que possam tomar as medidas necessárias em caso de atraso de alguma vacina. Se relatarem dificuldade em realizar a atividade, entre em contato com os pais ou responsáveis e auxilie-os a analisar a caderneta.
• Comente com os estudantes que Edward Jenner percebeu que as pessoas que trabalhavam extraindo leite de vacas não eram contaminadas. Depois de muitos estudos, o médico britânico identificou que as vacas desenvolviam uma doença semelhante à varíola. A doença das vacas era transmitida a quem trabalhava na extração de leite, tornando essas pessoas resistentes. Desde então, para prevenir a contaminação por varíola, Jenner começou a aplicar na população
01/10/2025 09:42:26
Essa visita virtual guiada traz uma abordagem histórica, desde o início do século XX até o ano de 2022, sobre surtos, epidemias e pandemias de doenças causadas por microrganismos que acometeram a população brasileira.
Dr. Jenner realizando sua primeira vacinação, de Ernest Board. Óleo sobre tela, 61,5 cm × 92 cm. 1796.
BNCC
• A leitura do trecho de reportagem e as atividades propostas nesta página colaboram com o desenvolvimento das Competências específicas de Ciências da Natureza 6, 7 e 8 e da habilidade EF04CI08, ao possibilitar aos estudantes que recorram aos conhecimentos de Ciências da Natureza para identificar medidas adequadas à prevenção de doenças que ajudam a promover a saúde.
Resposta
3. b) O objetivo desta questão é levantar os conhecimentos prévios dos estudantes sobre o modo de transmissão da dengue e o ciclo de vida do mosquito transmissor da doença. Espera-se que eles respondam que eliminar água parada prejudica a sobrevivência desse mosquito.
• Ao fazer com os estudantes a leitura das etapas do ciclo de vida do mosquito Aedes aegypti, explique que, mesmo na ausência de água, os ovos podem permanecer viáveis por meses no ambiente, originando novos mosquitos quando a água estiver disponível. Comente que o ciclo de vida do mosquito pode demorar de 7 a 10 dias para ser completado, a depender de alguns fatores, como temperatura e disponibilidade de alimento para as larvas no criadouro.
Resposta
4. Resposta pessoal. O objetivo desta questão é levar os estudantes a relacionarem a verificação e eliminação dos criadouros do mosquito transmissor da dengue ao ciclo de vida do inseto. Espera-se que comentem que essa medida deve ser realizada semanalmente para impedir que o mosquito chegue à fase adulta, que pode ocorrer em sete dias após a eclosão dos ovos.
3. Leia o trecho de reportagem a seguir.
Vacinação contra a dengue continua disponível para público-alvo
A SMS reforça a importância da adesão à vacinação e convida pais e responsáveis a levarem seus filhos aos postos de saúde para receberem a imunização. Além disso, destaca que a vacina não substitui as medidas de prevenção, como eliminar recipientes que acumulam água parada [...].
SMITH, Wilson. Vacinação contra a dengue continua disponível para público-alvo. Prefeitura de Maceió, 6 fev. 2025. Disponível em: https://maceio.al.gov.br/noticias/sms/vacinacao -contra-a-dengue-continua-disponivel-para-publico-alvo. Acesso em: 28 fev. 2025. [...]
Professor, professora: Comente que SMS é a sigla para Secretaria Municipal de Saúde.
a ) De acordo com o texto, qual medida, além da vacinação, pode prevenir a dengue?
Resposta: Espera-se que os estudantes citem a eliminação de recipientes que possam acumular água.
b ) Por que essa medida pode contribuir para prevenir a doença?
Resposta nas orientações ao professor
A dengue é uma doença causada por um vírus e transmitida pela picada do mosquito Aedes aegypti fêmea Confira o ciclo de vida desse mosquito.




Representação do ciclo de vida do Aedes aegypti
Mosquito da dengue (adulto): pode atingir cerca de 7 mm de comprimento.
A fêmea deposita os ovos em um recipiente com água parada, próximo da superfície da água.
Em contato com a água, os ovos se desenvolvem e deles saem as larvas, que são aquáticas.
Em cerca de cinco dias, as larvas se transformam em pupas.
A transformação da pupa em mosquito adulto pode ocorrer em dois dias.
4. Uma das recomendações para a prevenção da dengue é verificar as residências semanalmente e eliminar possíveis criadouros do mosquito. Em sua opinião, por que essa ação deve ocorrer toda semana?
Resposta nas orientações ao professor
ATIVIDADE EXTRA
Promova com os estudantes a elaboração e a encenação de uma peça teatral que aborde ações para a prevenção da dengue. Juntos, definam os personagens e elaborem o roteiro da peça. Explique que eles devem incluir no roteiro ações para evitar a proliferação do Aedes aegypti e alertar sobre quais problemas a dengue pode causar à saúde do ser humano. Peça-lhes que descrevam como montariam o cenário e o figurino da peça. Acolha as ideias e ajuste a construção desses elementos à realidade da escola. Defina com eles o papel de cada um na peça. Por fim, combine os ensaios com os
estudantes e a apresentação da peça. Se julgarem pertinente, como culminância desta atividade, verifique com a direção da escola um dia para que a comunidade escolar possa assistir à peça.
ARTICULANDO CONHECIMENTOS
A elaboração do roteiro para a peça teatral sobre a dengue, proposta na atividade extra desta página, pode ser desenvolvida com o componente curricular de Língua Portuguesa. Já a construção do cenário e do figurino e encenação permitem a interdisciplinaridade com o componente curricular de Arte.
Como você estudou, a dengue é uma doença transmissível. As doenças transmissíveis podem ser causadas por vírus, bactérias, protozoários e seres vivos conhecidos popularmente como vermes, entre outros. Essas doenças podem ser adquiridas de diferentes maneiras. Acompanhe a seguir.
Na transmissão direta, uma pessoa sadia adquire a doença pelo contato direto com a pessoa doente ou com as secreções contaminadas do doente, como saliva ou coriza. Catapora, sarampo e gripe são alguns exemplos.

As gotículas de saliva e as secreções do nariz podem contaminar outras pessoas. Por isso, devemos sempre cobrir o nariz e a boca ao espirrar ou tossir.
Na transmissão indireta, uma pessoa sadia adquire a doença por meio de objetos, água, solo ou outros animais contaminados. Dengue, febre amarela, malária, doença de Chagas e doenças causadas por vermes estão entre as doenças adquiridas dessa forma.

O solo sobre o qual caminhamos pode estar contaminado com vermes. Por isso, devemos andar calçados.
5. Além da dengue, a chikungunya, a zika e a febre amarela são doenças transmitidas pela picada da fêmea do mosquito Aedes aegypti contaminado com os vírus causadores dessas doenças. Explique com suas palavras como cada medida a seguir contribui para prevenir essas doenças.
Manter as lixeiras fechadas e protegidas da chuva.
Colocar areia nos pratinhos dos vasos de planta.
Manter a caixa-d'água da residência bem fechada.
Resposta: Essas medidas evitam o acúmulo de água e, portanto, colaboram para que o mosquito transmissor dessas doenças não se reproduza.
• Antes da leitura da atividade 5, leia para os estudantes os principais sintomas de cada doença.
• Dengue: febre alta, dor de cabeça, dores no corpo e articulações, fraqueza, dor atrás dos olhos e manchas vermelhas na pele.
• Zika: dor de cabeça, febre baixa (ou ausente), dores leves nas articulações, manchas vermelhas na pele, com coceira intensa, e vermelhidão nos olhos.
• Chikungunya: febre alta e abrupta, dores intensas nas articulações de pés, mãos, dedos, tornozelos e pulsos.
• Febre amarela: início súbito de febre, calafrios, dor de cabeça intensa, dores nas costas, dores musculares, vômitos e fraqueza.
AVALIANDO
Objetivo
• Verificar se os estudantes compreenderam que a eliminação de mosquitos é uma medida preventiva para dengue, zika, chikungunya e febre amarela, doenças de transmissão indireta transmitidas por insetos vetores.
Antes de iniciar o assunto sobre doenças transmissíveis, organize os estudantes em uma roda e inicie uma troca de ideias sobre de que modo algumas doenças, como a gripe, o sarampo e a conjuntivite, acometem o corpo humano. Com base nas respostas dadas, verifique o que sabem sobre doenças transmissíveis e como os microrganismos causadores são transmitidos.
Anote as principais ideias dos estudantes na lousa e faça um esquema que as represente. Ao final desse tópico, retome esse esquema e solicite-lhes que o complementem ou o corrijam.
BNCC
• A abordagem dessa página contribui para o desenvolvimento da habilidade EF04CI08, pois apresenta a forma de transmissão de diversos microrganismos causadores de doenças e atitudes que os estudantes devem ter para prevenir a transmissão e sua contaminação. Essas atitudes promovem o cuidado de si e do próprio corpo e seu bem-estar, além do respeito à saúde individual e coletiva, recorrendo aos conhecimentos das Ciências da Natureza, o que favorece o desenvolvimento da Competência geral 8 e das Competências específicas de Ciências da Natureza 7 e 8
01/10/2025 09:42:32
Sugestão de intervenção
Caso os estudantes tenham dificuldade em responder, pergunte qual é o tipo de microrganismo causador dessas doenças e se a maneira de transmissão é direta ou indireta. Espera-se que sejam capazes de identificar medidas de prevenção depois de verificarem que o agente causador da doença é um vírus e que a transmissão ocorre de maneira indireta, por meio da picada de mosquitos contaminados com os respectivos vírus.
Criança protegendo o nariz e a boca ao espirrar. Pessoas caminhando com calçados sobre o solo. Sadia: que não está doente.
BNCC
• Ao apresentar a vacinação como principal forma de prevenção do sarampo, a abordagem desta página colabora para o desenvolvimento da habilidade EF04CI08. Além disso, a compreensão da importância da vacinação para saúde individual e coletiva da população contribui para o desenvolvimento das Competência gerais 7 e 8 e das Competências específicas de Ciências da Natureza 7 e 8
Resposta
6. O objetivo desta questão é levar os estudantes a analisarem o gráfico. Espera-se que eles comentem que não foram registradas mortes por sarampo no Brasil do ano de 2014 até 2017. No entanto, de 2018 a 2021 as mortes por sarampo voltaram a ocorrer no país, reduzindo a zero novamente entre 2022 e 2024.
• Explique que a falta de vacinação por parte da população foi a principal causa da volta do sarampo ao Brasil, mas não a única. A alta taxa de imigração ocorrida nos últimos anos e viagens internacionais para regiões onde há ocorrência da doença também contribuíram para seu reaparecimento. Explique aos estudantes que uma população com baixa taxa de vacinação para determinada doença fica mais suscetível a disseminar casos importados dessa doença.
• Comente que uma parcela suficientemente grande da população vacinada contra determinada doença leva à chamada imunidade coletiva. Quando isso acontece, a circulação do vírus nessa população diminui, e consequentemente pessoas que não podem se vacinar também ficam protegidas.
• Se julgar pertinente, para que os estudantes compreendam melhor a im -
O sarampo é uma doença causada por vírus e transmitida de forma direta. A transmissão ocorre pelo contato com secreções de uma pessoa contaminada, como a saliva ao ser expelida pelo espirro e pela tosse.
Os sintomas da doença incluem manchas vermelhas no corpo e febre alta e as complicações da doença podem levar à morte. Análise o gráfico a seguir.
Quantidade de óbitos por sarampo no Brasil (2014-2024)
Óbitos: mortes ou falecimentos.
Fonte de pesquisa: SITUAÇÃO epidemiológica. Gov.br. Disponível em: https://www.gov.br/saude/ pt-br/assuntos/saude-de-a-a-z/s/ sarampo/situacao-epidemiologica. Acesso em: 10 abr. 2025.
6. O que você pode concluir sobre a ocorrência de mortes por sarampo no Brasil entre os anos 2014 e 2024?
Resposta nas orientações ao professor.
A principal forma de prevenção do sarampo é a vacinação.
No passado, o sarampo foi uma causa significativa de mortalidade infantil no Brasil. Essa realidade começou a mudar em 1992, com a adoção de várias medidas pelo governo para alcançar uma alta taxa de vacinação na população. Em 2016, a doença foi considerada eliminada do país pela Organização Mundial da Saúde (OMS).
No entanto, em 2018, novos casos da doença e mortes por sarampo ocorreram em território nacional, fato que foi considerado uma consequência da queda nas taxas de vacinação.
portância das altas taxas de vacinação em uma população e o conceito da imunidade coletiva, acesse o link a seguir.
• ESCOLA Superior do Instituto Butantan. Jogo da imunidade coletiva. São Paulo: Instituto Butantan, 2021. Disponível em: https://labmovel. butantan.gov.br/src/downloads/Jogo-da-imu nidade-coletiva.pdf. Acesso em: 22 jul. 2025.
• Ao ler o cartaz com os estudantes, pergunte se já ouviram falar em vacinas tríplice viral e tetra viral. Diga que essas vacinas previnem contra o sarampo e outras doenças virais e pergunte se sabem quais são essas doenças. Caso os estudantes não saibam a resposta, comente

para prevenção do sarampo.
que a tríplice viral protege contra os vírus do sarampo, caxumba e rubéola, enquanto a tetra viral protege contra os vírus do sarampo, caxumba, rubéola e varicela (conhecida como catapora), levando-os a conhecer outras doenças virais que podem ser prevenidas pela vacinação. Se julgar pertinente, comente que essas vacinas são disponibilizadas gratuitamente pelo Sistema Único de Saúde (SUS).
Quantidade de óbitos
Cartaz de campanha de vacinação da tríplice viral, uma das vacinas
COLETIVAMENTE
Vacinação e desinformação
Conhecendo o problema 1
Respostas nas orientações ao professor
Acompanhe a história em quadrinhos a seguir. [...]

https://turmadamonica.uol.com.br/revistasespeciais/vacinacao -vida-e-saude-de-montao/. Acesso em: 19 abr. 2025.
a ) Segundo a história em quadrinhos, por que as pessoas estão deixando de se vacinar?
b ) Qual é o assunto abordado no quarto e no quinto quadrinho da história?
• Diga aos estudantes que a poliomielite pode ser prevenida pela vacinação. Comente que o último caso da doença no Brasil foi registrado em 1989 e que, em 1994, foi considerada erradicada do país graças à adesão da população brasileira às campanhas de vacinação.
• Informe aos estudantes que em alguns países do mundo, como Afeganistão e Paquistão, a doença não foi erradicada e pergunte a eles se ainda há risco de que a poliomielite retorne ao Brasil e como isso poderia acontecer.
• Se julgar pertinente, acesse o site a seguir e leia com os estudantes o relato de
uma pessoa diagnosticada com poliomielite na infância.
• PINELLI, Natasha. Minha vida com sequelas da poliomielite: sobrevivente conta como experiência do passado pode proteger o futuro. Portal do Butantan, 1 nov. 2024. Disponível em: https:// butantan.gov.br/noticias/minha -vida-com-sequelas-da-poliomielite -sobrevivente-conta-como-experiencia -do-passado-pode-proteger-o-futuro. Acesso em: 22 jul. 2025.
Respostas
a) Espera-se que os estudantes respondam que, segundo a história em quadri-
BNCC
• Ao abordar os impactos da hesitação vacinal para a saúde individual e coletiva e permitir aos estudantes que reconheçam a vacinação como medida de prevenção efetiva para o controle e a erradicação de doenças transmissíveis, esta seção permite o desenvolvimento do tema contemporâneo transversal Saúde e colabora com o aprimoramento da habilidade EF04CI08, das Competências gerais 7 e 8 e das Competências específicas de Ciências da Natureza 7 e 8
OBJETIVOS
• Reconhecer a vacinação como medida preventiva importante para o controle e a erradicação de doenças transmissíveis.
• Conhecer momentos na história em que a divulgação de informações falsas e a desinformação prejudicaram a vacinação.
• Conhecer e divulgar ações necessárias para a identificação de informações falsas.
• Reconhecer que a desinformação pode prejudicar a saúde individual e coletiva.
1. CONHECENDO O PROBLEMA
• Antes da leitura da história em quadrinhos, aborde com os estudantes a poliomielite. Pergunte a eles se conhecem e o que sabem sobre essa doença. Pode ser que muitos não a conheçam, já que foi erradicada do país há mais de três décadas.
01/10/2025 09:42:33
nhos, as pessoas deixam de se vacinar por não acreditarem que doenças que foram erradicadas ou controladas pela vacinação ainda existem. Além disso, podem mencionar que a divulgação de informações falsas sobre as vacinas contribui para que muitos deixem de se vacinarem.
b) Espera-se que os estudantes respondam que o assunto abordado no quarto e no quinto quadrinho da história é a divulgação de informações falsas sobre doenças e vacinas por meio da internet.
SOUSA, Mauricio de. Turma da Mônica em: Vacinação, vida e saúde de montão. Turma da Mônica, 2021. p. 13. Disponível em:
ARTICULANDO CONHECIMENTOS
Ao tratar da revolta da população do Rio de Janeiro diante da obrigatoriedade da vacinação contra varíola no início do século XX, esta seção permite a abordagem interdisciplinar do tema contemporâneo transversal Saúde com o componente curricular de História
Com o professor desse componente, em uma aula conjunta, comentem com os estudantes que esse momento ficou conhecido como Revolta da Vacina e mencionem alguns aspectos, como o fato de a obrigatoriedade da vacina para população ter sido sugerida pelo médico sanitarista Oswaldo Cruz (1872-1914) e de a vacinação ter deixado de ser obrigatória após a revolta da população.
Abordem também que, na época, os críticos de Oswaldo Cruz e da vacinação utilizavam os meios de comunicação para espalhar informações falsas e zombar da iniciativa. Charges nos jornais e marchinhas de Carnaval foram criadas para incentivar as pessoas a não se vacinarem. Comentem que, nesse contexto de hesitação vacinal, em 1908, uma epidemia de varíola ocorreu no Rio de Janeiro, levando a 6 500 mortes somente naquele ano. Expliquem que, com o aumento dos casos e mortes pela doença, a população começou, então, a buscar a vacinação por conta própria. Informem aos estudantes que a varíola só foi erradicada no Brasil em 1971.
Resposta
c) O objetivo desta questão é levar os estudantes a refletirem sobre o tema. Espera-se que comentem que a divulgação de informações falsas pode influenciar as pessoas a acreditarem que as vacinas não têm efetividade ou podem causar doenças. Essa descrença faz que a quantidade de pessoas vacinadas diminua, e doen-
As campanhas de vacinação já foram prejudicadas pela desinformação em diferentes momentos da história.
Recentemente, entre os anos 2020 e 2023, o mundo enfrentou a pandemia de COVID-19. No início da pandemia, não havia vacinas para o combate da doença.
Em 2021, quando as vacinas foram disponibilizadas e teve início a campanha de vacinação contra a COVID-19, diversas informações sobre supostos prejuízos que elas poderiam causar foram divulgadas. Essas informações não foram comprovadas cientificamente, eram falsas, mas a divulgação delas levou muitas pessoas a deixarem de se vacinar.
Em um passado menos recente, a vacina utilizada na prevenção da varíola comum também foi alvo da desinformação.
Em 1904, durante um aumento de casos e mortes por varíola na cidade do Rio de Janeiro, uma lei federal tornou obrigatória a vacinação contra a doença. Essa medida, somada a outros problemas sociais, levou a população a se revoltar e a ser contra a vacinação. Na época, influenciada por informações incorretas, parte da população não acreditava na efetividade da vacina como medida preventiva.
A varíola comum é hoje uma doença erradicada do mundo, mas o Brasil foi um dos últimos países a se ver livre da doença.
c ) Como a divulgação de informações falsas sobre as vacinas pode prejudicar a saúde de uma população?
Resposta nas orientações ao professor
Organizando as ideias 2
As informações falsas não se baseiam em estudos científicos. Muitas vezes, estão fora de contexto ou podem ter sido criadas para enganar as pessoas em favor de algum interesse de quem as criou.
É fundamental refletir sobre o que lemos e ouvimos e nos questionar se as informações são verdadeiras. Além disso, devemos buscar fontes de informação confiáveis e não propagar informações sem conferi-las antes.
Imagem com elementos sem proporção entre si. Cores fantasia.
Representação de estudantes conferindo a veracidade de informações.
ças que já tinham sido eliminadas ou estavam sob controle em uma população retornem.
• No item c, se julgar pertinente, retome o conteúdo abordado anteriormente sobre o sarampo para exemplificar o que pode acontecer quando a cobertura vacinal para determinada doença diminui.
2. ORGANIZANDO AS IDEIAS
BNCC
• A abordagem sobre a identificação e o reconhecimento de informações falsas colabora

para o desenvolvimento da Competência geral 5 e da Competência específica de Ciências da Natureza 5, ao permitir aos estudantes que compreendam como utilizar as tecnologias digitais para acessar informações confiáveis, possibilitando que utilizem esse tipo de informação para embasar seus argumentos e se comunicarem. Além disso, a produção e divulgação de um material sobre esse assunto, proposta nesta seção, permite o desenvolvimento da educação midiática, promovendo o combate à desinformação e colaborando para formação de cidadãos conscientes.
Agora, responda às questões a seguir oralmente.
Respostas nas orientações ao professor.
a ) Você ou algum familiar já leu ou ouviu uma informação falsa? Qual foi a sua reação?
b ) Você considera que essas informações falsas podem impactar as pessoas? Se sim, como?
c ) Quais são os meios e as pessoas que você costuma buscar para se manter informado? Você considera essas fontes confiáveis? Por quê?
d ) Você acredita que é capaz de diferenciar informações verdadeiras de informações falsas?
Buscando soluções 3
Respostas nas orientações ao professor.
a ) Em sua opinião, o que é necessário para evitar a divulgação de informações falsas?
b ) Junte-se a três colegas e façam uma pesquisa sobre maneiras de reconhecer uma informação falsa.
c ) Troque ideias com o seu grupo sobre qual das ações pesquisadas vocês já conheciam e qual delas já tinham o hábito de realizar.
d ) Com o grupo, elaborem um material informativo abordando os temas a seguir.
• O que são informações falsas?
• Quais são as possíveis consequências da divulgação de informações falsas?
• Como proceder para verificar a veracidade de uma informação?
e ) Com a ajuda do professor, exponham esse material na escola.
Imagem com elementos sem proporção entre si. Cores fantasia.
Representação de estudantes expondo os trabalhos na escola.

b) O objetivo desta questão é levar os estudantes a reconhecerem diferentes maneiras de identificar informações falsas. Eles podem citar que, para reconhecer uma informação falsa, é necessário: desconfiar de conteúdos exagerados, chamativos ou apelativos; perguntar onde foi publicado e conferir se o veículo de comunicação é confiável; buscar a mesma informação em outros veículos de comunicação; identificar se é um fato ou uma opinião; pesquisar o que especialistas ou agências de checagem falam sobre o assunto.
c) Resposta pessoal. O objetivo desta questão é levar os estudantes a trocarem experiências pessoais sobre atitudes que já tiveram e que possivelmente ajudaram a evitar a divulgação de uma notícia falsa.
d) O objetivo desta atividade é levar os estudantes a organizarem e revisarem o conteúdo trabalhado nesta seção e o pesquisado por eles.
• Nas questões a, b, c e d, incentive os estudantes a exporem suas vivências e pensamentos aos colegas, acolhendo respostas de todos que se sintam à vontade para verbalizá-las.
Respostas
a) Resposta pessoal. O objetivo desta questão é levar os estudantes a refletirem sobre as informações que recebem e como reagem a elas.
b) Resposta pessoal. Espera-se que os estudantes respondam que sim, pois essas informações podem impactar nas decisões de uma pessoa com relação à saúde, como deixar de se vacinar ou tomar substâncias que não fazem bem a ela.
c) Resposta pessoal. O objetivo desta questão é levantar os meios que os estudantes utilizam para se manterem informados. Eles podem citar pais, professores, livros e internet.
d) Resposta pessoal. O objetivo desta questão é levar os estudantes a refletirem sobre como se comportam diante de uma informação e a avaliarem se sabem como proceder para identificar as informações falsas.
3. BUSCANDO SOLUÇÕES
Respostas
a) Resposta pessoal. Espera-se que os estudantes comentem que é necessário reconhecer que a informação é falsa e verificar sua origem antes de compartilhá-la com outra pessoa.
01/10/2025 09:42:35
e) O objetivo desta atividade é levar os estudantes a divulgarem o conteúdo trabalhado em sala de aula para o restante da comunidade escolar, auxiliando no combate à desinformação.
• Caso julgue pertinente, esta seção pode ser desenvolvida com os estudantes em forma de projeto. Como culminância da seção, elabore com eles uma cartilha abordando como identificar informações falsas e quais são as consequências da desinformação e promova a divulgação desse material para a comunidade escolar.
BNCC
• A abordagem das doenças paracoccidioidomicose e tétano desta página colabora com o desenvolvimento da habilidade EF04CI08, ao trabalhar medidas preventivas dessas doenças, bem como seus agentes causadores.
• Na questão 7 , caso os estudantes tenham dificuldade em respondê-la, lembre-os que, em algumas técnicas de preparo do solo para o cultivo, como na aração, o solo precisa ser revolvido, o que pode fazer que a poeira fique suspensa no ar. Verifique se eles comentam que a cabine pode proteger o trabalhador da poeira, que pode conter o fungo causador da paracoccidioidomicose. Se julgar pertinente, diga aos estudantes que outra medida que pode ajudar a prevenir a doença é o uso de máscaras do tipo N95 ao realizar as atividades de manejo do solo.
• A paracoccidioidomicose é causada por fungos do gênero Paracoccidioides. Comente com os estudantes que, ao infectar o ser humano, esse fungo pode causar falta de ar, lesões na pele, febre, emagrecimento e comprometimento dos pulmões. Segundo o Ministério da Saúde, a paracoccidioidomicose é umas das principais causas de morte por doenças infecciosas e parasitárias crônicas no Brasil. Acesse o site a seguir para obter mais informações sobre essa doença.
• PARACOCCIDIOIDOMICOSE. Ministério da Saúde. Disponível em: https:// www.gov.br/saude/pt-br/ assuntos/saude-de-a-a -z/p/pcm. Acesso em: 22 jul. 2025.
• Comente com os estudantes que a principal maneira de prevenir o tétano é a vacinação. Diga a eles que no tétano acidental, após a limpeza do
7. Resposta: Espera-se que os estudantes comentem que a cabine protege o trabalhador da exposição à poeira que pode conter o fungo causador da paracoccidioidomicose.
Como você estudou, além dos vírus, fungos, bactérias e protozoários também podem causar doenças em seres humanos.
A paracoccidioidomicose é uma doença causada por um fungo que afeta principalmente o trabalhador rural e outros profissionais que manipulam o solo. Ela é adquirida principalmente pela inalação de poeira contendo o fungo causador da doença, que pode ocorrer durante o revolvimento do solo.
7. Algumas máquinas utilizadas na agricultura possuem uma cabine para acomodar o trabalhador que as operam. Explique como esse tipo de maquinário pode contribuir para a prevenção da paracoccidioidomicose.
Trabalhador rural operando máquina agrícola em Paraíso do Sul, no Rio Grande do Sul, em 2024.

Outra doença causada por um microrganismo que pode ser encontrado no solo é o tétano. Ele é causado pela bactéria Clostridium tetani. Quando ocorre um ferimento, geralmente profundo, por algum objeto contaminado com solo, essa bactéria pode invadir o corpo humano e causar a doença. O tétano pode ser prevenido pela vacinação, além de outras medidas importantes.
8. Explique como cada uma das medidas representadas a seguir pode ajudar a prevenir o tétano.

Realizar a limpeza do ferimento com água e sabão imediatamente após se ferir.

utilizando calçado sobre o solo.
8. Resposta: A limpeza do ferimento com água e sabão pode ajudar a evitar que a bactéria penetre no corpo humano. Por sua vez, o uso de calçados pode evitar que objetos contaminados com a bactéria perfurem os pés.
ferimento, recomenda-se que o ferido vá até um posto de saúde para que seja avaliada a necessidade de outros procedimentos, como o uso do soro antitetânico. Informe que os sintomas do tétano incluem dificuldade de abrir a boca (trismo), contraturas musculares, rigidez nos membros e dores nas costas e membros. Comente que o tétano é uma doença grave que pode levar à morte se não for corretamente tratada. Para mais informações acesse o site a seguir.
• TÉTANO acidental. Ministério da Saúde Disponível em: https://www.gov.br/saude/pt-br/ assuntos/saude-de-a-a-z/t/tetano-acidental. Acesso em: 22 jul. 2025.
A.
B.
Caminhar
O botulismo é uma doença que pode causar sintomas como visão embaçada, tontura e paralisia dos músculos respiratórios, dos braços e das pernas. A maneira mais comum de transmissão é por meio do consumo de ali -
b ) Escreva, no caderno, a letra do alfabeto que antecede cada uma das letras a seguir e descubra a palavra que completa corretamente o texto. Depois, reescreva a frase completa no caderno. mentos contaminados com a bactéria Clostridium botulinum, como enlatados e conservas produzidos ou armazenados inadequadamente.
9. Fernando resolveu preparar o jantar. Ao pegar uma lata de atum no armário, ele percebeu que a embalagem estava estufada. Por isso, ele decidiu não usar o produto da lata no jantar.

a ) Sabendo dos cuidados que devemos ter com a alimentação, a atitude de Fernando foi correta? Justifique sua resposta.
Resposta nas orientações ao professor
Resposta: GASES.
H B T F T
A decomposição da matéria orgânica por bactérias libera ■ no ambiente. No caso de produtos enlatados, isso pode deixar a lata estufada.
c ) Por que não devemos consumir alimentos com latas estufadas? Converse com um colega sobre isso.
Além de observar o aspecto dos alimentos que vamos consumir, outros cuidados devem ser tomados para prevenir doenças transmitidas por alimentos contaminados. Confira alguns desses cuidados a seguir.
Lavar as mãos com água e sabão antes de manipular os alimentos.
Alimentos como ovos e carnes devem ser consumidos bem cozidos.
Alimentos que são consumidos crus, como frutas e verduras, devem ser higienizados.
9. c) Resposta: O objetivo desta questão é levar os estudantes a identificarem hábitos que possam prevenir doenças.
Resposta
9. a) Resposta pessoal. Espera-se que os estudantes comentem que a atitude de Fernando foi correta, pois é preciso analisar o estado da embalagem dos alimentos antes de consumi-los. Alimentos enlatados não devem ser consumidos caso as latas estejam amassadas ou estufadas.
• Explique aos estudantes que é preciso verificar diversos fatores no armazenamento de alimentos, como temperatura, umidade e local de armazenamento. Cada alimento precisa de uma condição
específica para seu armazenamento. Lembre-os de que é importante observar o prazo de validade antes de consumir um alimento e que, mesmo que o produto esteja dentro da validade, devem prestar atenção caso o alimento tenha coloração, gosto ou cheiro anormal. No entanto, muitas vezes, as crianças podem não saber o gosto e o cheiro normais de um alimento e consumir algo estragado. Portanto, oriente os estudantes a perguntarem a um adulto se os alimentos estão em boas condições.
• Para mais informações sobre como es-
BNCC
• Ao apresentar o aspecto da embalagem de um alimento contaminado por bactéria e a atitude de não o consumir, para evitar a contaminação, esta página contribui para o desenvolvimento da habilidade EF04CI08. A associação da formação dos gases e do estufamento da embalagem com o processo de decomposição realizado pelas bactérias também colabora para o desenvolvimento da habilidade EF04CI06
• Esclareça aos estudantes que o botulismo não é causado pela bactéria, e sim por uma toxina produzida por ela, que, mesmo em pequenas quantidades, pode causar sintomas graves. Leia mais informações sobre o botulismo no site a seguir.
• BOTULISMO. Ministério da Saúde. Disponível em: https://www.gov.br/saude/ pt-br/assuntos/saude-de -a-a-z/b/botulismo. Acesso em: 22 jul. 2025.
• Cozinhar os alimentos a uma temperatura de 80 °C por cerca de 30 minutos é suficiente para evitar o botulismo, pois as toxinas são destruídas quando expostas ao calor. Contudo, as bactérias são altamente resistentes, podendo sobreviver durante horas à temperatura de 100 °C Portanto, o cozimento do alimento garante segurança apenas para o consumo imediato.
01/10/2025 09:47:31
colher, conservar e armazenar alimentos, leia o texto a seguir.
• CUIDADOS com os alimentos. Disponível em: https://bvsms.saude.gov.br/ bvs/publicacoes/cuidado_alimentos.pdf. Acesso em: 22 jul. 2025.
Lata estufada.
• Complemente a atividade 11 dizendo aos estudantes que, por ser um alimento perecível, é muito importante deixar a carne o mínimo possível fora da geladeira. Explique-lhes que a redução da temperatura dos alimentos dificulta o desenvolvimento e crescimento de fungos e bactérias que podem tornar os alimentos inadequados para o consumo.
BNCC
• A seção prática trabalhada nessa e na próxima página permite o desenvolvimento da Competência geral 2 e das Competências específicas de Ciências da Natureza 2 e 3, pois leva os estudantes a realizarem um procedimento experimental prático para observar a ação de microrganismos, utilizando práticas e procedimentos de investigação científica para analisar, compreender e explicar características e fenômenos relativos ao mundo natural.
OBJETIVOS
• Compreender a importância do armazenamento adequado dos alimentos para atrasar o processo de decomposição deles pela ação de microrganismos decompositores da matéria orgânica.
• Identificar alguns fatores, como a temperatura e os nutrientes, que favorecem ou inibem o crescimento de bactérias e fungos nos alimentos.
Resposta a) Resposta pessoal. Espera-se que os estudantes respondam que alguns alimentos são armazenados em armários, em temperatura ambiente, enquanto outros precisam ser mantidos na geladeira, em temperatura mais baixa.
10. Qual é a importância da atitude que está sendo mostrada na fotografia?
Resposta: Essa atitude reduz as chances de o alimento ser contaminado por microrganismos. Além disso, a baixa temperatura dificulta o desenvolvimento dos seres vivos microscópicos que já estão no
alimento. Isso aumenta a durabilidade do
alimento e evita danos à saúde das pessoas que o consumirem.
11. Escreva no caderno as letras que representam alimentos que, necessariamente, devem ser conservados na geladeira. Pessoa colocando um alimento na geladeira.
Resposta: A, C e E.





VAMOS INVESTIGAR


a ) Em sua moradia, como são armazenados os alimentos para que eles sejam preservados por mais tempo?
MATERIAIS NECESSÁRIOS
• 3 copos descartáveis de 50 mL
• 1 xícara de chá de mingau de amido de milho
• Se os estudantes tiverem dificuldade em responder à questão a, pergunte se eles têm despensa em suas casas, local onde ficam os mantimentos e as reservas alimentares de uso doméstico. Pergunte também se na geladeira só são colocados alimentos abertos que estão sendo consumidos ou se também há mantimentos fechados, com a finalidade de armazenamento.
Resposta nas orientações ao professor.
• 1 colher de sopa
• filme plástico
• caneta marcador permanente
Imagens sem proporção entre si.
D. E. F.
Alface.
Pó de café.
Carne crua.
Açúcar.
Arroz cru.
Queijo fresco.
A.
B. C.
A.
B.
Enumere os copos plásticos de 1 a 3.
Coloque uma colher de sopa de mingau no interior de cada um dos copos.
Atenção: O mingau de amido deve ser preparado por um adulto.

Dica: Para preparar o mingau de amido de milho, peça a um adulto que, em uma panela, dissolva 2 colheres de sopa de amido de milho em 1 xícara de chá de água. Em seguida, o adulto deve levar a panela com a mistura ao fogo e mexê-la até que ela se torne espessa.
C.
D.
E.
Cubra os copos 2 e 3 com filme plástico.
Coloque os copos 1 e 2 sobre uma pia ou bancada do laboratório, mantendo-os em temperatura ambiente.
Leve o copo 3 para a geladeira. Mantenha os copos nos locais recomendados por cinco dias.

Copos com mingau, um aberto e outro fechado.

Copo com mingau armazenado dentro da geladeira.
Agora, responda às questões a seguir no caderno.
Respostas nas orientações ao professor
1. Desenhe o que você observou em cada um dos copos.
2. Em qual copo o mingau teve mais alteração? Por quê?
3. Em qual copo o mingau ficou mais conservado? Por quê?
perceberem e a documentarem diferenças nos alimentos submetidos a diferentes condições após os cinco dias. Espera-se que nos copos 1 e 2 eles observem a formação de colônias de fungos e bactérias.
2. Espera-se que os estudantes respondam que foi no copo 1: tratamento em que o mingau ficou em um recipiente aberto e em temperatura ambiente, facilitando a contaminação por fungos e bactérias. Explique-lhes que a falta de vedação permitiu o acesso dos microrganismos e que a temperatura ambiente está mais próxima
da temperatura ideal para o crescimento desses seres.
3. Espera-se que os estudantes respondam que foi no copo 3: tratamento em que o mingau ficou em um recipiente fechado e em temperatura baixa, o que contribuiu para conservar o alimento por mais tempo. Verifique se eles compreendem que os microrganismos não tiveram acesso ao conteúdo do copo e permaneceram em uma temperatura menos favorável para seu desenvolvimento.
• Na etapa B do procedimento, oriente os estudantes a solicitarem a um adulto que prepare o mingau de amido de milho. Depois de ter esfriado completamente, ele vai transferir o mingau para os copos.
• Na etapa C, questione os estudantes sobre a importância de cobrir os copos com plástico filme e verifique se comentam a respeito da contaminação que pode ocorrer em alimentos mantidos em recipientes abertos. Pergunte se eles acham que existem microrganismos no ar e, depois que responderem, diga que sim, e são milhares, presentes em diversos outros ambientes, como nos oceanos, nos solos e nos seres vivos.
• Caso os estudantes não mencionem, comente que cobrir pode ser uma medida importante para evitar que insetos, como moscas, entrem em contato com alimentos. Diga que elas podem carregar consigo vários microrganismos, inclusive causadores de doenças. Leia mais informações nesta indicação: MOSCAS podem transmitir muito mais doenças do que se imaginava. Sociedade Brasileira de Microbiologia , 11 dez. 2017. Disponível em: https://sbmicrobiologia. org.br/moscas-podem -transmitir-muito-mais -doencas-do-que-se -imaginava/. Acesso em: 22 jul. 2025.
Respostas
1. O objetivo desta atividade é levar os estudantes a
01/10/2025 09:47:42
BNCC
• A observação dos resultados obtidos pelos estudantes na atividade experimental desta página contribui com o desenvolvimento da habilidade EF04CI06, pois eles podem relacionar a participação de fungos e bactérias ao processo de decomposição.
Copos com mingau de amido de milho.
BNCC
• Ao abordar doenças de transmissão indireta causadas por protozoários, bem como medidas de prevenção dessas doenças, o conteúdo desta página contribui para o desenvolvimento da habilidade EF04CI08.
• Ao abordar a atividade 12, caso os estudantes tenham dificuldades em identificar as ações mostradas nas fotografias como maneiras de prevenção contra a malária e a leishmaniose, enfatize que essas doenças não são transmitidas de maneira direta, e sim indireta, pois ocorrem por meio da picada do mosquito-prego e do mosquito-palha, respectivamente. Portanto, pergunte a eles se, evitando a picada dos mosquitos transmissores dessas doenças, é possível preveni-las.
• Se julgar pertinente, comente com os estudantes que a vacinação para prevenção da malária já é uma realidade em outros países. Em alguns da África, a vacinação é recomendada para crianças pela Organização Mundial da Saúde desde o ano de 2021, com vacinas que atuam contra o protozoário causador da malária da espécie Plasmodium falciparum. No Brasil, pesquisadores têm buscado desenvolver uma vacina para a prevenção da doença que atue contra o Plasmodium vivax , responsável pela maior parte dos casos no país.
REFERÊNCIAS
COMPLEMENTARES
SANTOS, Teresa. Vacina contra malária em programas de vacinação na África. InVivo, 25 abr. 2024. Disponível em: https://www.invivo. fiocruz.br/saude/vacinas -contra-a-malaria-africa/. Acesso em: 22 jul. 2025. Leia nessa reportagem mais informações sobre as vacinas para a prevenção da malária.
A malária é uma doença antiga, mas ainda muito comum no Brasil, principalmente na região amazônica.
Ela é transmitida ao ser humano pela picada do mosquito do gênero Anopheles infectado com o protozoário causador da malária.
12. Resposta:
Mosquito transmissor da malária, popularmente conhecido como mosquito-prego. Espera-se que os estudantes comentem que passar repelente na pele evita a picada do mosquito e que instalar telas em portas e janelas dificulta o acesso do mosquito ao interior das residências.
Outra doença que afeta os humanos e é causada por protozoário é a leishmaniose.
A leishmaniose é transmitida ao ser humano pela picada de insetos chamados de flebotomíneos e popularmente conhecidos como mosquitos-palha.
Mosquito-prego: pode atingir cerca de 6 mm de comprimento.

Mosquito-palha: pode atingir cerca de 3 mm de comprimento.

12. Como as ações mostradas nas fotografias a seguir podem contribuir para a prevenção da malária e da leishmaniose?

Passar repelente na pele.

Instalar telas de proteção contra mosquitos em janelas e portas.
13. Escreva no caderno somente o nome das doenças que têm forma de transmissão semelhante à da malária e da leishmaniose.
• febre amarela
• chikungunya
• dengue
• zika
• COVID-19
• onicomicose
• gripe
• sarampo
Resposta: Febre amarela, chikungunya, dengue e zika, pois a transmissão também ocorre por meio da picada de um inseto.
• Se julgar adequado, esclareça aos estudantes que há mais de um tipo de leishmaniose. Na leishmaniose visceral, o protozoário causador da doença invade os órgãos internos da pessoa, causando sintomas como febre, falta de apetite, fraqueza e inchaço do abdome. Já na leishmaniose cutânea ou tegumentar, os protozoários causam principalmente lesões na pele e nas mucosas.
AVALIANDO
Objetivo
• Verificar se os estudantes conseguem reconhecer doenças de transmissão indireta que são transmitidas pela picada de insetos vetores.
Sugestão de intervenção
Se os estudantes tiverem dificuldade em responder à atividade 13, explique a eles que nenhuma outra doença apresentada na atividade é causada por protozoários, porém o tipo de microrganismo não define a forma de transmissão da doença. Diga que devem considerar apenas a forma como o microrganismo chega até o ser humano. Se necessário, ajude-os a se lembrarem do tipo de microrganismo causador e a forma de transmissão de cada uma dessas doenças.
Mosquito-palha.
A CIÊNCIA E A TECNOLOGIA A SERVIÇO
DA SAÚDE HUMANA
Apenas 48 horas depois de o primeiro caso de COVID-19 ter sido notificado no Brasil, em 2020, a pesquisadora Jaqueline Goes de Jesus (1989-), em conjunto com outros pesquisadores, havia mapeado o genoma do vírus causador da doença. Uma medida importante para entender a transmissão do vírus na população e para o desenvolvimento de vacinas.
Quando uma doença atinge pessoas do mundo todo, a resposta da comunidade científica deve ser acelerada, como foi o caso da pandemia de COVID-19. Os impactos da doença levaram cientistas de todo o mundo a unir esforços para compreender a ação do vírus e desenvolver vacinas.
Para desenvolver uma vacina, os cientistas precisam primeiro compreender o modo de ação do agente causador da doença e, então, realizar testes de eficácia. Depois, são feitas três fases de testes em seres humanos. Só após essas etapas a vacina é registrada para ser disponibilizada à população.

Genoma: parte de um organismo que contém as informações responsáveis por determinar algumas de suas características.
INFOGRÁFICO CLICÁVEL: PREVENÇÃO E CONTROLE DA COVID-19
Produção de vacina contra a COVID-19 na Fundação Oswaldo Cruz, na cidade do Rio de Janeiro, em 2021.
É por meio da pesquisa, científica e tecnológica, que os cientistas conseguem investigar as causas de uma doença, como ela se manifesta no organismo de um ser vivo e qual é o melhor tratamento.
No caso da COVID-19, por se tratar de uma pandemia, os governos investiram recursos em laboratórios para que os cientistas encontrassem uma maneira rápida e eficiente de combater o vírus e impedir sua propagação. a ) Converse com os colegas sobre a importância de valorizar a ciência.
Resposta pessoal. O objetivo desta atividade é levar os estudantes a refletirem sobre como a ciência é fundamental para promover a saúde e o bem-estar das pessoas.
elevada eficácia começaram a ser aplicadas. Os resultados foram muito positivos e acompanhados da redução no contágio e retorno das atividades sociais e econômicas que a pandemia havia restringido.
ATIVIDADE EXTRA
Promova com os estudantes a confecção de um mural abordando as cientistas estudadas ao longo desta unidade: Jaqueline Goes de Jesus (1989-), Johanna Döbereiner (1924-2000) e Mariangela Hungria da Cunha (1958-). Para isso, forneça papel kraft e canetas hidrográficas coloridas. Se
julgar interessante, imprima fotografias das cientistas e distribua aos estudantes para que as utilizem na confecção do mural. Para compor o mural, oriente-os a produzir textos informativos sobre o trabalho realizado por essas cientistas e a importância socioambiental das pesquisas desenvolvidas por elas.
Caso julgue pertinente, antes da produção do mural, leve os estudantes ao laboratório de informática ou à biblioteca da escola para que pesquisem outras informações sobre as cientistas. Eles podem pesquisar, por exemplo, onde as cientistas
• O conteúdo desta página contribui para o desenvolvimento das Competências específicas de Ciências da Natureza 1 e 4, uma vez que os estudantes podem compreender a Ciência como um empreendimento humano e constatar as soluções propostas aos desafios do mundo contemporâneo. Além disso, o texto aborda a importância da Ciência, o que contempla o tema contemporâneo transversal Ciência e tecnologia, além de valorizar a atuação do cientista nas pesquisas científicas, desenvolvendo o tema contemporâneo transversal Trabalho
• Após a leitura desta página, diga aos estudantes que as vacinas contra a COVID-19 foram as mais rápidas desenvolvidas na história. Até então, a vacina liberada mais rapidamente havia sido a da caxumba, que levou quatro anos para ser aplicada, em 1960. Esse tempo decorre principalmente pelo fato de que os protocolos de testes e aprovação são longos.
• Em uma situação excepcional, como a da COVID-19, alguns países mudaram as regras de registro e estabeleceram a aprovação emergencial, em que algumas etapas da avaliação são abreviadas, sem, contudo, afetar a segurança. A consequência é que em menos de um ano algumas vacinas de
01/10/2025 09:47:50
nasceram, onde estudaram na infância e na vida adulta, qual é a formação delas e prêmios ou homenagens que receberam em reconhecimento à importância de seus trabalhos. Se necessário, auxilie os estudantes a compreenderem os textos pesquisados e a incluí-los no mural. Exponha o material produzido para a comunidade escolar.
1. Objetivo
• Identificar algumas características de fungos, protozoários e bactérias.
Sugestão de intervenção
Caso os estudantes tenham dificuldade em realizar as associações, ressalte que as descrições apresentam algumas características únicas de cada tipo de microrganismo, como as doenças causadas. Se necessário, oriente-os a retomar os conteúdos sobre tétano (página 88), botulismo (página 89 ), micoses (página 76), doença de Chagas (página 79) e malária (página 92).
BNCC
• A atividade 2 contribui para o desenvolvimento da habilidade EF04CI07, pois os estudantes verificam a participação de um microrganismo na produção do leite fermentado.
2. Objetivos
• Identificar a participação de um microrganismo na produção de um alimento ao avaliarem o rótulo desse alimento.
• Reconhecer que microrganismos podem ser benéficos para o ser humano.
Sugestão de intervenção
Se os estudantes tiverem dificuldade em identificar o microrganismo no item a, diga a eles que a fermentação do leite é realizada por bactérias adicionadas ao longo da preparação do alimento. Comente também que esses microrganismos geralmente se mantêm vivos no alimento até o consumo e que, mesmo após a ingestão da bebida, muitos deles chegam vivos ao intestino.
Se os estudantes não conseguirem encontrar respostas para o item b, pergunte como fizeram a pesquisa e
Escreva as respostas no caderno.
VAMOS AVALIAR O APRENDIZADO
1. Mateus anotou no caderno algumas frases com características dos microrganismos.
2. b) Resposta: Espera-se que os estudantes citem que a bactéria é benéfica para o funcionamento do intestino.
1. 1. São formadas por apenas uma célula e podem constituir colônias. Podem causar doenças como botulismo e cólera.
2. 2. São formados por uma ou várias células. Crescem em locais úmidos e podem causar micoses.
3. 3. São formados por apenas uma célula. Locomovem-se por meio de cílios, flagelos ou pseudópodes. Podem causar doença de Chagas e malária.
No caderno, escreva a qual grupo de microrganismos, fungos, bactérias ou protozoários, correspondem as características anotadas nas frases 1, 2 e 3
Resposta: 1 – bactérias; 2 – fungos; 3 – protozoários.
2. Observe a imagem e responda às questões.
a ) Qual é o ser vivo microscópico presente no produto mostrado na imagem?
Resposta: Lactobacilos.
b ) Faça uma pesquisa e descubra qual benefício essa bactéria traz para o corpo humano.
c ) Com seus pais ou responsáveis, leiam o rótulo da embalagem dos alimentos que vocês têm na despensa de casa e verifiquem se algum deles apresenta bactérias ou fungos em sua composição.
Em caso afirmativo, que produto é esse?
Resposta pessoal. O objetivo desta atividade é levar os estudantes a ampliarem o
Leite fermentado.

conhecimento deles sobre a aplicação de bactérias e fungos. Eles podem encontrar microrganismos em fermentos biológicos, queijos, cogumelos etc.
verifique se utilizaram os termos corretos. Se necessário, leve-os ao laboratório de informática e oriente-os a pesquisar pelo nome da bactéria e por “leite fermentado”.
No item c, espera-se que, com o envolvimento dos responsáveis, os estudantes ampliem o conhecimento sobre as aplicações de bactérias e fungos. Eles podem encontrar microrganismos em fermentos biológicos, queijos e outros produtos.
3. Leia o trecho de reportagem a seguir.
4. a) Resposta: Por ser uma doença transmissível, ao espirrar protegendo o nariz com o antebraço, Daniela evita que as secreções contaminadas sejam lançadas no ambiente. Assim, a atitude dela ajuda a evitar que as pessoas ao redor sejam contaminadas com as secreções contaminadas e,
consequentemente, fiquem gripadas.
Em 2011, o pesquisador da Fiocruz, Luciano Moreira, iniciou uma série de discussões com o Ministério da Saúde (MS) para trazer uma nova alternativa para enfrentar a dengue: a introdução no ambiente de mosquitos Aedes aegypti carregando uma bactéria chamada Wolbachia [...].
[...] Em laboratório, a equipe de pesquisadores conseguiu introduzir esta bactéria, que foi retirada da mosca-da-fruta, dentro dos ovos de Aedes aegypti. Foi comprovado que, quando a bactéria está presente no mosquito, os vírus como o da dengue, zika e chikungunya não se desenvolvem bem, reduzindo a sua transmissão.
[...]
3. b) Resposta: A dengue, a zika e a chikungunya são doenças transmitidas pela picada do mosquito Aedes aegypti
MOREIRA, Luciano; VIEIRA, Alessandro; CHALEGRE, Diogo. Bactéria Wolbachia: a história do método que se fortalece no combate à dengue no Brasil. Fiocruz, 15 mar. 2024. Disponível em: https://portal. fiocruz.br/noticia/2024/03/bacteria-wolbachia-historia-do-metodo-que-se-fortalece-no-combate -dengue-no-brasil. Acesso em: 14 abr. 2025.
a ) As doenças citadas no texto são causadas por que tipo de microrganismo?
Resposta: A dengue, a zika e a chikungunya são doenças causadas por vírus.
b ) Qual é o agente transmissor das doenças citadas no texto?
c ) No caderno, produza um texto explicando como a bactéria Wolbachia é utilizada para combater essas doenças.
Resposta nas orientações ao professor
4. Daniela está gripada. Ao espirrar, ela coloca o antebraço em frente ao nariz, como mostra a imagem.
a ) Qual é a importância da atitude de Daniela ao espirrar?
b ) Você costuma ter atitudes semelhantes à de Daniela ao espirrar? Converse com os colegas sobre o assunto.
4. b) Resposta pessoal. O objetivo
Daniela espirrando.

desta questão é levar os estudantes a refletirem sobre as atitudes deles ao espirrar e como atitudes corretas podem evitar a transmissão de algumas doenças.
tão é verificar a capacidade de interpretação e compreensão de texto dos estudantes. Eles podem mencionar que, quando introduzida no mosquito Aedes aegypti, a bactéria prejudica os vírus causadores de dengue, zika e chikungunya, reduzindo a transmissão do vírus e, consequentemente, da quantidade de casos da doença.
4. Objetivo
• Compreender a importância do cuidado de evitar a disseminação de microrganismos ao espirrar.
Sugestão de intervenção
01/10/2025 09:47:53
Se os estudantes tiverem dificuldade em responder ao item a, pergunte a eles qual é o tipo de microrganismo que causa a gripe e qual é a maneira de transmissão: direta ou indireta. Sabendo que as secreções de uma pessoa gripada estão contaminadas com o vírus, espera-se que compreendam a importância de evitar que se espalhem.
Com base nas respostas dos estudantes ao item b, incentive-os a proteger o nariz e a boca quando forem espirrar como maneira de prevenir a transmissão de doenças.
BNCC
• A atividade 3 contribui para o desenvolvimento das habilidades EF04CI07 e EF04CI08, pois permite aos estudantes que verifiquem a participação de um microrganismo em uma estratégia tecnológica para o controle e a prevenção de doenças. A atividade 4, ao apresentar uma forma de prevenção para a transmissão da gripe, colabora para o desenvolvimento da habilidade EF04CI08.
3. Objetivo
• Identificar o tipo de microrganismo causador e o agente transmissor de dengue, zika e chikungunya, além de levá-los a conhecer uma aplicação tecnológica para controle de doenças envolvendo um microrganismo.
Sugestão de intervenção
No item a, caso os estudantes tenham dificuldade em identificar o microrganismo causador das doenças citadas, incentive-os a ler novamente o texto, buscando essa informação. Se necessário, enfatize que a bactéria citada não causa doenças em seres humanos. No item b, caso os estudantes não consigam responder qual é o agente transmissor da dengue, da zika e da chikungunya, oriente-os a ler novamente o conteúdo da página 82 e retome com eles, se necessário, a atividade 5 da página 83
Resposta 3. c) O objetivo desta ques-
BNCC
• A atividade 5 favorece o desenvolvimento da habilidade EF04CI08, pois incentiva os estudantes a associarem diversas medidas de prevenção às respectivas doenças. Já a atividade 6 contribui para o desenvolvimento da habilidade EF04CI07 , pois permite a eles que identifiquem a participação de um microrganismo na produção de alimentos e combustíveis.
5. Objetivo
• Reconhecer a maneira de transmissão e prevenção de algumas doenças.
Sugestão de intervenção
Se os estudantes não conseguirem classificar as doenças corretamente, peça a eles que identifiquem o tipo de microrganismo causador da doença e a maneira como sua transmis são ocorre. Verifique se identificam que sarampo, COVID-19, dengue e zika são doenças causadas por vírus; cólera, por uma bactéria; e onicomicose, por um fungo. Em seguida, solicite-lhes que reflitam sobre as maneiras de transmissão, ressaltando que nem todos os vírus identificados têm a mesma maneira de transmissão. Quanto às medidas de prevenção, lembre-os de que não precisam estar vinculadas diretamente ao microrganismo e podem também estar associadas ao agente transmissor dele.
6. Objetivo
• Compreender que alguns microrganismos são utilizados no preparo de alimentos e combustíveis.
Sugestão de intervenção
Caso os estudantes tenham dificuldade em responder ao item a, pergunte-lhes o que é necessário para que a levedura realize a fermentação no processo de produção do etanol e verifique se mencionam o açúcar da cana. Em seguida, pergunte também qual
5. No caderno, crie um quadro de duas colunas com os títulos: Transmissão direta e Transmissão indireta. Na sequência, classifique as doenças a seguir conforme a maneira de transmissão: direta ou indireta.
Resposta: Transmissão direta: sarampo e COVID-19; transmissão indireta: cólera, zika, dengue e onicomicose.
sarampo • COVID-19 • dengue cólera • zika • onicomise
a ) Agora, escreva na frente de cada doença listada no quadro a letra que representa sua maneira de prevenção. Imagens sem proporção entre si.

Pessoa limpando vaso de planta para evitar o acúmulo de água.

Pessoa secando os pés com toalha após o banho.
6. A levedura Sacharomyces cerevisiae é utilizada na fabricação de diversos produtos industriais.
a ) Crie um texto explicando a participação desse microrganismo na produção do combustível etanol. Utilize todas as palavras a seguir em seu texto.


Criança tomando água potável.
5. a) Resposta: Dengue e zika – A; onicomicose – B; sarampo, dengue e COVID-19 – C; cólera – D

Veículo sendo abastecido.
Resposta nas orientações ao professor
• levedura Sacharomyces cerevisiae
• cana-de-açúcar
• álcool
• gás carbônico
• açúcar
• fermentação
b ) Cite outro produto que utiliza a levedura Sacharomyces cerevisiae em sua produção.
Resposta: Os estudantes podem mencionar os pães que levam fermento contendo a levedura Sacharomyces cerevisiae em sua produção.
material é formado quando a levedura realiza a fermentação e verifique se citam o gás carbônico e o álcool.
No item b, se os estudantes tiverem dificuldade em se lembrar de outro produto com a participação da levedura Sacharomyces cerevisiae, pergunte qual ingrediente é utilizado no preparo do pão para que ele cresça e verifique se mencionam o fermento biológico. Em seguida, pergunte o que há no fermento biológico que faz a massa do pão crescer.
Se julgar necessário, oriente-os a ler novamente o conteúdo da página 73.
Resposta 6. a) Espera-se que os estudantes comentem que o combustível etanol é produzido pela fermentação da cana-de-açúcar e que esse processo é realizado pela levedura Sacharomyces cerevisiae. Na fermentação, a levedura utiliza o açúcar da cana e libera álcool e gás carbônico.
Pessoa tomando vacina.
A.
B.
C.
D.
7. a) Resposta nas orientações ao professor
7. Leia com seus pais ou responsáveis o cartaz a seguir.
7. c) Resposta nas orientações ao professor.

a ) Qual é a importância das campanhas de vacinação?
b ) Para que as vacinas sejam uma medida de prevenção efetiva para doenças como a poliomielite e o sarampo, a cobertura vacinal deve ser superior a 90%, ou seja, para cada 10 pessoas, 9 devem ter sido vacinadas. Explique como a baixa cobertura vacinal pode afetar a saúde de uma população.
c ) Produza um texto explicando a frase “Vacina é vida. Vacina é para todos”.
Cartaz do movimento nacional pela vacinação, Ministério da Saúde.
7. b) Resposta pessoal. Espera-se que os estudantes respondam que uma baixa
8. Leia a manchete a seguir.
cobertura vacinal pode levar doenças que antes eram controladas ou erradicadas em uma população, como o sarampo e a poliomielite, a retornarem.
Saúde recomenda uso
de máscara diante de sintomas gripais
LABOISSIÈRE, Paula. Saúde recomenda uso de máscara diante de sintomas gripais. Agência Brasil, 23 jun. 2023. Disponível em: https://agenciabrasil.ebc.com.br/saude/noticia/2023-06/ saude-recomenda-uso-de-mascara-diante-de-sintomas-gripais. Acesso em: 17 abr. 2025.
8. a) Resposta: Espera-se que os estudantes classifiquem a gripe como uma doença de transmissão direta.
a ) A gripe é uma doença de transmissão direta ou indireta?
Professor, professora: Comente com os estudantes que o termo saúde no texto diz respeito ao Ministério da Saúde.
b ) Explique como a medida citada na manchete pode contribuir para prevenir a doença.
Resposta: As máscaras podem barrar as secreções emitidas pela pessoa doente, ajudando a impedir que uma pessoa saudável entre em contato com as secreções de uma pessoa contaminada.
se quanto maior a quantidade de pessoas vacinadas menor a chance de uma doença que já havia sido controlada ou erradicada retornar a uma população. Depois verifique se incluem em seus textos a vacinação como uma medida de prevenção individual e coletiva.
Respostas
7. a) Resposta pessoal. Espera-se que os estudantes mencionem que as campanhas de vacinação podem ajudar a população a não esquecer de se vacinar, bem como se conscientizar da gravidade de
algumas doenças e a importância das vacinas nessa prevenção.
7. c) O objetivo desta questão é levar os estudantes a refletirem sobre a importância das vacinas como medida individual e coletiva de prevenção de doenças.
8. Objetivo
• Identificar o uso de máscara como medida preventiva para a gripe.
Sugestão de intervenção
Caso os estudantes tenham dificuldade em responder ao item a, pergunte a eles
BNCC
• A atividade 7 colabora com o desenvolvimento da habilidade EF04CI08, pois possibilita aos estudantes que reflitam sobre a importância da vacinação e a reconheçam como medida para prevenção de doenças. Além dela, a atividade 8 contempla a habilidade EF04CI08, ao permitir aos estudantes que identifiquem o uso de máscara como medida preventiva para a gripe.
7. Objetivo
• Reconhecer a importância das altas taxas de vacinação para a prevenção e o controle de doenças.
Sugestão de intervenção
Caso os estudantes tenham dificuldade em responder ao item a, pergunte se as campanhas de vacinação podem ajudar pais e responsáveis a se lembrarem de manter a caderneta de vacinação de seus filhos e dependentes atualizada, por exemplo. Caso julgue pertinente, retome o cartaz da campanha de vacinação da página 84 e identifique algumas informações, como a faixa etária do público-alvo e os dias destinados à vacinação contra o sarampo. No item b, retome com os estudantes o conteúdo da página 84 e relembre-os do aumento dos casos e mortes por sarampo no Brasil, entre 2018 e 2021, após a queda nas taxas de vacinação. No item c, pergunte a eles
01/10/2025 09:48:00
por que quando alguém está gripado deve cobrir o nariz com o antebraço ao espirrar. Verifique se eles respondem que essa medida evita que as secreções da pessoa doente, que contêm o vírus causador da gripe, atinjam quem estiver perto dela. No item b, após a identificação do modo de transmissão da gripe, verifique se eles mencionam que a máscara pode ser utilizada como uma barreira, evitando que as secreções da pessoa doente se espalhem pelo ambiente e possam atingir outras pessoas no local.
OBJETIVOS DA UNIDADE
• Compreender o que é saneamento básico.
• Conhecer os serviços públicos relacionados ao saneamento básico.
• Refletir sobre a importância do saneamento básico para a saúde.
• Conhecer as etapas do tratamento de água.
• Compreender a importância da ingestão de água potável.
• Compreender a importância da coleta e do tratamento de esgoto.
• Conhecer as etapas do tratamento de esgoto.
• Compreender a importância da coleta e da destinação adequada de resíduos sólidos.
• Refletir sobre as atitudes que contribuem para evitar a poluição do ambiente.
• Compreender o que são misturas.
• Identificar misturas em diferentes contextos do dia a dia.
• Identificar e classificar as misturas em homogêneas ou heterogêneas.
• Identificar substâncias que são dissolvidas em água.
• Conhecer substâncias insolúveis em água.
• Conhecer algumas técnicas de separação de misturas.
• Nesta unidade, serão trabalhadas com os estudantes a identificação de misturas no dia a dia e algumas características delas, bem como os serviços de saneamento básico e sua importância para a saúde.
• O tema 14 aborda os problemas relacionados à falta de saneamento básico e conduz os estudantes a perceberem a importância dos serviços de saneamento para a saúde e a qualidade de vida do ser humano.
• No tema 15, serão abordados o tratamento de água e suas etapas, e os
UNIDADE4 MISTURAS NO DIA A DIA

estudantes poderão perceber a importância do acesso à água tratada para a saúde das pessoas.
• Já no tema 16, eles perceberão que o esgoto necessita de tratamento para que possa ser lançado no ambiente sem poluí-lo. Além disso, serão abordadas algumas doenças relacionadas à falta de acesso aos serviços de saneamento básico.
• No tema 17, serão trabalhadas a poluição gerada pela destinação inadequada dos resíduos sólidos e a importância da separação, da coleta e do tratamento adequado aos diferentes tipos de resíduos.
• O tema 18 inicia a abordagem sobre as misturas apresentando aos estudantes o soro caseiro,
uma mistura utilizada para evitar a desidratação causada por diversas doenças relacionadas à falta de saneamento básico. Além disso, trata do conceito de misturas e da classificação delas em homogêneas ou heterogêneas.
• Já o tema 19 aborda as diferentes técnicas de separação de misturas e suas aplicações, além da observação de algumas dessas técnicas no cotidiano.
Pessoa lavando as mãos com água e sabão.
Tomar banho, escovar os dentes, dar descarga, lavar as mãos.
Todos os dias utilizamos a água para realizarmos diversas atividades. Depois disso, a água e alguns resíduos de nossas atividades diárias escoam pelo ralo e passam a compor o que é chamado de esgoto, uma mistura que, além da água, contém diversos componentes, como resíduos de produtos de higiene e de limpeza e dejetos humanos.
Respostas nas orientações ao professor
Qual é o destino da água após ela ser usada em nossas atividades diárias?
Em sua opinião, é possível separar a água dos demais componentes que formam o esgoto? Como? 1. 2. 3.
O que são misturas?

• Na questão 3, permita aos estudantes que exponham livremente seus pensamentos, propondo maneiras de separar a água dos demais componentes que formam o esgoto. Acolha as ideias deles e anote-as na lousa. Se julgar pertinente, execute algumas delas ou a atividade extra proposta a seguir.
ATIVIDADE EXTRA
Nesta prática, misture um pouco de solo em água. O solo representará a matéria orgânica presente no esgoto. Depois, pergunte aos estudantes se após algum tempo eles acham que será possível notar a separação do solo da água.
01/10/2025 09:50:58
O que será observado é a decantação, uma técnica de separação de misturas utilizada em uma das etapas do tratamento de esgoto, que será estudada nesta unidade.
Respostas
1. O objetivo desta questão é levantar os conhecimentos prévios dos estudantes sobre a coleta e o tratamento de esgoto.
2. O objetivo desta questão é levantar o conhecimento prévio dos estudantes sobre misturas. Espera-se que eles comentem que as misturas são formadas por dois ou mais materiais.
3. Resposta pessoal. O objetivo desta questão é levantar o conhecimento prévio dos estudantes sobre algumas das etapas do tratamento de esgoto e técnicas de separação de misturas utilizadas ao longo desse tratamento.
• Na questão 1, caso os estudantes respondam que, após ser usada nas atividades diárias, a água escoa pelo ralo, questione-os sobre o que acontece depois disso e verifique se comentam a coleta de esgoto e as estações de tratamento de esgoto. Eles ainda podem mencionar que o esgoto pode ser destinado às fossas sépticas, pois, em alguns locais, não há rede de coleta nem de tratamento de esgoto disponíveis. Caso algum estudante comente que essa água vai para os rios e lagos, o que infelizmente é uma realidade em algumas regiões do país, pergunte se isso pode causar danos ao ambiente e aos seres vivos, aproveitando para incentivar uma reflexão sobre a importância do tratamento de esgoto.
BNCC
• Este tema está relacionado à habilidade EF04CI08 e favorece o trabalho com o tema contemporâneo transversal Saúde, além de colaborar para o desenvolvimento da Competência geral 8 e da Competência específica de Ciências da Natureza 7, pois trata de atitudes para a prevenção de doenças e cuidados com o próprio corpo.
• O cartum apresentado contribui para desenvolver a Competência geral 4 e a Competência específica de Ciências da Natureza 6, pois incentiva os estudantes a interpretarem informações de recursos de diferentes linguagens. Além disso, as questões sobre esse cartum possibilitam desenvolver a Competência específica de Ciências da Natureza 3 ao analisarem a situação com base nos conhecimentos científicos.
ARTICULANDO CONHECIMENTOS
O recurso apresentado na página possibilita um trabalho integrado com o componente curricular de Língua Portuguesa, incentivando os estudantes a lerem e interpretarem um cartum. Explique-lhes que o cartum é um gênero textual caracterizado por apresentar críticas e provocar reflexões sobre temas atemporais e universais e pode ou não apresentar humor. Se julgar conveniente, peça-lhes que façam desenhos que se relacionem com o tema discutido no cartum. Diga-lhes que os cartuns podem apresentar somente imagens (linguagem não verbal) ou combinar as imagens com texto escrito (linguagem verbal).
• Se achar interessante, leve imagens de locais onde ocorre o descarte incorreto de resíduos sólidos e esgoto para mostrar os impactos ambientais dessa situação, como a poluição da água e do solo e a morte de seres
14 SANEAMENTO BÁSICO
Como você estudou, diversas substâncias resultantes de nossas atividades diárias são misturadas com a água. A retirada dessas substâncias da água envolve os serviços de saneamento básico. É esse assunto que vamos estudar a seguir.
1. Resposta: Porque há resíduos sólidos e esgoto sendo lançados diretamente no mar, próximo de onde ele e o pai estão. Esse ato pode resultar na contaminação da água do mar por microrganismos causadores de doenças.
Leia o cartum a seguir e responda às questões.

1. Por que o menino está com medo de adoecer?
2. Você já observou uma situação semelhante à apresentada no cartum? Converse sobre isso com os colegas.
nas orientações ao professor Resposta
ARIONAURO. Charge poluição, esgoto, praia. Arionauro Cartuns, 23 mar. 2020. Disponível em: http://www.arionaurocartuns. com.br/2020/03/charge-poluicao-esgoto -praia.html. Acesso em: 23 abr. 2025.
Os problemas retratados no cartum são o despejo irregular de esgoto no mar e o despejo inapropriado de resíduos sólidos. Esses problemas evidenciam a falta de saneamento em determinado lugar.
O saneamento é um conjunto de medidas que contribui para manter o ambiente em condições adequadas para prevenir doenças e melhorar a qualidade de vida das pessoas.
Como medidas consideradas essenciais, há o saneamento básico, que envolve os serviços de abastecimento de água tratada, coleta e tratamento de esgoto, limpeza urbana e coleta de resíduos sólidos.

vivos. Questione como isso pode afetar os seres humanos que vivem em locais onde ocorre o descarte incorreto de resíduos sólidos e esgoto. Eles podem citar que isso pode causar a proliferação de organismos causadores de doenças ou de seres vivos associados à transmissão delas, além de dificultar o acesso à água.
Resposta
2. Resposta pessoal. O objetivo desta questão é levar os estudantes a compartilharem com os colegas suas observações e vivências acerca do lançamento de esgoto e de resíduos sólidos de forma inadequada.

Profissional realizando a limpeza de uma calçada na cidade de Joinville, em Santa Catarina, em 2025.
Pessoa lavando louça.
3. Resposta: O objetivo desta questão é levantar os conhecimentos prévios dos estudantes sobre a relação entre o saneamento básico e a prevenção de doenças.
Leia a manchete e o trecho de reportagem a seguir.
Falta de saneamento adequado sobrecarrega sistema de saúde
Foram mais de 340 mil internações e 11,5 mil mortes em 2024
[...] a universalização do saneamento básico no país reduziria em mais de 86 mil o número de internações por doenças como dengue, hepatite, malária e leptospirose.
[...]
4. Possíveis respostas: Manter tampados os recipientes que podem acumular água, como caixas-d’água, ou mantê-los armazenados em locais que não fiquem expostos à chuva; usar repelentes e mosquiteiros; manter os vasos de plantas com areia, entre outras medidas.
LUZ, Solimar. Falta de saneamento adequado sobrecarrega sistema de saúde. Rádio Agência, 19 mar. 2025. Disponível em: https://agenciabrasil.ebc.com.br/radioagencia-nacional/saude/audio/2025-03/falta-de-saneamento -adequado-sobrecarrega-sistema-de-saude115. Acesso em: 23 abr. 2025.
3. Por que o acesso ao saneamento básico de qualidade ajudaria a evitar internações?
Como citado no trecho da reportagem, as condições inadequadas de saneamento e a falta de saneamento básico podem causar algumas doenças nas pessoas.
Entre as doenças relacionadas à falta de saneamento, podemos citar a cólera, a hepatite A e algumas verminoses. Os seres que causam essas doenças podem ser adquiridos quando o ser humano bebe água sem tratamento.

Além disso, é preciso lembrar que alguns mosquitos transmissores de doenças, como o Aedes aegypti, dependem da água para se reproduzir.
Na falta de acesso ao serviço de abastecimento de água, a população, muitas vezes, acumula água em reservatórios para suas atividades diárias. Isso pode contribuir para a proliferação de mosquitos transmissores de doenças, caso a água não seja armazenada de maneira adequada. Além disso, quando não há coleta de resíduos sólidos, esses resíduos podem se acumular em locais inadequados e se tornar possíveis criadouros desses insetos.
4. Cite duas medidas de prevenção contra a transmissão do vírus da dengue.
• Leptospirose: Pode causar sintomas como febre alta, dores de cabeça, dores musculares, especialmente na panturrilha, calafrios e, em casos graves, icterícia e problemas renais.
• Ao abordar a dengue, verifique se os estudantes se recordam que ela é transmitida principalmente pela picada da fêmea do mosquito Aedes aegypti contaminada com o vírus causador da doença. Se julgar necessário, retome o ciclo de
01/10/2025 09:51:04
vida do mosquito trabalhado na unidade 3 deste volume.
• Ao abordar a relação entre a falta de acesso a serviços de tratamento de água e a proliferação de mosquitos transmissores da dengue, enfatize que a prática de armazenar água em reservatórios, como cisternas e caixas-d’água, é sustentável e ajuda a economizar o recurso natural. No entanto, é importante manter os reservatórios fechados para evitar que mosquitos transmissores de doenças se proliferem nele.
• Caso os estudantes tenham dificuldade em responder à questão 3, retome o conteúdo sobre a cólera, doença que ocorre quando o ser humano ingere água ou alimentos contaminados com a bactéria que a causa. Peça, então, que eles retomem a questão e verifique se mencionam que, com o saneamento básico adequado, as pessoas têm menos chance de se exporem a microrganismos que podem causar doenças associadas à água sem tratamento, por exemplo.
• Ao trabalhar o trecho de reportagem, apresente os sintomas causados pelas doenças mencionadas no texto.
• Dengue: Geralmente, é caracterizada por febre alta e dores musculares, articulares, de cabeça e atrás dos olhos, além de possíveis manchas vermelhas na pele.
• Hepatite: A hepatite A, uma das hepatites cuja transmissão está relacionada a condições inadequadas de saneamento básico, pode causar fadiga, febre, dores abdominais, urina escura e icterícia (pele e olhos amarelados).
• Malária: Geralmente, causa febre alta, calafrios, dores de cabeça, dores musculares e fadiga, podendo evoluir para complicações graves.
Criança bebendo água filtrada.
FERNANDO FAVORETTO/CRIAR IMAGEM
BNCC
• A atividade dessa seção contribui para desenvolver as Competências gerais 2 e 9 e as Competências específicas de Ciências da Natureza 2 e 8, pois os estudantes exercitam a curiosidade para investigar como retirar, por filtração, componentes misturados à água e agir em prol da saúde individual e coletiva. Além disso, a atividade propõe o trabalho em grupo, colaborando para que pratiquem a cooperação, o diálogo e o respeito aos colegas.
OBJETIVOS
• Reconhecer a importância da filtração na remoção de impurezas da água.
• Reconhecer a técnica de filtração como uma forma de tratamento de água caseiro.
• Estabelecer um paralelo entre o tratamento de água nas ETA e o tratamento de água caseiro.
• Na etapa B, enfatize que o corte da garrafa deve ser realizado por um adulto.
• Auxilie os estudantes na montagem do aparato experimental, respondendo aos questionamentos que surgirem. Aproveite o momento e questione se a ordem de disposição dos materiais poderia afetar o resultado da filtração. Ressalte que manter a ordem exata dos materiais é essencial para que cada camada retenha partículas cada vez menores que estiverem na água.
Respostas
a) Resposta pessoal. O objetivo da questão inicial dessa página é levar os estudantes a refletirem sobre as etapas do tratamento dado à água para que ela se torne apropriada ao consumo humano.
b) Resposta pessoal. Os estudantes podem citar a construção de um filtro, que contribui para separar algumas impurezas da água.
15 TRATAMENTO DA ÁGUA
VAMOS INVESTIGAR
a ) Como você acha que a água é tratada antes de chegar à sua casa? Em sua opinião, é um processo simples ou envolve várias etapas?
b ) Você considera possível separar impurezas da água utilizando materiais simples? De que maneira?
MATERIAIS NECESSÁRIOS
• 2 garrafas plásticas (PET) de 2,5 L
• tesoura com pontas arredondadas
• pequenas rochas
• carvão vegetal moído
A.
B. C. D.
Junte-se a três colegas e formem um grupo.
Em seguida, peçam a um adulto que corte uma garrafa PET ao meio.
Encaixem a parte superior da garrafa na base, formando um funil. Tampem a abertura do funil com o algodão. Sobre ele, coloquem uma camada de carvão vegetal moído, areia e pequenas rochas, nessa ordem.
Dica: Cada camada do filtro deve ter aproximadamente dois dedos de espessura.
Respostas nas orientações ao professor
• algodão
• areia
• água (1 L)
• solo

pequenas rochas
areia algodão
Filtro com camadas de carvão vegetal moído, areia e pequenas rochas. carvão vegetal
E.
Na outra garrafa PET, coloquem um pouco de solo e adicionem água até completar metade da capacidade da garrafa. Tampem-na e agitem a mistura.
F.
G.
H. I.
Agora, despejem a mistura de água e solo dentro do funil. Esperem alguns segundos até que comece a escorrer. Anotem suas observações no caderno.
Passem a mistura novamente pelo filtro. Anotem suas observações no caderno.
Passem a mistura uma terceira vez pelo filtro e registrem suas observações.

Respostas nas orientações ao professor
Agora, responda às questões a seguir no caderno.
Atenção: Lembre-se: não consuma a água filtrada nesta atividade. Ela representa apenas uma parte do processo de tratamento da água.
1. Qual era o aspecto da água após passar pelo filtro pela primeira vez?
2. E qual era o aspecto da água após passar outras vezes pelo filtro?
3. Por que, apesar do aspecto, ainda não é possível beber essa água?
4. Como você explica a mudança na água após ela passar pela primeira filtração?
5. Você considera que as camadas no filtro contribuíram para os resultados? Converse sobre isso com os colegas.
6. A filtração é uma das etapas do tratamento da água. Em sua opinião, como a filtração pode ajudar no tratamento da água?
01/10/2025 09:51:05
• Antes que os estudantes despejem a mistura de água e solo dentro do funil na etapa F, pergunte a eles o que acham que vai acontecer quando realizarem essa ação, com o objetivo de incentivar o levantamento de hipóteses. Permita que exponham seus pensamentos e verifique se mencionam que a água ficará mais limpa, pois partículas do solo serão retidas no filtro.
• Enfatize que, apesar de a água barrenta ter passado pelo filtro e se tornado mais límpida, ela é imprópria para o consumo, pois pode conter outras impurezas e seres vivos causadores de doenças que não são visíveis a olho nu. Comente que, para a água que eles filtraram na atividade se tornar potável, ela ainda precisaria passar por outras etapas de tratamento, além da filtração.
Respostas
1. A água continuou com terra, porém saiu mais limpa.
2. A água estava aparentemente mais limpa do que na primeira filtração. Espera-se que os estudantes percebam que, a cada vez que a água passava pelo filtro, ela se tornava mais limpa.
3. Não é possível beber essa água, pois ainda pode conter seres microscópicos capazes de causar doenças, que atravessaram as camadas do filtro.
4. Espera-se que os estudantes concluam que parte das partículas de solo ficou retida no filtro.
5. Resposta pessoal. Espera-se que os estudantes percebam que cada etapa ajudou a reter parte das partículas de solo que estavam misturadas à água.
6. Resposta pessoal. Espera-se que os estudantes mencionem que a filtração ajuda a reter partículas, o que pode tornar a água mais limpa.
Pessoa despejando a mistura de água e solo no funil.
• Ao trabalhar as estações de tratamento de água (ETA), leia as etapas seguindo a ordem da numeração para que os estudantes entendam todos os processos envolvidos no tratamento da água.
• Comente que nas etapas do tratamento de água são utilizadas diferentes técnicas de separação de misturas, como floculação, decantação e filtração. Essas técnicas servem para separar as impurezas sólidas da água, porém ela só se torna própria para o consumo humano após sua desinfecção, ou seja, após o tratamento para a eliminação de microrganismos causadores de doenças.
• Ressalte a importância de evitar a contaminação dos corpos de água, como rios, córregos, lagos e represas, pois são deles que as estações de tratamento retiram água. Comente que a poluição prejudica também as pessoas que não têm acesso à rede de distribuição de água tratada, retirando água diretamente dos corpos de água.
AVALIANDO
Objetivos
• Conhecer as etapas do tratamento de água.
• Compreender a importância da ingestão de água potável.
• Reconhecer o acesso à água tratada como um direito de todos.
Sugestão de intervenção
Desenhe na lousa um esquema simplificado de uma estação de tratamento de água e escreva os nomes das etapas, deixando espaços para que os estudantes escrevam informações sobre cada uma delas. Em seguida, peça-lhes que, com o livro fechado, conversem sobre a função e a importância de cada etapa e, após uma conclusão,
A água que utilizamos em nossas residências geralmente provém de rios ou reservas de água subterrânea. Como essa água pode conter agentes causadores de doenças e materiais que prejudicam nossa saúde, antes de ser encaminhada à população, ela precisa passar por um tratamento. As etapas desse processo ocorrem nas estações de tratamento de água (ETAs). Acompanhe o esquema a seguir.
Estação de tratamento de água
Imagem com elementos sem proporção entre si. Cores fantasia.

Representação de uma estação de tratamento de água.
Captação: a água captada dos rios é encaminhada à estação de tratamento de água.
Adição de produtos químicos: a água é armazenada em um tanque no qual são adicionados produtos químicos, como cloro, cal e sulfato de alumínio. Esses produtos eliminam diversos agentes causadores de doenças e preparam a água para a próxima etapa.
Floculação: no tanque de floculação, as partículas e impurezas presentes na água juntam-se umas às outras, formando flocos.
Decantação: os flocos formados na etapa anterior se depositam no fundo do tanque.
Filtração: a água passa por um filtro com carvão, areia e pequenas rochas para remover as impurezas.
Desinfecção e fluoretação: a água recebe novamente cloro e flúor. O cloro ajuda a eliminar agentes causadores de doenças e o flúor atua na prevenção da cárie dentária.
Reservatório: a água é armazenada em reservatórios antes da distribuição.
Distribuição: a água é distribuída às residências, às indústrias e aos estabelecimentos comerciais.
escrevam essas informações na lousa, completando o esquema. Depois, oriente-os a pesquisar em livros e na internet, sob a supervisão dos pais ou responsáveis, doenças relacionadas à ingestão de água contaminada. Se julgar pertinente, leve-os ao laboratório de informática ou à biblioteca da escola para que realizem a pesquisa. Incentive-os a pesquisar informações relacionadas à transmissão, aos sintomas e ao tratamento de cada doença. Após apresentá-las, peça que expliquem a importância das estações de tratamento de água.
Fonte de pesquisa: GAUTO, Marcelo Antunes; ROSA, Gilber Ricardo. Processos e operações unitárias da indústria química. Rio de Janeiro: Ciência Moderna, 2011. p. 19.
1. Qual é a etapa do tratamento de água retratada na imagem?
Resposta: Floculação.
2. Qual é a etapa seguinte do tratamento de água?
Resposta: Decantação.
3. Relacione o que acontece na etapa mostrada na imagem à etapa seguinte.
Imagem com elementos sem proporção entre si. Cores fantasia.
Representação de uma etapa de tratamento da água em uma ETA.
3. Resposta nas orientações ao professor.
Após o tratamento, a água é distribuída à população por meio de tubulações.
Nas residências, a água pode ser armazenada em um recipiente denominado caixa-d’água.
As caixas-d’água devem ser mantidas tampadas e precisam ser limpas periodicamente para poder armazenar água com segurança.
Caixa-d’água tampada no telhado de uma residência, no município de Marília, em São Paulo, em 2022.


A água que chega às residências, apesar de ter passado pelo tratamento, não deve ser consumida diretamente da torneira. Durante o transporte e o armazenamento, a água pode adquirir componentes que prejudicam a saúde. Dessa maneira, é fundamental fazer o tratamento caseiro da água antes de ingeri-la.
Uma das maneiras de tornar a água potável, isto é, própria para o consumo, é fervê-la.
Outras maneiras são a filtração e a adição de hipoclorito de sódio. Ambos os processos visam à eliminação de microrganismos causadores de doenças.

4. Em sua moradia, você e sua família costumam fazer algum tipo de tratamento caseiro com a água que consomem? Comente esse assunto com os colegas.
Resposta nas orientações ao professor
01/10/2025 09:51:12
• Ao trabalhar o armazenamento da água em caixas-d’água nas residências, questione os estudantes sobre o motivo de esses reservatórios precisarem ser limpos periodicamente e mantidos fechados. Verifique se eles se lembram que manter as caixas-d’água bem fechadas é uma medida que evita a proliferação do mosquito Aedes aegypti , transmissor da dengue, Zika, chikungunya e febre amarela.
• Explique aos estudantes que tampar as caixas-d’água impede também que animais que podem transmitir doenças, como ratos, baratas e morcegos entrem em contato com a água. Já a limpeza e a desinfecção periódica desses reservatórios ajudam a eliminar microrganismos causadores de doença.
• Explique a eles que, para tornar a água de torneira potável, devem ser adicionadas duas gotas de solução de hipoclorito de sódio (2,5%) para cada litro de água e aguardar cerca de 15 minutos. Essa substância também pode ser utilizada na desinfecção da água usada no preparo de alimentos, além da desinfecção das caixas-d’água.
Respostas
3. Espera-se que os estudantes respondam que, no tanque de floculação, as partículas e impurezas presentes na água juntam-se umas às outras, formando flocos. Esses flocos se depositam no fundo do tanque durante a etapa de decantação.
4. Resposta pessoal. O objetivo desta questão é incentivar os estudantes a fazerem uma avaliação da qualidade da água que consomem e identificarem a possível necessidade de ações para realizar um tratamento caseiro, como usar filtros ou ferver a água antes de usá-la.
• Ao trabalhar a questão 4, enfatize a importância de realizar tratamentos caseiros da água antes de consumi-la. Comente que a água deve ser tratada para beber e para preparar alimentos.
BNCC
• A questão 4 proporciona o desenvolvimento da Competência específica de Ciências da Natureza 7, pois permite aos estudantes que apresentem formas de cuidar de si com base em conhecimentos dessa área. A abordagem sobre a manutenção adequada das caixas-d’água favorece o trabalho com a habilidade EF04CI08 ao possibilitar aos estudantes que reconheçam atitudes e medidas que colaboram para a prevenção de doenças.
Chaleira com água fervendo.
• No item a da questão 5, incentive os estudantes a refletirem sobre os riscos da contaminação da água durante as enchentes. Explique que nessas situações a água pode ser contaminada por microrganismos causadores de doenças e que a ingestão dessa água aumenta o risco de doenças como a hepatite A e a toxoplasmose.
• No item b, incentive os estudantes a refletirem sobre a importância da água potável para a saúde pública. Leve-os a reconhecer que o acesso ao recurso é fundamental para a prevenção de doenças.
• No item c, explique aos estudantes que mesmo alimentos embalados em, por exemplo, caixas longa vida, garrafas e sacos, mas que não são vedados não devem ser consumidos. Mesmo que aparentem estar secos, a água da enchente pode ter entrado nesses recipientes. Ressalte que o consumo desses alimentos pode provocar doenças.
• Comente que o contato direto com a água e a lama das enchentes também favorece a ocorrência de doenças, sendo um exemplo a leptospirose. Caso julgue interessante, aproveite essa abordagem e oriente a turma a realizar a atividade 3 da página 110 sobre essa doença.
• Se julgar pertinente, comente com os estudantes que, em situações de enchente, após a autorização dos órgãos competentes, a limpeza e a desinfecção das áreas e dos objetos atingidos pela água são necessárias para diminuir o risco de doenças. Caso julgue relevante, acesse com os estudantes o fôlder divulgado pelo Governo Federal indicado a seguir e comente algumas etapas de limpeza e desinfecção da caixa-d’água relacionadas à prevenção de doenças, como o uso de
5. Leia a manchete e o trecho de reportagem a seguir.
Saúde alerta para cuidados pós-enchente no Rio Grande do Sul
[...]
5. a) Resposta: Espera-se que os estudantes comentem que, durante as enchentes, pode haver a contaminação da água e que a água contaminada pode favorecer a transmissão de doenças.
A água contaminada, de acordo com o ministério, é um dos principais riscos após enchentes. [...]
“Não consuma alimentos que tenham tido contato com a água da inundação ou lama, incluindo alimentos embalados, enlatados ou alimentos perecíveis (como frutas, legumes e verduras). Antes de beber, é essencial adotar medidas para tornar a água segura para consumo.”
Professor, professora: Comente com os estudantes que a palavra saúde na manchete se refere ao Ministério da Saúde. 5. b) Resposta: Espera-se que os estudantes citem a filtragem da água, seguida da fervura da água ou a adição de hipoclorito de sódio.
LABOISSIÈRE, Paula. Saúde alerta para cuidados pós-enchente no Rio Grande do Sul. Agência Brasil, 20 maio 2024. Disponível em: https://agenciabrasil.ebc.com.br/saude/noticia/2024-05/saude-alerta-para-cuidados-pos -enchente-no-rio-grande-do-sul. Acesso em: 28 abr. 2025.
a ) Por que, durante as enchentes, deve-se ter cuidado com a água consumida?
b ) Nesses casos, quais medidas podem ser tomadas para que a água possa ser consumida com mais segurança?
c ) Por que os alimentos que tiveram contato com a água da inundação não devem ser consumidos?
No Brasil, milhares de pessoas ainda não têm acesso à água tratada. Nesses casos, a água utilizada nas tarefas do dia a dia é obtida diretamente de rios, lagos e poços. Por isso, essa água deve passar obrigatoriamente pelo tratamento caseiro antes de ser consumida.
Em algumas comunidades, a água das chuvas fica armazenada em recipientes chamados cisternas.
A cisterna é essencial em locais em que a água é escassa.
A água armazenada nela é utilizada em atividades como limpeza, irrigação de hortas e lavagem de calçadas e quintais, evitando o uso de água tratada.
Cisterna em uma residência no município de Nova Redenção, na Bahia, em 2021. 5. c) Resposta: Espera-se que os estudantes comentem que a água da inundação pode

conter microrganismos ou outros agentes causadores de doenças e que, portanto, os alimentos que tiveram contato com essa água também podem estar contaminados.
equipamentos de proteção individual: BRASIL. Ministério da Saúde. Limpeza e desinfecção de caixa-d’água e reservatórios de água pós-enchente. Disponível em: https://www.gov.br/saude/pt-br/centrais-de-conteudo/publicacoes/ svsa/enchentes/folder-limpeza-de-caixa-dagua.pdf. Acesso em: 23 jul. 2025.
BNCC
• A questão 5 possibilita o desenvolvimento da habilidade EF04CI08 ao trabalhar medidas para prevenção de doenças causadas por microrganismos em situações de enchentes.
• Ao abordar a falta de acesso à água tratada, comente que, de acordo com a Organização Mundial de Saúde (OMS) e o Fundo das Nações Unidas para a Infância (Unicef), em 2022, cerca de 2,2 bilhões de pessoas em todo o mundo não tinham acesso à água potável gerenciada com segurança, ou seja, água disponível quando necessária, livre de contaminação de fezes e de produtos químicos. Ressalte que, em razão da falta de acesso à água de qualidade, milhares de pessoas, principalmente crianças, morrem todos os anos por conta de doenças causadas pelo consumo de água não tratada.
A CIÊNCIA E ALTERNATIVAS PARA O TRATAMENTO DA ÁGUA
Leia o trecho de reportagem a seguir.
[...]
a) Resposta pessoal. Espera-se que os estudantes comentem que
pesquisas científicas que buscam o desenvolvimento de tecnologias alternativas para o tratamento de água são importantes para tornar a água potável um recurso acessível a toda a população.
Encontrar uma solução sustentável para a reutilização de águas e aumentar o acesso à água potável, principalmente no Nordeste. Essas foram as motivações de pesquisadores da Universidade Federal do Rio Grande do Norte (UFRN) para criar um novo coagulante, feito a partir da casca de caju, para o tratamento de águas turvas e barrentas como as de represas, poços e rios.
[...] “o coagulante, em pó, age como ligante capturando as sujeiras, formando flocos maiores, passíveis de filtragem”. [...]
UFRN cria solução sustentável para o tratamento de água. Gov.br, 9 maio 2022. Disponível em: https://www.gov.br/capes/pt-br/assuntos/noticias/ufrn-cria-solucao-sustentavel-para-o-tratamento-de-agua. Acesso em: 6 maio 2025.
a ) Qual é a importância de pesquisas científicas como a citada no texto?
Para garantir o acesso à água potável para todos, pesquisas científicas que buscam desenvolver tecnologias para melhorar a eficiência do tratamento da água e tornar esse recurso acessível a toda a população são fundamentais. Diversas dessas tecnologias estão em estudo.
Cientistas pesquisando alternativas para o uso do cloro no tratamento de água.

Um exemplo são as pesquisas sobre novos materiais que possam ser utilizados na construção de membranas para a filtração da água. Essas membranas apresentam elevada eficiência na remoção de contaminantes na água.
Tecnologias para eliminar os microrganismos da água, como o uso do ozônio e da radiação ultravioleta, são estudadas e já são empregadas no tratamento de água de modo alternativo ou complementar ao tratamento com cloro.
Outras iniciativas, como a distribuição de filtros portáteis, tornam a água potável um recurso acessível a comunidades que vivem afastadas da área urbana.
Membranas: barreiras que separam dois meios e não permitem a passagem de determinados materiais de um meio ao outro.
utilizando termos como filtros portáteis, purificadores portáteis, sachês para tratamento de água e comunidades
Após a leitura das reportagens, oriente os estudantes a trocarem informações sobre os textos pesquisados, comentando as tecnologias citadas e as melhorias na vida das comunidades proporcionadas pelo acesso à água potável.
Ao final, incentive-os a elaborar uma conclusão sobre a importância do acesso à água potável. Para isso, escreva na lousa a seguinte frase: “O acesso à água potável é um direito essencial, fundamental à vida
e à dignidade humana, pois...” e solicite que a completem. Permita que se expressem livremente, engajando-se na construção de uma conclusão sobre o tema, e anote as respostas na lousa. Verifique se eles comentam a importância desse recurso para a saúde e para a realização de diversas atividades do cotidiano, associadas a uma melhor qualidade de vida.
REFERÊNCIAS COMPLEMENTARES
BAPTISTA, Andressa Camargo; OLIVEIRA, Matheus Pereira de; ALMEIDA, Ronei
BNCC
• O conteúdo dessa página permite o trabalho com os temas contemporâneos transversais Educação em direitos humanos e Ciência e tecnologia ao apresentar soluções que facilitam o acesso à água potável e a tecnologias que tornam o tratamento da água mais eficiente. Além disso, contribui para desenvolver a Competência específica de Ciências da Natureza 4 ao incentivar a turma a analisar as implicações sociais da ciência e da tecnologia.
• Ao abordar o trecho de reportagem, trabalhe a ação do coagulante feito com base na casca de caju associando-a às etapas de tratamento de água nas estações de tratamento. Pergunte aos estudantes em qual dessas etapas o coagulante citado no texto poderia ser utilizado. Verifique se eles mencionam a etapa de floculação.
• Incentive-os a refletir sobre o papel da Ciência na melhoria da qualidade de vida da população. Se julgar pertinente, realize a atividade extra proposta a seguir.
ATIVIDADE EXTRA
Leve os estudantes ao laboratório de informática da escola e peça a eles que pesquisem reportagens sobre comunidades que tiveram o acesso a água potável facilitado por tecnologias para tratar a água. Oriente-os a realizar a pesquisa em sites de busca
01/10/2025 09:51:15
de. Panorama da aplicação de membrana de ultrafiltração e nanofiltração na produção de água para abastecimento público. In: CONGRESSO BRASILEIRO DE ENGENHARIA SANITÁRIA E AMBIENTAL, 33., 2025, Brasília. Anais... Brasília: Fitabes, 2025. Disponível em: https:// abes-dn.org.br/anaiseletronicos/33cbesa/616_tema_i.pdf. Acesso em: 24 jul. 2025.
Esse texto aborda o uso de membranas de ultrafiltração e nanofiltração no tratamento de água.
BNCC
• O tema sobre tratamento de esgoto permite o desenvolvimento dos temas contemporâneos transversais Educação em direitos humanos, Saúde e Educação ambiental ao levar os estudantes a compreenderem que o esgoto tratado contribui para evitar a poluição do meio ambiente e a ocorrência de doenças. Nesse contexto, podem ser trabalhadas as Competências específicas de Ciências da Natureza 4, 6 e 7 e a habilidade EF04CI08, pois eles devem avaliar aplicações socioambientais da Ciência utilizando diferentes linguagens e propor medidas para cuidar de sua saúde.
SUGESTÃO DE ESTRATÉGIA INICIAL
Reproduza o quadro a seguir na lousa.
AfirmaçãoConcordo Não concordo
Na coluna “Afirmação”, anote frases corretas e incorretas relacionadas ao tema (confira sugestões a seguir). Leia-as para os estudantes, uma a uma, e solicite a eles que troquem ideias sobre elas, comentando se concordam ou discordam de cada uma delas. Oriente-os a justificar o posicionamento adotado. Após a discussão, peça-lhes que levantem a mão de acordo com o posicionamento deles para cada frase. Anote as respostas na lousa nas respectivas colunas do quadro. Ao término do estudo do tema, retome o quadro e colete novamente as respostas dos estudantes. Caso mudem de posicionamentos, peça-lhes que argumentem o motivo dessa mudança. Sugestões de frases: • O tratamento do esgoto pode prevenir a dissemina-
1. Resposta pessoal. O objetivo desta questão é levar os estudantes a identificarem as condições de saneamento do local onde moram.
16
TRATAMENTO
DE ESGOTO
2. Resposta pessoal. O objetivo desta atividade é levar os estudantes a esquematizarem o que pensam ser o destino do esgoto.
1. Para onde a água usada de sua residência segue após o uso?
2. Faça um desenho mostrando o que você acha que acontece com a água após ser usada. Mostre seu desenho aos colegas.
Utilizamos água em diversas atividades em nossas residências, como para lavar louças e roupas ou para a limpeza das mãos e das superfícies. Também utilizamos água no banho e na descarga. Como você estudou, a água utilizada, associada a resíduos de sabão, detergente, sabonete e dejetos humanos, forma o esgoto.

Pessoa lavando louça.
O esgoto deve ser tratado em uma estação de tratamento de esgoto (ETE). Confira a seguir as etapas do tratamento de esgoto.
Estação de tratamento de esgoto
Imagem com elementos sem proporção entre si. Cores fantasia.

Representação de uma estação de tratamento de esgoto.
ção de doenças como as adquiridas pela ingestão de água e alimentos contaminados.
• As fossas sépticas são unidades de tratamento de esgoto que podem ser instaladas em residências.
• As fossas sépticas representam uma opção de tratamento de esgoto mais adequado para o meio ambiente do que aquele realizado nas estações de tratamento de esgoto.
• Caso os estudantes tenham dificuldades em se posicionar, incentive-os a expor as dúvidas e converse com eles a respeito delas.
• Ao trabalhar essa página, comente com eles que, de acordo com a Assembleia Geral das Nações Unidas, a água limpa e própria para consumo e o saneamento são direitos humanos essenciais para que todos desfrutem plenamente da vida e de seus direitos. Entretanto, segundo dados da OMS e do Unicef, 3,5 bilhões de pessoas não têm acesso a serviços de saneamento básico, como a coleta de esgoto. Ou seja, esse direito tem sido desrespeitado em muitas regiões do planeta.
Fonte de pesquisa: GAUTO, Marcelo Antunes; ROSA, Gilber Ricardo. Processos e operações unitárias da indústria química. Rio de Janeiro: Ciência Moderna, 2011. p. 39-40.
Grades: o esgoto doméstico é conduzido à estação de tratamento por meio de tubulações. O material passa por grades que retêm materiais maiores, como garrafas plásticas, pedaços de madeira e papéis.
Caixa de areia: retém materiais de menor tamanho que não ficaram retidos na etapa anterior.
Tanque de decantação primário: o líquido fica em repouso e as partículas se depositam no fundo.
Tanque de aeração: a água é movimentada, aumentando a quantidade de ar dissolvido nela. Isso facilita o desenvolvimento de organismos microscópicos que se alimentam da matéria orgânica presente na água.
Tanque de decantação secundário: as impurezas que ainda restam se depositam no fundo desse tanque.
Rio: a porção líquida que sai dos tanques de decantação não pode ser consumida pela população, porém, como é menos prejudicial ao ambiente, geralmente é lançada em rios ou mares.
Lodo primário: a parte sólida do esgoto recebe o nome de lodo. Algumas partículas afundam e são separadas.
Lodo secundário, adensadores e flotadores: o lodo é tratado, retirando a água e introduzindo bolhas de ar no material.
Digestadores: nesses recipientes, microrganismos decompõem o material orgânico.
Tortas para aterro sanitário: o lodo é prensado, transportado por uma esteira e separado em blocos. Os blocos são deixados em repouso para que o restante da água ainda presente nesse material evapore. O material seco é enviado ao aterro sanitário.
ESTAÇÕES DE TRATAMENTO DE ESGOTO E BIOCOMBUSTÍVEIS
O lodo das ETEs pode ser utilizado na produção de energia. Ao realizarem a decomposição da matéria orgânica presente no lodo, os microrganismos liberam o biogás, uma mistura gasosa composta principalmente de gás carbônico e metano.
O biogás pode ser utilizado para gerar energia elétrica ou térmica ou, ainda, ser purificado para obter biometano, que pode ser utilizado como combustível para veículos.
Estação de tratamento de esgoto no município de Franca, em São Paulo, em 2019.
Na ETE de Franca, o biogás gerado é captado e transformado em biometano.

• Leia com os estudantes, seguindo a ordem numérica, as etapas envolvidas na estação de tratamento de esgoto, retomando a imagem da página anterior.
ATIVIDADE EXTRA
Ao trabalhar as etapas 4 e 9 do tratamento de esgoto, pergunte aos estudantes se percebem o que elas têm em comum. Auxilie-os a notar que é a presença de microrganismos decompositores que se alimentam de matéria orgânica.
Leve-os ao laboratório de informática da escola e solicite-lhes que façam uma pesquisa para descobrir quais são esses microrganismos, como eles atuam no processo de tratamento de esgoto e quais processos metabólicos realizam.
BNCC
• A abordagem sobre a produção de biogás e biometano por meio do lodo gerado nas estações de tratamento de esgoto favorece o desenvolvimento da habilidade EF04CI07, pois possibilita aos estudantes verificarem a participação dos microrganismos na produção de combustíveis.
01/10/2025 09:54:45
• Ao abordar os problemas causados pelo lançamento de esgoto a céu aberto, se julgar pertinente, comente sobre as fossas secas. Explique aos estudantes que as fossas secas consistem em buracos escavados no solo, sem revestimento, no qual os dejetos são despejados. Além disso, nessas fossas, os dejetos atingem o solo diretamente, sem que haja tratamento, por isso pode ocorrer contaminação do solo e da água. Enfatize que as fossas secas também podem causar prejuízos ao ambiente e à saúde humana.
• Explique aos estudantes que as fossas sépticas são uma alternativa para o tratamento do esgoto doméstico em locais onde não há rede de coleta nem tratamento de esgoto. Ressalte que, embora as fossas sépticas possam ser uma solução para o tratamento do esgoto, elas exigem manutenção adequada para evitar problemas ambientais e de saúde.
• Ao realizar com os estudantes a atividade sobre a leptospirose, comente que a doença geralmente resulta da exposição à urina de rato contaminado com a bactéria, porém a urina de outros animais contaminados, como bois e cães, também pode levar à infecção.
• Explique que a leptospirose está relacionada a condições precárias de saneamento, uma vez que o esgoto ou o acúmulo de resíduos sólidos podem atrair ratos infectados com a bactéria. Desse modo, medidas que reduzam a possibilidade de instalação e proliferação de ratos, como o acondicionamento e a destinação adequada dos resíduos sólidos, ajudam a prevenir a doença.
• Comente que as enchentes aumentam a incidência da leptospirose, pois, nessas situações, ao entrar em contato direto com a água ou a lama contaminada com
3. a) Resposta: A leptospirose é causada pela bactéria Leptospira interrogans e é transmitida pelo contato com solo ou água contaminados com urina de rato infectada com essa bactéria.
Em locais onde não há rede de coleta e tratamento do esgoto, muitas vezes são construídas fossas sépticas.
As fossas sépticas são unidades de tratamento de esgoto doméstico. Algumas fossas sépticas são feitas de concreto e armazenam grande quantidade de esgoto. Essas estruturas são subterrâneas. Confira a seguir.
Fossa séptica

Imagem com elementos sem proporção entre si. Cores fantasia.
Representação de uma fossa séptica.
Fonte de pesquisa: INSTITUTO FEDERAL CATARINENSE. Fossa séptica e filtro anaeróbio: conceitos e dicas de manutenção. Blumenau, 2021.
No primeiro tanque, o esgoto é armazenado e os seres microscópicos começam a transformar a matéria orgânica.
O segundo tanque funciona como um filtro.
No terceiro tanque, a porção líquida filtrada penetra no solo.
Entretanto, há lugares em que não há rede de coleta e tratamento de esgoto nem fossas sépticas. Nesses locais, o esgoto é lançado a céu aberto e as pessoas que vivem ao redor podem ser contaminadas com diferentes microrganismos causadores de doenças.
Os esgotos sem tratamento, lançados em rios, lagos e mares, contaminam esses corpos de água, prejudicando os seres vivos que vivem nesses ambientes.
3. Utilize o código a seguir para descobrir o nome de uma doença relacionada à falta de saneamento básico e escreva-o no caderno.
Código
Nome da doença
Resposta: Leptospirose.
a ) Pesquise o agente causador e o modo de transmissão dessa doença. b ) Pesquise os principais sintomas e as medidas de prevenção dessa doença.
musculares, vômito, diarreia e dor de cabeça. Evitar o contato com
Resposta: Os principais sintomas da leptospirose são febre, dores água e solo contaminados e a ingestão de água e alimentos contaminados com a urina desses animais são algumas maneiras de prevenção dessa doença.
a bactéria causadora da doença, o ser humano pode ser infectado. Por isso, em situações de enchente, recomenda-se utilizar botas de borracha ou luvas em circunstâncias que seja necessário entrar em contato com a água e a lama, como na limpeza e desinfecção do local depois que as águas baixarem.
Confira outras doenças relacionadas à falta de acesso ao saneamento básico.
A febre tifoide é uma doença causada pela bactéria Salmonella typhi. Ela é transmitida pela ingestão de água ou alimentos contaminados com essa bactéria.
Essa doença pode causar febre, alterações no funcionamento intestinal, perda de apetite, dores de cabeça, náuseas e vômito.
Essa bactéria pode afetar órgãos como o fígado e o baço. Se não for tratada, a pessoa pode ir a óbito.
Salmonella typhi. Imagem ampliada cerca de 2 450 vezes e colorida em computador.

A giardíase é uma doença causada pelo protozoário Giardia lamblia. Quando uma pessoa ingere os cistos desse protozoário junto com os alimentos ou a água, ela pode se infectar. A pessoa infectada pode apresentar dores abdominais, náusea, diarreia, perda de massa magra, entre outros sintomas.
Giardia lamblia. Imagem ampliada cerca de 16 000 vezes e colorida em computador.
A amebíase é causada pelo protozoário Entamoeba histolytica. A pessoa é contaminada ao consumir alimentos ou água contendo os cistos desse protozoário.
O indivíduo infectado tem diarreia e dores abdominais.
Entamoeba histolytica. Imagem ampliada cerca de 800 vezes e colorida em computador.


Esses microrganismos são eliminados com as fezes das pessoas infectadas. Assim, na ausência de saneamento básico, as pessoas podem ingerir água contaminada com esses seres microscópicos.
INFOGRÁFICO CLICÁVEL: SANITIZAÇÃO DOS ALIMENTOS
4. Além de acesso ao saneamento básico, quais atitudes ajudam a prevenir essas doenças?
Resposta: Beber somente água fervida, filtrada ou clorada, fazer a higienização dos alimentos e lavar as mãos após ir ao banheiro e antes das refeições.
à água potável. Já o acesso à coleta e ao tratamento de esgoto deverá ser garantido a 90% da população até essa data. Incentive os estudantes a refletirem sobre a importância de se fazer cumprir a meta estabelecida por essa lei. Caso julgue pertinente, desenvolva com eles a atividade extra indicada a seguir.
ATIVIDADE EXTRA
Para esta atividade, imprima fotografias ou reportagens que retratem a relação entre a falta dos serviços de saneamento básico e os temas propostos a seguir.
• Doenças.
• Evasão escolar.
• Contaminação e poluição ambiental.
• Desvalorização do turismo.
• Organize a turma em grupos e distribua entre eles os temas e os materiais correspondentes a cada um dos temas, impressos por você. Caso julgue mais adequado, leve os estudantes ao laboratório de informática e proponha a eles que realizem a pesquisa sobre os temas.
Atribua um tempo para que eles estudem os materiais impressos. Em se-
BNCC
• O conteúdo abordado nessa página contribui para desenvolver o tema contemporâneo transversal Saúde ao explorar as doenças relacionadas ao descarte inadequado de esgoto. Além disso, possibilita desenvolver a Competência geral 8 e a Competência específica de Ciências da Natureza 7, pois incentiva o cuidado com a saúde física.
• Na questão 4, caso os estudantes tenham dificuldade em responder, lembre-os de que os serviços de saneamento básico incluem serviços de abastecimento de água tratada, coleta e tratamento de esgoto e coleta e destinação dos resíduos sólidos. Questione-os se, além desses serviços, existem outras medidas que podem ser adotadas no dia a dia, por exemplo, antes das refeições ou antes de beber água, que possam prevenir as doenças abordadas.
• Aproveite para discutir a importância do saneamento básico na prevenção dessas doenças e o papel da comunidade e do poder público na manutenção de ambientes limpos e seguros. Se julgar pertinente, comente a lei nº 14.026/2020, que atualizou o Marco Legal do Saneamento proposto pela lei n º 11.445/2007. De acordo com a lei nº 14.026/2020, até o ano de 2033, 99% da população brasileira deverá ter acesso
01/10/2025 09:54:46
guida, solicite que elaborem um texto explicando a relação entre a falta dos serviços de saneamento básico e o tema pelo qual o grupo ficou responsável.
Peça aos estudantes que leiam a explicação formulada por eles para o restante da turma.
Caso julgue interessante, elabore com eles um mural com as reportagens, as fotografias e os textos produzidos e exponha esse material no ambiente escolar.
BNCC
• Essa seção trabalha o consumo consciente da água e o desenvolvimento de argumentos para promover a consciência socioambiental e a tomada de decisões baseadas em princípios sustentáveis, permitindo o desenvolvimento do tema contemporâneo transversal Educação ambiental, das Competências gerais 7 e 10 e da Competência específica de Ciências da Natureza 5
OBJETIVOS
• Conhecer e ler uma fatura de consumo de água, identificando os dados de consumo e de custo.
• Reconhecer a importância do consumo consciente da água tanto para a conserva ção do meio ambiente quanto para a economia doméstica.
• Produzir um cartaz de conscientização sobre o uso da água.
• Auxilie os estudantes na leitura da fatura, explicando o significado dos dados que aparecem nela.
• Referência: mês que está sendo cobrado.
• Data da leitura: dia em que foi medido o consumo residencial.
• Leitura anterior: consumo de água medido no mês anterior.
• Leitura atual: consumo de água medido no mês de referência.
• Dias de consumo: quantos dias estão sendo cobrados.
• Consumo: valor consumido durante o período de referência.
• Consumo mensal em metro cúbico: cada metro cúbico equivale a 1 000 litros.
• Água: valor, em reais, da água tratada.
• Esgoto: valor, em reais, do tratamento de esgoto. Equivale a uma por-
ENTRE TEXTOS
a) Resposta nas orientações ao professor
Todos os meses, as pessoas que têm acesso ao tratamento de água e esgoto recebem uma fatura referente a ele. Nela, constam os valores relacionados ao tratamento e ao consumo de água e esgoto de uma residência. As empresas fornecedoras desse serviço são as responsáveis por produzir a fatura e encaminhá-la ao usuário.
a ) Você já leu uma fatura de água e de esgoto? Em caso afirmativo, converse com um colega sobre essa leitura. Leia a fatura a seguir.
Imagem com elementos sem proporção entre si. Cores fantasia.
DESCRIÇÃO DOS SERVIÇOS LANÇADOS
DIAS DE CONSUMO MÉDIA DE CONSUMO/m3 ÚLTIMOS 5 MESES MOTIVO DA AUSÊNCIA DE LEITURA
Representação de uma fatura de água e de esgoto.
centagem fixa sobre o consumo de água.
ARTICULANDO CONHECIMENTOS
A abordagem da fatura permite estabelecer uma relação com o componente curricular de Matemática. Peça ao professor desse componente que auxilie os estudantes na conversão entre as unidades de medida metro cúbico e litro. Essa articulação pode envolver também o cálcu-
lo do valor unitário do metro cúbico.
Resposta
01/10/2025 09:54:46
a) Resposta pessoal. O objetivo desta questão é incentivar a participação dos estudantes e levá-los a compartilhar suas vivências sobre o assunto abordado.
NOME DO CLIENTE MATRÍCULA
ARMANDO SILVA TÁVORA
EXPLORANDO O TEXTO
Respostas nas orientações ao professor
b ) Quantos litros foram consumidos no mês de referência?
c ) Com base nessa informação, quantos litros de água foram consumidos, aproximadamente, por dia nesse mês?
d ) Observe o histórico de consumo de água na fatura. Houve economia de água em relação ao mês anterior?
e ) Identifique na fatura o valor cobrado pelo serviço de esgoto.
ALÉM DO TEXTO
Respostas nas orientações ao professor
f ) Junte-se a três colegas e formem um grupo. Façam uma pesquisa e conversem sobre hábitos individuais e coletivos que contribuem para o uso consciente da água. Com base nas informações obtidas e na conversa, elaborem um cartaz de conscientização com relação ao uso da água, com imagens sobre o tema e textos em letra cursiva. Apresentem o cartaz para a comunidade escolar.
Imagem com elementos sem proporção entre si. Cores

a torneira fechada enquanto seu uso não é necessário. Oriente-os a produzir um cartaz relacionando esses dados em colunas. Ao final, eles devem apresentar o total de água desperdiçada quando fazemos atividades cotidianas sem atentar para o uso da água.
• Verifique se, na escrita dos textos do cartaz, os estudantes realizam a pegada de três pontos no lápis ou na caneta. Caso necessário, oriente-os nessa etapa para que desenvolvam a escrita cursiva.
• Ao apresentarem o cartaz para a comunidade escolar, eles devem enfatizar os cuidados para evitar o desperdício de água.
Resposta
01/10/2025 09:54:47
f) Resposta pessoal. Espera-se que os estudantes insiram nos cartazes medidas relacionadas à redução do consumo de água durante a higienização do corpo, como manter as torneiras fechadas ao ensaboar partes do corpo e ao escovar os dentes, reparar vazamentos em encanamentos, acumular roupas para lavá-las juntas e aproveitar a água da lavagem de roupas para limpar calçada.
EXPLORANDO
O TEXTO
• Incentive os estudantes a conversarem sobre como os hábitos pessoais podem interferir no valor da fatura de água para que eles identifiquem atitudes que causam desperdício de água. Espera-se que concluam que evitar o desperdício de água ajuda a diminuir o valor da conta e a preservar o meio ambiente.
Respostas
b) 14 m 3 ou 14 000 litros.
c) Foram consumidos cerca de 467 litros de água por dia no mês de março (14 000 litros: 30 dias = 466,66 litros de água por dia).
d) Resposta pessoal. Espera-se que os estudantes comentem que houve redução no consumo de água, ou seja, houve economia de água, pois em fevereiro foram consumidos 17 m 3 de água, enquanto em março foram consumidos 14 m 3 . e) O valor cobrado é R$ 24,26.
ALÉM DO TEXTO
• Oriente os estudantes a pesquisarem o consumo médio de água em atividades diárias, como tomar banho, escovar os dentes, lavar as mãos, lavar a louça com a torneira aberta e lavar roupas. Em seguida, devem pesquisar quanto de água pode ser economizado fazendo as mesmas atividades, mas deixando
fantasia.
Representação de estudantes apresentando um cartaz para a turma.
FERNANDA
BNCC
• Esse tema contribui para o desenvolvimento dos temas contemporâneos transversais Saúde e Educação ambiental ao explorar as consequências do descarte incorreto dos resíduos sólidos. Além disso, contempla a Competência geral 10 e as Competências específicas de Ciências da Natureza 6 e 7, pois incentiva o cuidado com a saúde física e a reflexão acerca das consequências do descarte inadequado de resíduos sólidos no ambiente, colaborando para que os estudantes ajam com base em princípios sustentáveis.
SUGESTÃO DE ESTRATÉGIA INICIAL
Antes de iniciar o estudo desse tema com os estudantes, oriente-os a observar, por alguns dias, locais que costumam frequentar na comunidade, como as proximidades da escola, a rua onde moram, as bibliotecas, as praças e os parques. Solicite a eles que anotem situações de acondicionamento e descarte incorreto de resíduos sólidos, caso as observem.
Em sala de aula, peça aos estudantes que exponham as situações identificadas por eles e anote-as na lousa. Em seguida, oriente-os a debater sobre os problemas associados ao descarte incorreto dos resíduos sólidos, incentivando-os a refletir sobre o possível impacto para a saúde humana, para o meio ambiente e para os demais seres vivos.
Esta sugestão de estratégia inicial e o estudo desse tema permitem o desenvolvimento de um projeto sobre consumo consciente e gestão dos resíduos sólidos com os estudantes. Se julgar pertinente, desenvolva-o solicitando a eles que elaborem uma cartilha para promover a conscientização da comunidade sobre a importância do descarte
17 COLETA DE RESÍDUOS SÓLIDOS
Leia a tirinha a seguir.

1. Qual é o problema identificado pelo personagem Armandinho no terceiro quadrinho da tirinha?
Resposta: O descarte irregular de resíduos sólidos no ambiente.
2. Você já observou um problema semelhante no lugar onde vive? Conte aos colegas onde e o que observou.
Resposta pessoal. Espera-se que os estudantes comentem se já presenciaram descarte irregular de resíduos sólidos.
3. Quais consequências esse problema traz ao meio ambiente? E aos seres vivos?
Diversas atividades que realizamos no dia a dia resultam no descarte de materiais, como papéis, embalagens plásticas, caixas de papéis, potes de vidro, latas de metais e restos de alimentos. Esses materiais são chamados resíduos sólidos
Pense nos resíduos que você produziu hoje desde que acordou. Todos os dias, produzimos grande quantidade de resíduos.
Segundo a Associação Brasileira de Resíduos e Meio Ambiente (Abrema), em 2023, em média, cada brasileiro produziu mais de 1 quilograma de resíduos sólidos todos os dias.
Os resíduos sólidos devem ser descartados, recolhidos e destinados a locais adequados.
Antes de descartá-los, devemos identificar os tipos de resíduos para que possamos destiná-los adequadamente.

de resíduos sólidos acumulados em uma calçada.
3. Resposta: O despejo irregular de resíduos sólidos pode alterar a composição do solo, do ar e da água e prejudicar os seres vivos que dependem desses recursos.
e da destinação adequada dos resíduos sólidos. Nessa cartilha, eles deverão incluir os problemas que levantaram relacionados à gestão inadequada dos resíduos sólidos na comunidade, além de práticas e soluções para uma melhor gestão e destinação dos resíduos. A cartilha também deverá conscientizar o leitor sobre a importância do consumo consciente a fim de reduzir a quantidade de resíduos gerados e sobre os prejuízos que a gestão inadequada dos resíduos sólidos pode causar à saúde humana e ao meio ambiente. Caso julgue interessante, desenvolva a produção da cartilha com os componentes curriculares de Arte e Língua Portuguesa
• Solicite a alguns estudantes que leiam a tirinha para a turma. Na sequência, aproveite o momento e pergunte a eles se têm o costume de descartar os resíduos sólidos sempre na lixeira em sua residência, nos lugares por onde passeiam ou na escola. Mostre-lhes que pequenas atitudes contribuem para manter a limpeza dos ambientes.
Sacos
BECK, Alexandre. Armandinho onze. Florianópolis: A. C. Beck, 2019. p. 49.
Os resíduos sólidos que não podem ser reciclados ou reaproveitados devem ser destinados à coleta comum. Em geral, a coleta de resíduos sólidos é realizada por profissionais que recolhem os materiais, colocando-os em caminhões especializados.
4. Resposta pessoal. O objetivo desta questão é levar os estudantes a identificarem se têm acesso à coleta de resíduos sólidos comuns e a perceberem que há uma frequência na coleta desses resíduos.

Coleta de resíduos sólidos no município de Natal, no Rio Grande do Norte, em 2024.
4. No lugar onde você vive, há coleta de resíduos sólidos comuns? Com que frequência esses resíduos são coletados?
As cascas de vegetais, ovos e restos de alimentos, por exemplo, são resíduos chamados orgânicos. Já materiais como papel higiênico e guardanapos usados formam os rejeitos
Alguns resíduos podem ser perigosos para o meio ambiente e prejudicar a saúde dos seres humanos e de outros seres vivos. Por isso, eles devem ter uma destinação específica.
Pilhas e baterias usadas, equipamentos eletroeletrônicos em desuso e medicamentos fora do prazo de validade, por exemplo, são resíduos que contêm materiais que, se descartados incorretamente, podem contaminar o solo, a água e o ar e prejudicar a saúde dos seres vivos.
Muitos desses resíduos têm um sistema chamado de logística reversa. Nesse sistema, eles são coletados e devolvidos ao setor empresarial para que sejam reciclados ou reutilizados, ou para que tenham uma destinação ambientalmente adequada.
Para coletar os resíduos sólidos com logística reversa, podem ser criados pontos fixos de coleta ou campanhas para recolhimento desses resíduos ou de suas embalagens.

Ponto de coleta de medicamentos vencidos ou em desuso em uma farmácia no município de Londrina, no Paraná, em 2023.
• Ao abordar a coleta de resíduos sólidos comuns, incentive a reflexão sobre a importância desse serviço para o meio ambiente e para a saúde da população, assim como a de respeitar os profissionais que trabalham nessa atividade.
• Se julgar pertinente, comente que os resíduos sólidos podem ser classificados de acordo com a origem, como os domésticos, hospitalares, industriais, agroquímicos ou de construção civil. Explique que alguns rejeitos, como os hospitalares, industriais e de construção civil, devem ser coletados separadamente por empresas especializadas que os destinam para o descarte correto, evitando acidentes. Os resíduos hospitalares são especialmente perigosos, pois o manejo incorreto deles pode causar contaminação por agentes infecciosos.
• Ao abordar os resíduos com logística reversa, se julgar pertinente, acesse o site indicado nas referências complementares a seguir e apresente outros resíduos sólidos incluídos nesses sistemas.
REFERÊNCIAS COMPLEMENTARES
01/10/2025 09:54:48
O QUE é logística reversa. Sistema Nacional de Informações sobre a Gestão dos Resíduos Sólidos Disponível em: https://sinir. gov.br/perfis/logistica -reversa/logistica-reversa/. Acesso em: 26 jul. 2025. Nesse site, obtenha mais informações sobre a logística reversa e os resíduos e produtos para qual esse sistema é implementado.
• O trabalho com o tempo de decomposição de alguns materiais permite o desenvolvimento do tema contemporâneo transversal Educação ambiental , da Competência geral 10 e da Competência espe cífica de Ciências da Natureza 8, pois permite aos estudantes que identifiquem a necessidade de reutilizar, reduzir e reciclar esses materiais. Essa abordagem os incentiva a agir com responsabilidade, baseados em princípios sustentáveis, sobre questões socioambientais.
• Comente que os resíduos sólidos que levam muito tempo para se decompor, ao serem descartados incorretamente no ambiente, podem causar problemas ambientais. Leve imagens que mostrem o acúmulo de plástico nos mares e em algumas praias.
Aproveite para abordar o impacto disso na vida de alguns animais, como as tartarugas, que acabam consumindo pedaços de plástico e morrendo.
• Destaque também que, em razão do problema global da poluição por plástico, alguns países já proibiram a comercialização de itens plásticos de uso único, como canudos, talheres, copos e sacolas.
Quando um resíduo é lançado no ambiente, leva certo tempo para sofrer decomposição. Confira na tabela o tempo de decomposição de alguns materiais.
Fonte de pesquisa: BRASIL. Ministério do Meio Ambiente; Ministério da Educação; INSTITUTO BRASILEIRO DE DEFESA DO CONSUMIDOR. Manual de educação para o consumo sustentável. Brasília, 2005. p. 118.
Para reduzir a quantidade de resíduos no ambiente, devemos evitar o descarte de alguns materiais, pois eles podem se acumular durante anos ou séculos.
Entre as maneiras de evitar o descarte, destacam-se a reutilização e o reaproveitamento de materiais para diferentes finalidades.
Mesa e bancos feitos de pneus.
Tempo de decomposição de alguns materiais no ambiente
Material Tempo de decomposição
Papel De 3 a 6 meses
AlumínioMais de 200 anos
PlásticoMais de 400 anos
VidroMais de 1 000 anos
BorrachaIndeterminado

Os materiais podem ser enviados para reciclagem, processo pelo qual são transformados em outros. Resíduos como papel, plástico, vidro ou metal, que podem ser reciclados, devem ser separados para a coleta seletiva.
Os materiais destinados à coleta seletiva são recolhidos por profissionais e encaminhados a locais onde são separados e em seguida conduzidos a usinas de reciclagem.
Em alguns municípios, há locais com coletores seletivos para plástico, vidro, metal e papel. Cada tipo de material deve ser descartado separadamente, de acordo com sua constituição, no recipiente adequado.
Lixeiras para coleta seletiva de resíduos em Fortaleza, no Ceará, em 2025.

5. Recorte, de jornais ou revistas, imagens de resíduos como papel, plástico, vidro e metal e cole-as no caderno. Em seguida, contorne essas imagens com as cores das respectivas lixeiras em que esses resíduos devem ser descartados.
Resposta: Resíduos de papel: lixeira azul; resíduos de metal: lixeira amarela; resíduos de plástico: lixeira vermelha; resíduos de vidro: lixeira verde; resíduos que não podem ser reciclados: lixeira cinza.
A IMPORTÂNCIA DA RECICLAGEM
Você já parou para pensar que a maneira como tratamos os materiais que destinamos à coleta seletiva pode prejudicar ou favorecer a reciclagem, bem como o trabalho dos profissionais que atuam na coleta e triagem desses materiais?
Confira alguns cuidados que devemos ter com os materiais recicláveis.
Devemos higienizar os materiais destinados à reciclagem. Deixar, por exemplo, restos de comida nesses materiais pode impossibilitar a reciclagem deles.
Além disso, os resíduos orgânicos podem contribuir para a proliferação de microrganismos, podendo prejudicar a saúde dos profissionais da reciclagem.
Materiais com pontas que possam ferir os trabalhadores da reciclagem, como cacos de vidro, devem ser acondicionados em embalagens plásticas ou envoltos por papelão e ser identificados.

Materiais que podem ser reaproveitados ou reciclados, mas que podem causar danos ao ambiente e à saúde humana, como pilhas, baterias e eletroeletrônicos, não devem ser destinados à coleta seletiva.
A reciclagem dos resíduos sólidos diminui a retirada de recursos naturais do ambiente para a fabricação de novos produtos e reduz a quantidade de resíduos sólidos acumulados nos aterros sanitários, prolongando o tempo de utilização desses espaços. Além disso, ao ajudar a evitar que resíduos sólidos se acumulem em locais inadequados, ela contribui para a saúde da população.
Assim, os profissionais que atuam na reciclagem prestam um serviço de utilidade pública para a sociedade, pois ajudam a transformar resíduos que poderiam gerar problemas ambientais e de saúde pública em um produto de valor econômico.
Trabalhador em cooperativa de separação de recicláveis no município de São Paulo, em 2024.

por exemplo, usar um guardanapo que já havia sido utilizado e que seria descartado. Explique aos estudantes que as embalagens devem estar secas antes de serem colocadas nas lixeiras.
• Com relação à proliferação de microrganismos nos materiais higienizados incorretamente, explique que fungos e bactérias podem causar mau cheiro, além de atrair animais como ratos para o local de armazenamento dos materiais recicláveis, prejudicando a saúde dos profissionais da reciclagem. Caso necessário,
01/10/2025 09:54:52
lembre-os de que os ratos estão associados à transmissão de doenças como a leptospirose.
• Verifique se a turma se recorda que materiais como pilhas, baterias e eletroeletrônicos têm logística reversa e não devem ser destinados à coleta seletiva e tampouco à coleta comum.
• Ao abordar a importância da reciclagem para a saúde da população, verifique se os estudantes se recordam que o descarte irregular de resíduos sólidos está associado à ocorrência de certas doenças, como a dengue.
• Ao discutir a importância ambiental da reciclagem e ações que possibilitam a reciclagem dos materiais, a abordagem dessa página favorece o desenvolvimento do tema contemporâneo transversal Educação ambiental.
• Incentive os estudantes a responderem à questão inicial da seção de forma oral e livremente. Crie na lousa um quadro com duas colunas: “Atitudes que prejudicam a reciclagem e o trabalho dos profissionais da reciclagem” e “Atitudes que favorecem a reciclagem e o trabalho dos profissionais da reciclagem” e anote as respostas da turma nele. O objetivo desta atividade é levantar os conhecimentos prévios dos estudantes sobre o assunto. Se julgar adequado, ao término da leitura da seção, retome os pontos trabalhados nela e o quadro da lousa, completando-o se necessário. Reforce a importância do tratamento adequado dos resíduos sólidos recicláveis pela população e da reciclagem para o ambiente e para saúde da população.
• Ao abordar os cuidados com os resíduos sólidos antes da coleta e reciclagem dos materiais, comente que a higienização deve ser feita evitando o desperdício de recursos. Para retirar os restos de alimentos, pode-se,
Garrafas plásticas após higienização.
• Leia com os estudantes, seguindo a ordem alfabética, as etapas de processamento dos resíduos sólidos que ocorrem nos aterros sanitários. Enfatize que os aterros sanitários representam a solução mais adequada para a disposição dos resíduos sólidos, pois os impactos ao ambiente e à saúde pública são menores nesse tipo de instalação.
• Comente que, em muitas regiões do país, os resíduos sólidos ainda são destinados inadequadamente para os chamados lixões. Segundo Relatório dos Serviços de Limpeza Urbana e Manejo de Resíduos Sólidos (Sinisa) 2024, em 2023, ainda existiam 1 606 lixões em operação no país. Explique à turma que, nesses locais, os resíduos sólidos não são recobertos, sendo depositados diretamente no solo sem que haja impermeabilização. Desse modo, o chorume formado da decomposição dos resíduos sólidos pode contaminar o solo e o lençol freático. Além disso, os resíduos dispostos sem cuidado no ambiente podem atrair animais associados à transmissão de doenças e contribuir para a proliferação deles.
• Se julgar pertinente, mostre aos estudantes fotografias de lixões a céu aberto e de aterros sanitários, enfatizando as diferenças entre esses dois tipos de instalações.
• Explique que, embora o aterro sanitário seja a solução mais adequada para a disposição final dos resíduos sólidos, reduzir a geração desses resíduos, sempre que possível, é a melhor prática. Além dessa atitude, a reutilização e reciclagem dos materiais contribuem para que menos resíduos sólidos cheguem aos aterros sanitários, prolongando o tempo de uso dessas instalações.
Os resíduos que não podem ser reciclados devem ser destinados aos aterros sanitários por meio da coleta comum.
Aterro sanitário

Representação de um aterro sanitário.
com elementos sem proporção entre si.
Nos aterros sanitários, os resíduos são cobertos por uma camada de solo para não atrair animais e para evitar o mau cheiro. Durante a decomposição dos resíduos, são formados gases, os quais são captados por tubulações e eliminados do aterro por meio de chaminés. A decomposição dos resíduos gera o biogás, que pode ser captado e tratado para gerar energia.
Os aterros sanitários são formados por várias camadas de solo e resíduos, intercaladas por uma camada de rocha e material impermeável. As camadas auxiliam na coleta dos líquidos e gases e impedem a contaminação das demais camadas e do solo.
Quando os resíduos sofrem decomposição, ocorre a formação de um produto chamado chorume, que muitas vezes pode ser tóxico. Por isso, os resíduos sólidos são depositados sobre uma camada impermeável, a fim de evitar a contaminação do solo.
Imagem
Cores fantasia.
Fonte de pesquisa: HINRICHS, Roger A.; KLEINBACH, Merlin; REIS, Lineu B. dos. Energia e meio ambiente. Tradução de Lineu Belico dos Reis, Flávio Maron Vichi e Leonardo Freire de Mello. São Paulo: Cengage Learning, 2014. p. 689.
A. B. C.
D.
A.
B.
C. D.
A maioria dos resíduos orgânicos é encaminhada aos aterros sanitários. Entretanto, parte desses resíduos pode ser transformada por meio da compostagem, que é um processo de decomposição de matéria orgânica.
Nesse processo, organismos decompositores transformam os resíduos orgânicos em um composto que pode ser utilizado como adubo em hortas, pois é rico em sais minerais e nutrientes.

Solo rico em húmus formado por meio do processo da compostagem.
A destinação e o descarte inadequados dos resíduos podem causar danos ao ambiente, levar à formação de poluentes e colocar a saúde das pessoas em risco.
a) Resposta pessoal. O objetivo desta questão é conduzir os estudantes a lembrarem se já viram resíduos sólidos acumulados em bueiros.
BUEIROS ENTUPIDOS E ALAGAMENTOS

a ) Você já presenciou em seu município uma situação parecida com a mostrada na fotografia?
b ) Por que você considera que esse problema acontece?
Bueiro entupido na cidade de São Paulo, em 2025.
Os bueiros ou bocas de lobo, construídos ao longo de ruas e rodovias, são aberturas que têm por finalidade a captação de água das chuvas. Ao entrar pelo bueiro, a água da chuva é encaminhada para as galerias subterrâneas pluviais.
No entanto, quando os bueiros ficam entupidos pelo excesso de resíduos sólidos, a água das chuvas não escoa adequadamente, o que ocasiona alagamentos em dias chuvosos.
Os alagamentos podem trazer prejuízos econômicos e contribuir para a disseminação de microrganismos causadores de doenças.
Dessa maneira, não se deve jogar resíduos sólidos nas ruas, a fim de manter os bueiros livres.
b) Resposta pessoal. O objetivo desta questão é que os estudantes reflitam sobre as razões desse problema, como o descarte de resíduos nas ruas.
deixar espaços nas construções para que a água infiltre no solo, além de evitar o descarte incorreto de resíduos sólidos. Ambas as atitudes são tanto pessoais quanto sociais. Ressalte também que a atitude de cada pessoa é importante para resolver esses problemas coletivos.
• Se julgar pertinente, comente que os serviços de saneamento básico também incluem o manejo e a drenagem das águas pluviais. Explique que, a fim de evitar alagamentos, ao planejar a construção de áreas urbanas, deve-se prever a infraestrutura necessária para coletar e drenar a água da chuva. Fazem parte dessa
01/10/2025 09:57:25
infraestrutura, por exemplo, a construção de sarjetas e bueiros, para coletar a água da chuva, e de galerias para transportar a água coletada até os pontos de lançamento.
BNCC
• A abordagem sobre a importância do descarte correto dos resíduos sólidos para evitar o entupimento de bueiros (bocas de lobo), os alagamentos e a possível disseminação de doenças permite o desenvolvimento dos temas contemporâneos transversais Educação ambiental e Saúde
• Ao abordar a composteira, mostre que a gestão dos resíduos orgânicos pode ser realizada em iniciativas comunitárias e institucionais. Comente a construção de composteiras em escolas e em hortas comunitárias. Se julgar interessante, realize com os estudantes a atividade extra proposta a seguir.
ATIVIDADE EXTRA
Peça aos estudantes que pesquisem formas de montar uma pequena composteira doméstica. Converse com a direção da escola para definir um local para a instalação da composteira e um local para o uso do adubo produzido.
Auxilie os estudantes na montagem da composteira, no cuidado dela e, posteriormente, no destino do adubo formado nesse processo.
• Comente com os estudantes que, além dos resíduos sólidos que entopem os bueiros, outro problema que contribui para alagamentos e enchentes nas cidades é a impermeabilização do solo, causada pela construção de ruas de asfalto e do calçamento em concreto sem deixar espaços para que a água da chuva infiltre no solo. Como não penetra no solo, a água escoa por cima do chão, formando enxurradas e provocando alagamento nas cidades. Enfatize que, para resolver esses problemas, é necessário
BNCC
• Essa seção possibilita o desenvolvimento do tema contemporâneo transversal Educação em direitos humanos ao trabalhar a importância do saneamento básico para a saúde e a saúde como um direito humano. Além disso, contempla a Competência geral 7 e as Competências específicas de Ciências da Natureza 5 e 6, pois leva os estudantes a buscarem informações e utilizarem diferentes linguagens para promover a consciência socioambiental.
OBJETIVOS
• Conhecer o problema da falta de acesso aos serviços de saneamento básico por parte da população brasileira e as consequências dessa privação.
• Refletir sobre a quantidade e o destino dos resíduos sólidos gerados no Brasil.
• Realizar uma entrevista para verificar a situação do saneamento básico no bairro e na cidade onde os estudantes vivem.
1. CONHECENDO O PROBLEMA
• Oriente os estudantes a lerem a reportagem apresentada na página, relacionando o problema relatado aos conteúdos trabalhados ao longo da unidade.
• Comente que o tratamento e a distribuição da água tratada, a coleta e o tratamento do esgoto e a coleta de resíduos são serviços públicos que devem ser prestados à população, a fim de garantir a qualidade de vida de todos. Aproveite para questionar os estudantes sobre os motivos que levam à falta desses serviços públicos em alguns locais do Brasil.
Resposta
a) Resposta pessoal. O objetivo desta questão é levar os estudantes a identifica-
COLETIVAMENTE
Situação do saneamento básico no Brasil
Conhecendo o problema 1
Leia o trecho de reportagem a seguir.
Com mais de 32 milhões de brasileiros sem acesso à água potável e cerca de 90 milhões sem coleta de esgoto, a ausência de saneamento básico traz graves consequências para a saúde da população [...]
AUSÊNCIA de saneamento resulta em mais internações de crianças e idosos no Brasil. Trata Brasil, 27 mar. 2025. Disponível em: https://tratabrasil.org.br/ausencia-saneamento-internacoes-crianca-idoso/. Acesso em: 5 maio 2025.
Embora seja um direito de todo cidadão ter acesso à saúde e, consequentemente, ao saneamento básico, muitos lugares no Brasil ainda são desabastecidos de serviços básicos de saneamento. Em algumas regiões, mesmo quando as pessoas pagam por esses serviços, não o recebem com total qualidade. a ) A cidade em que você vive recebe quais serviços de saneamento?
Resposta nas orientações para o professor.
Organizando as ideias 2
De acordo com dados da Associação Brasileira de Resíduos e Meio Ambiente (Abrema), em 2023 foram produzidas cerca de 81 milhões de toneladas de resíduos sólidos no Brasil. Desse total, cerca de 76 milhões de toneladas de resíduos sólidos foram coletadas no mesmo ano. Observe o gráfico a seguir.
Quantidade de resíduos sólidos produzidos e coletados por região do Brasil (2023)
rem os serviços de saneamento básico disponíveis no município onde vivem ou a falta deles, se for o caso.
ARTICULANDO CONHECIMENTOS
Essa seção permite o trabalho interdisciplinar do tema contemporâneo transversal Educação em direitos humanos com o componente curricular de Geografia ao abordar serviços públicos que devem ser prestados a toda população. Caso julgue pertinente, utilize o gráfico sobre os serviços de abastecimento de água e de coleta de esgoto da página 135 para traba-
Fonte de pesquisa: PANORAMA. Abrema, 2024. Disponível em: https://www.abrema.org. br/panorama/. Acesso em: 5 maio 2025.
lhar a disparidade do acesso a esses serviços nas diferentes regiões do Brasil, ampliando a abordagem sobre o acesso aos serviços de saneamento básico.
01/10/2025 09:57:25
2. ORGANIZANDO AS IDEIAS
• Auxilie os estudantes na leitura dos dados do gráfico. Verifique se notam que, em todas as regiões do país, a quantidade de resíduos coletados é menor do que a quantidade gerada.
Região
Sul Sudeste
Centro-Oeste Nordeste Norte
Quantidade de resíduos sólidos (tonelada)
Resíduos sólidos produzidos
Resíduos sólidos coletados
Respostas nas orientações para o professor
a ) Qual região brasileira produziu a maior quantidade de resíduos sólidos em 2023?
b ) Explique por que é preocupante, do ponto de vista ambiental, que cerca de 5 milhões de toneladas não tenham sido coletadas.
Buscando soluções 3
Respostas nas orientações para o professor
a ) Em grupos de quatro estudantes, elaborem um roteiro de entrevista sobre as condições sanitárias em seu bairro e município. Lembrem-se de questionar o entrevistado sobre:
• tratamento de água e coleta de esgoto;
• coleta de resíduos comuns e coleta seletiva;
• limpeza de bueiros;
• focos de água parada;
• condições em dias de chuvas intensas;
• saúde das pessoas da família;
• mudanças ou melhorias ao longo do tempo.
b ) Com a ajuda dos pais ou responsáveis, utilizem o roteiro elaborado e entrevistem algumas pessoas da comunidade sobre as condições de saneamento no bairro e no município.
c ) Levem os materiais das entrevistas para a sala de aula e os apresentem aos colegas. Formem uma mesa-redonda e conversem sobre as observações que fizeram e levantem possíveis soluções para os problemas encontrados.
Imagens com elementos sem proporção entre si. Cores fantasia.

no da escola, registrando os problemas do bairro no qual ela se situa.
• Por fim, peça-lhes que analisem a situação local e discutam possíveis soluções para os problemas encontrados, visando melhorar a abrangência dos serviços de saneamento básico do município.
Respostas
a) Resposta pessoal. Espera-se que os estudantes elaborem questões para nortear suas entrevistas, facilitando a abordagem e focando o saneamento básico e como ele pode impactar a vida das pessoas.
b) Espera-se que os estudantes interajam com pessoas que vivem há certo tempo no bairro e que se lembram de mudanças ocorridas no local a fim de levantar problemas e melhorias que ocorreram ao longo do tempo relacionadas ao saneamento básico.
c) Espera-se que os estudantes compartilhem suas experiências e busquem pontos comuns e divergentes em suas observações, enriquecendo o debate de ideias.
• Se julgar pertinente, como culminância dessa atividade, peça aos estudantes
Respostas
a) Região Sudeste. b) Resposta pessoal. Espera-se que os estudantes comentem que isso é preocupante porque grande parte desses resíduos pode ter sido lançada no ambiente de maneira inadequada, o que pode levar à contaminação ou à poluição do solo e da água.
ARTICULANDO CONHECIMENTOS
A abordagem sobre a produção e a coleta de resíduos sólidos no Brasil permite o trabalho integrado com o componente curricular de Matemática ao mencionar a tonelada, medida utilizada para expressar grandes massas. Trabalhe a representação das 5 milhões de toneladas de resíduos sólidos não coletadas em quilograma. Caso seja necessário, relembre os estudantes que 1 tonelada equivale a 1 000 quilogramas.
3. BUSCANDO SOLUÇÕES
• Oriente os estudantes a realizarem as entrevistas acompanhados de um responsável. Eles podem fazer um questionário e solicitar às pessoas que o preencham. Isso facilita a coleta e a organização dos dados.
• Se julgar conveniente, mediante a autorização dos pais e responsáveis, realize a atividade em conjunto com os estudantes em tor-
01/10/2025 09:57:26
que elaborem uma carta pessoal e de reclamação. Oriente-os a elencar os problemas levantados e incluir solicitações e reivindicações aos órgãos competentes para a melhoria das condições de saneamento básico do bairro e do município. Incentive-os a argumentar na carta sobre como essas reivindicações podem contribuir para a melhora da qualidade de vida da população. Essa abordagem colabora para o desenvolvimento da capacidade argumentativa dos estudantes.
Representação de crianças conversando sobre as entrevistas realizadas.
BNCC
• Esse tema contribui para o desenvolvimento da habilidade EF04CI01 , pois permite ao estudantes que identifiquem misturas na vida cotidiana com base em suas propriedades físicas observáveis, reconhecendo as respectivas composições. Também promove o trabalho com a habilidade EF04CI03, pois aborda mudanças reversíveis e irreversíveis que podem ocorrer com as misturas.
• Antes de iniciar o trabalho com essa página, pergunte aos estudantes se conhecem o soro caseiro. Caso respondam que sim, pergunte se já precisaram beber essa mistura e em que ocasião isso ocorreu. Permita que exponham suas experiências, engajando-se no estudo do tema.
• Retome com os estudantes algumas doenças transmitidas pela ingestão de água e alimentos contaminados que causam diarreia, como a amebíase e a giardíase. Explique a eles que na diarreia o corpo passa por uma perda excessiva de sais minerais e de água, levando à desidratação. Caso o tratamento adequado para combater a desidratação não seja iniciado rapidamente, pode ocorrer uma série de complicações para a saúde, levando, inclusive, à morte.
• Comente que, para que mortes por desidratação e diarreia sejam evitadas, tratamentos que incluam reidratação, como a ingestão do soro, e cuidados com a alimentação dos pacientes são importantes. No entanto, outras medidas são fundamentais, como o acesso ao saneamento básico e à vacinação. Caso julgue pertinente, ressalte que o quadro vacinal brasileiro inclui a vacina que previne contra o rotavírus, um vírus que causa uma das principais doenças
MISTURAS
Conheça a seguir parte da história da médica brasileira Zilda Arns (1934-2010).
Tipsi acordou um dia muito animada. Havia tido uma ideia e colocá-la em prática não seria uma tarefa simples: queria fazer com que toda criança do seu país, quiçá do mundo, pudesse crescer saudável e feliz.
[...]
Na verdade, seu nome era Zilda, mas ela gostava quando a chamavam de Tipsi. [...]
Quando cresceu, decidiu estudar para ser médica. [...]
Ela se tornou pediatra e especialista em saúde pública. [...]
Tipsi decidiu que era hora de colocar sua ideia em prática. [...] passou a ensinar, no Brasil inteiro, que havia uma poção – nem um pouco mágica – capaz de salvar vidas: o soro caseiro. [...]
THOMÉ, Débora. 50 brasileiras incríveis para conhecer antes de crescer. 2. ed. Rio de Janeiro: Galera, 2018. p. 77.
Como você estudou, a falta de saneamento adequado pode estar associada a diversas doenças. Algumas delas podem causar diarreia e levar à desidratação.
A mistura que Zilda Arns passou a divulgar, o soro caseiro, ajudou várias famílias brasileiras a prevenir a desidratação. Confira a seguir como prepará-la.
No preparo do soro caseiro, pode-se utilizar uma colher-medida. Nesse caso, deve-se adicionar a 200 mL de água fervida ou filtrada uma medida rasa de sal e duas medidas rasas de açúcar.

de açúcar

Imagens sem proporção entre si.
Zilda Arns, fundadora da Pastoral da Criança, responsável pela Campanha do Soro Caseiro. Colher-medida.
1. Quais componentes são misturados para preparar o soro caseiro?
Resposta: Água potável, sal e açúcar.
A seguir, você vai conhecer mais sobre as misturas.
diarreicas que afetam crianças em seus primeiros anos de vida.
• Diga aos estudantes que a campanha sobre o preparo do soro caseiro divulgada por Zilda Arns e pela Pastoral da Criança colaborou para a redução da quantidade de hospitalizações por desidratação causadas por doenças diarreicas no Brasil, ajudando a salvar vidas e colaborando para a saúde da população brasileira.
• Comente que o Sistema Único de Saúde (SUS) fornece gratuitamente envelopes com sais de reidratação oral, que contêm os componentes nas quantidades adequadas ao preparo do soro de reidratação oral. Enfatize que a desidratação
deve ser avaliada por um profissional da saúde para que o tratamento mais adequado seja recomendado.
• Incentive-os a pensar em outras misturas que conhecem e como elas são utilizadas.
medida
medida de sal
No dia a dia, temos contato com diferentes tipos de mistura. Uma mistura é constituída de dois ou mais materiais, denominados componentes da mistura. As misturas e seus componentes podem ser sólidos, líquidos ou gasosos. Confira os exemplos a seguir.
Imagens sem proporção entre si.
O ar atmosférico é uma mistura gasosa. Ele é formado por diferentes componentes gasosos, como nitrogênio, gás oxigênio e gás carbônico, além do vapor de água.
O vinagre, utilizado no preparo de saladas e conservas, é uma mistura líquida Ele é formado por diferentes componentes líquidos, como ácido acético e água.
Vinagre.

A granola é um exemplo de mistura sólida. Ela contém diferentes componentes sólidos, como aveia, castanhas e frutas secas.

Além disso, muitos componentes de uma mistura também podem ser misturas.
As geleias são exemplos de misturas geralmente compostas de água, frutas e açúcar. As frutas também são misturas formadas por componentes, como carboidratos, vitaminas e água.
Observe a imagem a seguir.


de
de garrafa de água mineral.
2. A água mineral é uma mistura? Justifique sua resposta.
2. Resposta pessoal. Espera-se que os estudantes respondam que sim, pois ela contém diversas substâncias dissolvidas.
Esta atividade contribui para o desenvolvimento da habilidade EF04CI01 da BNCC ao possibilitar aos estudantes que identifiquem misturas em situações do dia a dia. Já a conversa sobre a importância da alimentação equilibrada para a manutenção da saúde colabora para o trabalho com o tema contemporâneo transversal Educação alimentar e nutricional e o desenvolvimento da Competência específica de Ciências da Natureza 7 da BNCC.
01/10/2025 09:57:28
• Pergunte à turma se as misturas são feitas apenas com componentes do mesmo estado físico. Explique que existem misturas com componentes em diferentes estados físicos, sejam elas homogêneas ou heterogêneas. Cite o exemplo da sopa, que é preparada com componentes líquidos e sólidos.
Anote na lousa os nomes de alguns alimentos, como os sugeridos a seguir.
• banana
• açúcar
• ovo
• morango
• óleo de soja
• cacau em pó
• fubá
• mamão
• queijo ralado
• leite
• farinha de trigo
• fermento químico
• tapioca
Solicite aos estudantes que proponham misturas com dois ou mais dos ingredientes que você listou na lousa. Peça a eles que pensem em alimentos que costumam consumir e que combinam, no preparo, os ingredientes listados, levando-os a identificar misturas em seu cotidiano. Permita que exponham suas experiências, incentivando o engajamento deles no estudo do tema, e anote as respostas na lousa.
Aproveite a atividade para conversar sobre manter uma alimentação equilibrada e como isso impacta a saúde do ser humano. Espera-se que os estudantes comentem que a alimentação deve ser composta de alimentos variados e em quantidade suficiente, sem excesso ou falta de nutrientes.
Parte
um rótulo
Pêssegos e geleia de pêssego.
Granola.
AVALIANDO
Objetivo
• As questões 3, 4 e 5 permitem observar se os estudantes identificam misturas homogêneas e heterogêneas, além da quantidade de fases das misturas heterogêneas.
Sugestão de intervenção
Para complementar o conteúdo, realize uma atividade prática. Peça aos estudantes que se sentem em círculo. Forneça, então, pedaços de massinha de modelar de diferentes cores para cada um. Em seguida, pegue um pedaço de uma cor qualquer e entregue a um estudante. Peça a ele que misture o próprio pedaço a esse e o mostre à turma, e que avalie a cor resultante e se é possível distinguir os elementos (mistura heterogênea). Passe essa mistura para o estudante subsequente, que deve misturar sua massinha a essa mistura e repetir o processo. Depois que todos tiverem misturado seu pedaço de massinha, avaliem juntos a cor e o tipo de mistura. Caso ainda seja possível distinguir diferentes cores, continue passando a massa de um estudante para outro a fim de que eles misturem mais até que o resultado final seja uma mistura que apresenta uma só cor. Aproveite esse momento para discutir os conceitos de misturas homogêneas e heterogêneas.
Resposta
6. O objetivo desta questão é levantar os conhecimentos prévios dos estudantes sobre a solubilidade de componentes na água. Assim, espera-se que eles comentem que a mancha se formou porque parte do petróleo não foi dissolvida na água.
Em algumas misturas, não conseguimos identificar visualmente os componentes delas. Elas são chamadas misturas homogêneas. Já nas misturas heterogêneas, em geral, é possível identificar visualmente os diferentes componentes.
3. Observe as imagens das misturas e classifique-as como homogêneas ou heterogêneas.
Resposta: A: heterogênea; B: homogênea.

A. B.

Nas misturas heterogêneas, as porções que apresentam aparência e composição uniforme são chamadas fases
4. A imagem mostra uma mistura de areia, água e óleo.
a ) Essa mistura é homogênea ou heterogênea?
Resposta: É uma mistura heterogênea.
b ) Quantas fases há nessa mistura?
Resposta: Há três fases nessa mistura: areia, água e óleo.
5. Na atividade 3, alguma mistura é heterogênea?
Em caso afirmativo, ela apresenta quantas fases?

6. Em 2019, um grande vazamento de petróleo ocorreu no mar próximo à costa brasileira, formando uma imensa mancha sobre a água e gerando diversos problemas ambientais.
Por que o petróleo derramado no mar formou uma camada sobre a água?
Resposta nas orientações ao professor

5. Resposta: O suco de laranja com gelo é um exemplo de mistura heterogênea. Essa mistura apresenta duas fases: o gelo e a mistura de suco de laranja, água e açúcar.
• Ressalte que vazamentos de petróleo são uma grave ameaça à biodiversidade marinha.
• Leve os estudantes ao laboratório de informática para que realizem uma pesquisa. Organize a turma em grupos de quatro a cinco integrantes e oriente-os a pesquisar informações sobre os prejuízos que o derramamento de petróleo no mar pode causar aos seres vivos e ao meio ambiente. Solicite que apresentem os trabalhos aos colegas, socializando suas produções. A pesquisa e a confecção de um cartaz sobre os impactos ambientais causados pelo derramamento de
óleo, bem como a socialização dessa produção, favorecem o desenvolvimento da Competência geral 5 e das Competências específicas de Ciências da Natureza 3 e 6 da BNCC, ao levarem os estudantes a utilizarem tecnologias digitais de informação para buscar conhecimentos próprios da Ciência a fim de explicar e divulgar implicações socioambientais de processos relativos ao mundo natural.
Imagens sem proporção entre si.
Suco de laranja com gelo.
Água mineral.
Mistura de areia, água e óleo.
Mancha de petróleo na praia do Janga, em Pernambuco, em 2019.
A água é capaz de dissolver diversos componentes sólidos, líquidos e gasosos. Por isso, ela é chamada solvente universal. No entanto, alguns componentes não se dissolvem na água. Observe a seguir duas misturas.

Ao misturar sal de cozinha e água em um copo, não é possível identificar visualmente o sal. Isso ocorre porque o sal se dissolve completamente na água, ou seja, o sal é um componente solúvel em água.
Sal e mistura de água e sal.
Ao misturar óleo vegetal e água em um copo, formam-se duas camadas, com o óleo por cima e a água por baixo. Isso ocorre porque o óleo vegetal não se dissolve na água, ou seja, é um componente insolúvel em água.
Mistura de óleo vegetal e água.

As substâncias que conseguem dissolver outras são chamadas solvente, e as substâncias dissolvidas são chamadas soluto. No exemplo anterior, a água é o solvente e o sal é o soluto.
7. Escreva as frases a seguir no caderno substituindo cada ■ pela palavra do quadro adequada.
7. a) Resposta: O açúcar e o álcool se dissolvem na água, portanto, nessa mistura, são chamados solutos. Nesse caso, a água é chamada solvente.
açúcar • areia • álcool • heterogênea • óleo • solutos
a ) O ■ e o ■ se dissolvem na ■, portanto, nessa mistura, são chamados ■. Nesse caso, a água é chamada ■
b ) A ■ e o ■ não se dissolvem na água, tratando-se de uma mistura ■.
Resposta: A areia e o óleo não se dissolvem na água, tratando-se de uma mistura heterogênea.
01/10/2025 09:57:33
AVALIANDO
Objetivo
• A atividade 7 permite observar se os estudantes compreendem os conceitos de solubilidade, soluto e solvente.
Sugestão de intervenção
Apesar de a água ser considerada um solvente de várias substâncias, sua capacidade de dissolução tem limite, formando, por exemplo, soluções saturadas. Conduza uma atividade com a turma para mostrar esse fato. Providencie um copo com água, uma colher e sal. Adicione uma colher de sal ao copo com água e vá adicionando outras colheres de sal aos poucos. Antes de acrescentar o sal, pergunte aos estudantes se acham que ele será dissolvido. Se considerar interessante, adicione mais água para observar o que acontece com o sal excedente. Aproveite esse momento para discutir com a turma a capacidade de dissolução de alguns solventes e o que acontece quando se aumenta a concentração do soluto ou do solvente nas soluções.
BNCC
• Esse assunto contribui para o desenvolvimento da habilidade EF04CI01 , já que permite aos estudantes que identifiquem misturas na vida diária com base em suas propriedades físicas observáveis, reconhecendo sua composição.
BNCC
• A seção trabalhada nessa página leva os estudantes a dominarem processos, práticas e procedimentos da investigação científica, o que permite o desenvolvimento da Competência específica de Ciências da Natureza 2. Além disso, incentiva-os a analisar, compreender e explicar fenômenos e processos relativos ao mundo natural, exercitando a curiosidade para fazer perguntas e buscar respostas com base nos conhecimentos das Ciências da Natureza, o que contempla a Competência geral 2 e a Competência específica de Ciências da Natureza 3
OBJETIVOS
• Reconhecer a peneiração como técnica de separação de mistura.
• Identificar e classificar misturas homogêneas e heterogêneas.
Resposta
a) O objetivo desta questão é resgatar os conhecimentos prévios dos estudantes sobre misturas. Eles podem citar que é possível misturar corantes ou outras substâncias coloridas na cola branca.
• Enfatize que a beterraba deve ser ralada por um adulto.
ARTICULANDO CONHECIMENTOS
Essa seção permite o trabalho com o componente curricular Arte. Proponha aos estudantes que realizem pinturas com as tintas preparadas e que exponham os desenhos produzidos por eles.
Respostas
1. Resposta pessoal. O objetivo desta questão é identificar os conhecimentos prévios dos estudantes
SEPARAÇÃO DE MISTURAS
VAMOS INVESTIGAR
a ) Como você faria para produzir tintas coloridas utilizando cola escolar como base?
Resposta nas orientações ao professor
MATERIAIS NECESSÁRIOS
• cola escolar
• água
• beterraba
A. B. C.
• solo rico em argila marrom
• peneira
• 2 colheres de sopa
Peça a um adulto que rale, amasse e peneire metade da beterraba para obter o caldo. Em seguida, armazene-o.
Passe três colheres de solo pela peneira para retirar pequenas rochas e partes de plantas, deixando passar apenas os componentes mais finos.
Em um pote plástico, misture o caldo de beterraba à cola escolar. Para o solo peneirado, misture-o a meio copo de água e, em seguida, misture a água com solo a duas colheres de cola.
• copos descartáveis e potes plásticos para fazer as misturas e armazená-las
Dica: Para os pigmentos líquidos, adicione a cola escolar e misture. Para os pigmentos em pó, dissolva os pigmentos em água e, depois, adicione a cola. Utilize as colheres de sopa como medida.

Agora, responda às questões a seguir no caderno.
1. Você sabe como se chama o processo utilizado nos procedimentos A e B? Para que ele é utilizado?
2. Como a quantidade dos materiais utilizados no preparo das tintas modifica a cor delas?
3. As tintas preparadas podem ser classificadas como misturas homogêneas ou heterogêneas? Justifique sua resposta.
4. Após o preparo das tintas no procedimento D, em sua opinião, é possível separar os componentes da mistura?
Respostas nas orientações ao professor
sobre os processos de separação de misturas. Espera-se que eles respondam que o processo utilizado nos procedimentos A e B é a peneiração, empregada para separar partículas maiores e menores em misturas de sólidos ou separar partes sólidas das líquidas em uma mistura.
2. Resposta pessoal. Espera-se que os estudantes respondam que a quantidade de pigmento utilizado influencia a cor da tinta e percebam que, quanto mais pigmento, mais intensa fica a cor da tinta. Já aumentando a quantidade de água e de cola branca, a tinta fica mais diluída (líquida) e mais clara (menos intensa).
3. Misturas homogêneas, pois não é possível identificar seus componentes, principalmente em relação à água e à cola branca.
4. Resposta pessoal. O objetivo desta questão é levantar os conhecimentos prévios dos estudantes sobre os processos de separação de misturas. Comente que, no processo de secagem da tinta, ocorre a evaporação, na qual a água evapora e se separa do restante da mistura. No entanto, não podemos separar a cola dos pigmentos.
Tinta feita de solo.
Observe a cena a seguir.
Imagem com elementos sem proporção entre si. Cores fantasia.
1. Resposta pessoal. O objetivo desta questão é levantar os conhecimentos prévios dos estudantes sobre as técnicas de separação de misturas. Espera-se que eles mencionem que essas técnicas podem ser identificadas no suco sobre a mesa (A), no preparo do café (B), na centrifugação de roupas (C) e na secagem de roupas no varal (D).

suco sobre a mesa (A), café sendo preparado (B), máquina centrifugando roupas (C) e roupas secando no varal (D).
1. Em quais situações mostradas na cena estão sendo utilizadas técnicas de separação de misturas?
Como você estudou, há diferentes tipos de misturas e elas podem ser formadas por diversos componentes.
Porém, em algumas situações, precisamos separar alguns componentes das misturas, o que é possível por meio de técnicas de separação de misturas. Essas técnicas podem ser aplicadas em atividades do dia a dia em nossa moradia, nas indústrias e no tratamento de água e esgoto, por exemplo.
2. Cite uma etapa do tratamento de água que envolve a separação de misturas.
Colocar as roupas para secar no varal, centrifugar roupas em uma máquina de lavar, preparar café ou apenas deixar um suco de maracujá em repouso são ações que envolvem técnicas de separação de misturas.
Vamos estudar algumas dessas técnicas a seguir.
2. Resposta pessoal. Os estudantes podem citar a etapa de decantação ou a etapa de filtração, por exemplo.
• Pergunte o que aconteceria se o café não fosse filtrado ou se as aberturas do filtro fossem maiores. Espera-se que eles percebam que o filtro precisa reter o pó de café, deixando somente a bebida passar.
• Quando a roupa molhada passa pelo processo de centrifugação, questione-os sobre o que está sendo separado. Averigue se os estudantes compreendem que na centrifugação uma quantidade da água é separada do tecido. Pergunte se é o mesmo processo que acontece com a roupa que fica no varal. Verifique se eles percebem que, nesse caso, o processo envolvido é a evaporação.
ATIVIDADE EXTRA
01/10/2025 09:57:39
Antes de trabalhar o tema com os estudantes, apresente três misturas hipotéticas e liste-as na lousa. Mistura 1: água e óleo; mistura 2: resíduos recicláveis (latas, papéis amassados e garrafas plásticas); mistura 3: água e sal.
Pergunte-lhes como fariam para separar essas misturas. Anote as sugestões dos estudantes na lousa e peça que as copiem no caderno. Após o trabalho com o tema, instrua-os a retomar as respostas e a avaliar se mudariam suas ideias iniciais.
• O trabalho com o tema Separação de misturas contribui para o desenvolvimento da habilidade EF04CI01 , pois permite aos estudantes que identifiquem misturas no cotidiano. Também possibilita o desenvolvimento da habilidade EF04CI02 ao incentivá-los a observar as transformações nos materiais do dia a dia quando expostos a diferentes condições. Por abordar as mudanças reversíveis e irreversíveis que podem ocorrer com as misturas, também contempla a habilidade EF04CI03
• Peça aos estudantes que descrevam a ilustração apresentada nessa página e citem as atividades realizadas pelos integrantes da família e os processos que estão ocorrendo na lavandaria e no quintal da casa.
• Na lousa, liste as atividades retratadas na ilustração relacionadas à separação de misturas. Peça aos estudantes que expliquem por que essas situações se referem a separações de misturas.
• Averigue se eles percebem que, quando o suco de maracujá decanta na jarra, ocorre uma separação dos componentes mais densos do suco. Indague em quais sucos isso costuma ocorrer com mais frequência. Se possível, leve para a sala de aula um copo contendo suco de maracujá e deixe-o em repouso para mostrar a eles a decantação.
Representação de uma casa com destaque para algumas situações:
A. B.
C.
D.
• Explique aos estudantes que as separações de misturas apresentadas nessa página podem ser percebidas no cotidiano deles. Ressalte que alguns purificadores e filtros de água também contêm filtros em seu interior, os quais impedem que partículas de pequeno tamanho sejam consumidas.
• Peça aos estudantes que identifiquem, entre as etapas do tratamento da água que ocorrem nas estações de tratamento de água, as que correspondem às técnicas de filtração e de decantação. Solicite que representem no caderno, por meio de desenhos, cada uma dessas etapas e que elaborem textos explicativos sobre a finalidade de cada uma dessas técnicas no tratamento da água. Verifique se eles incluem nos textos a retirada de impurezas da água.
Para preparar um café, colocamos o pó de café no interior do filtro de papel e, em seguida, despejamos água aquecida sobre esse pó, cuidadosamente, formando uma mistura.
3. Reescreva o texto a seguir completando-o com as informações adequadas entre parênteses.

Pessoa preparando café.
Os componentes do pó de café que ■ (não se dissolveram/se dissolveram) na água aquecida ficaram retidos no filtro de papel. A água e os componentes do pó de café que ■ (não se dissolveram/se dissolveram) nela atravessaram o filtro de papel e foram coletados em um recipiente.
A técnica de separação de misturas utilizada no preparo do café é chamada filtração. Nela, a mistura passa por um filtro, e a maior parte dos componentes insolúveis em água, geralmente sólidos, fica retida no filtro, enquanto o restante da mistura o atravessa.
Agora, observe o suco de maracujá na fotografia. As sementes do maracujá não se dissolvem na água e vão se depositar no fundo do copo após certo tempo em repouso. Essa situação envolve uma técnica de separação de misturas chamada decantação
Ela pode ser utilizada, por exemplo, para separar componentes da mistura que não se dissolvem na água. Nessa técnica, a mistura é deixada em repouso e, após certo tempo, seus componentes se separam, flutuando ou se depositando no fundo do recipiente.
3. Resposta: Os componentes do pó de café que não se dissolveram na água aquecida ficaram retidos no filtro de papel. A água e os componentes do pó de café que se dissolveram nela atravessaram o filtro de papel e foram coletados em um recipiente.
Suco de maracujá.

4. Na preparação de chás, é feita a mistura das ervas com água aquecida em que é preciso aguardar alguns minutos para que ela fique pronta. Como se ingere apenas o líquido da mistura do chá, as ervas sólidas devem ser separadas do líquido. De que modo pode ser feita essa separação? Possíveis respostas: Filtração e peneiração.
BEBIDAS DE ERVA-MATE: MISTURAS TRADICIONAIS DO BRASIL
A erva-mate é uma planta bastante utilizada em bebidas tradicionais no Brasil. Entre elas, destacam-se o tereré e o chimarrão. O consumo dessas bebidas são heranças dos povos originários da América do Sul.
Os primeiros povos a consumir a infusão de erva-mate foram, provavelmente, os indígenas Guarani. Para consumi-la, eles utilizavam um recipiente feito de porongo e canudos feitos de taquara, chamados de tacuapi.
Em uma das extremidades do tacuapi eram feitos furos e trançados sobre eles, formando um tipo de filtro. Assim, ao sugar a bebida na outra extremidade do tacuapi, a erva era separada da mistura, permanecendo no porongo.

As cuias de porongo são utilizadas até hoje para o consumo das bebidas de erva-mate. Já os canudos costumam ser feitos com metal e são chamados de bomba.
As bebidas de erva-mate são consumidas em diversas regiões do Brasil.
No Rio Grande do Sul, por exemplo, a erva-mate tem grande valor cultural. O chimarrão, bebida muito consumida no estado, é uma infusão feita com erva-mate e água quente. Os gaúchos costumam consumir a bebida cotidianamente, inclusive em espaços públicos.
Outra bebida bastante consumida no Brasil, o tereré, é uma infusão feita de erva-mate moída grossa, com água fria ou gelada.

Além do valor histórico e cultural, a erva-mate faz parte da economia e da agricultura dos povos do Paraguai, do Brasil, do Uruguai e da Argentina.
Porongo: fruto da porongueira que quando seco pode ser utilizado como recipiente.
Taquara: planta de caules geralmente ocos também conhecida como bambu.
01/10/2025 10:51:25
BNCC
• Ao abordar as bebidas de erva-mate como herança dos povos indígenas e o chimarrão como manifestação cultural do povo gaúcho, essa seção colabora para o trabalho com os temas contemporâneos transversais Educação para valorização do multiculturalismo nas matrizes históricas e culturais brasileiras e Diversidade cultural, além de permitir o desenvolvimento da Competência geral 3
• Pergunte aos estudantes se já observaram o preparo de um chimarrão ou de um tereré. Peça a eles que comentem por que as bombas são utilizadas no consumo desse tipo de bebida. Verifique se mencionam que esse utensílio permite a separação dos componentes sólidos da mistura do líquido que é consumido. Se julgar pertinente, leve para a sala de aula uma bomba e uma cuia e as apresente à turma.
• Se julgar pertinente, comente que, em razão de sua importância histórica e cultural no Rio Grande do Sul, a erva-mate é reconhecida como patrimônio cultural imaterial do estado pelo Instituto do Patrimônio Histórico e Artístico do Estado (Iphae). Esse reconhecimento também valoriza o sistema de cultivo e a comercialização convencional da planta.
Gaúcho segurando cuia com chimarrão.
Tacuapis
ATIVIDADE EXTRA
Para investigar com os estudantes o processo de separação de misturas por evaporação, realizado nas salinas, coloque um prato em um local da escola que receba luz solar diretamente e, dentro dele, despeje uma mistura de água e sal. Mostre a eles como está o prato. Deixe-o nesse local até que toda a água evapore e, quando isso ocorrer, mostre a eles o que restou no prato. Espera-se que percebam que a água evaporou, restando apenas cristais de sal no fundo do prato. Relacione esse experimento ao processo de separação de misturas realizado nas salinas.
Esta atividade incentiva os estudantes a investigarem o processo de separação de misturas por evaporação por meio de procedimentos científicos, contribuindo para o desenvolvimento da Competência específica de Ciências da Natureza 2 da BNCC.
• Relacione a centrifugação apresentada nessa página à centrifugação realizada em algumas máquinas de lavar e centrífugas de roupas. Explique aos estudantes que, nesses equipamentos, a água é separada e retirada por tubos específicos que permitem sua saída. Já nos tubos de ensaio utilizados para separar os componentes do sangue, os elementos sólidos ficam no fundo do tubo, enquanto o plasma fica na parte superior.
5. Qual transformação ocorre com a água quando colocamos roupas para secar no varal?
Resposta pessoal. Espera-se que eles respondam que na secagem das roupas a água passa do estado líquido para o gasoso.
As roupas que penduramos no varal, após certo tempo, estão secas em decorrência da evaporação da água.
A evaporação é uma técnica de separação de misturas utilizada para separar tanto os componentes solúveis como os insolúveis em água.
Nessa técnica, a mistura é aquecida e a água evapora, separando-se do restante da mistura.
Nas salinas, a água do mar é encaminhada a tanques rasos que recebem luz solar diretamente. Após certo tempo, a água evapora, restando o sal, que é retirado do fundo do tanque.
Outra técnica que possibilita a separação de componentes sólidos e líquidos de uma mistura é a centrifugação

no município de Araruama, no Rio de Janeiro, em 2025.
Por meio dessa técnica, é possível retirar água das roupas e separar os componentes sólidos do sangue, como células e fragmentos celulares, da porção líquida (plasma). Confira a seguir como funciona a centrifugação do sangue.
Tubos contendo o sangue são colocados em um equipamento chamado centrífuga.

Na centrífuga, os tubos giram em alta velocidade, fazendo as células e os pedaços celulares se separarem do plasma.

plasma células sanguíneas
Salinas
Pessoa segurando tubo com sangue humano próximo a uma centrífuga.
Pessoa segurando tubos com sangue humano centrifugado.
Algumas plantas produzem óleos durante o desenvolvimento, os quais, em muitos casos, são responsáveis pelo aroma delas.
Muitos desses óleos são utilizados pela indústria farmacêutica, de cosméticos e de perfumaria.
Para a extração dos óleos de uma planta, como a lavanda, utiliza-se uma técnica de separação de misturas chamada destilação. Acompanhe a seguir.
Técnica de destilação simples
Lavanda: pode atingir cerca de 2 m de altura.


Representação da técnica de destilação simples.
A mistura é aquecida em um recipiente.
Imagem com elementos sem proporção entre si. Cores fantasia.
• Ao abordar a produção de óleo por algumas plantas, como a lavanda, ressalte que o óleo dela é extraído das folhas e das inflorescências, um conjunto de flores agrupadas e sustentadas por um ramo comum da planta.
• Retome as mudanças de estados físicos da matéria. Relembre aos estudantes que, quando um material passa do estado líquido para o gasoso, ocorre a vaporização e, quando há a passagem do estado gasoso para o líquido, ocorre a condensação. Peça que identifiquem em que parte da destilação essas mudanças de estado físico ocorrem.
Fonte de pesquisa: BROWN, Theodore L. et al Química: a ciência central. Tradução de Eloiza Lopes, Tiago Jonas e Sonia Midori Yamamoto. 13. ed. São Paulo: Pearson Education do Brasil, 2016. p. 13.
O componente da mistura com menor ponto de ebulição evapora e passa para o condensador.
No condensador, o vapor resfria e condensa, retornando ao estado líquido.
O líquido é, então, armazenado no recipiente coletor.
A destilação é empregada, principalmente, para separar componentes sólidos e líquidos de misturas homogêneas.
INFOGRÁFICO CLICÁVEL: DESTILAÇÃO DO PETRÓLEO
01/10/2025 10:51:28
Plantação de lavanda para extração de óleo no município de Nova Petrópolis, no Rio Grande do Sul, em 2022.
• Caso julgue pertinente, ao abordar a físico-química húngara Mária Telkes (19001995), comente que ela foi reconhecida por suas invenções com o uso da energia solar em uma época em que essa tecnologia ainda era pouco explorada. Uma de suas invenções mais lembradas é a construção de um sistema de aquecimento solar para uma residência construída por ela com a arquiteta Eleanor Raymond (1887-1989).
• Explique que as separações de misturas apresentadas nessa página podem ser percebidas no cotidiano dos estudantes. Mostre que o processo de catação pode ser utilizado para arroz ou feijão, quando os grãos são separados de impurezas antes do cozimento.
• Para complementar o conceito de catação, leve para a sala de aula grãos de arroz, feijão e milho. Organize a turma em grupos de três estudantes. Misture os grãos e distribua um punhado deles para cada grupo. Peça a eles que separem todos os elementos da mistura. Pergunte também se alguma das outras técnicas estudadas até o momento poderia ter sido utilizada. Por fim, peça que justifiquem suas respostas, ou seja, que expliquem por que apenas a técnica da catação é apropriada para fazer a separação dos componentes da mistura.
Resposta
7. b) Resposta pessoal. Os estudantes podem mencionar que o descarte incorreto de resíduos sólidos pode, por exemplo, causar o entupimento de bueiros e agravar alagamentos. Eles podem também mencionar que os resíduos sólidos descartados inadequadamente podem acumular água, contribuindo para a proliferação de mosquitos vetores de doenças. Além disso, podem citar a poluição do solo e da água pelos resíduos sólidos.
6. A físico-química húngara Mária Telkes (1900-1995) é reconhecida por suas invenções de dispositivos movidos a energia solar. Uma de suas invenções mais importantes foi um dispositivo capaz de transformar a água do mar em água própria para o consumo. O equipamento utilizava a energia solar para vaporizar a água do mar e, em seguida, condensá-la, permitindo seu uso.
Mária Telkes (1900-1995), 1956

a ) Qual técnica de separação de misturas permitiria separar o sal da água do mar e, em seguida, reaproveitar a água obtida, tal qual o dispositivo criado por Mária Telkes?
Resposta: Destilação.
b ) Que outra técnica pode ser utilizada para separar o sal da água do mar?
Resposta: Evaporação.
A retirada das impurezas do feijão antes de seu cozimento pode ser realizada pela técnica de separação de misturas chamada de catação. Essa técnica permite separar os componentes de misturas heterogêneas sólidas e pode ser realizada com as mãos, com uma colher ou com uma pinça, por exemplo.
7. Nas cooperativas de reciclagem, os resíduos sólidos podem ser separados manualmente pelo tipo de material ou pela cor.
a ) Qual é a técnica de separação de misturas utilizada nesse processo?
Resposta: Catação.
b ) Qual é a importância de dar destinação adequada aos resíduos sólidos?
Resposta nas orientações ao professor.
Trabalhadores realizando a triagem de resíduos sólidos em uma cooperativa no município de Ubatuba, em São Paulo, em 2024.


Pessoa separando feijão com as mãos.
DANOS AMBIENTAIS CAUSADOS POR MISTURAS
O descarte inadequado de resíduos sólidos e de esgoto, tanto doméstico como industrial, pode causar diversos problemas ambientais. Isso ocorre porque esses resíduos contêm restos de alimentos, plásticos, metais, substâncias como detergentes, tinturas e óleos, entre outros materiais que, ao atingirem os corpos de água, poluem esses locais.

Quando o esgoto sem tratamento é descartado no ambiente, pode diminuir a quantidade de gás oxigênio da água, causar a proliferação de algas, a morte de animais e aumentar a propagação de agentes causadores de doenças.
B.
O resíduo sólido doméstico descartado incorretamente pode atingir os corpos de água e acumular-se neles.
Diversas ações devem ser tomadas em conjunto para recuperar os corpos de água poluídos. Uma delas é eliminar as causas da poluição, ou seja, evitar o descarte incorreto de resíduos sólidos e de esgoto. Outra ação é coletar e tratar o esgoto.
Os resíduos sólidos que estão em rios e lagos podem ser retirados, por exemplo, por dragagem. A dragagem consiste em usar bombas de sucção para retirar a sujeira que se acumula no fundo do rio. Além da dragagem, a limpeza dos rios e lagos também pode ser feita com a instalação de barreiras flutuantes. Essas barreias ajudam a conter resíduos sólidos que estão na superfície da água para que sejam retirados do corpo de água.

• O trabalho com a conscientização socioambiental permite o desenvolvimento da Competência geral 7, das Competências específicas de Ciências da Natureza 3 e 8 e do tema contemporâneo transversal Educação ambiental, bem como a análise crítica sobre os problemas ambientais e como eles afetam os ecossistemas e a saúde humana.
• Ao abordar o assunto dessa seção, enfatize que nem toda mistura causa danos à água, mas que o lançamento de resíduos em rios, lagos e mares pode causar grandes prejuízos. A partir do momento em que resíduos são misturados à água, diversos seres vivos podem ser afetados, além de ser um crime ambiental.
• Aproveite o assunto para mostrar aos estudantes a importância da conservação dos recursos naturais e da fiscalização do lançamento de resíduos nos corpos de água.
• Incentive a reflexão da turma sobre a importância dos serviços de saneamento básico, como o tratamento de esgoto e o manejo e a coleta dos resíduos sólidos, para que danos ambientais sejam evitados.
01/10/2025 10:51:33
A.
Despejo irregular de esgoto e de resíduos sólidos em um corpo de água na cidade do Rio de Janeiro, em 2021.
Barreira flutuante em rio da cidade de Porto Alegre, no Rio Grande do Sul, em 2020.
• Solicite aos estudantes que citem outras técnicas do cotidiano que empregam a peneiração, promovendo o engajamento deles no estudo do tema e possibilitando-lhes que identifiquem técnicas de separação de misturas no dia a dia. Caso tenham dificuldade em citar exemplos, comente que a peneiração é muito utilizada na cozinha.
AVALIANDO
Objetivo
• A atividade 8 permite avaliar se os estudantes conseguem identificar métodos de separação de misturas que possibilitem fazer a separação de dois componentes sólidos com características diferentes.
Sugestão de intervenção
Conduza uma discussão com os estudantes sobre como cada uma das alternativas funcionaria para separar o arroz do feijão. Caso questionem sobre o processo de peneiração, explique que se trata de uma técnica que pode ser utilizada para separar misturas entre sólidos ou entre sólidos e líquidos, dependendo do tamanho dos componentes e das aberturas da peneira.
ATIVIDADE EXTRA
Organize uma Feira de Ciências como culminância do estudo desta unidade. Proponha aos estudantes a construção de maquetes que representem os serviços de saneamento básico, como as estações de tratamento de água e de esgoto e os aterros sanitários. Eles também podem incluir áreas urbanas e rurais nas maquetes para representar os serviços de coleta de resíduos sólidos, incluindo a coleta seletiva, e a infraestrutura para coleta de águas pluviais. Providencie materiais necessários para a construção da maquete, como poliestireno expandi-
No preparo do cimento, é utilizada a técnica de separação de misturas chamada peneiração. Essa técnica pode ser utilizada para separar componentes de diferentes tamanhos de uma mistura sólida. Nesse caso, ao passar a mistura pela peneira, os componentes de tamanho menor atravessam os orifícios enquanto os componentes de tamanho maior ficam retidos na peneira.
A separação dos componentes da mistura dependerá do tamanho de cada um deles e do tamanho dos orifícios da peneira utilizada.
A peneiração também pode ser utilizada para separar sólidos que não se dissolvem em uma mistura líquida. Nesse caso, os componentes sólidos devem ser maiores que os orifícios da peneira. Assim, ao peneirar a mistura, o líquido e os componentes dissolvidos nele passarão pela peneira e os componentes sólidos ficarão retidos nela.
8. Quais das técnicas de separação a seguir poderiam ser utilizadas para separar os componentes da mistura mostrada na fotografia?
A. B. C.
D.
Peneiração.
Centrifugação.
Filtração.
Catação.



Dependendo do tipo de mistura e das substâncias envolvidas, algumas técnicas de separação de misturas não são eficientes. Por exemplo, para separar os componentes de uma mistura de água e sal, não podemos usar a decantação ou a filtração.
8. Resposta: A: peneiração; D: catação. A peneiração da mistura de arroz e feijão pode ser feita desde que a peneira tenha furos maiores do que os grãos de arroz e menores do que os grãos de feijão.
do, palitos de madeira, cola escolar, tesoura com pontas arredondadas, lápis de cor, pequenas caixas de papelão e papel crepom. Oriente-os a elaborar legendas, explicando os serviços de saneamento e incluindo as técnicas de separação de misturas utilizadas, por exemplo, no tratamento da água e do esgoto ou na separação de materiais recicláveis. Organize junto à escola um dia para que os estudantes exponham o trabalho desenvolvido nesta atividade para a comunidade. Oriente-os a explicar aos visitantes a importância dos serviços de saneamento para o meio ambiente e para a saúde da população. As maquetes auxiliam na percepção tridimen-
sional dos espaços por pessoas com deficiência visual. A fim de promover a inclusão, providencie materiais com diferentes texturas para a confecção das maquetes. Leia sobre algumas possibilidades de materiais no artigo Maquetes e mapas táteis: diretrizes para projeto, seleção de materiais e técnicas. Disponível em: https:// app.periodikos.com.br/journal/abergo/article/ 627a562ea953950cd955f623. Acesso em: 18 ago. 2025.
Pessoa peneirando areia.
Pessoa peneirando maracujá.
Mistura de grãos crus de arroz e feijão.
Escreva as respostas no caderno.
VAMOS AVALIAR O APRENDIZADO
1. Analise o gráfico a seguir.
População atendida com rede de abastecimento de água e rede coletora de esgoto por região do Brasil (2023)
População atendida com rede de abastecimento de água
População atendida com rede coletora de esgoto
Fontes de pesquisa: BRASIL. Ministério das Cidades. Secretaria Nacional de Saneamento ambiental; SISTEMA NACIONAL DE INFORMAÇÕES EM SANEAMENTO BÁSICO. Relatório dos serviços de abastecimento de água. Brasília, 2024. Disponível em: https://www.gov.br/cidades/pt-br/acesso-a-informacao/acoes -e-programas/saneamento/sinisa/resultados-sinisa/RELATORIO_SINISA_ABASTECIMENTO_DE_AGUA_2024.pdf. Acesso em: 6 maio 2025. BRASIL. Ministério das Cidades. Secretaria Nacional de Saneamento ambiental; SISTEMA NACIONAL DE INFORMAÇÕES EM SANEAMENTO BÁSICO. Relatório dos serviços de esgotamento sanitário. Brasília, 2024. Disponível em: https://www.gov.br/cidades/pt-br/acesso-a-informacao/acoes-e-programas/saneamento/sinisa/ resultados-sinisa/RELATORIO_SINISA_ESGOTAMENTO_SANITARIO_2024.pdf. Acesso em: 6 maio 2025.
a ) Observando o gráfico anterior, o que você conclui sobre o acesso aos serviços de abastecimento de água e de coleta e tratamento de esgoto nas diferentes regiões do Brasil?
Resposta nas orientações ao professor
b ) Qual é a importância de garantir o acesso aos serviços de saneamento básico para a saúde da população brasileira?
c ) Quais das doenças citadas a seguir estão relacionadas à falta de saneamento básico?
• câncer
• cólera
• caxumba
Resposta: Leptospirose, cólera, giardíase, amebíase e febre tifoide.
• varicela
• hipertensão arterial
• leptospirose
• giardíase
• febre tifoide
• amebíase
1. b) Resposta pessoal. Espera-se que os estudantes comentem que o acesso aos serviços de saneamento básico são fundamentais para evitar uma série de doenças.
No item b, caso os estudantes não consigam relacionar os serviços de saneamento básico à prevenção de doenças, peça a eles que retomem a leitura do trecho de reportagem da página 101
No item c, caso os estudantes tenham dificuldade em reconhecer as doenças relacionadas à falta de saneamento básico, leve-os ao laboratório de informática e solicite que realizem uma pesquisa sobre cada doença listada. Oriente-os a identificar se são doenças transmissíveis ou não transmissíveis. No caso das doenças transmissíveis, comente que devem
pesquisar o agente causador e o modo de transmissão da doença e, em seguida, avaliar se a falta de acesso aos serviços de saneamento básico favorece a disseminação dessas doenças.
Resposta 1. a) O objetivo desta questão é levar os estudantes a analisarem o gráfico. Espera-se que eles comentem que os serviços de abastecimento de água e de coleta e tratamento de esgoto não são garantidos à toda população brasileira e variam entre as regiões do Brasil, sendo a Região Sudeste a que apresenta maior
1. Objetivos
• Identificar qual parte da população brasileira não tem acesso a alguns serviços de saneamento básico.
• Reconhecer a importância dos serviços de saneamento básico para a saúde do ser humano.
• Identificar doenças relacionadas à falta de saneamento básico.
Sugestão de intervenção
No item a, caso os estudantes não identifiquem qual parte da população brasileira não tem acesso aos serviços de saneamento básico abordados, solicite que representem as porcentagens do gráfico em malhas quadriculadas. Para isso, forneça a malha quadriculada e peça que, para cada região do país, delimitem dois quadrados de 10 × 10 unidades. Para representar os dados relativos à Região Norte, por exemplo, solicite aos estudantes que pintem de azul 71 quadrados referentes à população abastecida com água tratada e 23 quadrados de laranja para representar a população com acesso à coleta e tratamento de esgoto. Verifique se percebem que a porção em branco do quadrado representa a parcela da população sem acesso aos serviços de saneamento básico abordados e peça que identifiquem, para cada serviço, quais regiões do país ficaram com mais quadrados sem pintar.
01/10/2025 10:51:37
porcentagem da população com acesso a esses serviços e a Região Norte a com menor porcentagem da população atendida por ambos os serviços.
BNCC
• A questão 1 colabora para o desenvolvimento da habilidade EF04CI08, pois permite aos estudantes que identifiquem a importância do acesso aos serviços de saneamento básico para a prevenção de doenças.
Norte Sul Nordeste Sudeste Centro-Oeste
2. Objetivos
• Diferenciar água não tratada e imprópria para o consumo humano de água tratada.
• Reconhecer a importância do tratamento da água para a eliminação de impurezas.
Sugestão de intervenção
Se os estudantes tiverem dificuldade para responder ao item a, questione-os sobre a importância do tratamento da água. Verifique se consideram que as etapas do tratamento da água eliminam a maior parte das impurezas dela.
Com base nas respostas dos estudantes, peça que avaliem as características visíveis das duas amostras e que respondam novamente à questão a.
No item b, caso tenham dificuldade, questione os estudantes sobre as principais etapas de tratamento de água e sua importância. Se julgar pertinente, peça a eles que retomem o esquema da página 104 e identifiquem processos associados à eliminação de impurezas da água e de microrganismos. Retome os resultados que obtiveram ao realizarem a atividade prática das páginas 102 e 103
3. Objetivo
• Reconhecer as atividades relacionadas aos serviços de saneamento básico.
Sugestão de intervenção
Caso os estudantes tenham dificuldade em reescrever as frases utilizando as palavras adequadas, oriente-os a compor um mapa conceitual dos serviços de saneamento básico. Oriente-os a utilizar cores diferentes para destacar conceitos-chaves sobre cada serviço. Se julgar perti-
2. Observe as amostras de água a seguir.
2. a) Resposta pessoal. Espera-se que os estudantes respondam que o copo B passou por um tratamento, pois, aparentemente, está com água limpa, livre de partículas.


a ) Qual das amostras passou por um tratamento?
b ) O que pode ser feito com a amostra de água do outro copo para eliminar ou reduzir suas impurezas? Converse com os colegas sobre esse assunto.
Resposta: A amostra de água deve passar por algum tipo de tratamento, como a filtração e a desinfecção, para eliminar as partículas e os microrganismos prejudiciais à saúde humana.
3. Reescreva as frases a seguir utilizando a palavra ou expressão do quadro que completa adequadamente cada uma delas.
fossas sépticas • coleta seletiva • fluoretação chorume • coleta comum • aterros sanitários
a ) A ■ recolhe materiais que podem ser reciclados.
Resposta: A coleta seletiva recolhe materiais que podem ser reciclados.
b ) Os ■ são locais adequados à deposição dos resíduos sólidos.
Resposta: Os aterros sanitários são locais adequados à deposição dos resíduos sólidos.
c ) Os resíduos que não podem ser reciclados são separados para a ■.
Resposta: Os resíduos que não podem ser reciclados são separados para a coleta comum.
d ) O ■ é um líquido formado pela decomposição da matéria orgânica.
Resposta: O chorume é um líquido formado pela decomposição da matéria orgânica.
e ) Na etapa de ■ que ocorre nas ETAs, a água recebe flúor.
Resposta: Na etapa de fluoretação que ocorre nas ETAs, a água recebe flúor.
f ) As ■ são unidades de tratamento de esgoto doméstico compostas de tanques subterrâneos revestidos. Professor, professora: As legendas das imagens não foram inseridas para não comprometerem a realização da atividade.
Resposta: As fossas sépticas são
unidades de tratamento de esgoto doméstico compostas de tanques subterrâneos revestidos.
nente, após a confecção dos mapas conceituais pelos estudantes, peça a eles que compartilhem com a turma os registros. Anote os conceitos levantados e relatados por eles na lousa para que possam consultar.
4. Observe a fotografia a seguir.
a ) A salada de frutas pode ser considerada uma mistura? Justifique sua resposta.
Resposta: Sim, pois é formada por diferentes componentes, nesse caso, diferentes frutas.
b ) Caso sua resposta ao item a tenha sido afirmativa, essa mistura é homogênea ou heterogênea? Justifique sua resposta.
Resposta: Heterogênea, pois é possível identificar visualmente os componentes.

Salada de frutas.
5. Observe, nas imagens a seguir, os diferentes tipos de misturas preparadas e identifique-as como homogênea ou heterogênea.
A: água + álcool

Preparo da mistura de água e álcool.

Mistura de água e álcool.
Mistura C: água + óleo

Preparo da mistura de água e óleo.

Mistura de água e óleo.
B: água + areia

Preparo da mistura de água e areia.

Mistura de água e areia.
Mistura D: água + açúcar

Preparo da mistura de água e açúcar.

Mistura de água e açúcar.
Resposta: A: homogênea; B: heterogênea; C: heterogênea; D: homogênea.
Classificação de diferentes misturas
MisturaComponentes Número de fases Heterogênea ou Homogênea
Mistura A
Mistura B
Mistura C
Mistura D
MODELO
Em seguida, peça aos estudantes que adicionem outras misturas trabalhadas ao longo da unidade na coluna “Mistura”, como o soro
01/10/2025 10:51:52
caseiro, a granola e o suco de laranja com gelo, e que preencham o quadro com as demais informações, solicitadas no quadro, sobre essas misturas.
BNCC
• As atividades 4 e 5 colaboram para o desenvolvimento da habilidade EF04CI01 ao levarem os estudantes a reconhecerem misturas e suas propriedades físicas observáveis.
4. Objetivos
• Reconhecer o que são misturas.
• Identificar uma mistura de sólidos.
Sugestão de intervenção
Caso eles apresentem alguma dificuldade para a resolução desta atividade, questione-os sobre o que entendem por misturas. Com base nessas respostas, pergunte-lhes quais ingredientes foram usados para preparar a salada de frutas. No item b, pergunte-lhes se é possível identificar os diferentes ingredientes da salada de frutas. Depois, peça que expliquem o que são misturas homogêneas e heterogêneas. Solicite aos estudantes que representem no caderno, por meio de desenhos, algumas misturas e que, em seguida, as classifiquem em homogêneas ou heterogêneas, justificando os critérios utilizados para isso.
5. Objetivo
• Diferenciar misturas homogêneas de misturas heterogêneas.
Sugestão de intervenção
Reproduza na lousa o quadro a seguir e peça aos estudantes que o copiem no caderno e o completem, complementando-o com informações sobre os componentes de cada mistura, a quantidade de fases visíveis em cada uma delas e a classificação em mistura homogênea ou heterogênea.
Mistura
Mistura
6. Objetivo
• Identificar métodos de separação de misturas que possibilitem separar componentes sólidos de uma mistura.
Sugestão de intervenção
Leve para a sala de aula alguns materiais, como porcas, serragem, ímã, ventilador e luvas de limpeza. Misture as porcas com a serragem e pergunte aos estudantes como poderiam utilizar o ímã, o ventilador e as luvas para separar os componentes da mistura e em que ordem o fariam. Explique-lhes que o ventilador auxilia em uma técnica conhecida como ventilação, em que materiais menos densos podem ser levados pelo ar em movimento. Como exemplo de ventilação, mencione que, quando descascamos amendoins, podemos soprá-los para que as cascas sejam levadas, restando somente as sementes. Nesta atividade, também é abordada a separação magnética, que necessita do uso de ímãs. Nesse caso, o ímã atrai objetos metálicos que estão na mistura, separando-os dos demais componentes.
7. Objetivo
• Identificar atitudes e medidas adequadas à prevenção de doenças.
Sugestão de intervenção
Escreva na lousa os nomes de algumas doenças transmitidas por água e alimentos contaminados, como a giardíase e a amebíase. Solicite aos estudantes que identifiquem o agente causador dessas doenças e como elas podem ser transmitidas. Se necessário, oriente-os a reler a página 111. Depois de identificado que as pessoas podem se infectar ao ingerir água e alimentos contaminados com os microrganismos causadores dessas doenças, pergunte a eles quais letras
6. Após terminar seu trabalho, um carpinteiro se deparou com os parafusos e pregos misturados a lascas de madeira. Sabendo que o carpinteiro tem à disposição os três objetos a seguir, associe as imagens a como ele poderia utilizar cada um deles para separar os parafusos e pregos das lascas de madeira.


Parafusos e pregos misturados a lascas de madeira.
Imagens sem proporção entre si.


Luvas de proteção.
Ventilador. Ímã. Luvas de proteção. Pode ser utilizado para atrair os pregos e parafusos, separando-os das lascas de madeira.
2. 3.
Podem ser vestidas para fazer a catação.
Pode ser utilizado para “soprar” as lascas de madeira, separando-as dos pregos e parafusos. 1.
Resposta: A – 3; B – 1; C – 2.
7. A professora de Alice escreveu na lousa cinco ações. Algumas delas podem contribuir para a prevenção de doenças.
A. B. C. D. E.
Armazenar água em cisternas.
Ferver água antes de consumi-la.
Beber água filtrada e tratada com cloro. Beber soro caseiro.
Fazer a sanitização de frutas e verduras com hipoclorito de sódio.
Escreva no caderno as letras das ações que contribuem para a prevenção de doenças.
Resposta: B, C e E
representam medidas capazes de eliminar o microrganismo da água ou dos alimentos. Leia e discuta cada uma das ações listadas. Caso os estudantes identifiquem o armazenamento da água em cisternas como medida preventiva, lembre-os de que a água armazenada nesses reservatórios é geralmente utilizada para atividades como limpeza ou irrigação de hortas e não é adequada para consumo, pois não passa por tratamento. Se indicarem a ingestão do soro caseiro, pergunte se essa medida é utilizada para tratamento ou para prevenção de doenças. Se necessário, esclareça que o soro é utilizado no tratamento de doenças, para evitar a
desidratação, mas não é uma medida adequada para prevenção de doenças.
BNCC
• A atividade 7 colabora para o desenvolvimento da habilidade EF04CI08, pois permite aos estudantes que identifiquem atitudes e medidas adequadas à prevenção de doenças causadas por microrganismos.
A.
B.
C.
Ventilador.
3. a) Resposta: Mistura A: Os estudantes podem citar as técnicas de evaporação e destilação; mistura F: Os estudantes podem citar a catação
VAMOS CONCLUIR
Escreva as respostas no caderno.
e a peneiração (desde que os poros da peneira permitam a passagem de apenas um dos componentes da mistura).
1. Identifique, entre os objetos a seguir, aqueles que podem ser utilizados para determinar as direções geográficas Norte, Sul, Leste e Oeste.


Resposta: Gnômon e bússola.

Imagens sem proporção entre si.
a ) Além dos objetos identificados por você anteriormente, cite outras maneiras de orientar-se geograficamente.
Resposta: Os estudantes podem
citar o Sistema de Posicionamento Global (GPS) e a orientação com base nas constelações.
2. No caderno, associe os fenômenos, representados pelas letras, aos movimentos que são responsáveis pela sua ocorrência, representados pelos números.
Resposta: A – 3; B – 1; C – 2.
Estações do ano. A.
Períodos do dia. B.
Fases da Lua. C.
Resposta: Misturas homogêneas: A, C, D, E; misturas heterogêneas: B, F.
Rotação da Terra. 1.
Movimento cíclico da Lua.
Translação da Terra associada à inclinação do seu eixo imaginário.
3. No caderno, classifique as misturas a seguir em homogênea ou heterogênea. Água com sal. Óleo com vinagre. Gasolina.
Água e álcool.
Suco de manga. Feijão com arroz.
a ) Como você poderia separar os componentes das misturas A e F?
4. No caderno, classifique as transformações representadas nas imagens a seguir em: físicas ou químicas; reversíveis ou irreversíveis.



Resposta: A: química e irreversível; B: física e irreversível; C: física e reversível.
2. Objetivo
• Relacionar os movimentos da Terra e da Lua à ocorrência de fenômenos regulares.
Sugestão de intervenção
Realize uma simulação dos movimentos da Terra. Com uma lanterna e duas bolas de poliestireno expandido (ou algum material plástico), simule os efeitos do Sol sobre a Terra à medida que ela gira em seu eixo e ao redor do Sol, assim como o ciclo Lunar e suas diferentes fases.
3. Objetivo
• Identificar diferentes tipos de misturas e técnicas adequadas para a separação dos componentes de uma mistura.
Sugestão de intervenção
Leve para a sala de aula um copo com água e um pouco de sal e óleo. Solicite que os estudantes observem que, ao misturar o sal e a água, não há mais distinção entre os dois componentes, ou seja, formou-se uma mistura homogênea. No entanto, ao adicionar o óleo, verifica-se que ele não se dissolve, formando uma mistura heterogênea. Caso os estudantes tenham dificuldade em responder ao item a, solicite que retomem o conteúdo das páginas 130, 131, 132 e 134
BNCC
• A atividade 1 permite que os estudantes reconheçam instrumentos que possibilitam orientação geográfica, relacionando o conteúdo com as habilidades EF04CI09 e EF04CI10.
• A atividade 2 possibilita associar os movimentos da Terra e da Lua aos fenômenos regulares, colaborando para o desenvolvimento da habilidade EF04CI11
• A atividade 3 incentiva os estudantes a reconhecerem características das misturas, desenvolvendo a habilidade EF04CI01
• A atividade 4 possibilita o reconhecimento da reversibilidade de algumas transformações, permitindo o trabalho com a habilidade EF04CI03
1. Objetivo
• Identificar instrumentos e maneiras de se orientar geograficamente. Sugestão de intervenção
Caso os estudantes tenham dificuldade em identificar os instrumentos que permitem a orientação geográfica, retome com eles a atividade prática das páginas 16 e 17. No item a, questione-os sobre as maneiras de se orientar geograficamente, no presente e no passado, para navegar. Verifique se eles mencionam o GPS e a orientação com base nas constelações.
4. Objetivo
01/10/2025 10:59:23
• Reconhecer transformações físicas e químicas e sua reversibilidade.
Sugestão de intervenção
Conceitue brevemente o que é uma transformação química e o que é uma transformação física. Depois, oriente os estudantes a classificarem cada uma das transformações da atividade em física e química. Para auxiliá-los a reconhecer a reversibilidade das transformações, aborde cada uma delas. Por exemplo, pergunte: “É possível fazer o ovo frito voltar a ser cru?”. Repita o processo com as transformações dos itens B e C.
Gnômon.
Ovo fritando em frigideira. Copo de vidro quebrado. Gelo em um congelador.
Bússola. Relógio.
BNCC
• A atividade 5 incentiva os estudantes a comporem uma cadeia alimentar, reconhecendo a posição dos seres vivos nela, o que colabora para o desenvolvimento da habilidade EF04CI04
• A atividade 6 leva à identificação de determinados microrganismos ao analisar algumas de suas características, desenvolvendo as habilidades EF04CI06, EF04CI07 e EF04CI08
5. Objetivo
• Reconhecer as relações tróficas entre os seres vivos e compor uma cadeia alimentar.
Sugestão de intervenção
Retome com os estudantes os conceitos de fotossíntese e de produtor. Depois, pergunte quais dos seres vivos mostrados se encaixa nessa definição e verifique se eles identificam o capim. Pergunte também qual dos outros seres vivos se alimenta de capim e qual se alimenta do animal que consome o capim, assim será possível reconhecer os consumidores primário e secundário. No item a, se julgar interessante, aborde com os estudantes situações de desequilíbrio ambiental envolvendo cadeias alimentares como as nuvens de gafanhotos e a destruição de lavouras. Se julgar pertinente, leia com eles trechos do texto indicado a seguir sobre esse assunto. COMUNELLO, Éder; ÁVILA, Crébio José; MARTINS, Celso de Souza. A ameaça das nuvens de gafanhotos em Mato Grosso do Sul. Embrapa, 21 jul. 2020. Disponível em: https://www.embrapa.br/ en/busca-de-noticias/-/ noticia/54381260/ artigo---a-ameaca -das-nuvens-de-gafanhotos-em-mato-grosso -do-sul. Acesso em: 21 ago. 2025.
Resposta
5. No caderno, construa uma cadeia alimentar com todos os seres vivos mostrados nas imagens a seguir. Em seguida, identifique os produtores e consumidores da cadeia alimentar formada.
Anu-branco: pode atingir cerca de 38 cm de comprimento.

Anu-branco.
Gafanhoto: pode atingir cerca de 5 cm de comprimento.

Gafanhoto.
Resposta nas orientações ao professor
Capim: tamanho pode variar de acordo com a espécie.


Seres vivos decompositores. Imagem ampliada cerca de 1 300 vezes e colorida em computador.
a ) O que aconteceria nessa cadeia alimentar se a população de anu-branco fosse reduzida?
Resposta: Espera-se que os estudantes respondam que a
população de gafanhoto aumentaria, e isso poderia reduzir a população de capim.
6. Reescreva as frases a seguir no caderno, completando-as com uma das seguintes palavras: bactérias, fungos, vírus ou protozoários.
a ) Algumas ■ participam como decompositoras nos ecossistemas, e outras estão presentes no nosso intestino auxiliando na digestão.
Resposta: Bactérias.
b ) Os ■ são responsáveis por causar doenças como a COVID-19 e o sarampo. Essas doenças podem ser prevenidas pela vacinação.
Resposta: Vírus.
c ) A maioria dos ■ são de vida livre, e alguns podem causar doenças, como a malária e a doença de chagas.
Resposta: Protozoários.
d ) Alguns ■ atuam como decompositores nos ecossistemas, e outros são utilizados na produção de pães e queijos. Além disso, alguns deles podem causar doenças, como as micoses.
Resposta: Fungos.
6. Objetivo
• Identificar e diferenciar grupos de microrganismos.
Sugestão de intervenção
Faça um quadro na lousa intitulando as colunas com os nomes dos grupos de microrganismos estudados: bactérias, fungos, protozoários
5. Os estudantes devem representar: capim gafanhoto anu-branco, assim como setas partindo do capim, do gafanhoto e do anu-branco em direção aos seres vivos decompositores. Espera-se que eles reconheçam como produtor o capim, como consumidor primário o gafanhoto e como consumidor secundário o anu-branco.
e vírus. Oriente os estudantes a listarem as características de cada um desses microrganismos, como uso e benefícios para o ser humano, relação com outros seres vivos e com o ambiente, doenças causadas por eles e modo de prevenção dessas doenças. Acolha as respostas deles, anotando-as na lousa, e corrija eventuais equívocos. Quando julgar que o quadro tem informações suficientes, realize a atividade com eles. Leia as sentenças e, com base no quadro, solicite que identifiquem o microrganismo em questão.
Capim.
SELMA CAPARROZ BARROS/SHUTTERSTOCK.COM
SAIBA MAIS
A seguir, apresentamos sugestões para você ampliar seus conhecimentos sobre os temas abordados ao longo deste volume. Aproveite a oportunidade para interagir com os seus familiares!
Terra: nossa grande casa
“Por que ocorrem dia e noite na Terra?”; “Por que existem diferentes estações no ano na Terra?”; “Por que cuidar do nosso planeta e preservar os recursos naturais são importantes?”. Nesse livro, você encontra a resposta para essas e outras questões relacionadas à Terra.
TERRA: a nossa grande casa. São Paulo: On Line, 2023. (Coleção Vamos Salvar o Planeta).
Nos trilhos da Ciência : uma história dos cientistas
Oswaldo Cruz e Calos chagas
Nesse livro, você vai conhecer sobre dois importantes cientistas: Oswaldo Cruz e Carlos Chagas; e suas contribuições para a saúde no Brasil. Você também pode realizar a leitura desse livro de forma interativa acessando o site a seguir.
OLIVEIRA, Claudia. Nos trilhos da Ciência: uma história dos cientistas Oswaldo Cruz e Carlos Chagas. Disponível em: https:// museudavida.fiocruz.br/nostrilhosdaciencia/. Acesso em: 22 set. 2025.


OLIVEIRA, Claudia. Nos trilhos da Ciência: uma história dos cientistas Oswaldo Cruz e Carlos Chagas. Rio de Janeiro: Fiocruz, 2019.
Exposição “Aedes: que mosquito é esse?”
Você seria capaz de identificar possíveis criadouros do Aedes aegypti? Conheça esses locais e obtenha mais informações a respeito do Aedes aegypti e sobre e as doenças que ele pode transmitir por meio da visita virtual a uma exposição sobre o tema.
AEDES: que mosquito é esse? Era virtual. Disponível em: https://www.eravirtual.org/aedes/. Acesso em: 8 ago. 2025.
• A seção Saiba mais oferece sugestões para ampliar os conhecimentos dos estudantes que podem estar relacionadas ao conteúdo ou a contextos trabalhados no volume, além de temas atuais ligados ao convívio social. Verifique se na biblioteca da escola há exemplares dos livros indicados, por exemplo, e disponibilize-os para os estudantes manusearem.
02/10/2025 11:26:45
O lixo
Em nossa residência, nos hospitais, nos mercados e em outros estabelecimentos são produzidos, diariamente, resíduos sólidos, popularmente chamados de lixo. Mas qual o destino adequado desses resíduos? Neste livro, você encontra a resposta para essa e outras perguntas relacionadas aos resíduos sólidos, além de curiosidades sobre o assunto.
ARNOLDUSSEN, Lucas. O lixo São Paulo: Via Lúdica, 2025.
Museu da vacina

Nessa visitação, acompanhe a Doutora Rosa e conheça os caminhos das vacinas: a pesquisa, a distribuição para a população e a ação da vacina no nosso corpo. Encontre também jogos. Um deles, ajuda a compreender a importância das elevadas taxas de vacinação e vídeos com explicação de conceitos relacionados à vacina. Para realizar essa visitação, acesse com seus pais ou responsáveis o site a seguir.
MUSEU da vacina. Butantan. Disponível em: https://museudavacina.butantan.gov.br/tourvirtual/index.htm. Acesso em: 29 maio 2025.
Exposição “Vacina! Ciência protegendo vidas!”
A exposição “Vacina! Ciência protegendo vidas!” realizada no espaço cultural José Lins do Rego, na cidade de João Pessoa, no estado da Paraíba, pode ser visitada virtualmente. Nela, por meio de recursos interativos, você terá acesso a diversas informações sobre as vacinas e a importância delas para a saúde humana. Você pode acessar uma cinemateca e assistir vários vídeos sobre a história da vacina, os tipos de vacinas, entre outros. Além disso, você pode jogar um jogo virtual, no qual precisará escolher medidas de saúde adequadas para conter a disseminação de uma doença e controlar uma pandemia. Para isso, acesse com seus pais ou responsáveis o site a seguir.

VACINA. Era virtual. Disponível em: https://www.eravirtual.org/vacina/. Acesso em: 8 ago. 2025.
REFERÊNCIAS BIBLIOGRÁFICAS COMENTADAS
AGUIAR, Laura; DELDUQUE, Marcelo; SCHARF, Regina. Como cuidar da nossa água. Ilustrações de Fabio Otubo e Luiz Fernando Martini. 4. ed. São Paulo: BEĨ Comunicação, 2014. (Coleção Entenda e Aprenda).
A água é o centro das discussões sobre sustentabilidade. O livro apresenta os desafios, usos e origens dessa conscientização, assim como informações gerais sobre a água.
ATLAS geográfico escolar. 9. ed. Rio de Janeiro: IBGE, 2023.
O atlas apresenta informações abrangentes sobre dimensões sociopolíticas, ambiental e econômica.
BAIRD, Colin; CANN, Michael. Química ambiental. 4. ed. Porto Alegre: Bookman, 2011. Esse livro de química aborda as principais questões ambientais e explora as propriedades e os processos químicos envolvidos.
BEGON, Michael; TOWNSEND, Colin R.; HARPER, John L. Ecologia: de indivíduos a ecossistemas. Tradução de Adriano Sanches Melo et al. 4. ed. Porto Alegre: Artmed, 2007.
O livro aborda a ecologia de um modo geral, com base em conceitos e reflexões fundamentais de diversos temas.
BRASIL. Ministério da Educação. Base Nacional Comum Curricular. Versão final. Brasília: MEC, 2018. Disponível em: https:// basenacionalcomum.mec.gov.br/images/ BNCC_EI_EF_110518_versaofinal_site.pdf. Acesso em: 25 set. 2025.
A Base Nacional Comum Curricular (BNCC) é o documento norteador desse livro. Ela define o conjunto de aprendizagens essenciais que os estudantes precisam desenvolver durante a Educação Básica.
BROWN, Theodore L. et al Química: a ciência central. Tradução de Eloiza Lopes, Tiago Jonas e Sonia Midori Yamamoto. 13. ed. São Paulo: Pearson Education do Brasil, 2016.
Livro de referência na área de química, conhecida por sua abordagem clara e objetiva.
COMINS, Neil F.; KAUFMANN III, William J. Descobrindo o Universo. 8. ed. Tradução
de Eduardo Neto Ferreira. Porto Alegre: Bookman, 2010.
O livro é um guia completo sobre Astronomia e Astrofísica e aborda seus principais temas.
GAUTO, Marcelo Antunes; ROSA, Gilber Ricardo. Processos e operações unitárias da indústria química. Rio de Janeiro: Ciência Moderna, 2011.
O livro apresenta alguns processos da indústria química, como tratamento de água, siderurgia, biodiesel, entre outros.
HEWITT, Paul G. Física conceitual. 11. ed. Porto Alegre: Bookman, 2011.
O livro apresenta texto atrativo, com muitas ilustrações sobre o conhecimento conceitual dos princípios da Física.
HICKMAN JR., Cleveland; ROBERTS, Larry; LARSON, Alla. Princípios integrados de zoologia. Tradução de Antonio Carlos Muques et al. 11. ed. Rio de Janeiro: Guanabara Koogan, 2009. Esse livro de Zoologia integra diferentes áreas da Biologia abordando os animais em suas relações com o ambiente de maneira multidisciplinar.
HORVATH, J. E. O ABCD da astronomia e astrofísica. São Paulo: Livraria da Física, 2008. O livro traz informações gerais sobre a Astronomia de maneira multidisciplinar e de fácil compreensão.
HINRICHS, Roger A.; KLEINBACH, Merlin; REIS, Lineu B. dos. Energia e meio ambiente. Tradução de Lineu Belico dos Reis, Flávio Maron Vichi e Leonardo Freire de Mello. São Paulo: Cengage Learning, 2014. O livro apresenta princípios físicos relacionados ao uso da energia e seus efeitos no ambiente. Nele, é possível encontrar artigos que tratam da questão energética do Brasil.
INSTITUTO FEDERAL CATARINENSE. Fossa séptica e filtro anaeróbio: conceitos e dicas de manutenção. Blumenau, 2021. Esse material apresenta a definição de esgoto, o funcionamento do sistema de fossa séptica e filtro anaeróbio, dicas de uso e manutenção destes sistemas, bem como a importância do tratamento de esgoto para a saúde da população e para o ambiente.
01/10/2025 09:28:26
INSTITUTO Trata Brasil. Manual do Saneamento Básico: entendendo o saneamento básico ambiental no Brasil e sua importância socioeconômica. São Paulo, 2012. Disponível em: https://tratabrasil.org. br/wp-content/uploads/2022/09/manual -imprensa.pdf. Acesso em: 25 set. 2025. Esse manual explica a importância do saneamento básico e sua relevância à saúde humana, de séculos atrás até os dias de hoje.
JULIANO, Marcio de C. Consumo excessivo e o modelo de economia de materiais. Revista Terceiro Setor & Gestão, Guarulhos, v. 3. n. 1, p. 58-59, 2009. Disponível em: https:// revistas.ung.br/index.php/3setor/article/ view/519/614. Acesso em: 25 set. 2025. Esse artigo trata do consumo desenfreado e suas consequências para o ser humano e o meio ambiente. Além disso, discorre sobre a cadeia produtiva desde a obtenção da matéria-prima ao descarte dos bens produzidos.
KAYABI, Aturi et al Geografia indígena: Parque Indígena do Xingu. São Paulo: Instituto Socioambiental, 1996. Disponível em: https://acervo.socioambiental.org/sites/ default/files/publications/0pd00054.pdf. Acesso em: 22 maio 2025. Obra que valoriza a visão indígena sobre a utilização e preservação de territórios e destaca a conexão profunda que eles têm com a natureza.
MARQUES, Manuel Nunes. Origem e evolução do nosso calendário. Disponível em: https://www.mat.uc.pt/%7Ehelios/Mestre/ H01orige.htm. Acesso em: 23 maio 2025. O texto conceitua os elementos essenciais para construção de um calendário, assim como apresenta diversos calendários e os problemas inerentes a eles.
MILLER, George T.; SPOOLMAN, Scott E. Ciência ambiental. São Paulo: Cengage Learning, 2008.
A obra trata sobre a natureza, sua interação com o ser humano e mostra uma maneira sustentável de viver, com informações baseadas em estudos científicos.
ODUM, Eugene P.; BARRETT, Gary W. Fundamentos de ecologia. Tradução de Pégasus Sistemas e Soluções. São Paulo: Cengage Learning, 2011.
Esse livro aborda a Ecologia como um todo, com ênfase nos dilemas humanos.
PANORAMA. Abrema. Disponível em: https://www.abrema.org.br/panorama/. Acesso em: 5 maio 2025.
A publicação traz detalhamento sobre o fluxo de resíduos sólidos, incluindo outras formas de valorização de materiais além da reciclagem. Ainda, apresenta os avanços já conquistados e os desafios que ainda precisam ser enfrentados para uma gestão ambiental responsável e financeiramente viável.
REECE, J. B. et al Biologia de Campbell Tradução de Anne Villela et al. 10. ed. Porto Alegre: Artmed, 2015. Livro completo de referências da área de Ciências Biológicas, apresentando uma visão científica e pedagógica nos atuais padrões de ensino.
SADAVA, David et al Vida: a ciência da Biologia. Tradução de Ardala Katzfuss et al. 11. ed. Porto Alegre: Artmed, 2020. Livro que aborda várias áreas de Ciências Biológicas por meio de textos e imagens.
SITUAÇÃO epidemiológica. Gov.br Disponível em: https://www.gov.br/saude/ pt-br/assuntos/saude-de-a-a-z/s/sarampo/ situacao-epidemiologica. Acesso em: 10 abr. 2025.
O Ministério da Saúde apresenta dados sobre a situação epidemiológica do sarampo no Brasil.
STEINKE, Ercília T. Climatologia fácil São Paulo: Oficina de Textos, 2012.
O livro aborda conceitos de movimentos de rotação e translação da Terra, radiação solar, poluição, entre outros assuntos, utilizando exemplos reais.
STRAZZACAPPA, Cristina; MONTANARI, Valdir. Pelos caminhos da água. 2. ed. São Paulo: Moderna, 2003.
O livro mostra as etapas do caminho da água desde o abastecimento, passando pelo saneamento básico, os recursos hídricos presentes no planeta e comenta sobre a preservação dos ecossistemas.
TORTORA, Gerard J.; FUNKE, Berdell R.; CASE, Christine L. Microbiologia. 8. ed. Porto Alegre: Artmed, 2005. Esse livro de Microbiologia apresenta textos objetivos com muitas ilustrações didáticas.
MANUAL DO PROFESSOR
Este Manual do Professor é um complemento à primeira parte do Livro do Professor, oferecendo um suporte para o desenvolvimento docente e para o dia a dia em sala de aula. Neste manual, você encontrará uma série de informações importantes, como a estrutura da BNCC, sugestões para desenvolver um trabalho interdisciplinar, informações sobre conceitos, objetivos e instrumentos de avaliação, reflexões sobre o papel do professor e a prática docente, e a fundamentação teórico-metodológica da coleção. Além disso, encontrará um quadro de distribuição dos conteúdos
com as habilidades, competências gerais e específicas de cada componente curricular e os temas contemporâneos transversais da BNCC que estão sendo desenvolvidos em cada unidade, além de sugestões de cronogramas bimestrais, trimestrais e semestrais. Ao final desta parte, são também apresentadas sugestões de referências complementares para a prática docente e as referências bibliográficas comentadas utilizadas como consulta para a produção das orientações ao professor e deste Manual do Professor
A BASE NACIONAL COMUM CURRICULAR ( BNCC )
Desde a publicação da Constituição Federal de 1988, o artigo 210 já previa a necessidade de uma base comum para a educação brasileira. Em 1996, com a aprovação da Lei de Diretrizes e Bases da Educação (LDB), as discussões sobre um documento que orientasse os currículos da Educação Básica em todo o Brasil ganharam ainda mais força. Em 2018, após um amplo processo de debates e contribuições de educadores e da sociedade, a Base Nacional Comum Curricular (BNCC) foi homologada.
A BNCC propõe uma progressão de aprendizagens que visa à formação humana integral dos estudantes e à construção de uma sociedade mais justa, democrática e inclusiva. O documento estabelece um aprendizado mínimo e comum, orientado por competências e habilidades que devem ser desenvolvidas em cada etapa de ensino.
Na BNCC, as áreas de conhecimento são compostas de componentes curriculares. Por meio de unidades
temáticas, objetos de conhecimento e habilidades, esses componentes têm o objetivo de desenvolver as competências gerais e específicas.
AS COMPETÊNCIAS GERAIS DA EDUCAÇÃO BÁSICA
A BNCC orienta que, ao longo da Educação Básica, os estudantes desenvolvam dez competências gerais, que envolvem a mobilização de conhecimentos, habilidades, atitudes e valores. Essas competências são o alicerce, definindo o que se espera que o estudante desenvolva em toda a Educação Básica. Nesta coleção, elas são trabalhadas por meio de temas, discussões e atividades que incentivam a reflexão crítica, com sugestões nas orientações ao professor. A seguir, apresentamos as competências gerais da BNCC.
Competências gerais da Educação Básica
1. Valorizar e utilizar os conhecimentos historicamente construídos sobre o mundo físico, social, cultural e digital para entender e explicar a realidade, continuar aprendendo e colaborar para a construção de uma sociedade justa, democrática e inclusiva.
2. Exercitar a curiosidade intelectual e recorrer à abordagem própria das ciências, incluindo a investigação, a reflexão, a análise crítica, a imaginação e a criatividade, para investigar causas, elaborar e testar hipóteses, formular e resolver problemas e criar soluções (inclusive tecnológicas) com base nos conhecimentos das diferentes áreas.
3. Valorizar e fruir as diversas manifestações artísticas e culturais, das locais às mundiais, e também participar de práticas diversificadas da produção artístico-cultural.
4. Utilizar diferentes linguagens – verbal (oral ou visual-motora, como Libras, e escrita), corporal, visual, sonora e digital – bem como conhecimentos das linguagens artística, matemática e científica, para se expressar e partilhar informações, experiências, ideias e sentimentos em diferentes contextos e produzir sentidos que levem ao entendimento mútuo.
5. Compreender, utilizar e criar tecnologias digitais de informação e comunicação de forma crítica, significativa, reflexiva e ética nas diversas práticas sociais (incluindo as escolares) para se comunicar, acessar e disseminar informações, produzir conhecimentos, resolver problemas e exercer protagonismo e autoria na vida pessoal e coletiva.
6. Valorizar a diversidade de saberes e vivências culturais e apropriar-se de conhecimentos e experiências que lhe possibilitem entender as relações próprias do mundo do trabalho e fazer escolhas alinhadas ao exercício da cidadania e ao seu projeto de vida, com liberdade, autonomia, consciência crítica e responsabilidade.
7. Argumentar com base em fatos, dados e informações confiáveis, para formular, negociar e defender ideias, pontos de vista e decisões comuns que respeitem e promovam os direitos humanos, a consciência socioambiental e o consumo responsável em âmbito local, regional e global, com posicionamento ético em relação ao cuidado de si mesmo, dos outros e do planeta.
8. Conhecer-se, apreciar-se e cuidar de sua saúde física e emocional, compreendendo-se na diversidade humana e reconhecendo suas emoções e as dos outros, com autocrítica e capacidade para lidar com elas.
9. Exercitar a empatia, o diálogo, a resolução de conflitos e a cooperação, fazendo-se respeitar e promovendo o respeito ao outro e aos direitos humanos, com acolhimento e valorização da diversidade de indivíduos e de grupos sociais, seus saberes, identidades, culturas e potencialidades, sem preconceitos de qualquer natureza.
10. Agir pessoal e coletivamente com autonomia, responsabilidade, flexibilidade, resiliência e determinação, tomando decisões com base em princípios éticos, democráticos, inclusivos, sustentáveis e solidários.
BRASIL. Ministério da Educação. Base Nacional Comum Curricular. Versão final. Brasília: MEC, 2018. p. 9-10. Disponível em: https://basenacionalcomum.mec.gov.br/images/BNCC_EI_EF_110518_versaofinal_site.pdf. Acesso em: 14 ago. 2025.
A BNCC propõe que o conteúdo chegue à sala de aula de forma contextualizada, o que exige novas estratégias do professor, como a transposição didática. Isso significa converter o conteúdo científico em uma linguagem acessível e adaptada à realidade dos estudantes. Para isso, o estudo e a reavaliação constante da prática docente são essenciais.
A seguir, apresentamos algumas ações que podem ser aplicadas para desenvolver as competências gerais em sala de aula.
Sugestões de ações docentes para as competências gerais
Competência geral 1: Incentive os estudantes a reconhecerem a importância dos conhecimentos já adquiridos, mostrando como eles servem de base para a compreensão da realidade e para a construção de novos saberes.
Competência geral 2: Exercite a curiosidade intelectual, levando os estudantes a usarem a abordagem científica para investigar, levantar hipóteses, resolver problemas e analisar os resultados por meio de experiências e observações.
Competência geral 3: Proporcione o contato com diferentes manifestações culturais em âmbito local, regional e global e promova atividades artísticas, como grupos de dança, elaboração de roteiros e atuação em peças de teatro, festivais musicais e saraus.
Competência geral 4: Dê subsídios para que os estudantes se comuniquem por meio de diferentes linguagens, ajudando-os a selecionar a mais apropriada para cada situação.
Competência geral 5: Utilize de forma intencional e pedagógica diversas tecnologias em sala de aula, verificando o conhecimento prévio dos estudantes e diversificando os recursos metodológicos.
Competência geral 6: Ajude os estudantes a refletirem sobre o futuro e a importância da liberdade, autonomia e consciência crítica em suas escolhas profissionais e pessoais, valorizando a diversidade de saberes e experiências.
Competência geral 7: Ofereça subsídios para que os estudantes desenvolvam a capacidade de argumentar com base em fatos e dados confiáveis, sabendo selecionar e verificar a origem de diferentes fontes para negociar pontos de vista e defender ideias.
Competência geral 8: Leve os estudantes a se compreenderem e se valorizarem dentro da diversidade, reconhecendo suas emoções e as dos outros, e exercitando a autocrítica.
Competência geral 9: Promova o exercício da empatia, do diálogo e da cooperação, incentivando os estudantes a resolverem conflitos de forma respeitosa e democrática.
Competência geral 10: Contribua para que os estudantes ajam de modo responsável, guiados por princípios éticos e de cidadania, e conscientes de que suas ações devem estar alinhadas à tomada de decisões inclusivas, sustentáveis e solidárias.
Nesta coleção, as competências gerais que são desenvolvidas nos textos, atividades e seções que permeiam os conteúdos são destacadas nas orientações ao professor e são listadas no Quadro de distribuição dos conteúdos
AS COMPETÊNCIAS ESPECÍFICAS
Para que as competências gerais se manifestem em cada componente, a BNCC estabelece as competências específicas. A organização dessas competências no Ensino Fundamental varia: em áreas como Matemática e Ciências Naturais, as competências
específicas são as mesmas para o componente; e em áreas como Linguagens e Ciências Humanas, há competências específicas por área e também para cada componente curricular que as compõem (Língua Portuguesa, Arte, Educação Física, Língua Inglesa, Geografia e História), reconhecendo as particularidades de cada um. Em todos os casos, as competências específicas colaboram para que os objetivos de aprendizagem sejam claros e coerentes, do nível mais amplo ao mais específico.
A seguir, apresentamos as competências específicas de Ciências da Natureza.
1. Compreender as Ciências da Natureza como empreendimento humano, e o conhecimento científico como provisório, cultural e histórico.
2. Compreender conceitos fundamentais e estruturas explicativas das Ciências da Natureza, bem como dominar processos, práticas e procedimentos da investigação científica, de modo a sentir segurança no debate de questões científicas, tecnológicas, socioambientais e do mundo do trabalho, continuar aprendendo e colaborar para a construção de uma sociedade justa, democrática e inclusiva.
3. Analisar, compreender e explicar características, fenômenos e processos relativos ao mundo natural, social e tecnológico (incluindo o digital), como também as relações que se estabelecem entre eles, exercitando a curiosidade para fazer perguntas, buscar respostas e criar soluções (inclusive tecnológicas) com base nos conhecimentos das Ciências da Natureza.
4. Avaliar aplicações e implicações políticas, socioambientais e culturais da ciência e de suas tecnologias para propor alternativas aos desafios do mundo contemporâneo, incluindo aqueles relativos ao mundo do trabalho.
5. Construir argumentos com base em dados, evidências e informações confiáveis e negociar e defender ideias e pontos de vista que promovam a consciência socioambiental e o respeito a si próprio e ao outro, acolhendo e valorizando a diversidade de indivíduos e de grupos sociais, sem preconceitos de qualquer natureza.
6. Utilizar diferentes linguagens e tecnologias digitais de informação e comunicação para se comunicar, acessar e disseminar informações, produzir conhecimentos e resolver problemas das Ciências da Natureza de forma crítica, significativa, reflexiva e ética.
7. Conhecer, apreciar e cuidar de si, do seu corpo e bem-estar, compreendendo-se na diversidade humana, fazendo-se respeitar e respeitando o outro, recorrendo aos conhecimentos das Ciências da Natureza e às suas tecnologias.
8. Agir pessoal e coletivamente com respeito, autonomia, responsabilidade, flexibilidade, resiliência e determinação, recorrendo aos conhecimentos das Ciências da Natureza para tomar decisões frente a questões científico-tecnológicas e socioambientais e a respeito da saúde individual e coletiva, com base em princípios éticos, democráticos, sustentáveis e solidários. BRASIL. Ministério da Educação. Base Nacional Comum Curricular. Versão final. Brasília: MEC, 2018. p. 324. Disponível em: https://www.gov.br/mec/pt-br/escola-em-tempo-integral/BNCC_EI_EF_110518_versaofinal.pdf. Acesso em: 14 ago. 2025.
Nesta coleção, as competências específicas que são desenvolvidas nos textos, atividades e seções que permeiam os conteúdos são destacadas nas orienta-
ções ao professor e listadas no Quadro de distribuição dos conteúdos
Competências específicas de Ciências da Natureza
AS UNIDADES TEMÁTICAS, OS
OBJETOS DE CONHECIMENTO E AS HABILIDADES
Para garantir o desenvolvimento das competências gerais e específicas, a BNCC organiza o currículo em três elementos interligados: unidades temáticas, objetos de conhecimento e habilidades.
As unidades temáticas são os grandes blocos de conhecimento que orientam a organização curricular. Elas funcionam como eixos estruturantes que agrupam temas e conceitos de forma mais ampla, garantindo uma abordagem contextualizada e progressiva ao longo dos anos escolares.
Dentro de cada unidade temática, os objetos de conhecimento são os conteúdos, conceitos e processos que devem ser ensinados.
As habilidades representam o que o estudante deve ser capaz de fazer com o conhecimento. Elas
indicam ações, processos e competências a serem desenvolvidos.
Juntos, esses três elementos garantem que o processo de ensino não seja apenas a transmissão de conteúdos. A unidade temática fornece o contexto, o objeto de conhecimento define o tema, e a habilidade define a ação que o estudante precisa executar, garantindo um aprendizado significativo e o desenvolvimento das competências.
Nesta coleção, as habilidades que são desenvolvidas nos textos, atividades e seções que permeiam os conteúdos são destacadas nas orientações ao professor e são listadas no Quadro de distribuição dos conteúdos, mostrando a relação entre os diferentes elementos da BNCC.
A seguir, apresentamos as unidades temáticas, objetos de conhecimento e habilidades de Ciências da Natureza da BNCC referentes ao 4º ano.
Ciências – 4º ano
UNIDADES TEMÁTICAS OBJETOS DE CONHECIMENTO
Matéria e energia Misturas Transformações reversíveis e não reversíveis
HABILIDADES
(EF04CI01) Identificar misturas na vida diária, com base em suas propriedades físicas observáveis, reconhecendo sua composição.
(EF04CI02) Testar e relatar transformações nos materiais do dia a dia quando expostos a diferentes condições (aquecimento, resfriamento, luz e umidade).
(EF04CI03) Concluir que algumas mudanças causadas por aquecimento ou resfriamento são reversíveis (como as mudanças de estado físico da água) e outras não (como o cozimento do ovo, a queima do papel etc.).
Vida e evolução Cadeias alimentares simples
Microrganismos
Terra e Universo Pontos cardeais
Calendários, fenômenos cíclicos e cultura
(EF04CI04) Analisar e construir cadeias alimentares simples, reconhecendo a posição ocupada pelos seres vivos nessas cadeias e o papel do Sol como fonte primária de energia na produção de alimentos.
(EF04CI05). Descrever e destacar semelhanças e diferenças entre o ciclo da matéria e o fluxo de energia entre os componentes vivos e não vivos de um ecossistema.
(EF04CI06) Relacionar a participação de fungos e bactérias no processo de decomposição,reconhecendo a importância ambiental desse processo.
(EF04CI07) Verificar a participação de microrganismos na produção de alimentos, combustíveis, medicamentos, entre outros.
(EF04CI08) Propor, a partir do conhecimento das formas de transmissão de alguns microrganismos (vírus, bactérias e protozoários), atitudes e medidas adequadas para prevenção de doenças a eles associadas.
(EF04CI09) Identificar os pontos cardeais, com base no registro de diferentes posições relativas do Sol e da sombra de uma vara (gnômon).
(EF04CI10) Comparar as indicações dos pontos cardeais resultantes da observação das sombras de uma vara (gnômon) com aquelas obtidas por meio de uma bússola.
(EF04CI11) Associar os movimentos cíclicos da Lua e da Terra a períodos de tempo regulares e ao uso desse conhecimento para a construção de calendários em diferentes culturas.
BRASIL. Ministério da Educação. Base Nacional Comum Curricular. Versão final. Brasília: MEC, 2018. p. 338, 339. Disponível em: https://www.gov.br/mec/pt-br/escola-em-tempo-integral/BNCC_EI_EF_110518_versaofinal.pdf. Acesso em: 14 ago. 2025.
TRANSVERSAIS
Para enriquecer o trabalho com as habilidades e competências da BNCC e contextualizar o ensino, as propostas pedagógicas devem abordar os temas contemporâneos transversais (TCT). Esses temas são assuntos relevantes para a formação cidadã dos estudantes e para a construção de uma sociedade mais justa, ética e sustentável. São temas com caráter interdisciplinar, que conectam os conteúdos escolares com o cotidiano dos estudantes e com questões importantes em discussão na sociedade.
De acordo com o documento Temas Contemporâneos Transversais da BNCC, publicado em 2019, esses temas são de relevância local, regional e global e estão organizados em seis macroáreas.
Meio ambiente
Economia
Saúde
Educação ambiental
Educação para o consumo
Trabalho
Educação financeira
Educação fiscal
Saúde
Educação alimentar e nutricional
Cidadania e civismo
Multiculturalismo
Vida familiar e social
Educação para o trânsito
Educação em direitos humanos
Direitos da criança e do adolescente
Processo de envelhecimento, respeito e valorização do idoso
Diversidade cultural
Educação para valorização do multiculturalismo nas matrizes históricas e culturais brasileiras
Ciência e tecnologia
Ciência e tecnologia
Nesta coleção, esses temas são explorados em diferentes momentos no desenvolvimento dos conteúdos e recebem destaque na seção Coletivamente, contribuindo para a formação cidadã dos estudantes por meio de reflexões e propostas de resoluções para problemas, de modo que eles sejam atuantes na sociedade em que vivem.
INTEGRAÇÃO ENTRE OS COMPONENTES CURRICULARES
Desde a década de 1990, o trabalho interdisciplinar tem ganhado relevância no Brasil, sendo incentivado em todos os níveis da Educação Básica. A interdisciplinaridade é a relação entre dois ou mais componentes curriculares que se unem para obter um conhecimento mais amplo e unificado. Essa abordagem vai além da simples comunicação de ideias; ela integra conceitos, metodologias e terminologias para que o conhecimento se torne mais significativo e conectado à realidade dos estudantes. Ao integrar os diversos componentes, a interdisciplinaridade amplia a compreensão da realidade e contribui para a formação integral dos estudantes como cidadãos. No ambiente escolar, essa abordagem gera resultados positivos, pois incentiva a colaboração e a contextualização de temas, garantindo que o aprendizado esteja alinhado à vivência dos estudantes.
No desenvolvimento de um trabalho interdisciplinar, tanto o professor quanto os estudantes devem estabelecer conexões entre saberes mais amplos e os conteúdos específicos dos diferentes componentes curriculares. Com base nessa articulação, espera-se que
consigam construir uma síntese que amplie sua compreensão, superando o nível de entendimento inicial.
Para que esse processo ocorra de forma efetiva, é imprescindível que o professor assuma um papel mediador nesse percurso, sendo o primeiro a exercitar esse movimento de integração. Nesse contexto, o professor deve mobilizar algumas competências, como:
[...]
• diferenciação, comparação e contraste entre diferentes perspectivas disciplinares, profissionais e interdisciplinares;
• identificação de pontos comuns e esclarecimento de como as diferenças se relacionam com a tarefa a ser cumprida;
• delineamento de um entendimento holístico baseado nos pontos comuns, mas que continua suscetível às diferenças.
[...]
KLEIN, Julie Thompson. Ensino interdisciplinar: didática e teoria. In: FAZENDA, Ivani Catarina Arantes (org.). Didática e interdisciplinaridade 17. ed. Campinas: Papirus, 2017. p. 121. (Coleção Práxis).
Além disso, para realizar um trabalho interdisciplinar de maneira significativa, é essencial que ele esteja pautado nas experiências, no cotidiano e nos interesses dos estudantes. Isso implica aproveitar as situações que emergem naturalmente em sala de aula, por exemplo: perguntas formuladas por eles, projetos em andamento, investigações e demais práticas pedagógicas, como oportunidades para articular diferentes saberes.
Nas propostas interdisciplinares, é comum que os estudantes atuem em grupo, promovendo a interação entre eles. Essa prática fortalece habilidades importantes, como a argumentação, a escuta ativa e a organização de ideias.
Essa abordagem exige metodologias mais dinâmicas e colaborativas, favorecendo a construção coletiva do saber. Ao promover a articulação entre os conteúdos curriculares, ela amplia as possibilidades de leitura e interpretação do mundo, tanto para os professores quanto para os estudantes, permitindo uma compreensão do conhecimento como algo vivo, em constante transformação.
Nesta coleção, você encontrará atividades cujo propósito é integrar diferentes componentes curriculares. As seções Coletivamente e Entre textos, por exemplo, trazem temas e reflexões que possibilitam um trabalho integrado. Além disso, o boxe Articulando conhecimentos detalha algumas integrações nas orientações ao professor, contribuindo para o aumento da criatividade e para a formação crítica e responsável dos estudantes na construção de seu conhecimento.
A PRÁTICA INTERDISCIPLINAR
E O TRABALHO COM PROJETOS
INTERDISCIPLINARES
Para planejar um trabalho interdisciplinar, o ponto de partida é definir os objetivos de aprendizagem. Com base nisso, se for o caso, é importante dialogar com o professor de outros componentes para planejar estratégias conjuntas, considerando os objetivos previamente levantados, os conhecimentos prévios dos estudantes e como os conteúdos podem ser abordados de forma integrada. Quando não for possível contar com a colaboração do professor de outros componentes curriculares, cabe a você orientar os estudantes nas pesquisas, ensinando-os a buscar fontes confiáveis e adequadas à proposta, a fazer registros relevantes, a organizar as informações obtidas e a planejar como os resultados das pesquisas serão entregues.
PROJETOS INTERDISCIPLINARES
Projetos investigativos e pesquisas também são exemplos de atividades que favorecem o trabalho interdisciplinar em sala de aula, pois envolvem tarefas
que integram conhecimentos de diferentes áreas, como planejamento, levantamento de hipóteses, coletas de dados, análises, deduções e conclusões.
Os projetos oferecem aos estudantes oportunidades concretas de participação ativa no processo de construção do conhecimento, contribuindo diretamente para o desenvolvimento de diversas competências, como o pensamento crítico e reflexivo, a argumentação, a valorização do pluralismo de ideias, a criatividade, a cooperação, a autonomia e a comunicação.
Nesse contexto, você continua sendo o mediador, orientando e acompanhando os estudantes para que atuem com autonomia e sejam protagonistas do desenvolvimento do projeto.
É importante ressaltar que a estrutura de um projeto não deve ser encarada como um modelo fixo ou engessado. Os projetos podem assumir diferentes formatos, conforme os objetivos e os contextos de aplicação. Em geral, iniciam-se com uma situação-problema ou uma questão orientadora, que dá origem a um conjunto de etapas organizadas de forma lógica. A seguir, apresentamos um modelo com etapas fundamentais que podem nortear a construção de um projeto interdisciplinar.
PLANEJAMENTO
• Definição da situação-problema ou da questão norteadora.
• Conversa sobre o tema e levantamento de hipóteses.
• Elaboração de questões norteadoras com base na situação-problema.
• Formação das equipes, distribuição de tarefas e estabelecimento de metas e prazos.
• Consulta de diversas fontes e coleta de informações.
EXECUÇÃO
• Organização, testes e execução do trabalho.
• Realização de ajustes finais.
• Avaliação durante o processo.
• Definição da participação dos integrantes que conduzirão a apresentação.
DIVULGAÇÃO
• Apresentação dos resultados para a comunidade escolar.
• Publicação do trabalho final.
AVALIAÇÃO
• Avaliação dos resultados do projeto.
• Realização de autoavaliação.
• Verificação do desempenho e do desenvolvimento das aprendizagens dos estudantes.
Fonte de pesquisa: BENDER, William N. Aprendizagem baseada em projetos: educação diferenciada para o século XXI. Tradução de Fernando de Siqueira Rodrigues. Porto Alegre: Penso, 2014. p. 61.
AVALIAÇÃO
A avaliação tem papel fundamental no processo de ensino-aprendizagem, pois é uma oportunidade de investigar, diagnosticar, refletir e intervir sobre o processo e acompanhar o desenvolvimento dos estudantes e sua atuação enquanto docente.
É fundamental compreender que a avaliação não deve ocorrer apenas em situações isoladas. O acompanhamento do percurso de aprendizagem dos estudantes precisa ser contínuo, tendo como base observações frequentes e diversificadas. Nesse sentido, o processo avaliativo deve fazer parte das práticas pedagógicas do dia a dia, de modo integrado ao planejamento e às atividades desenvolvidas em sala de aula.
A você, a avaliação possibilita observar e refletir sobre sua prática docente e a oportunidade de readequar e reajustar atividades, práticas e estratégias para alcançar determinados objetivos, com a participação ativa dos estudantes nesse processo. Desse modo, é de grande importância a interpretação dos resultados para que, com base neles, você possa refletir sobre intervenções a serem feitas para sanar possíveis defasagens e, assim, auxiliar no processo de construção do conhecimento, identificando possibilidades de recuperação e progressão do aprendizado.
É essencial que a avaliação seja compreendida como uma ferramenta de inclusão e de apoio ao processo de ensino-aprendizagem, evitando que seja usada apenas como forma de analisar a eficiência e classificar os estudantes. Avaliar não deve ser sinônimo de rotular
Avaliação diagnóstica
ou excluir, mas sim de compreender os percursos formativos deles.
Para que a avaliação realmente contribua para identificar os progressos, as dificuldades e as possíveis lacunas no desenvolvimento das aprendizagens, é necessário que os critérios sejam previamente compartilhados e discutidos com os estudantes, pois isso favorece a compreensão dos objetivos da avaliação e promove uma participação mais ativa por parte deles.
O planejamento das avaliações deve estar alinhado aos conteúdos e às atividades efetivamente trabalhados em sala de aula, com uma abordagem reflexiva e contextualizada. É essencial considerar os processos de aprendizagem mais adequados à turma e considerar a diversidade de perfis entre os estudantes. Além disso, é recomendável diversificar os instrumentos utilizados, não se restringindo a provas e testes, e incluir diferentes formas de expressão do conhecimento. Entre as possibilidades, destacam-se atividades em grupo, debates, produções escritas e orais, atividades práticas, questões objetivas e dissertativas, entre outros formatos que respeitem as múltiplas formas de aprender e se comunicar dos estudantes.
Nesta coleção, a ação avaliativa do processo de ensino-aprendizagem propõe três tipos principais: a avaliação diagnóstica, a avaliação formativa e a avaliação somativa.
A avaliação diagnóstica é o momento de identificar os conhecimentos que os estudantes trazem consigo, além de suas necessidades e dificuldades.
Essa etapa é fundamental para você reajustar as rotas e os objetivos de ensino. É importante ressaltar que a avaliação diagnóstica não precisa de um registro formal; a simples observação de uma atividade em sala de aula, por exemplo, já permite que você identifique as habilidades que precisam ser desenvolvidas ou aperfeiçoadas.
Onde ocorre
Nesta coleção, um exemplo de avaliação diagnóstica está na seção Vamos iniciar, no início de cada volume. Nela, são propostas atividades que possibilitam determinar se será necessário retomar conteúdos, estabelecer objetivos e definir as práticas e as estratégias didáticas. Nas orientações ao professor, você encontra sugestões de intervenção com base na análise das respostas e nas dificuldades dos estudantes.
A avaliação diagnóstica também pode ser feita no início de cada unidade, pois as atividades das páginas de abertura possibilitam diagnosticar os conhecimentos prévios dos estudantes sobre os temas e os conteúdos que serão abordados.
Avaliação formativa
A avaliação formativa acontece ao longo do período letivo. São os processos contínuos pelos quais você obtém indicadores a respeito da aprendizagem dos estudantes.
Desse modo, esse tipo de avaliação possibilita que você realize intervenções, propondo novas estratégias e procedimentos que visam à melhoria e/ou ao aprofundamento dos conhecimentos por parte dos estudantes.
A avaliação formativa pode ter um papel fundamental na melhoria das aprendizagens de todos os alunos. A sua utilização sistemática deve permitir que os alunos conheçam bem: a) o que têm de aprender no final de um dado período de tempo; b) a situação em que se encontram quanto às aprendizagens que têm de desenvolver; e c) os esforços que têm de fazer para aprenderem o que está previsto e descrito nos documentos curriculares. Para tal, a comunicação entre professores e alunos é fundamental, pois é através dela que os alunos podem receber orientações que os ajudam a aprender. [...]
FERNANDES, Domingos. Avaliação formativa: Folha de apoio à formação: Projeto de Monitorização, Acompanhamento e Investigação em Avaliação Pedagógica (Maia). Ministério da Educação: Direção-Geral da Educação, 2021. p. 4.
Onde ocorre
Nesta coleção, a avaliação formativa é um processo contínuo e integrado. A seção Vamos avaliar o aprendizado, ao final de cada unidade do Livro do Estudante, oferece atividades que retomam os principais conceitos e noções trabalhados para verificar a aprendizagem com relação aos objetivos estabelecidos.
Nas orientações ao professor, o boxe Avaliando complementa essa prática com propostas de atividades avaliativas adicionais. Ele inclui objetivos e estratégias de intervenção, caso seja necessária a retomada de conteúdos e conceitos.
Além disso, é importante o hábito de transitar pela sala de aula e observar os estudantes durante as atividades propostas. Esse acompanhamento mais próximo contribui para que eles se reconheçam como parte do processo de ensino-aprendizagem, desenvolvam sua autonomia e busquem aprimoramento contínuo.
Avaliação somativa
A avaliação somativa é realizada ao final de um período de estudos, em consonância com as práticas pedagógicas da escola. Com base nas respostas a essa avaliação, você poderá refletir sobre ações a serem tomadas para sanar possíveis dificuldades dos estudantes.
Por ser comumente associada a testes e notas que visam classificar o desempenho dos estudantes, é fundamental que ela não seja o único foco do processo avaliativo. A nota é apenas uma das muitas formas de representar os resultados, e essa etapa deve ser considerada como a consequência natural das avaliações diagnóstica e formativa já realizadas. Ao analisar os resultados, você pode refletir sobre as ações necessárias para sanar possíveis dificuldades, utilizando o desempenho como um indicativo para a retomada de conteúdos e a definição de novas estratégias. Dessa forma, resultados abaixo do esperado não são uma sentença, mas sim um ponto de partida para aprimorar o processo de ensino-aprendizagem.
Onde ocorre
Nesta coleção, a avaliação somativa acontece ao final de cada volume, na seção Vamos concluir. Essa seção oferece atividades que permitem a você verificar os conhecimentos adquiridos pelos estudantes no decorrer do ano letivo. Nas orientações ao professor, você encontra sugestões de intervenção para analisar as respostas e identificar a necessidade de estratégias de remediação, garantindo que os objetivos pedagógicos sejam alcançados.
Para um sistema de avaliação eficiente, é recomendável a combinação das três modalidades, além de usar diferentes instrumentos que auxiliem a obter
informações sobre o desenvolvimento da aprendizagem dos estudantes. Apresentamos a seguir alguns exemplos.
Instrumentos de avaliação
Podem ser elaborados com questões abertas, análise de situações, questões objetivas e quizzes e realizados de forma regular, abordando conteúdos específicos ou referentes a determinado período. Seminários e debates
Provas e testes
Portfólios
Possibilitam a você perceber o desenvolvimento de habilidades relacionadas a tarefas como pesquisa, síntese das informações, pensamento crítico e comunicação.
A elaboração de portfólios com base em suas observações e registros em fichas avaliativas contribui para analisar não só o desenvolvimento cognitivo dos estudantes, mas também a maneira como cada um aprende, com atenção especial às habilidades que eles desenvolvem com mais facilidade e as que demandam mais atenção e auxílio para serem desenvolvidas.
Saraus Permitem a você verificar o desenvolvimento de habilidades relacionadas à interação social, capacidade de expressão, criatividade, sensibilidade e conhecimento cultural.
Ditados
Autoavaliação
Possibilitam que você acompanhe as principais dificuldades dos estudantes com relação à escuta e à escrita.
Incentiva o desenvolvimento da autonomia dos estudantes, levando-os a refletir sobre sua participação nas atividades, suas dificuldades e aspectos que devem ser melhorados. Com base nessas informações, você pode debater com eles os caminhos para gerar mudanças no planejamento e melhorias para toda a turma.
Para auxiliar o monitoramento das aprendizagens, sugerimos a utilização de uma ficha de avaliação de acompanhamento individual, como a que apresentamos a seguir. Essa ferramenta permite registrar a trajetória de cada estudante, observando seu desenvolvimento com relação aos objetivos e às habilidades trabalhados.
A ficha usa um sistema de marcação simples para identificar o nível de desenvolvimento do estudante.
• S (Sim): o estudante demonstrou ter alcançado o objetivo.
• P (Parcialmente): o estudante atingiu o objetivo de forma incompleta, necessitando de intervenção para avançar.
• N (Não): o estudante não alcançou o objetivo, sendo necessária uma intervenção imediata. Quando o objetivo é alcançado e marcado com S, você deve incentivar o estudante a aprofundar seus saberes. Se a marcação for P ou N, a ficha serve como um diagnóstico claro, indicando a necessidade de planejar intervenções para que o estudante progrida nos estudos.
Você pode usar esse tipo de ficha para registrar observações feitas durante o trabalho com as seções Vamos iniciar, Vamos avaliar o aprendizado e Vamos concluir do Livro do Estudante e com o boxe Avaliando das orientações ao professor
Escola: Professor(a):
Estudante: Turma: Período letivo do registro:
preencher com o nome da escola. preencher com o nome do estudante. preencher com a indicação da turma. preencher com o período do planejamento. preencher com o nome do professor.
Ficha de acompanhamento individual das aprendizagens
Objetivos ou habilidades avaliados
Preencher com o objetivo ou a habilidade.
Preencher com o objetivo ou a habilidade.
O PAPEL DO PROFESSOR E A PRÁTICA DOCENTE
No contexto atual da educação, o papel do professor dos Anos Iniciais do Ensino Fundamental vai além da transmissão de conteúdo. Ele deve atuar como mediador do conhecimento, incentivando a autonomia dos estudantes e formando leitores e pensadores críticos. Acima de tudo, o professor é um agente essencial na construção da base educacional e emocional dos estudantes.
Essa etapa da escolarização é marcada por profundas transformações no desenvolvimento cognitivo, afetivo e social dos estudantes. Por isso, a prática pedagógica exige sensibilidade e escuta ativa. Você deve estar atento às necessidades individuais dos estudantes, respeitando seus ritmos de aprendizagem e suas realidades. A construção de vínculos afetivos é fundamental para fortalecer a autoestima e a autonomia, pois são eles que criam um ambiente acolhedor, onde o erro é considerado como parte do processo de aprendizagem e todos os estudantes se sentem seguros para se expressarem.
Sua atuação docente envolve uma reflexão constante sobre os conteúdos, as metodologias e, principalmente, sobre como os estudantes aprendem. Ao aproximar o conteúdo escolar dos conhecimentos prévios deles, você torna o aprendizado mais significativo e prazeroso. Essa abordagem, que valoriza a bagagem cultural e as experiências dos estudantes, é fundamental na construção de uma relação positiva deles com o ato de estudar.
O planejamento pedagógico é o ponto de partida, mas a prática em sala de aula é dinâmica e não linear. É no dia a dia que você conhece os perfis, as necessidades e os ritmos da turma e que a flexibilidade e a capacidade de adaptação se tornam essenciais. O diálogo constante com a equipe pedagógica e a participação em formações continuadas são atitudes que favorecem o desenvolvimento de uma prática docente mais eficaz e alinhada às reais demandas da turma.
Nessa jornada, você é o principal organizador das ações pedagógicas. É quem acolhe, engaja e dá
MODELO
oportunidade para que os estudantes verbalizem seu raciocínio, escrevam e desenvolvam, no coletivo da turma, a compreensão sobre os motivos das atividades e a realização das respostas. O livro didático não é apenas um guia, mas um instrumento cultural que serve como mediador entre você e o estudante, auxiliando na construção do conhecimento. Com autonomia, é você quem dá vida a esse material, ajustando-o às necessidades de cada turma para que os estudantes se tornem os protagonistas de sua aprendizagem.
A PRÁTICA PEDAGÓGICA EM AÇÃO
A sala de aula é marcada pela diversidade. Cada estudante traz consigo um conjunto de experiências, saberes e modos de aprender. Essa diversidade se expressa em aspectos comportamentais, cognitivos, afetivos e socioculturais, que influenciam diretamente o modo como cada um constrói o conhecimento. Já as trajetórias individuais são moldadas por fatores como o contexto familiar, as vivências culturais e o ambiente social em que estão inseridos. É seu papel e da equipe escolar acolher essas diferenças.
Nesse sentido, compreender o desenvolvimento dos estudantes exige atenção ao contexto em que vivem, às suas práticas cotidianas e à maneira como atribuem significado às suas experiências. Por isso, uma das grandes questões que se impõe ao trabalho docente é: como planejar intervenções pedagógicas que deem conta da heterogeneidade presente em sala de aula, especialmente em turmas numerosas?
Diante desse desafio, é essencial que você reconheça que não há um único caminho para a aprendizagem. As interações, os ritmos e os interesses variam, e é seu papel estar atento a essas diferenças, promovendo práticas pedagógicas flexíveis e inclusivas. Só assim será possível garantir que todos os estudantes tenham oportunidades reais de desenvolvimento, respeitando suas singularidades sem comprometer a qualidade do processo de ensino-aprendizagem.
A seguir, apresentamos sugestões para auxiliar seu dia a dia, promovendo a adequação de atividades e a progressão do aprendizado, para que os estudantes avancem no próprio ritmo, com o apoio necessário para superar desafios.
A PEGA DO LÁPIS NO PROCESSO DE ALFABETIZAÇÃO
Como os estudantes dos Anos Iniciais do Ensino Fundamental estão no processo de alfabetização, é importante que você os auxilie na apropriação do sistema de escrita. Uma das intervenções relevantes nesse processo é a orientação sobre a pega funcional do lápis. A pega de três pontos, também conhecida como pega
tripoide ou trípode, é uma técnica considerada funcional, pois favorece movimentos mais precisos, fluidos e controlados, o que é essencial para o desenvolvimento da escrita e evita fadiga muscular. Para orientar os estudantes, incentive-os a:
• posicionar o lápis de forma relaxada, sem forçar os dedos;
• segurar o lápis entre a ponta do polegar e a lateral do dedo indicador;
• apoiar o lápis no dedo médio para dar suporte e estabilidade;
• deixar os outros dedos (anelar e mínimo) levemente dobrados na palma da mão, servindo de apoio.
É fundamental acompanhar o processo individualmente, observando se a pega está firme, mas não tensa. No entanto, trata-se de um desenvolvimento, desse modo, inicialmente não é recomendada a correção direta da pega, mas sim uma observação atenta para compreender como cada estudante está se apropriando desses movimentos e o que pode ser feito para progredir.
O desenvolvimento da pega do lápis não se resume apenas a segurar o instrumento. Ele é resultado de uma coordenação motora fina bem desenvolvida. Para auxiliar nesse processo, é importante incluir atividades lúdicas e variadas na rotina da sala de aula que ajudam a fortalecer a musculatura das mãos e dos dedos, como brincar com massinha de modelar ou argila, rasgar papel com as mãos, rasgar papel em pedaços pequenos e fazer bolinhas com as pontas dos dedos, cortar com tesoura de pontas arredondadas e colar pedaços de papel pequenos.
O
LETRAMENTO MATEMÁTICO
Com relação ao letramento matemático, é fundamental que ele ocorra de forma integrada com todos os componentes curriculares. Para isso, ao abordar os conteúdos, procure criar situações didáticas contextualizadas que incentivem os estudantes a desenvolverem o raciocínio lógico e a aplicarem o conhecimento matemático na busca de soluções para situações-problema do cotidiano. Essa abordagem facilita a compreensão dos conceitos e reforça sua relevância.
Além disso, as atividades a seguir contribuem para o letramento matemático, por exemplo:
• contagem de objetos usando materiais concretos, como tampinhas e lápis;
• uso e escrita de algarismos por meio de jogos e brincadeiras;
• compreensão do conceito de números; realização de operações básicas; e reconhecimento de formas geométricas na identificação de quantidades e na ordenação de elementos;
• comparação de medidas com o uso de instrumentos não padronizados, como palmos e passos;
• leitura e interpretação de gráficos e tabelas com dados reais sobre a turma e a escola.
A INCLUSÃO NAS ESCOLAS
Garantir a inclusão de estudantes com deficiência na escola regular não é apenas um dever legal, mas um compromisso ético e pedagógico com a equidade e a justiça social. A legislação brasileira, incluindo a Constituição Federal (1988), a Lei Brasileira de Inclusão (LBI) (2015) e as Diretrizes da Política Nacional de Educação Especial (2008), reforça o papel da escola em assegurar que todos os estudantes tenham acesso a uma educação de qualidade.
Contudo, a inclusão vai além de permitir o acesso físico à sala de aula. Ela exige a participação ativa dos estudantes no cotidiano escolar, promovendo aprendizagens significativas e respeitando suas particularidades. Para isso, é essencial o envolvimento de toda a comunidade escolar na construção de um ambiente que valorize as diferenças e que favoreça as interações e o respeito à diversidade. Nesse contexto, o papel do professor é central, como mediador e agente de transformação.
O primeiro passo mais importante é levar ao professor o reconhecimento das diversas dificuldades que deverá encontrar, suas especificidades, suas formas de atuação e como identificá-las em seus alunos. Neste processo, ao professor caberá a autonomia de reconhecer as dificuldades e intervencionar, em sala de aula, para a aplicação de novas metodologias e saberes, para a chegada da cognição.
JOIA, Michele. A inclusão de crianças na escola: o papel do educador diante das dificuldades de aprendizagem. 2. ed. Rio de Janeiro: Wak Editora, 2023. p. 41. A prática pedagógica inclusiva deve reconhecer que todo estudante tem a capacidade de aprender, desde que seja incentivado por vínculos afetivos e em um ambiente acolhedor. Para isso, as estratégias precisam ser flexíveis e adaptadas às necessidades individuais.
PRÁTICAS PEDAGÓGICAS INCLUSIVAS
A seguir, sugerimos algumas ações que podem ser aplicadas em sala de aula para promover a inclusão.
• Materiais concretos e táteis: utilize materiais com diferentes texturas e relevos para que os estudantes possam explorar o conteúdo de forma sensorial. Ao utilizar recursos visuais, sempre descreva as imagens com clareza, indicando posições e características dos objetos.
• Comunicação clara: apresente os enunciados
das atividades de forma clara e direta, evitando ambiguidades, figuras de linguagem ou construções muito complexas. Divida as tarefas em etapas menores e forneça uma instrução por vez. Durante as explicações, posicione-se de frente para os estudantes, facilitando a atenção à sua fala.
• Flexibilização e ritmo: ofereça prazos flexíveis para a entrega de atividades, respeitando o tempo de aprendizagem de cada estudante. Incentive a leitura compartilhada de textos e enunciados para promover a compreensão coletiva e o apoio mútuo.
• Incentivo à expressão: incentive a expressão oral, quando possível, e a organização do pensamento dos estudantes, auxiliando na estruturação das ideias. Ferramentas como alfabeto móvel e banco de palavras são ótimas aliadas para a alfabetização e o fortalecimento da participação dos estudantes no processo de aprendizagem.
• Uso de tecnologia: quando possível, adote recursos tecnológicos que atendam às necessidades específicas dos estudantes, ampliando as possibilidades de acesso ao conteúdo e tornando o aprendizado mais dinâmico e acessível.
• Valorização de estratégias de resolução de problemas: apresente e valorize diferentes estratégias para a resolução de problemas, respeitando a forma única de compreensão e de elaboração de soluções.
O USO DE METODOLOGIAS ATIVAS
O uso de metodologias ativas favorece o engajamento dos estudantes e o desenvolvimento de diversas habilidades. A prática pedagógica exige um planejamento cuidadoso, momentos de discussão em grupo, atividades colaborativas e trocas de saberes, especialmente quando o objetivo é fortalecer competências como leitura, escrita e raciocínio lógico-matemático.
[...]
Metodologias ativas são estratégias de ensino centradas na participação efetiva dos estudantes na construção do processo de aprendizagem, de forma flexível, interligada e híbrida. As metodologias ativas, num mundo conectado e digital, expressam-se por meio de modelos de ensino híbridos, com muitas possíveis combinações. A junção de metodologias ativas com modelos flexíveis e híbridos traz contribuições importantes para o desenho de soluções atuais para os aprendizes de hoje.
MORAN, José. Metodologias ativas para uma aprendizagem mais profunda. In: BACICH, Lilian; MORAN, José (org.). Metodologias ativas para uma educação inovadora: uma abordagem teórico-prática. Porto Alegre: Penso, 2018. p. 4.
A seguir, apresentamos três metodologias ativas
que promovem o protagonismo e a autonomia dos estudantes.
Pensar-conversar-compartilhar
É uma estratégia eficaz para aumentar o engajamento dos estudantes, pois promove o pensamento individual e a colaboração, permitindo que todos participem ativamente da aula. A fase individual garante que todos os estudantes tenham oportunidade de organizar suas ideias e de se expressarem. A fase em duplas e a discussão geral mantêm os estudantes ativos e envolvidos no processo de aprendizagem, incentivando o pensamento crítico, a argumentação e a formulação de ideias. Para iniciar, você deve fazer uma pergunta ou lançar um desafio relacionado ao conteúdo da aula e estipular um tempo para os estudantes pensarem sozinhos na resposta. É o momento de organizar as ideias e formular uma primeira hipótese. Depois do tempo de reflexão individual, os estudantes se juntam a um colega. Em duplas, eles devem conversar, compartilhar ideias e chegar a uma conclusão, consolidando o raciocínio e construindo o conhecimento de forma colaborativa. Na etapa final, o professor deve escolher algumas duplas, ou todas, para apresentarem suas ideias, incentivando a participação de todos, levando-os a perceber que há diferentes formas de pensar e de resolver o mesmo problema. Vire e fale
Essa estratégia é eficaz para aumentar o engajamento e a participação dos estudantes, pois modifica o formato de pergunta e resposta e cria um espaço para que eles possam expressar suas ideias. A conversa em duplas incentiva os estudantes a organizarem suas ideias e a praticarem a escuta ativa. É uma estratégia rápida e simples que pode ser utilizada várias vezes durante a aula para checar a compreensão e manter o ritmo de forma dinâmica e interativa. Para começar, faça uma pergunta clara e direta relacionada ao conteúdo que está sendo trabalhado e que possa ser respondida em cinco minutos. Imediatamente após a pergunta, peça aos estudantes que virem para um dos colegas para conversarem sobre a pergunta, tentando chegar a uma resposta em até cinco minutos. Esse é o momento em que eles devem verbalizar suas ideias uns para os outros, escutando o que o outro tem a dizer e chegando juntos a uma conclusão. Após a conversa em duplas, escolha alguns estudantes, ou todos, para compartilharem as ideias que surgiram nas duplas e faça intervenções quando julgar necessário. Caminhada na galeria
Essa é uma estratégia colaborativa que envolve a produção de cartazes sobre os conteúdos estudados que devem ser expostos como em uma galeria de arte. A atividade foge da rotina da sala de aula e envolve movimento, o que é indicado para essa faixa etária. Os estudantes aprendem uns com os outros e desenvolvem a capacidade de escutar e argumentar, além de aprimorar a comunicação, o raciocínio e a organização de ideias de forma lúdica e prática, aprofundando os conteúdos que aprenderam. Para empregar essa metodologia, organize a turma em grupos e proponha um tema, uma pergunta ou um problema para ser trabalhado em cada grupo. Oriente os grupos a fazerem pesquisas sobre o assunto e a registrarem as conclusões em cartazes. Depois de prontos, os cartazes devem ser fixados na sala de aula, como se fossem obras de arte, e cada grupo deve escolher um apresentador que ficará ao lado para explicar o trabalho. O restante da turma, em grupos, começa a caminhada pela galeria, observando e analisando as produções dos colegas. Após todos os grupos visitarem as obras da galeria, reúna todos e incentive uma conversa sobre o que foi aprendido. Esse é o momento para discutir as diferentes soluções encontradas, os pontos em comum e o que mais chamou a atenção dos estudantes.
A ORGANIZAÇÃO DO ESPAÇO
Para a organização do trabalho pedagógico em sala de aula, é essencial considerar a disposição do espaço e promover um ambiente pautado pela empatia, pelo respeito mútuo e pela valorização do coletivo, o que contribui para a construção de uma sala de aula acolhedora, na qual o desenvolvimento da autonomia dos estudantes seja incentivado de forma constante.
A fim de promover um ambiente mais dinâmico, inclusivo e colaborativo, você pode alterar a organização tradicional da sala de aula, que tem carteiras enfileiradas e o professor ocupando o papel central como único detentor do saber. Ao repensar a organização da sala de aula como um recurso pedagógico, você amplia as possibilidades de interação, cooperação e construção coletiva do conhecimento, aproximando a prática docente das demandas reais da turma. A seguir, apresentamos algumas sugestões para organizar a sala de aula de diferentes maneiras.
Disposição em grupo: indicada para atividades que exigem colaboração direta e trocas constantes en-
tre os estudantes, como trabalhos em equipe, debates e projetos que precisam de divisão de tarefas, pois a proximidade física facilita a comunicação e o apoio mútuo, incentivando a resolução de problemas de forma coletiva.

Representação de carteiras dispostas em grupo.
Disposição em círculo: indicada para atividades que priorizam a participação de todos, a escuta ativa e a criação de um ambiente de igualdade, como rodas de conversa, discussões sobre temas específicos, contação de histórias e compartilhamento de experiências,
permitindo que a construção do conhecimento, a troca de experiências e a comunicação sejam mais diretas e isonômicas entre você e os estudantes.

Representação de carteiras dispostas em círculo.
Disposição em U: indicada para apresentações orais, demonstrações, debates supervisionados ou quando você precisa circular entre as carteiras para dar assistência individual, pois combina sua visibilidade com a possibilidade de interação entre os estudantes, permitindo que todos mantenham o foco na atividade.

Representação de carteiras dispostas em U.
Disposição de frente uns para os outros: parecida com a disposição em grupo, mas pode ser utilizada para trabalhos em duplas, entrevistas ou atividades de reflexão, pois promove uma interação mais focada e próxima, permitindo aos estudantes que se concentrem na troca de informações e ideias entre si, sem a dispersão que um grupo maior poderia causar.

Representação de carteiras dispostas de frente umas para as outras.
Outra estratégia que ajuda a aproximar o currículo da vida dos estudantes é incentivar a utilização de outros espaços dentro e fora da sala de aula para
divulgar o trabalho desenvolvido pela turma, como os murais e as paredes, explorando diferentes recursos e estratégias.
A ORGANIZAÇÃO DO TEMPO E DA ROTINA ESCOLAR
Além da organização do espaço físico, é fundamental atentar à gestão do tempo e da rotina em sala de aula. Estabelecer uma rotina clara e bem estruturada favorece a execução do planejamento pedagógico, garantindo que os horários e as atividades sejam conduzidos de forma sequencial e coerente, sempre respeitando as particularidades e os diferentes ritmos de aprendizagem dos estudantes.
Planejar a prática pedagógica de acordo com a proposta curricular proporciona um ambiente mais estável e acolhedor, no qual os estudantes sabem o que esperar e se sentem mais seguros diante das estratégias utilizadas no dia a dia. Além de facilitar a condução do trabalho docente, essa organização contribui para equilibrar e diversificar as atividades ao longo da semana, ampliando as possibilidades de aprendizagem.
Além das aulas nas quais os conteúdos e as atividades são abordados, é importante que você inclua atividades diversificadas em seu planejamento de rotina, como as sugeridas a seguir.
• Rodas de conversa: podem ser realizadas no começo ou no final da aula para solicitar aos estudantes que relatem alguma vivência pessoal (como forma de explorar os conhecimentos prévios) ou exponham o que aprenderam, quais dificuldades tiveram ou o que gostariam de aprender na próxima aula.
• Momentos de leitura: esses momentos podem ser conduzidos tanto por você, por meio da leitura em voz alta, quanto pelos próprios estudantes, com a leitura compartilhada ou um de cada vez. É importante reservar intervalos de tempo específicos na rotina para a leitura de diferentes textos com a intenção de proporcionar momentos de apreciação e, ao mesmo tempo, ampliar o repertório e os conhecimentos dos estudantes.
• Momentos de registro: essa estratégia consiste em reservar, ao final das aulas, alguns minutos para que os estudantes expressem o que aprenderam. Esse registro pode ser feito por meio da escrita, de esquemas visuais, de desenhos ou até pela oralidade, com gravações em áudio ou vídeo. Essa etapa funciona como uma forma de verificação da aprendizagem, permitindo a você identificar o que foi compreendido e o que ainda precisa ser retomado em aulas futuras ou em atividades de reforço. Os registros podem ser realizados
ILUSTRAÇÕES: IVY NUNES/ ARQUIVO DA EDITORA
individualmente, em duplas ou em pequenos grupos, de acordo com os objetivos da proposta.
• Visitas guiadas a diferentes espaços de aprendizagem: a sala de aula não é o único ambiente para o aprendizado dos estudantes, por isso é importante sugerir atividades em outros espaços na escola, como laboratórios, bibliotecas, pátio, auditório e jardim, e fora da escola, como teatros, museus, espaços públicos, centros de pesquisas, cinema e centros culturais. Em casos de atividades em espaços fora da escola, é necessário que você solicite, com antecedência, as autorizações para a direção e para os pais ou responsáveis dos estudantes e o acompanhamento de outros pro-
Escola:
preencher com o nome da escola.
preencher com o nome da escola.
Professor(a):
preencher com o nome do professor.
fissionais da escola, bem como oriente sobre o uso de filtro solar, a ingestão de água e o uso de repelentes e de vestimentas e calçados adequados, visando à segurança, à integridade física e ao bem-estar dos estudantes.
Além dessas atividades, o planejamento de rotina deve incluir atividades lúdicas que incentivem a interação social e momentos que envolvam alimentação e higiene pessoal.
Apresentamos a seguir um exemplo de planejamento de rotina, que pode ser adaptado de acordo com as suas necessidades, as dos estudantes e as da escola.
preencher com o nome do componente curricular. preencher com o período do planejamento.
Componente curricular: Turma:
Data:
Horário Local
Planejamento de rotina
Atividade
preencher com a indicação da turma.
MODELO
Objetivos
7h30 – 8h00Sala de aulaAcolhimento e roda de conversa. Promover a socialização e desenvolver a oralidade.
8h00 – 9h30Sala de aula
9h30 – 10h00 Refeitório, banheiro e pátio
10h00 – 11h00 Quadra
Leitura compartilhada de textos e atividades dirigidas de escrita.
Lanche, escovar os dentes, lavar as mãos e recreio.
Brincadeiras tradicionais e jogos cooperativos.
11h00 – 11h30 Sala de aulaRoda de leitura e fechamento.
Outro recurso pedagógico que pode auxiliar a gestão do tempo e o planejamento de rotina é a sequência didática. Uma sequência didática é um plano de ensino estruturado, composto de um conjunto de atividades ordenadas e interligadas que são desenvolvidas ao longo de várias aulas. A elaboração de sequências didáticas é um recurso pedagógico que pode tornar o planejamento mais eficaz e alinhado às necessidades dos estudantes. Por meio delas, você consegue organizar o processo de ensino de maneira intencional e progressiva, estruturando atividades e estratégias de forma coerente e articulada.
Ao planejar uma sequência didática, você estabelece etapas claras e encadeadas que favorecem a construção do conhecimento ao longo do tempo, seja
Desenvolver habilidades de leitura e de escrita.
Momento de descanso, alimentação, higiene e interação livre.
Desenvolver a expressão corporal e a coordenação motora.
Desenvolver a escuta ativa, retomar as aprendizagens do dia e organizar a sala de aula.
em alguns dias, semanas ou até meses. Essa organização permite flexibilizar o percurso, ajustando-o conforme o ritmo de aprendizagem da turma e as particularidades do contexto escolar.
É fundamental que as sequências estejam alinhadas aos objetivos de ensino, considerando também os recursos didáticos disponíveis e a realidade da escola.
Outro aspecto essencial é a inclusão de estratégias de avaliação que permitam acompanhar e refletir sobre o avanço dos estudantes ao longo do processo, verificando seu envolvimento e observando as dificuldades que possam surgir. Sempre que julgar necessário, faça intervenções que contribuam para ampliar a compreensão dos conteúdos.
Ao término da sequência didática, registre suas considerações sobre o processo de aprendizagem dos estudantes, destacando avanços e aspectos que ainda precisam ser desenvolvidos.
A seguir, apresentamos uma sugestão de modelo de sequência didática que pode servir como referência. Sinta-se à vontade para adaptá-lo conforme as necessidades da sua turma e os conteúdos que pretende desenvolver.
Planejamento de sequência didática
Escola: preencher com o nome da escola.
Professor(a): preencher com o nome do professor.
Componente curricular: preencher com o nome do componente curricular.
Turma: preencher com a indicação da turma.
Data: preencher com o período estimado para o desenvolvimento da sequência didática.
Assunto/conteúdo: preencher com os assuntos ou conteúdos a serem desenvolvidos.
Quantidade de aulas: preencher com a estimativa da quantidade de aulas que será necessária para desenvolver todas as atividades.
1. Objetivos gerais: definir o que se espera que os estudantes sejam capazes de fazer ao final da sequência didática.
2. Competências e habilidades da BNCC: identificar as habilidades da BNCC que serão trabalhadas.
3. Materiais necessários: fazer uma lista detalhada de todos os materiais que serão necessários para desenvolver as atividades.
4. Etapas da sequência didática: detalhar as etapas de cada aula, organizando as atividades em uma ordem lógica e progressiva.
• Aula 1: descrever o início do trabalho com a sequência didática, que pode ser uma atividade para verificar o que os estudantes já sabem sobre o assunto; pode ser uma roda de conversa, uma dinâmica ou uma pergunta deflagradora para despertar a curiosidade deles.
• Aula 2 em diante: descrever as atividades intermediárias que ajudarão os estudantes a construírem o novo conhecimento; podem ser pesquisas, leituras, discussões, atividades práticas, entre outras dinâmicas.
• Aula final: descrever a última aula, a culminância da sequência didática; planejar uma atividade final para que os estudantes coloquem em prática tudo o que aprenderam; pode ser a produção de um texto, a apresentação de um trabalho ou a criação de um projeto.
5. Avaliação: definir os critérios (o que será observado) e os instrumentos (como será registrado) que serão utilizados para avaliar a aprendizagem dos estudantes ao longo da sequência didática; a avaliação deve ser contínua e não apenas ao final.
6. Autoavaliação: após a execução da sequência didática, verificar se ela foi eficaz, se os objetivos foram alcançados, quais desafios surgiram e o que pode ser mudado para a próxima vez e anotar essas reflexões para aprimorar suas práticas pedagógicas.
O USO DE TECNOLOGIAS DIGITAIS
A presença das tecnologias digitais no cotidiano das pessoas é cada vez mais comum, inclusive entre crianças e adolescentes. No entanto, a maneira como esses recursos, especialmente os dispositivos móveis como os celulares, têm sido utilizados dentro das escolas tem gerado muitos debates. O foco dessas discussões recai, principalmente, sobre os efeitos negativos do uso inadequado desses aparelhos no processo de aprendizagem e no desenvolvimento integral dos estudantes.
Estudos recentes reforçam essas preocupações, apontando prejuízos que vão desde a distração em sala
de aula até impactos mais sérios, como problemas de saúde física e mental, que incluem aumento da ansiedade, distúrbios do sono, dificuldades de atenção, entre outros. Essas evidências contribuíram para a criação da Lei nº 15.100, de 13 de janeiro de 2025, que estabelece diretrizes para o uso de celulares nas escolas brasileiras.
Os desafios enfrentados com o uso inadequado e desregulado das tecnologias digitais não se restringem ao ambiente escolar. A Unesco destaca riscos que vão desde o enfraquecimento das relações humanas até ameaças à democracia e aos direitos fundamentais,
como a disseminação de discursos de ódio e a violação da privacidade. Tais aspectos mostram que a tecnologia, sem orientação adequada, pode acentuar desigualdades e comprometer valores essenciais.
No contexto escolar, o uso excessivo e sem propósito de recursos digitais tem mostrado efeitos prejudiciais, como o isolamento social, a dependência de redes sociais e a dispersão durante as aulas. Por isso, torna-se indispensável repensar o papel desses recursos na educação.
Por outro lado, quando inserida de maneira planejada e intencional no cotidiano escolar, a tecnologia pode se tornar uma ferramenta poderosa para o processo de ensino-aprendizagem. Recursos como computadores, tablets e celulares, quando utilizados com orientação pedagógica, promovem o acesso à informação, favorecem o desenvolvimento de habilidades críticas e éticas e ampliam o alcance da educação, especialmente em contextos de vulnerabilidade.
A proposta, portanto, não é excluir a tecnologia do ambiente escolar, mas sim incorporá-la com responsabilidade, sempre pautada em objetivos pedagógicos claros e alinhados às competências e aos conteúdos previstos no currículo.
Você tem um papel fundamental nesse processo. Cabe a você planejar atividades que utilizem de forma significativa a tecnologia, promovendo a aprendizagem ativa e a reflexão crítica por parte dos estudantes. A intencionalidade no uso desses recursos deve estar presente desde o momento da escolha da ferramenta até a avaliação dos resultados.
Além disso, é importante lembrar que tecnologias educacionais não se limitam às mais recentes. Televisão, rádio, lousa, projetores e outros dispositivos já fazem parte da rotina escolar há décadas e desempenham papel importante na mediação pedagógica.
BOAS PRÁTICAS NO USO DE TECNOLOGIAS NA EDUCAÇÃO
Para que a utilização de ferramentas tecnológicas seja eficaz e enriquecedora, é fundamental adotar algumas práticas pedagógicas intencionais. A seguir, apresentamos algumas dicas.
PLANEJAMENTO PEDAGÓGICO DO USO DE RECURSOS TECNOLÓGICOS
• Definir com clareza os objetivos de aprendizagem.
• Escolher as ferramentas tecnológicas adequadas para alcançar esses objetivos.
• Garantir que o uso dos recursos esteja articulado aos conteúdos e às competências curriculares.
DESENVOLVIMENTO DE HABILIDADES CRÍTICAS
• Propor atividades que incentivem a análise crítica de fontes de informação pelos estudantes.
• Levar os estudantes a refletirem sobre o impacto da tecnologia no cotidiano.
• Incentivar o uso consciente, seguro e responsável da internet.
INTEGRAÇÃO COM OUTRAS METODOLOGIAS
• Combinar o uso de tecnologias com estratégias convencionais, como leitura, escrita e pesquisa de campo.
• Incentivar experiências interativas, como a visita a museus virtuais e o uso de acervos digitais, que ampliam o repertório cultural dos estudantes e fortalecem vínculos com a memória coletiva.
Em resumo, o uso da tecnologia na educação não deve ser encarado como uma solução isolada ou um fim em si mesmo. Ela deve estar a serviço do processo de ensino-aprendizagem e contribuir para a formação crítica, ética e cidadã dos estudantes. Seu olhar pedagógico enquanto docente é essencial para transformar esses recursos em verdadeiros aliados do conhecimento.
Para auxiliar na utilização de recursos digitais em consonância com seu planejamento pedagógico, a fim de complementar e enriquecer o desenvolvimento dos conteúdos, esta coleção apresenta alguns objetos educacionais digitais, como infográficos clicáveis.
A lista com os objetos digitais sugeridos em cada volume encontra-se no sumário. Além disso, os momentos de utilização desses recursos foram indicados nas páginas do Livro do Estudante por meio de ícones. Para acessá-los, basta clicar sobre os ícones indicados nas páginas da versão digital do Livro do Estudante.
O ENSINO DE CIÊNCIAS DA NATUREZA
FUNDAMENTOS
TEÓRICO - METODOLÓGICOS NO ENSINO DE CIÊNCIAS
DA NATUREZA
A curiosidade é uma característica que se mostra bastante presente nos primeiros anos de vida, fase esta
de intenso desenvolvimento cognitivo e permeada de inúmeros questionamentos sobre si mesmo e o próprio corpo e sobre aquilo que o rodeia, como os seres vivos, os fenômenos naturais e os objetos de uso cotidiano.
Nesse cenário, o ensino de Ciências da Natureza se compromete em promover o letramento científico
dos estudantes, contribuindo para que eles sejam capazes de interpretar e compreender o mundo que os cerca, bem como intervir e transformar esses ambientes, aliando conhecimento científico a acontecimentos cotidianos e eventos naturais.
Essa atuação dos estudantes na sociedade deve ocorrer de maneira consciente, embasada em princípios éticos e sustentáveis. Para isso, deve-se considerar também que os estudantes carregam consigo vivências e diversos conhecimentos prévios a respeito do mundo que os cerca, alguns deles insuficientes ou, até mesmo, equivocados. Cabe, portanto, ao ensino de Ciências da Natureza fornecer subsídios para que esses estudantes possam, de maneira autônoma, questionar esses conhecimentos, analisá-los criticamente e elaborar respostas com embasamento científico, desenvolvendo um novo olhar de mundo e da realidade próxima.
Ao longo do Ensino Fundamental, o ensino de Ciência da Natureza deve possibilitar aos estudantes dominarem alguns dos processos inerentes ao método científico. Nesta coleção, os estudantes são incentivados a desenvolver e dominar processos como observação, identificação de problemas, elaboração e teste de hipóteses, análise de resultados e reflexão sobre procedimentos que auxiliam na resolução de problemas e na elaboração de respostas. Além disso, a vivência do saber científico se manifesta no confronto, na discussão e na argumentação de ideias e opiniões com os colegas.
Para que os estudantes possam alcançar o raciocínio científico, o processo de alfabetização científica é fundamental. O uso da terminologia científica e da interpretação de informação apropriada estabelece relações entre Ciência, Sociedade, Saúde, Tecnologia e Ambiente e mostra como essas áreas impactam o conhecimento científico e sua aplicação.
[...]
De modo geral, pode-se dizer que alfabetização científica é um conceito que reflete um objetivo educacional contemporâneo.
É o domínio, por parte da população em geral, de conhecimentos básicos sobre ciência, para capacitar as pessoas a se comportarem como consumidores de forma responsável e eficaz, bem como posicionar-se acerca de questões relativas a políticas científicas, garantindo às ações governamentais voltadas para a ciência uma
natureza democrática com participação efetiva dos cidadãos (Miller, 2000a; 2000b).
[...]
SCHULZE, Clélia Nascimento; CAMARGO, Brigido; WACHELKE, João. Alfabetização científica e representações sociais de estudantes de ensino médio sobre ciência e tecnologia. Arquivos Brasileiros de Psicologia, v. 58, n. 2, 2006. p. 26. Disponível em: http://pepsic.bvsalud.org/pdf/arbp/ v58n2/v58n2a04.pdf. Acesso em: 15 set. 2025.
Diante das exigências da sociedade atual, os conhecimentos científico e tecnológico são essenciais na formação integral dos estudantes, a fim de que se tornem cidadãos críticos e capazes de compreender o mundo e suas transformações, bem como invalidar informações não científicas e inviabilizar sua veiculação. Essa criticidade, no entanto, deve estar acompanhada do respeito a diferentes opiniões para promover uma sociedade justa, igualitária e pluralista.
O desenvolvimento e o domínio de processos investigativos devem ser considerados elementos essenciais na formação integral dos estudantes. Nesse sentido, é fundamental considerar os objetivos do ensino de Ciências, como os listados a seguir.
[...]
• entender as relações entre Ciência, Tecnologia, Sociedade;
• analisar o papel do homem nas transformações ambientais e suas consequências para todos os seres vivos;
• superar as representações e explicações “mágicas” de vários fenômenos naturais e suas transformações;
• compreender o corpo humano como sistema que interage com o ambiente e a condição de saúde ou doença resultantes do ambiente físico e social.
[...]
BORGES, Gilberto Luiz de Azevedo. O que devemos esperar do ensino de ciências e o que observamos em sala de aula: objetivos em questão. Conteúdos e Didática de Ciências e Saúde, v. 10, 2012. p. 45. Disponível em: https://acervodigital.unesp.br/bitstream/123456789/47358/1/ u1_d23_v10_t02.pdf. Acesso em: 15 set. 2025.
Ao considerar o papel do ensino de Ciências da Natureza na formação integral dos estudantes, é preciso ter em mente a importância do livro didático como uma ferramenta de apoio em sala de aula. Nesse sentido, a presente coleção foi planejada especialmente para os Anos Iniciais do Ensino Fundamental, de modo a possibilitar o avanço gradual na complexidade dos conteúdos, apoiados por atividades e procedimentos investigativos, permitindo aos estudantes entrar em contato de maneira elementar com alguns conceitos que envolvem o conhecimento científico.
Ao longo dos volumes da coleção, os estudantes são expostos a situações desafiadoras, adequadas ao nível
de ensino, que promovem a curiosidade científica. Além disso, a coleção apresenta algumas sugestões metodológicas que se alinham à proposta pedagógica e que podem auxiliar no trabalho docente, podendo ser adaptável à realidade social e cultural de cada estudante.
A ação docente na sala de aula deve proporcionar aos estudantes momentos de reflexão e estímulo à investigação científica e à formação cidadã, dando a eles oportunidade para fazerem questionamentos e expressarem suas opiniões e ideias, suprindo as necessidades de respostas por parte dos estudantes. O professor pode, portanto, auxiliar os estudantes na busca e na construção de conhecimentos.
Nesse contexto, a presente obra busca propiciar a reflexão sobre a prática docente, ressaltando que, na formação cidadã, o papel do professor como mediador da aprendizagem é essencial, auxiliando os estudantes a desenvolverem uma postura crítica e ativa na construção do conhecimento. [...]
No processo de mediação entre o aluno e o objeto do conhecimento, o professor atua, intencionalmente, como agente cultural externo, possibilitando aos alunos o contato com a realidade científica. Como mediador, o trabalho do professor consiste em ações intencionais que conduzem os alunos à reflexão sobre os conceitos que estão sendo propostos. (GASPARIN, 2005, p. 116).
Ao propor situações concretas como problemas, o professor cria um ambiente desafiador, que [produz] respostas tanto no âmbito intelectual quanto no âmbito da ação, desestabilizando conhecimentos existentes e criando situações para a apropriação de novos conhecimentos. [...] CAMPOS, Raquel Sanzovo Pires de; CAMPOS, Luciana Maria Lunardi. A formação do professor de ciências para os anos iniciais do ensino fundamental e a compreensão de saberes científicos. Amazônia –Revista de Educação em Ciências e Matemáticas, v. 13, n. 25, jul./ dez. 2016. p. 138. Disponível em: https://periodicos.ufpa.br/index.php/ revistaamazonia/article/download/3812/4048. Acesso em: 16 set. 2025.
ESTRATÉGIAS QUE AUXILIAM NO DESENVOLVIMENTO DIDÁTICO DOS CONTEÚDOS DE CIÊNCIAS DA NATUREZA
Quando falamos de ensino de Ciência, é essencial destacar a importância dos conhecimentos prévios dos estudantes com relação aos objetos científicos obtidos fora da escola, que não devem ser descartados pelo professor, mas sim utilizados como base para a construção da compreensão dos fenômenos naturais.
[...] Os conhecimentos prévios formam-se a partir de concepções espontâneas e intuitivas
acerca de situações e fenômenos da vida cotidiana, de representações sociais transmitidas culturalmente e a partir de analogias: quando o aluno não possui imagens concretas para determinado conhecimento, faz determinadas associações, cria modelos para entendê-lo. [...]
HOFFMANN, Jussara. Avaliar para promover: as setas do caminho. 15. ed. Porto Alegre: Mediação, 2014. p. 87-88. Com base na identificação dos conhecimentos prévios, o professor pode planejar e rever suas ações pedagógicas, adaptando seu planejamento. Para tal, é necessário utilizar estratégias que o auxiliam no desenvolvimento didático dos conteúdos, como problematização, observação, trabalho em grupo e experimentação investigativa.
Problematização
Na atualidade, os problemas acerca das ciências estão nos diferentes meios de comunicação e nas mídias sociais. Por isso, o professor deve estar atento à realidade apresentada aos discentes e ajudá-los a analisar as situações por meio de um ponto de vista científico.
A análise de conceitos ou situações-problema em situações do cotidiano é a problematização. Essa abordagem coloca suposições não científicas frente a explicações coerentes aos fenômenos e acontecimentos que ocorrem na sociedade e no mundo que cerca a realidade dos estudantes.
Os conhecimentos prévios dos estudantes, por vezes insuficientes, podem ser confrontados com situações reais. Para buscar determinadas respostas, os conhecimentos não científicos podem ser insatisfatórios e não responder adequadamente às indagações. Com isso, há a necessidade de desenvolver novos conhecimentos para resolver os problemas, possibilitando a reconstrução das ideias e a elaboração de novas explicações.
As situações-problema apresentadas também devem ser instigantes, motivando os estudantes a reelaborarem hipóteses e explicações. Além disso, o papel docente é fundamental na mediação e na desestabilização dos modelos prévios deles. O professor de Ciências pode ajudá-los em situações de conflito e na mobilização de novos conhecimentos, tornando a aprendizagem um processo ativo e significativo.
Observação
A observação é uma estratégia fundamental no ensino de Ciências, podendo ser direta ou indireta. Além dos conhecimentos prévios, os estudantes têm capacidade natural de perceber o mundo por meio dos
sentidos. Essa percepção se relaciona à observação direta, que se baseia em observações visuais, cheiros, gostos, texturas e diferentes sensações. Nesse processo, é fundamental que eles possam manipular objetos e visitar diferentes espaços de ensino, tanto formais como informais.
A observação indireta pode utilizar diferentes instrumentos, como fotografias, filmes, micrografias e telescópios. Atividades envolvendo esse tipo de observação podem ser registradas textualmente ou por meio de desenhos.
Dessa maneira, o processo de observação utiliza a curiosidade dos estudantes, associando-os à sua capacidade de sentir o mundo ao redor e manipulá-lo quando possível, de modo a esclarecer suas dúvidas e a responder a seus questionamentos. Nesse tipo de atividade, o professor atua como mediador, solicitando a eles que façam registros, discussões e debates, confrontando suas percepções e conclusões.
Essa estratégia pode ser utilizada no início do trabalho com determinados temas ou pode ser parte de um trabalho em grupo ou uma atividade investigativa.
Trabalho em grupo
O trabalho em grupo é uma estratégia bastante adotada em sala de aula. Seu uso deve estar no planejamento escolar, pois apresenta objetivos bastante específicos e é direcionado para fins determinados.
Ele envolve a interação e a cooperação entre diferentes indivíduos. É importante oportunizar diferentes formatos do trabalho em grupo com base em metodologias ativas, incluindo salas de aula invertidas, aprendizagem baseada em equipe, entre outras maneiras, de modo que todos os estudantes possam interagir e, dessa forma, colaborar uns com os outros na construção dos conhecimentos, tornando a aprendizagem um processo ativo.
O trabalho em grupo pode garantir momentos de fala, reflexão, discussão, troca de ideias e argumentação. Pela necessidade de diálogo e conclusões comuns ao grupo, os indivíduos precisam negociar e dialogar entre si, oportunizando a participação ativa de todos. Em grupo, o docente deve permitir que os estudantes se defrontem com situações que possibilitam a reorganização e a reconstrução de ideias pelo trabalho colaborativo.
Atividades de experimentação investigativa
Entre as possibilidades do ensino de Ciências está a de oportunizar aos estudantes o levantamento de hipóteses, bem como a de testá-las por meio da experimentação.
Nessa estratégia, o estudante pode manipular diferentes materiais, construir objetos e ferramentas e levantar diferentes questionamentos, o que lhe permite vivenciar o saber científico.
[...]
A experimentação pode ocupar um papel essencial na consolidação de conceitos a serem apreendidos, a partir da maneira como o docente desenvolve sua metodologia durante as aulas, baseando-se naquilo que o discente já conhece e o que está apto a descobrir, já que ao se estabelecer um problema criado pelo professor que será o mediador desse processo, cabe ao aluno realizar alguns experimentos e, por meio da observação cuidadosa e da coleta de dados, obter possíveis soluções (Carvalho et al., 2009; Sasseron & Machado, 2017).
[...]
COELHO, Antonia Ediele de Freitas; MALHEIRO, João Manoel da Silva. O ensino de ciências para os anos iniciais do ensino fundamental: a experimentação como possibilidade didática. Research, Society and Development, v. 8, n. 6, 2019. Disponível em: https://www.redalyc.org/ jatsRepo/5606/560662197022/html/index.html. Acesso em: 15 set. 2025.
Para isso, os professores auxiliam os estudantes, levantando situações-problema e questionando como elas podem ser resolvidas. Para tal, eles levantam hipóteses, e o docente os direciona a testar suas ideias. Assim, o processo de investigação científica torna-se essencial à construção de conhecimentos, e o papel do professor é essencial para motivar e orientar os estudantes.
O professor deve anotar seus resultados, comparando suas observações e como elas respondem aos questionamentos iniciais. Ao confrontarem diferentes resultados, eles precisam observar as etapas e o procedimento adotado, assim como argumentar suas conclusões.
Visitas guiadas
Outra alternativa ao ensino de Ciências é a visitação a espaços não formais de ensino, como planetários, herbários, parques e museus. Além de sair do ambiente de sala de aula, os estudantes vivenciam, nesses lugares, os conhecimentos científicos, tomando como base a observação. Essa experiência pode ser significativa, contribuindo para o desenvolvimento cognitivo deles.
Além de utilizar diferentes estratégias, é fundamental que os conhecimentos abordados nas aulas de Ciências estejam associados aos conteúdos dos demais componentes curriculares, permitindo a integração e a conexão entre as diferentes áreas do conhecimento. Essa visão integradora é essencial na compreensão do mundo e no desenvolvimento da cidadania.
QUADRO DE DISTRIBUIÇÃO DOS CONTEÚDOS
O quadro apresentado a seguir mostra a progressão dos conteúdos deste volume, destacando as habilidades, as competências e os temas contemporâneos transversais da BNCC trabalhados em cada unidade.
Trata-se de um quadro que pode ser utilizado para ter uma visão geral dos conteúdos das unidades, assim como facilitar a busca por orientações e comentários de práticas pedagógicas sugeridas nas orientações ao professor correspondentes ao Livro do Estudante
Quadro de distribuição dos conteúdos – 4º ano
UnidadeTema
1 – A movimentação dos astros e a nossa orientação no tempo e no espaço
1 – Orientação geográfica
2 – Movimento de rotação da Terra
3 – Movimento de translação da Terra
4 – Lua
5 - Calendário
Conteúdos
• Maneiras de orientações geográficas
• Grandes navegações e o conhecimento do céu
• Movimentos de rotação e translação da Terra
• Estações do ano
• Movimento de rotação e translação em outros planetas do Sistema Solar
• Ciclo lunar
• Calendários elaborados por diferentes povos
• Cientistas mulheres envolvidas na missão Apollo 11
Habilidades da BNCC
EF04CI09
EF04CI10
EF04CI11
Competências gerais e específicas
CG1; CG2; CG4; CG5; CG6; CG9
CECN 1; CECN 2; CECN 3; CECN 6
Temas contemporâneos transversais
• Ciência e tecnologia
• Trabalho
• Diversidade cultural
• Educação para valorização do multiculturalismo nas matrizes históricas e culturais brasileiras
2 – Transformações no ambiente e no dia a dia
6 – Transformações físicas e estados físicos dos materiais
7 – Transformações químicas dos materiais
8 – Transformações reversíveis e irreversíveis
9 – A transformação da matéria orgânica: decomposição
10 – Cadeias alimentares
11 – Desequilíbrio nas cadeias alimentares
• Estados físicos dos materiais
• Transformações físicas e químicas dos materiais
• Transformações na nutrição e respiração
• Transformações reversíveis e irreversíveis
• Transformação do plástico no ambiente
• Decomposição da matéria orgânica
• Cadeia e teia alimentar
• Transferência de nutrientes e de energia nas cadeias alimentares
• Desequilíbrio nas cadeias alimentares
• Espécies exóticas e invasoras
EF04CI02
EF04CI03
EF04CI04
EF04CI05
EF04CI06 CG2; CG4; CG7; CECN 2; CECN 3; CECN 5; CECN 6;
• Educação para o consumo
• Educação ambiental
• Ciência e tecnologia
• Educação para o trânsito
UnidadeTema
3 – Microrganismos
12 – Seres microscópicos
13 – Doenças causadas por seres microscópicos e sua prevenção
Quadro de distribuição dos conteúdos – 4º ano
Conteúdos Habilidades da BNCC
• Bactérias
• Fungos
• Protozoários
• Vírus
• Vacinação
• Tipos de transmissão de doenças transmissíveis
• Vacinação e desinformação
• Algumas doenças causadas por seres microscópicos e as maneiras de prevenção
• Ciência e tecnologia a serviço da saúde humana
EF04CI06
EF04CI07
EF04CI08
Competências gerais e específicas Temas contemporâneos transversais
CG1; CG2; CG5; CG7; CG8
CECN 1; CECN 2; CECN 3; CECN 4; CECN 6; CECN 7; CECN 8
• Ciência e tecnologia
• Saúde
• Trabalho
4 – Misturas no dia a dia
14 – Saneamento básico
15 – Tratamento da água
16 – Tratamento de esgoto
17 – Coleta de resíduos sólidos
• Estação de tratamento da água
• Estação de tratamento de esgoto
• Algumas doenças relacionadas à falta de acesso ao saneamento básico
• Coleta de resíduos sólidos
• Reciclagem
EF04CI01
EF04CI02
EF04CI03
EF04CI07
EF04CI08
CG2; CG3; CG4; CG5; CG7; CG8; CG9; CG10
CECN 2; CECN 3; CECN 4; CECN 5; CECN 6; CECN 7; CECN 8
• Saúde
• Educação em direitos humanos
• Ciência e tecnologia
• Educação ambiental
• Educação para valorização do multiculturalismo nas matrizes históricas e culturais brasileiras
SUGESTÕES
DE CRONOGRAMAS
As propostas de cronogramas apresentadas a seguir têm como objetivo orientar a distribuição das unidades em planejamentos bimestrais, trimestrais e semestrais, respeitando a organização dos volumes anteriormente mencionada.
Cabe destacar que essas sugestões não contemplam outras atividades que possam surgir ao longo do ano letivo, como projetos, eventos escolares ou avaliações institucionais, e que devem ser incorporadas ao planejamento de forma articulada.
Para elaborar essas sugestões, consideramos 200 dias letivos de aula, ou 40 semanas; no entanto, o cronograma deve ser ajustado conforme as especificidades de cada turma, levando em consideração o contexto, o ritmo de aprendizagem dos estudantes e o uso de diferentes recursos e estratégias pedagógicas, que vão além do livro didático.
Sugestão de planejamento bimestral
Bimestre Unidades e temas
1º bimestre
2º bimestre
3º bimestre
4º bimestre
Vamos iniciar
Unidade 1 – Tema 1 Tema 2 Tema 3 Tema 4 Tema 5
Unidade 2 – Tema 6 Tema 7 Tema 8 Tema 9
Unidade 2 – Tema 10 Tema 11
Unidade 3 – Tema 12 Tema 13
Unidade 4 – Tema 14 Tema 15 Tema 16 Tema 17
Vamos concluir
Sugestão de planejamento trimestral
Trimestre
1º trimestre
2º trimestre
3º trimestre
Unidades e temas
Vamos iniciar
Unidade 1 – Tema 1 Tema 2 Tema 3
Tema 4 Tema 5
Unidade 2 – Tema 6 Tema 7
Unidade 2 – Tema 8 Tema 9 Tema 10 Tema 11
Unidade 3 – Tema 12
Unidade 3 – Tema 13
Unidade 4 – Tema 15 Tema 16 Tema 17 Tema 18
Vamos concluir
Sugestão de planejamento semestral
Semestre
1º semestre
Unidades e temas
Vamos iniciar
Unidade 1 – Tema 1 Tema 2 Tema 3 Tema 4 Tema 5
Unidade 2 – Tema 6 Tema 7 Tema 8 Tema 9 Tema 10
Unidade 2 – Tema 11
Unidade 3 – Tema 12 Tema 13
2º semestre
Unidade 4 – Tema 15 Tema 16 Tema 17 Tema 18
Vamos concluir
BRASIL. Ministério da Saúde. Proteger e cuidar da saúde de adolescentes na atenção básica 2. ed. Brasília: Ministério da Saúde, 2018. Disponível em: https://bvsms.saude.gov.br/bvs/ publicacoes/proteger_cuidar_adolescentes_atencao_basica_2ed.pdf. Acesso em: 5 set. 2025.
Documento que visa auxiliar as Equipes de Atenção Básica/Saúde da Família no trabalho com adolescentes nos aspectos relacionados à saúde.
COSTA, Renato Pinheiro da; CASSIMIRO, Élida Estevão; SILVA, Rozinaldo Ribeiro da. Tecnologias no processo de alfabetização nos anos iniciais do ensino fundamental. Docência e Cibercultura, Rio de Janeiro, v. 5, n. 1, p. 97-116, jan./abr. 2021. Disponível em: https://www.e-publicacoes.uerj.br/ re-doc/article/view/53068/36747. Acesso em: 16 ago. 2025.
Nesse artigo, os autores abordam a influência da tecnologia no desenvolvimento do processo de alfabetização.
GRISA, Gregório Durlo et al Neurociência e alfabetização: noções fundamentais. Bento Gonçalves: IFRS, 2022.
Nesse livro, os autores se baseiam nos estudos da Neurociência para explicar os processos de alfabetização.
LIMA, Aurilia de Brito et al. (org.). Políticas de inclusão na educação básica. Curitiba: Appris, 2024.
Coletânea de textos que abordam os principais marcos das políticas públicas relacionadas à inclusão, desde as temáticas mais amplas até as mais específicas.
MIRANDA, Elaine (coord.). Educação inclusiva e a parceria da família: uma dimensão terapêutica. São Paulo: Literare Books International, 2021.
Nesse livro, a autora aborda aspectos da inclusão com base em evidências científicas. Além disso, ela busca evidenciar a importância da participação da família na educação inclusiva.
MORAIS, José. Criar leitores: para professores e educadores. Barueri: Manole, 2013.
O livro auxilia professores, pais e profissionais a compreenderem o processo cerebral da criança que está aprendendo a ler, considerando seus processos cognitivos e as dificuldades da faixa etária e sugerindo intervenções e estratégias para facilitar a alfabetização.
SANTOS, Maria Lucia dos; PERIN, Conceição Solange Bution. A importância do planejamento de ensino para o bom desempenho do professor em sala de aula. Cadernos PDE, Curitiba, v. 1, p. 1-24, 2013. (Os Desafios da Escola Pública Paranaense na Perspectiva do Professor PDE).
Nesse artigo, as autoras destacam a importância do planejamento e apresentam propostas que auxiliam o professor a realizar seus planejamentos.
SILVA, Janssen Felipe da; HOFFMANN, Jussara; ESTEBAN, Maria Teresa. Práticas avaliativas e aprendizagens significativas: em diferentes áreas do currículo. Porto Alegre: Mediação, 2012. Os autores discutem as práticas avaliativas em diferentes áreas do currículo, com destaque para a elaboração de práticas de avaliação articuladas ao fazer pedagógico.
SOARES, Alessandro Cury; MAUER, Melissa Boldt; KORTMANN, Gilca Lucena. Ensino de ciências nos anos iniciais do ensino fundamental: possibilidades e desafios em Canoas-RS. Revista Educação, Ciência e Cultura, v. 18, n. 1, jan./jun. 2013. Disponível em: https://revistas.unilasalle. edu.br/index.php/Educacao/article/view/954/868. Acesso em: 16 set. 2025.
Esse estudo apresenta as contribuições e obstáculos para a alfabetização científica dos estudantes e a importância dos espaços de formação permanentes para os docentes.
VICKERY, Anitra. Aprendizagem ativa nos anos iniciais do ensino fundamental. Porto Alegre: Penso, 2016.
O livro aborda a importância da aprendizagem ativa e do protagonismo do estudante para a concretização do processo de aprendizagem em sala de aula.
REFERÊNCIAS BIBLIOGRÁFICAS COMENTADAS –
LIVRO DO PROFESSOR
BACICH, Lilian; MORAN, José (org.). Metodologias ativas para uma educação inovadora: uma abordagem teórico-prática. Porto Alegre: Penso, 2018.
Esse livro apresenta a importância das estratégias de metodologias ativas para desenvolver a autonomia dos estudantes, valorizando a participação efetiva deles no processo de aprendizado.
BENDER, William N. Aprendizagem baseada em projetos: educação diferenciada para o século XXI. Tradução de Fernando de Siqueira Rodrigues. Porto Alegre: Penso, 2014.
Nesse livro, o autor destaca as diretrizes práticas para o trabalho com projetos em sala de aula, fornecendo subsídios para o professor planejar aulas mais eficazes e motivadoras.
BRASIL. Congresso Nacional. Grupo de trabalho Alfabetização infantil: os novos caminhos: relatório final. Brasília: Câmara dos Deputados, 2019. Disponível em: https://alfabetizacao.mec.gov. br/images/pdf/alfabetizacao_infanti_novos_caminhos_gastao_vieira.pdf. Acesso em: 5 set. 2025.
Esse relatório é um dos primeiros documentos produzidos no país sobre a temática e apresenta as pesquisas de cientistas internacionais da Ciência Cognitiva da Leitura que poderiam contribuir de modo significativo para a política de alfabetização do Brasil.
BRASIL. Lei nº 8.069, de 13 de julho de 1990. Disponível em: https://www.planalto.gov.br/ ccivil_03/leis/l8069.htm. Acesso em: 5 set. 2025.
Também conhecido como ECA, esse documento visa garantir os direitos fundamentais de crianças e adolescentes, assegurando proteção integral, saúde, educação e dignidade.
BRASIL. Ministério da Educação. Conscientização para o uso de celulares na escola: por que precisamos falar sobre isso? Brasília: MEC, 2025. Disponível em: https://www.gov.br/mec/pt-br/ celular-escola/guia-escolas.pdf. Acesso em: 9 ago. 2025.
Esse documento traz orientações práticas que ajudam o professor na implantação da Lei nº 15.100, que regulamenta o uso de dispositivos eletrônicos portáteis pelos estudantes nas escolas.
BRASIL. Ministério da Educação. Base Nacional Comum Curricular. Versão final. Brasília: MEC, 2018. Disponível em: https://basenacionalcomum.mec.gov.br/images/BNCC_EI_EF_110518 _versaofinal_site.pdf. Acesso em: 5 set. 2025.
Documento que determina as competências gerais e específicas, as habilidades e as aprendizagens que os estudantes brasileiros da Educação Básica precisam desenvolver e colocar em prática ao longo de sua trajetória escolar.
BRASIL. Ministério da Educação. Diretrizes Curriculares Nacionais Gerais da Educação Básica. Brasília: MEC: SEB: Dicei, 2013. Disponível em: https://www.gov.br/mec/pt-br/media/etnico_ racial/pdf/diretrizes_curriculares_nacionais_para_educacao_basica_diversidade_e_inclusao_2013. pdf. Acesso em: 5 set. 2025.
Esse documento traz princípios, fundamentos e procedimentos que norteiam as políticas públicas de educação e auxiliam o professor a elaborar, planejar, executar e avaliar práticas pedagógicas na Educação Básica.
BRASIL. Ministério da Educação. Temas contemporâneos transversais na BNCC: contexto histórico e pressupostos pedagógicos. Brasília: MEC, 2019. Disponível em: https:// basenacionalcomum.mec.gov.br/images/implementacao/contextualizacao_temas _contemporaneos.pdf. Acesso em: 5 set. 2025.
Esse documento apresenta os temas contemporâneos transversais da BNCC e explica a importância de sua utilização no processo de ensino-aprendizagem. BORGES, Gilberto Luiz de Azevedo. O que devemos esperar do ensino de ciências e o que observamos em sala de aula: objetivos em questão. Conteúdos e Didática de Ciências e Saúde, v. 10, 2012. Disponível em: https://acervodigital.unesp.br/bitstream/123456789/47358/1/u1_d23_ v10_t02.pdf. Acesso em: 16 set. 2025.
O trabalho discute quais são os objetivos mais relevantes no ensino de ciências e quais critérios podemos usar ao estabelecer os objetivos para o trabalho em sala de aula.
BRITO, Giseli Artioli; FLORES, Maria Marta Lopes. A inclusão de alunos com deficiência intelectual: em foco as práticas pedagógicas. Boletim de Conjuntura, Boa Vista, ano V, v. 16, n. 48, 2023. Disponível em: https://revista.ioles.com.br/boca/index.php/revista/article/view/2879/966. Acesso em: 18 ago. 2025.
Nesse artigo, as autoras abordam os principais aspectos que influenciaram os resultados de uma pesquisa sobre a inclusão escolar e a qualidade da educação.
CAMPOS, Raquel Sanzovo Pires de; CAMPOS, Luciana Maria Lunardi. A formação do professor de ciências para os anos iniciais do Ensino Fundamental e a compreensão de saberes científicos. Amazônia Revista de Educação em Ciências e Matemática, v. 13, n. 25, jul./dez. 2016. Disponível em: https:// periodicos.ufpa.br/index.php/revistaamazonia/article/view/3812/4048. Acesso em: 16 set. 2025.
Esse trabalho enfatiza a importância de os estudantes, ainda nos anos iniciais do Ensino Fundamental, desenvolverem os saberes científicos.
COELHO, Antonia Ediele de Freitas; MALHEIRO, João Manoel da Silva. O Ensino de Ciências para os anos iniciais do Ensino Fundamental: a experimentação como possibilidade didática. Research, Society and Development, v. 8, n. 6, 2019. Disponível em: https://www.redalyc.org/ jatsRepo/5606/560662197022/html/index.html. Acesso em: 16 set. 2025.
Esse trabalho investigou a concepção de experimentação como didática no ensino de ciências.
CORDEIRO, Claudia Talochinski; OLIVEIRA, Ivanete da Rosa Silva de (org.). Educação e políticas inclusivas: ressignificando a diversidade. Londrina: Syntagma Editores, 2020.
Nessa obra, as autoras discutem a inclusão de estudantes com deficiência na escola regular.
DIAS, Genebaldo Freire. Dinâmicas e instrumentação para educação ambiental. São Paulo: Gaia, 2010.
Estratégias e sugestões de trabalho em sala de aula são apresentadas nesse livro, que apoia o professor em abordagens com noções e conceitos que envolvem a Educação Ambiental.
DINIZ, Margareth; VASCONCELOS, Renata Nunes (org.). Pluralidade cultural e inclusão na formação de professores e professoras. Belo Horizonte: Formato Editorial, 2004.
Nessa obra, as autoras propõem reflexões sobre as práticas educativas e as ações pedagógicas voltadas para uma postura inclusiva.
FAZENDA, Ivani (org.). O que é interdisciplinaridade? 2. ed. São Paulo: Cortez, 2013.
Nesse livro, a autora destaca como são feitas e articuladas diferentes áreas de conhecimento, sob a mediação do professor, ao longo de etapas de projetos que nascem e se desenvolvem dentro das salas de aula.
FAZENDA, Ivani (coord.). Práticas interdisciplinares na escola. 8. ed. São Paulo: Cortez, 2017.
Nessa obra, os organizadores reúnem diversos textos sobre práticas docentes interdisciplinares no espaço escolar.
FERNANDES, Domingos. Avaliação formativa: folha de apoio à formação: Projeto de Monitorização, Acompanhamento e Investigação em Avaliação Pedagógica (Maia). Ministério da Educação: Direção-Geral da Educação, 2021. Disponível em: https://apoioescolas.dge.mec.pt/ sites/default/files/2021-02/folha_avaliacao_formativa.pdf. Acesso em: 6 set. 2025.
Esse material apresenta ações práticas que podem auxiliar o professor no planejamento das estratégias de avaliação.
FERREIRO, Emilia. Alfabetização em processo. 21. ed. São Paulo: Cortez, 2015.
Nesse livro, a autora explica como o processo de alfabetização ocorre no cérebro dos estudantes e sua influência no desenvolvimento dos conhecimentos de outras áreas.
GOMES, Sheila Freitas; OLIVEIRA, Juliana Coelho Braga de Penna; ARROIO, Agnaldo. Fake news científicas: percepção, persuasão e letramento. Ciência e Educação, v. 26, 2020. Disponível em: https:// www.scielo.br/j/ciedu/a/bW5YKH7YdQ5yZwkJY5LjTts/?format=pdf&lang=pt. Acesso em: 16 set. 2025. O artigo explora a compreensão de quais elementos influenciam na credibilidade das fake news científicas. HAYDT, Regina Cazaux. Avaliação do processo ensino-aprendizagem. São Paulo: Ática, 2008. Nesse livro, a autora explicita que a avaliação deve ser uma ação contínua, pois faz parte do processo de ensino-aprendizagem. Por isso, a ação avaliativa também deve ser aplicada de diversas maneiras para diagnosticar, controlar e classificar esse processo.
HOFFMANN, Jussara. Avaliar para promover: as setas do caminho. Porto Alegre: Mediação, 2005.
A autora aborda as relações entre uma concepção dialética de avaliação e os caminhos da aprendizagem.
JOIA, Michele. A inclusão de crianças na escola: o papel do educador diante das dificuldades de aprendizagem. 2. ed. Rio de Janeiro: Wak, 2023.
Nesse livro, a autora fornece dicas sobre a inclusão na escola com base em conhecimentos que ela construiu com base em sua experiência em sala de aula.
MELLO, Fabiane de Oliveira; ALLIPRANDINI, Paula Mariza Zedu. Estratégias de aprendizagem de alunos do ensino fundamental em processo de alfabetização. Revista de Psicología, Lima, v. 40, n. 2, 2022. Disponível em: https://revistas.pucp.edu.pe/index.php/psicologia/article/ view/25503/24038. Acesso em: 16 ago. 2025.
Nesse artigo, as autoras fazem uma análise qualitativa de algumas estratégias de ensino comumente utilizadas no processo de alfabetização.
MOREIRA, Antonio Flávio; CANDAU, Vera Maria (org.). Multiculturalismo: diferenças culturais e práticas pedagógicas. Petrópolis: Vozes, 2008.
O termo multiculturalismo tem sido amplamente usado e envolve distintas instâncias. Na escola, apresenta relação direta com a pluralidade cultural e a realidade cultural contemporânea. A obra tem como objetivo incentivar discussões, estudos e pesquisas que instiguem práticas renovadas em prol de uma sociedade mais justa e solidária.
OLIVEIRA, Maria Marly de. Projetos, relatórios e textos na educação básica: como fazer. Petrópolis: Vozes, 2009.
Obra voltada a professores da Educação Básica no cotidiano das salas de aula.
REIS, Ana Valéria Sampaio de Almeida; DAROS, Thuinie; TOMELIN, Karina Nones. Layouts criativos para aulas inovadoras. Maringá: B42, 2023.
Nesse livro, as autoras sugerem diferentes estratégias de layout das salas de aula a fim de envolver e criar experiências marcantes para os estudantes.
SCHULZE, Clélia Nascimento; CAMARGO, Brigido; WACHELKE, João. Alfabetização científica e representações sociais de estudantes de ensino médio sobre ciência e tecnologia. Arquivos Brasileiros de Psicologia, v. 58, n. 2, 2006. Disponível em: http://pepsic.bvsalud.org/pdf/arbp/ v58n2/v58n2a04.pdf. Acesso em: 16 set. 2025.
O artigo apresenta uma pesquisa que caracteriza o conhecimento científico de estudantes e suas representações sociais sobre ciência e tecnologia.
SILVA, Eva Aparecida Gomes da. O desenvolvimento do processo de ensino-aprendizagem do aluno com necessidades educacionais especiais. Revista Ibero-Americana de Humanidades, Ciências e Educação, São Paulo, v. 9, n. 3, mar. 2023. Disponível em: https://periodicorease.pro. br/rease/article/view/8972/3542. Acesso em: 14 ago. 2025.
Nesse artigo, a autora destaca a importância das atividades lúdicas no processo de ensino-aprendizagem dos estudantes com necessidades educacionais especiais.
SOARES, Magda. Alfabetização e letramento. 5. ed. São Paulo: Contexto, 2018.
Nesse livro, a autora incentiva a releitura de artigos que discutem as práticas escolares de alfabetização e letramento.
VIOLÊNCIA escolar e bullying: relatório sobre a situação mundial. Brasília: Unesco, 2019. Disponível em: https://unesdoc.unesco.org/ark:/48223/pf0000368092/PDF/368092por.pdf. multi. Acesso em: 5 set. 2025.
Nesse relatório, são apresentados dados sobre a violência escolar e o bullying, além de iniciativas que podem contribuir para a redução dessas ocorrências.
ZABALA, Antoni; ARNAU, Laia. Como aprender e ensinar competências. Porto Alegre: Artmed, 2010.
“O que fazer” e “como fazer” são capacidades desenvolvidas de modo que os estudantes articulem os conhecimentos que já têm e busquem outros. Essa eficiência é obtida ao trabalhar competências que, nessa obra, são apresentadas como a instrumentalização para um saber autônomo.
